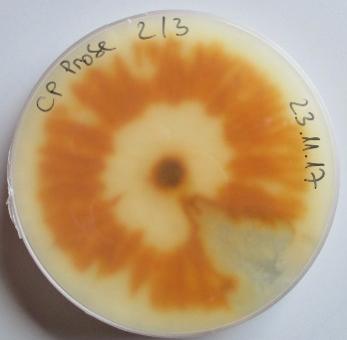

Care lettrici e cari lettori,
il lavoro congiunto con i nostri partner in agricoltura per quanto riguarda uno sviluppo sostenibile sta cominciando a dare i suoi frutti. Nell’ultimo anno sono stati avviati numerosi progetti, ma ciò di cui tutti abbiamo bisogno in questi tempi è un reddito equo per le nostre imprese e condizioni di contorno stabili. Ciò include la disponibilità di fitofarmaci e buone pratiche professionali nella protezione delle piante in frutticoltura e viticoltura. Allo stesso tempo, anche in futuro l’allevamento per la produzione lattiero-casearia dovrebbe rimanere un pilastro dell’agricoltura altoatesina. Le attività economiche secondarie sono e rimarranno importanti.
Si tratta ora di offrire agli agricoltori questa prevedibilità e quindi una prospettiva per i prossimi anni. Nuovi mercati, sviluppi del mercato e digitalizzazione richiedono inoltre un ulteriore rafforzamento della posizione degli agricoltori e delle loro filiere commerciali nei confronti dei partner di mercato. Anche per questo sono necessarie nuove idee al fine di garantire la redditività delle aziende. I prodotti altoatesini sono caratterizzati dalla qualità e dal loro ambiente di produzione. I consumatori devono essere sempre più informati sull’ambiente da cui provengono i prodotti. Se si riesce a comunicare in modo credibile ai consumatori il valore degli alimenti, saranno più disposti a pagarli un prezzo equo.
Sono convinto che si debba riuscire a rendere turismo, servizi e prodotti agricoli ugualmente attraenti per gli stessi consumatori e portarli ad un unico livello di percezione. Chi trascorre le vacanze in Alto Adige acquista anche le mele e il formaggio originale altoatesino apprezzandone l’eccellente qualità. Ma vorrei fare un ulteriore passo avanti. Il marchio Alto Adige dovrebbe trasformarsi da marchio di destinazione a marchio regionale. Vogliamo far conoscere a livello internazionale l’Alto Adige attraverso i suoi prodotti di elevata sostenibilità e qualità, ma anche e non meno importante i produttori stessi. L’Alto Adige come marchio regionale deve avere una risonanza in tutto il mondo. Abbiamo creato la base necessaria per questo
con il documento strategico Agricoltura 2030 e il piano d’azione. La prima parte della relazione sull’agricoltura e la silvicoltura contiene, tra l’altro, una selezione di progetti concreti nel settore agricolo. È iniziato il nuovo periodo di finanziamento della PAC dal 2023 al 2027. Per questo abbiamo dedicato un capitolo anche ai sussidi in agricoltura. Essi sono necessari per sostenere gli elevati standard di produzione e la gestione naturale in agricoltura. A causa dei nuovi regolamenti dell’UE, in Italia esiste un solo piano strategico con un programma di finanziamento. Con il piano strategico PAC si prosegue il precedente percorso altoatesino con un programma di sviluppo rurale molto importante, un sostegno mirato alle aziende agricole a conduzione familiare, premiando la sostenibilità e salvaguardando l’agricoltura di montagna. La riforma della PAC soddisfa le esigenze dei nostri agricoltori e comporta maggiori finanziamenti. Il bostrico, la funzione di protezione del bosco e lo sviluppo di boschi misti: questi sono stati alcuni dei diversi temi dell’ultimo anno riguardanti la silvicoltura. La seconda sezione, invece, presenta in dettaglio la variegata agricoltura e silvicoltura in Alto Adige e gli ampi compiti e attività dei singoli dipartimenti, uffici e istituti di ricerca di Laimburg e dell’Università di Bolzano. Siamo lieti di constatare che negli ultimi anni i fondi messi a disposizione appositamente per il centro di sperimentazione Laimburg siano stati costantemente aumentati. Gli stanzia-
menti per la ricerca e lo sviluppo per il centro di sperimentazione Laimburg, infatti, sono stati incrementati del 115%, passando da 5.475.134 milioni di euro nel 2013 a 11.740.000 milioni di euro nel 2023.
La terza e ultima sezione contiene informazioni dettagliate sui singoli capitoli, che sono state compilate in aggiunta alla seconda sezione. Per la ricchezza dei servizi, vorrei ringraziare gli attori protagonisti e attivamente impegnati quali agricoltori, silvicoltori, apicoltori, cacciatori, pescatori, il gruppo di interesse degli agricoltori, le comunità, le autorità, i fornitori di servizi e i partner dell’agricoltura e della silvicoltura per il loro importante impegno nei confronti del nostro Paese. Ringrazio anche i dipendenti dei dipartimenti e degli uffici dell’amministrazione provinciale e degli enti di ricerca per la raccolta e l’elaborazione dei dati.
Il rapporto sull’agricoltura e sulla silvicoltura fornisce approfondimenti e fatti inerenti questi ambiti in Alto Adige e vuole anche servire da compendio e opera di riferimento per tutti coloro che sono interessati al settore agricolo. Auguro dunque a tutti voi un’interessante lettura!

Il Vostro Assessore
Arnold Schuler

Sviluppo del settore agricolo
1.




1.1 Sostenibilità e agricoltura: un percorso comune per l’Alto Adige
Il dipartimento Agricoltura, Foreste, Turismo e Protezione civile insieme al Bauernbund e ai rappresentanti di settore hanno intrapreso l’anno scorso un percorso comune verso la sostenibilità per il settore dell’agricoltura in Alto Adige. È giunto il momento di unire le forze fra i diversi settori dell'agricoltura altoatesina e di elaborare un piano comune per una gestione sostenibile. Questo settore si trova già ora e si troverà ancora di più in futuro ad affrontare nuove sfide, e questo deve essere fatto insieme. Le nostre aziende agricole risentono della crescente pressione del cambiamento climatico, della digitalizzazione e spesso della scarsa comprensione da parte della società. La loro situazione economica in tutti i settori, ma soprattutto nel settore lattiero-caseario era tutt'al-
tro che rosea a causa dell'aumento dei prezzi. Tutti si sono confrontati con l'aumento esagerato dei costi dell'energia, dei carburanti agricoli e dei prodotti necessari alla cura delle coltivazioni. Nel settore lattiero-caseario, tuttavia, la situazione è stata resa ancora più difficile dal fatto, che i prezzi dei mangimi sono aumentati enormemente. È proprio in questi tempi difficili che si sono venute a creare le condizioni favorevoli per sostenere le aziende agricole di montagna unendo le forze e costituendo un tavolo permanente con l'assessore provinciale all'Agricoltura Arnold Schuler.
1.2 Nuovo periodo di finanziamento UE
1.3 Foreste
Le sovvenzioni a livello provinciale, nazionale e dell'UE sostengono standard di produzione elevati, una gestione naturale in agricoltura e mirano a rafforzare lo sviluppo sostenibile delle nostre aziende agricole. Finora si è riusciti ad evitare l’abbandono dei masi di montagna e vengono ancora gestite circa 1.500 malghe; anche i prati e le aree di montagna, quindi, svolgono la loro funzione protettiva naturale e sono attraenti dal punto di vista paesaggistico per escursionisti locali e stranieri. Tutto questo va pre-
servato. Il nuovo periodo di finanziamento dell'UE durerà 5 anni, a partire dal 2023 fino al 2027. Anche i criteri di finanziamento a livello provinciale sono stati rivisti in relazione all’inizio del nuovo periodo.
Il bostrico, la funzione protettiva delle foreste e il rimboschimento dei popolamenti misti: questi sono stati alcuni dei numerosi temi che hanno riguardato la silvicoltura nell'ultimo anno. Fino a cinque anni fa i boschi della provincia di Bolzano erano ancora sani e vitali, –mentre oggi sono sorvegliati speciali. Per questo, in Alto Adige va data –sempre e comunque – la massima priorità – ad uno sviluppo del nostro patrimonio forestale che sia sostenibile e rispettoso delle sue risorse. È
stata inoltre elaborata l'Agenda forestale 2030, con gli obiettivi e le misure attraverso cui vogliamo preparare la foresta, i suoi proprietari, i gestori e la società alle sfide forestali del futuro.
Workflow
Sostenibilità e agricoltura: un percorso comune per l’Alto Adige
La politica e gli stakeholder vogliono promuovere uno sviluppo sostenibile dell'agricoltura altoatesina. Perché la responsabilità condivisa richiede un percorso condiviso. Per quanto riguarda gli obiettivi di sostenibilità dello Stato dell'Alto Adige, il consigliere provinciale Arnold Schuler e i rappresentanti dell'agricoltura hanno concordato un metodo di lavoro comune per sviluppare ulteriormente i progetti comuni
gruppo d‘azione: 19.05.2022
Agricoltura: 2030: un percorso comune per l’Alto Adige
per un'agricoltura sostenibile e coordinarli ancora meglio in futuro. A tal fine sono stati istituiti 3 diversi tavoli di lavoro per sviluppare il processo strategico “Agricoltura 2030: un percorso comune per l’Alto Adige.”
Il gruppo di comunicazione: è composto da esperti di comunicazione dei settori mele, vino, lattiero-caseario, SBB, IDM e del dipartimento Agricoltura, Foreste, Turismo e Protezione





civile. Questo gruppo si riunisce una volta al mese, per coordinare le prossime questioni di comunicazione e per garantire la continuità del processo di sviluppo.
Il gruppo d’azione: è composto dall’Assessore all’Agricoltura Arnold Schuler, dai suoi collaboratori di dipartimento, dai direttori dei tre consorzi, dai rappresentanti del SBB, dai rappresentanti delle organizzazioni di consulenza, dai rappresentanti delle tre istituti di ricerca (UNIBZ, Laimburg, Eurac), dai rappresentanti del IDM e dall’Incaricato speciale per la sostenibilità della provincia. Questo gruppo si incontra trimestralmente. Su questo tavolo di lavoro scientificamente supportato, i temi chiave dell'agricoltura vengono discussi in modo mirato. Il grande cerchio: si riunisce una volta all'anno. Sono rappresentati gli stakeholder di tutti i settori coinvolti. Lo scopo del processo di sviluppo è quello di garantire una comprensione e un accordo comune su come procedere verso un'agricoltura sostenibile.
Questo processo di sviluppo attivo e cooperativo rafforza i gruppi coinvolti e l'agricoltura nel suo complesso. Il dialogo di apprezzamento su desideri, preoccupazioni, idee e opinioni consente uno scambio comune di conoscenze fra i partecipanti sull'a-
gricoltura altoatesina. E le discussioni costruttive creano una solida base per opportunità, visioni e potenzialità a lungo termine per l'agricoltura in Alto Adige.
1.1





gruppo d‘azione: 20.10.2022
le istituzioni scientifiche
gruppo d‘azione: 24.11.2022
Piano clima Alto Adige 2040

Agricoltura 2030 –Il piano d'azione

In occasione dei "Sustainability Days Alto Adige 2022" l'assessore provinciale all'Agricoltura, Arnold Schuler, unitamente a Leo Tiefenthaler in rappresentanza del Bauernbund, ha presentato il Piano d'azione 2030, "Agricoltura 2030: un percorso comune per l'Alto Adige". Il Piano d'azione presentato oggi è una raccolta di misure, corredate da circa cento progetti, volte all'attuazione di un piano comune. I progetti del Bauernbund, dei settori delle mele, del vino e del latte, della Provincia e delle istituzioni scientifiche rientrano nei sei ambiti di intervento del documento strategico Agricoltura 2030. Nello specifico: aziende familiari e territorio rurale, clima e riduzione delle emissioni di CO2, acqua e suolo, biodiversità e
paesaggio, salute e sapori, società e dialogo. Inoltre, è stato aggiunto il punto “monitoraggio e digitalizzazione” che mostra lo sviluppo digitale in agricoltura. Anche il Bauernbund, in stretta collaborazione con i settori produttivi, ha elaborato obiettivi comuni per uno sviluppo sostenibile dell'agricoltura. Gli sforzi congiunti per la sostenibilità sono elencati in sei linee guida e otto progetti faro afferenti al Piano d'azione.
Ecco alcuni esempi dell'anno 2022:

1.1.1 Ambito di intervento: Aziende familiari & territorio rurale
Visione del settore lattierocaseario
Viviamo in un periodo difficile. Negli ultimi anni l'agricoltura e soprattutto il settore lattiero-caseario sono stati messi a dura prova. I presidenti e i dirigenti delle latterie altoatesine hanno affrontato seriamente il problema riguardante il futuro del settore. Si sono posti la domanda su come e in quale direzione dovrebbe svilupparsi l'industria lattiero-casearia altoatesina per garantire ai soci un futuro sano ed economicamente sostenibile. Durante diversi incontri è stata definita la linea base per i prossimi anni. In questo contesto è stata concretizzata una visione per il settore lattiero-caseario altoatesino, che farà da guida. Tramite l’affinamento del latte in prodotti di alta qualità, il valore aggiunto dei fornitori di latte cresce. In questo modo il settore lattiero-caseario contribuisce a mantenere in vita l'agricoltura di montagna. La trasparenza, la sostenibilità e l’innovazione sono i punti di forza nella vendita. Un obiettivo strategico importante è la cooperazione con il fine di aumentare il valore per i soci. Esiste già una collaborazione molto stretta in vari ambiti come il coordinamento per l'acquisto di gas ed energia elettrica ma anche nell'ambito della logistica, della produzione, nello scambio di prodotti e dei temi relativi al benessere animale e alla sostenibilità.
Nuove linee guida per il finanziamento della consulenza
Le aziende agricole sono particolarmente colpite dai numerosi cambiamenti delle condizioni generali. Con i nuovi criteri per agevolare lo scambio di conoscenze e azioni di informazione nonché per servizi di consulenza possono essere concesse sovvenzioni per consulenze professionali con lo scopo di creare nuove opportunità per aumentare il proprio rendimento e la propria competitività. Nel nuovo periodo di finanziamento viene prestata maggiore attenzione alla prevenzione e gestione dei rischi, al risparmio energetico e all'energia sostenibile, nonché all'aumento della diversità biologica, al benessere animale e alla sostenibilità ecologica, temi che stanno diventando sempre più importanti e che dovrebbero essere trattati con maggior attenzione durante la consulenza. Un altro focus tematico riguarda il clima: la consulenza informa a proposito delle misure di riduzione delle emissioni che si possono attuare nelle aziende. Promuove inoltre approfondimenti sulle capacità imprenditoriali e l'innovazione.
1.1.1
1.1.2 Ambito di intervento: Clima & riduzione delle emissioni di CO2
Applicazione dello standard nazionale per la certificazione della sostenibilità
Il tema della sostenibilità è sulla bocca di tutti, soprattutto in agricoltura, e senza un certificato riconosciuto, oggi difficilmente è possibile comunicare e dimostrare la gestione sostenibile ai consumatori e ai canali di vendita. Oggigiorno molti prodotti lattiero-caseari vengono contrassegnati, in tutta Europa, con certificazioni relative al benessere animale, ovvero indici di qualità che attestano un alto grado di benessere animale. Anche lo Stato italiano si è occupato di questa tematica. Per questo motivo, nel 2020, è stato sviluppato e formato a livello statale il quadro normativo per la certificazione della sostenibilità. La legge 17 luglio 2020, n.77, agli articoli 224-bis e 224-ter prevede l'istituzione di un sistema per la certificazione della sostenibilità nell'ambito della zootecnia e del benessere degli animali ovvero dei prodotti agricoli. In futuro ci sarà la certificazione del benessere degli animali per gli allevamenti e i forni-
Inventario del carbonio
L'UE punta alla neutralità climatica per i settori agricolo, uso del suolo e forestale già a partire dal 2035. La produzione alimentare è inevitabilmente legata alle emissioni di gas serra, ad esempio attraverso la fertilizzazione. Tuttavia, i terreni agricoli e forestali hanno anche la possibilità di immagazzinare a lungo termine carbonio nella vegetazione o nel suolo. A seconda dell'uso del suolo, in un ettaro di terreno agricolo vengono immagazzinate tra le 50 e le 100 tonnellate di carbonio. Per quanto riguarda la realtà altoatesina, particolarmente eterogenea, tuttavia, non esistono ancora dati concreti sul volume di stoccaggio e sulla stabilità di queste riserve di carbonio. Un nuovo progetto condotto da Eurac Research in collaborazione con la Libera Università di Bolzano intende colmare questa lacuna. A tale proposito verranno raccolti e armonizzati dati sul suolo di progetti precedentemente conclusi e, laddove ce ne sarà bisogno, saranno analizzati nuovi campioni. Contemporaneamente si intende analizzare ii dati dei quattro punti di misurazione dell’anidride

tori di latte con l'etichetta SQNBA. Requisito per questa certificazione di benessere animale SQNBA è la classificazione "ClassyFarm" effettuata da parte di un veterinario aziendale. Successivamente, nel 2021, sono stati emanati due regolamenti attuativi che definiscono e disciplinano puntualmente la sostenibilità della filiera del settore vitivinicolo e ortofrutticolo a livello nazionale. L'obiettivo di questa nuova certificazione di sostenibilità dovrebbe essere quello di creare uno standard minimo uniforme a livello nazionale, indipendentemente dalla coltura agricola, a partire dalla coltivazione in campo fino alla fase post-raccolta, ovvero includendo la lavorazione, la conservazione, l'affinamento e il confezionamento di prodotti agricoli. L'attenzione si pone non solo su temi ecologico-agronomici ma anche su aspetti sociali come l'occupazione, la salute e la formazione continua dei dipendenti che lavorano in azienda e su priorità economico-ecologiche come energia, acqua e packaging.
carbonica esistenti in Alto Adige per capire quanto siano stabili le riserve di carbonio nei terreni agricoli. I dati verranno usati per un calcolo a livello
dell'Alto Adige e resi disponibili sotto forma di mappe. L'obiettivo principale del progetto è quello di quantificare le riserve di carbonio nei terreni agricoli e quali misure sono necessarie per mantenerle o addirittura aumentarle.
Nuovo fondo per le costruzioni in legno

Nel dicembre 2022 alla norma provinciale n. 21 definita “Legge forestale” e risalente al 21 ottobre 1996 è stato aggiunto un nuovo articolo, ovvero il 48/bis, diventa la base giuridica del nuovo "Fondo per l'edilizia in legno". L'obiettivo di questo nuovo finanziamento è quello, negli edifici pubblici, di preservare le risorse limitate favorendo l’impiego del legno come materiale da costruzione, assieme anche ad altre materie prime rinnovabili così da stoccare un maggior quantitativo di carbonio (CO2) e dare un contributo più significativo alla tutela del clima. Il nuovo fondo per le costruzioni in legno è stato istituito dalla giunta provinciale per il periodo 2023 – 2030 e sarà sostenuto con uno stanziamento di 1.200.000 euro all’anno; attraverso un bando di gara annuale saranno assegnate le risorse finanziarie ai progetti di edilizia pubblica. Il finanziamento è previsto per la costruzione di edifici e strutture ad uso pubblico realizzati esclusivamente o prevalentemente con legno certificato proveniente da foreste gestite in modo sostenibile situate entro un raggio di 500 km. L'accesso al fondo è aperto alle autorità pubbliche locali, quali comuni, comunità distrettuali, amministrazioni separate di beni di uso civico e simili. Il finanziamento viene concesso sotto forma di sovvenzione una tantum ed è legata alla quantità di carbonio sequestrato
dal legno utilizzato per gli elementi costruttivi e i materiali isolanti (quindi, sia legno che materiali a base di legno).
Agri-Fotovoltaico
Nell'ambito del progetto "Symbiosyst", il Centro di sperimentazione
Laimburg installerà due sistemi pilota, uno su un meleto nuovo e l'altro su uno esistente. Insieme al Bauernbund il centro di sperimentazione
Laimburg esaminerà le esigenze delle imprese agricole e valuterà i pro e contro per un simile investimento. E l'accettazione sociale di tali sistemi? Può essere raggiunta se gli agricoltori, la popolazione locale e la società nel suo complesso possono trarre vantaggio dall'agrifotovoltaico rispettando il paesaggio. Ciò può avere successo se i comuni adiacenti e la popolazione locale sono coinvolte nei processi decisionali ed economici. È importante spiegare che questa tecnologia può essere utilizzata in diversi contesti. Il progetto "Symbiosyst" è una misura di innovazione finanziata dal programma europeo Horizon Europe, che mira a rispondere alle sfide dell'approvvigionamento energetico e alle esigenze del settore agricolo, creando un rapporto reciprocamente vantaggioso tra fotovoltaico e agricoltura. Eurac Research coordina il progetto. I partner altoatesini coinvolti sono il Centro di sperimentazione Laimburg ed il Bauernbund. Il progetto svilupperà soluzioni e strategie tecnologiche per aumentare la competitività delle soluzioni fotovoltaiche per l'agricoltura in Europa e per minimizzare l'impatto sul paesaggio e sull'ambiente. Il progetto, al quale partecipano 17 partner, ha un budget complessivo di circa cinque milioni di euro.
1.1.3 Ambito di intervento: Acqua & suolo
Sviluppo di una strategia di adattamento climatico per l'Alto Adige
Nel settore agricolo, le strategie di adattamento ai cambiamenti climatici e di tutela del clima sono strettamente intrecciate. L'agricoltura è un settore che subisce le conseguenze dei cambiamenti climatici, ma allo stesso tempo è un fattore che contribuisce agli stessi. I rischi e i danni attuali e futuri derivanti da questi cambiamenti dovrebbero quindi essere mitigati tempestivamente. Un progetto commissionato dall'Agenzia per la Protezione civile si occupa dello sviluppo di una strategia globale di adattamento
Riscoprire il suolo
Il corso si propone di fornire gli strumenti per la conoscenza del suolo. È rivolto ad agricoltrici e agricoltori, consulenti e a tutti coloro che vogliono conoscere, comprendere e interpretare le connessioni nel suolo. Il “Bodenpraktiker Südtirol” è un progetto finanziato dal FEASR ed è organizzato e realizzato dal gruppo di lavoro per l'agricoltura biodinamica insieme a Bioland Südtirol. Il corso è strutturato in sei moduli di 2 giorni ciascuno. Si parte dalle condizioni climatiche e geologiche in cui sono stati
climatico per l'Alto Adige. Lo scopo è quello di identificare e comprendere i rischi climatici: sviluppare una conoscenza più approfondita sui rischi legati al clima e sviluppare una comprensione sistemica delle connessioni e degli effetti a cascata sui singoli processi, sugli ecosistemi e nei vari settori coinvolti (protezione civile, acqua ed energia, territorio e silvicoltura, pianificazione degli insediamenti e del territorio, conservazione del paesaggio e della natura, turismo, salute, …). É di primaria importanza, individuare le esigenze di adattamento e sviluppare opzioni di adeguamento intersettoriali.
creati ed esposti i nostri terreni altoatesini. Nel secondo modulo vengono spiegate le interazioni chimiche nel suolo e nella pianta. Il terzo modulo affronta il tema della micorriza e della funzione di assorbimento dei nutrienti nella rizosfera delle radici. Il quarto modulo affronta il tema della corretta nutrizione e concimazione del terreno attraverso la semina e la corretta lavorazione del terreno. Il modulo 5 si occupa della produzione e dell'applicazione del compost. Il sesto e ultimo modulo affronta il tema della semina in agricoltura.

Nuovi sussidi per il rinnovo delle infrastrutture irrigue in Alto Adige
I segnali del cambiamento climatico sono sempre più visibili anche in Alto Adige. In inverno le precipitazioni scarseggiano il che ha come conseguenza la mancanza d’acqua. L'Alto Adige intende quindi sensibilizzare l'uso sostenibile dell'acqua e promuovere il passaggio ad un'irrigazione mirata al fine del risparmio idrico con il conseguente stoccaggio dell’acqua. Negli ultimi 10 anni ne sono stati messi a disposizione circa 90 milioni per investimenti in questo ambito. Ogni anno vengono utilizzati per l'agricoltura circa 150 mi-
1.1.4 Ambito di intervento: Biodiversità & paesaggio
Effetto della concimazione con concimi organici aziendali in prati moderatamente ricchi di specie Raggiungere l’armonia tra produzione di foraggio e biodiversità è una sfida. Da un lato, gli animali altamente produttivi hanno bisogno di un'ottima qualità di foraggio per soddisfare il loro elevato fabbisogno energetico, con il vantaggio anche di una riduzione del consumo di mangimi concentrati; dall'altro, la gestione intensiva causa generalmente una diminuzione della biodiversità dei prati e pascoli. Ma qual è l'effetto della concimazione con concimi organici su prati che si trovano alla soglia tra la moderata povertà di specie (prati non Natu-
lioni di m³ di acqua. Degli oltre 9.000 impianti irrigui, 6.200 sono alimentati da pozzi. In Alto Adige l'irrigazione a goccia è da decenni una tecnica collaudata per fornire alle colture l'acqua necessaria. I principali vantaggi rispetto all'irrigazione soprachioma sono il grande potenziale di risparmio idrico ed energetico e la distribuzione più uniforme dell'acqua. L’Agenzia Demanio provinciale svolge già un ruolo pionieristico in questo ambito: oltre all’utilizzo su larga scala del sistema d’irrigazione a goccia nei terreni di propria competenza (principalmente impiegati per la ricerca scientifica), essa ha subito convertito tutti gli impianti al 100% con un progetto pilota, che prevede l’adozione di uno straordinario sistema a risparmio idrico, cioè un sistema di irrigazione di precisione, regolato automaticamente al bisogno tramite sensori. L’impiego dei tensiometri contribuisce ulteriormente ad utilizzare l'acqua come risorsa in modo ancora più efficiente e sostenibile. Un intero pacchetto di misure di finanziamento che hanno come finalità l’uso più parsimonioso dell'acqua come ad esempio la costruzione di bacini e la riparazione delle condotte per ridurre le perdite d’acqua è stato quindi introdotto quest’anno dalla Provincia Autonoma di Bolzano. Il nuovo sussidio provinciale per i sistemi di irrigazione ha lo scopo di rafforzare la sostenibilità delle operazioni agricole e, in particolare, di ridurre i costi di produzione.

1.1.4
ra 2000) e la moderata ricchezza di specie (prati Natura 2000)? È proprio questa la domanda che i ricercatori del Centro di Sperimentazione Laimburg hanno affrontato in un progetto quinquennale. Per questa ragione hanno studiato come il tipo di concime organico aziendale (liquame, letame, una combinazione di letame e colaticcio) e l'apporto di nutrienti (l'equivalente di 0, 0,65 e 1,3 UBA/ha) influenzano le proprietà del suolo, la composizione botanica, la resa e la qualità del foraggio. Dopo cinque anni (2018 – 2022), emergono già alcune tendenze: I prati moderatamente ricchi di specie sono più sensibili di quelli moderatamente poveri di specie alle variazioni dell'apporto di nutrienti, mentre i prati mode-
In un esperimento pluriennale del Centro di Sperimentazione Laimburg vengono studiati gli effetti della concimazione con diversi concimi organici e quantità di concime su prati permanenti moderatamente ricchi di specie, sia dal punto di vista agronomico sia dal punto della protezione della biodiversità.
1.1.5
Ambito di intervento:
Salute & sapori
Marchio Sostenibilità per le aziende turistiche
Il "Marchio Sostenibilità Alto Adige" viene assegnato a destinazioni turistiche e strutture ricettive. La base per la certificazione è un programma completo di sostenibilità per il turismo, che IDM Alto Adige ha sviluppato insieme a parti interessate ed esperti. Si tratta di economia circolare, mobilità smart, gestione dei visitatori, ma anche raccolta e riduzione delle emissioni di CO2. L'Alto Adige ha numerosi prodotti agricoli locali di alta qualità e quindi l'uso esclusivo di latte fresco, burro, yogurt, mele e succo di mela è
1.1.6 Ambito di intervento: Società & dialogo
Nuovo workshop sulla comunicazione
Sulla base del documento strategico per l'agricoltura altoatesina "Agricoltura 2030", che contiene obiettivi per il futuro dell'agricoltura in Alto Adige e dei diversi documenti strategici dei settori, è stata riconosciuta la necessità di una comunicazione uniforme. Questo tema deve essere comunicato in modo comprensibile e coerente e, ultimo ma non meno importante, con il contributo di tutti i soggetti coinvolti. Solo allora le misure sviluppate e sostenute congiuntamente potranno

ratamente poveri di specie reagiscono con maggiore inerzia. Al contrario, la qualità del foraggio è solo leggermente influenzata dalla concimazione. In conclusione, si può affermare che in prati moderatamente ricchi di specie è possibile effettuare una leggera concimazione (0,65 UBA/ha) senza notevoli cambiamenti del prato.
obbligatorio per ottenere la certificazione. Relativamente alla presenza di vini locali, i vini altoatesini devono avere la maggiore presenza nelle carte dei vini. Per il futuro, si sta lavorando alla successiva espansione dei gruppi di prodotti. Lo standard di sostenibilità appositamente sviluppato per l'Alto Adige si basa sui criteri del Global Sustainable Tourism Council (GSTC), un'organizzazione internazionale che ha definito uno degli standard più affidabili, certificabili e quindi più credibili per il turismo sostenibile e il viaggio sostenibile in tutto il mondo.
non solo essere comprese, ma anche vissute e interiorizzate dagli agricoltori e dalle parti interessate. Per questo il Dipartimento Agricoltura, Foreste, Turismo e Protezione Civile ha organizzato lo scorso dicembre un workshop insieme all'Agenzia di stampa e comunicazione. In questo seminario, per il quale si sono incontrati i numerosi esperti di comunicazione nel campo dell'agricoltura, l'obiettivo era quello di coordinare temi specifici della comunicazione come visione, narrazione, valori e gruppi target per la strategia "Agricoltura 2030: il per-
1.1.7 Ambito di intervento: Monitoraggio & digitalizzazione
Monitoraggio della deriva: le misure sono efficaci
L'agricoltura altoatesina è caratterizzata e influenzata dalle diverse altitudini e condizioni climatiche, dalla natura del suolo, dalla suddivisione in aree montane e di fondovalle, determinanti, quali condizioni base per ogni forma di agricoltura. In Alto Adige inoltre più della metà delle aziende agricole dei masi ha dimensioni inferiori a cinque ettari e un quinto solo fino a un ettaro, pertanto la struttura agricola in Alto Adige è inferiore per superficie in confronto con la media internazionale. Di conseguenza l'agricoltura in Alto Adige è sempre stata praticata su spazi ristretti. Per i trattamenti con prodotti fitosanitari nei frutteti e nei vigneti le misure sono finalizzate all'utilizzo delle più moderne tecniche di irrorazione e applicazione, ad un controllo a distanza per i nuovi impianti, alla messa a dimora di siepi di protezione dalla deriva e condizioni climatiche meteorologiche favorevoli per l'applicazione. Gli sforzi compiuti negli ultimi anni dai frutticoltori e dai viticoltori per evitare la deriva dei fito-
corso sostenibile dell'Alto Adige". In tal modo è stata sviluppata la visione comune "Un'agricoltura viva per un Alto Adige sostenibile". Si trattava soprattutto di condividere un atteggiamento uniforme e di individuare messaggi chiave per la comunicazione ai diversi gruppi target. Anche la classificazione dei valori del settore agricolo nel principio ordinatore del marchio regionale Alto Adige ha svolto un ruolo importante. L'obiettivo di questo workshop è stato quello di mettere i professionisti della comunicazione in condizione di progettare e comunicare strategicamente questi processi completi dall'interno del marchio. In questo modo, la sostenibilità e il potere innovativo dell'agricoltura possono essere rafforzati, il successo economico assicurato e gli agricoltori possono avere un orientamento chiaro in un mondo complesso.

1.1.7
sanitari hanno avuto effetto: i residui di sostanze attive rilevate sulle aree pubbliche, rimanendo appena superiori alla soglia di rilevabilità, sono diminuiti di oltre il 70 per cento negli ultimi quattro anni. Questo è il risultato di uno studio dell’Azienda Sanitaria altoatesina e del centro di sperimentazione Laimburg. Le misure nei frutteti e nella viticoltura per ridurre la deriva hanno quindi successo. Ciò include, ad esempio, mediante l’utilizzo di ugelli particolari negli spruzzatori, la dispersione di goccioline grossolane a bassa deriva e la sensibilizzazione degli utilizzatori alla tematica. L'intero studio sul monitoraggio delle aree pubbliche è stato pubblicato in inglese sulla rinomata rivista scientifica "Frontiers in Environmental Science" dal servizio sanitario e dal centro di ricerca Laimburg – dopo la verifica da parte di esperti indipendenti. Tutti i dati grezzi del monitoraggio a lungo termine sono pubblicamente accessibili su Internet. Lo scopo del lavoro è stato quello di presentare in modo trasparente e comprensibile tutti i dati ottenuti dal monitoraggio.
LIDO – Laimburg Integrated Digital Orchard
Il progetto LIDO è indirizzato ai nuovi strumenti digitali, alla robotica, all'automazione e all'intelligenza artificiale per l'agricoltura. Queste innovazioni digitali mirano a rendere l'agricoltura "smart" ("smart farming") e a promuovere una produzione più sostenibile, a utilizzare le risorse disponibili in modo più sostenibile e ad adeguarsi ai cambiamenti climatici. Per testare, verificare e (ulteriormente) sviluppare queste nuove tecnologie, nel 2022 è stato realizzato per la prima volta presso il Centro Sperimentale Laimburg

un laboratorio digitale a cielo aperto per la frutti- e viticoltura, il cosiddetto LIDO (Laimburg Integrated Digital Orchard). In questo laboratorio a cielo aperto ricercatori, consulenti, aziende e agricoltori lavoreranno insieme per testare in campo, anche in combinazione tra di loro, nuovi metodi e tecnologie come sensori, robot, droni e tecnologie per la trasmissione dati. Grazie a questo "Living Lab", l'innovazione nel campo della digitalizzazione nell'agricoltura verrà supportata e le tecnologie digitali verificate verranno integrate con successo nella realtà.
Sostegni economici 1.2
1.2.1 Sostegni economici UE –
Nuova PAC: 2023 – 2027
I finanziamenti nell'ambito della politica agricola comune europea rappresentano uno strumento importante per promuovere buone pratiche agricole e forestali. Sostengono gli elevati standard di produzione e la gestione naturale in agricoltura. L'obiettivo dell'Alto Adige resta quello della riqualificazione delle aree rurali, la garanzia della funzione di approvvigionamento e la competitività dell'agricoltura altoatesina. A differenza di altri paesi europei, l'Italia disponeva in precedenza di un programma di sviluppo rurale statale e di programmi
regionali. Questo è stato un vantaggio per l'Alto Adige, in quanto il programma poteva essere adattato più facilmente alle condizioni locali e alle esigenze dell'agricoltura di montagna. Nel nuovo periodo di finanziamento 2023 – 2027, questo cambierà. A causa dei nuovi regolamenti dell'UE, in Italia esiste un solo piano strategico nazionale con un programma di finanziamento. Dal 2014, le sovvenzioni all'agricoltura sono aumentate di circa il 20% e le cose si mettono bene per il futuro.
Sostegni economici UE
L'obiettivo della Provincia Autonoma di Bolzano rimane anche per il futuro quello di aumentare la sostenibilità economica, ecologica e sociale nelle aree rurali. Negli ultimi anni sono stati messi a disposizione ingenti finanziamenti volti a tale scopo nelle zone rurali.
Tra l'altro, la PAC prevede due pilastri di finanziamento: il primo pilastro con cui vengono erogati pagamenti diret-
ti con criteri di finanziamento uniformi per l'intero territorio nazionale. Il secondo pilastro di finanziamento, invece, riguarda la promozione dello sviluppo rurale (PSR) specifico per l'Alto Adige. Per questo sono disponibili 64,9 milioni di euro all'anno: l'UE stabilisce il quadro normativo e l'Alto Adige può stabilire i propri criteri per l'utilizzo dei fondi all'interno del piano strategico statale.
Il cosiddetto piano strategico nazionale – PAC – 2023 2027 è stato approvato dall'UE il 4 dicembre 2022. La base dell'attuazione italiana della politica agricola comune per il periodo di finanziamento 2023 – 2027 è il cosiddetto piano strategico della PAC. Per la prima volta, i due pilastri della politica agricola, compresa la regolamentazione del mercato e la prevenzione dei ri-
schi, sono riuniti in un unico documento strategico. Con il piano strategico nazionale PAC si prosegue il percorso altoatesino con un forte programma di sviluppo rurale, un sostegno mirato alle aziende agricole a conduzione familiare e la salvaguardia dell'agricoltura di montagna. La riforma della PAC soddisfa le esigenze dei nostri agricoltori e comporta maggiori finanziamenti.
1.2.1.1 Primo Pilastro –Nuova architettura
Nel caso del pagamento di base, il numero e la numerazione dei cosiddetti diritti al pagamento per ettaro sono rimasti invariati negli ultimi sette anni, ma il loro valore sarà adeguato alla media statale dall'attuale 60 all'85 per cento entro il 2026. Tuttavia, è stato introdotto un limite massimo di 2.000 euro per tutti i diritti all'aiuto a livello nazionale. Oltre al pagamento di base ed eventuali premi aggiuntivi per i giovani agricoltori per un periodo di cinque anni, ci saranno due innovazioni: La prima è che, ci sarà una ridistribuzione in base alla dimensione aziendale, di cui beneficeranno gli agricoltori altoatesini. Verrà introdotto un premio di ridistribuzione pari in media a circa di 81,7 euro per ettaro fino a 14 ettari di superficie ammissibile se le aziende agricole non coltivano più di 50 ettari.
1.2.1.2 Secondo pilastro –sviluppo rurale
Saranno disponibili 325 milioni di euro per lo sviluppo rurale tra il 2023 e il 2027. L'indennità compensativa costituisce la quota maggiore del finanziamento per lo sviluppo rurale. L'indennità compensativa nell'ambito del Secondo Asse di Sviluppo Rurale concede un sostegno per la difficoltà di trasformazione degli allevamenti in zone montane. L'indennità compensativa serve quindi a mantenere la situazione gestionale esistente e
La seconda novità riguarda invece l’introduzione dei cinque cosiddetti eco-schemi. Due di questi cinque sono molto interessanti per l'Alto Adige: uno riguarda l'allevamento di animali – chi conduce alpascolo i propri animali riceverà un sussidio notevolmente più alto – mentre l’altro; è per l'inverdimento permanente delle aree coltivate, cioè la crescita di un tappeto erboso tra i filari di mele e nel vigneto. In compenso, il precedente premio greening non sarà è più applicabile. Come negli anni precedenti, oltre al premio aziendale saranno concessi premi accoppiati per animali. Anche gli agricoltori che non hanno diritto al pagamento unico possono partecipare a questi programmi.
contribuisce alla conservazione dei valori economici, sociali, culturali ed etici caratteristici. A lungo termine, ciò dovrebbe garantire il mantenimento di un'attività agricola naturale estensiva nell'area montana. Nei prossimi cinque anni saranno erogati 97,5 milioni di euro attraverso l'indennità compensativa.
La seconda fetta più grande della torta è destinata alle sovvenzioni per i prati. L'obiettivo in questo caso è quello di sostenere l'uso di pratiche agricole estensive e rispettose dell'ambiente sui prati da fieno. Sono ammissibili al finanziamento anche il miglioramento del benessere degli animali, l'allevamento di razze a rischio di estinzione, la vendita e la commercializzazione di prodotti agricoli, i progetti Leader, i giovani agricoltori che rilevano un'azienda agricola e l'agricoltura biologica. Al fine di aumentare il numero di superfici coltivate biologicamente e quindi contribuire al raggiungimento dell'obiettivo della strategia "dal produttore al consumatore" (entro il 2030, il 25% della superficie agricola utilizzata nell'UE sarà coltivata biologicamente), i pagamenti per superficie per questa specifica misura sono stati rilanciati. Per la conservazione degli habitat e delle specie Natura 2000, nel nuovo piano strategico della PAC 2023 – 2027 sono previste due misure, che rappresentano un passaggio essenziale nell'attuazione di Natura 2000.

1.2.1.3 Offrire prospettive
Ciò premesso più finanziamenti non possono cambiare il fatto che la situazione resta difficile, soprattutto per l'agricoltura di montagna, e non solo a causa del lupo. Oltre agli alti costi di produzione, oltre al forte aumento dei costi di mangime ed energia, si è aggiunta anche la mancanza d'acqua registrata la scorsa estate. L'industria lattiero-casearia si è quindi trovata in una situazione particolarmente difficile nel 2022. Lo scorso anno è stato concesso un sostegno finanziario straordinario alle aziende lattiero-casearie

per un totale di 14 milioni di euro per oltre 3.800 domande. Si tratta di una misura intesa ad attutire l'aumento dei costi e a rallentare la cessazione dell'attività di allevamento lattiero-caseario. A medio e lungo termine, tuttavia, l'allevamento da latte altoatesino avrà bisogno da un lato di una strategia comune più forte per risparmiare sui costi e sfruttare al meglio le capacità esistenti, e dall’altro di massimizzare il valore del marchio altoatesino e di conseguenza aumentare il livello di commercializzazione agricola.
1.2.2 Regolamento di mercato UE
L'UE vuole orientare l'agricoltura europea verso il futuro, quindi i programmi di sostegno dovrebbero essere resi ancora più sostenibili di prima. Non solo rafforza i requisiti ambientali, ma stabilisce anche un requisito minimo di equità sociale nei rapporti con i dipendenti. Le misure esistenti di intervento sul mercato saranno mantenute e integrate con misure per attuare e gestire requisiti sanitari e fitosanitari dei paesi terzi per facilitarne l'accesso ai mercati e misure di comunicazione per sensibilizzare e informare i consumatori. Anche nel programma operativo (PO) possono ora
essere previste misure di formazione, compresi l’orientamento e lo scambio di buone pratiche, in particolare per quanto riguarda le tecniche sostenibili di lotta contro gli organismi nocivi e le malattie, l’uso sostenibile dei prodotti fitosanitari e la mitigazione dei cambiamenti climatici. Nell'OCM ortofrutta, i programmi operativi (PO) per il miglioramento delle condizioni ambientali e climatiche devono prevedere almeno 3 misure corrispondenti e ciò per un importo complessivo del 15% del programma. Allo stesso modo, devono dedicare il 2% del loro PO alla ricerca e allo sviluppo di metodi di agricoltura sostenibile. Tuttavia, l'UE ha concesso agli Stati membri in materia di OCM ortofrutta un rinvio di ulteriori tre anni dell'applicazione della nuova strategia nazionale della PAC, di cui le nostre organizzazioni di produttori VIP e VOG si avvalgono. Vuol dire che sarà realizzato un Programma Operazionale 2023 – 2025 utilizzando ancora il vecchio regime. Nell'OCM vino, invece, scadrà nell'autunno 2023 il precedente programma nazionale di sostegno e partirà il nuovo programma nazionale di sostegno con misure solo leggermente diverse dalle precedenti. Per l'Alto Adige, ciò significa che gli investimenti nelle cantine e la promozione del vino nei paesi terzi continueranno ad essere effettuati attraverso l’OCM vino. Nei criteri di sostegno degli investimenti sono stati inseriti specifici criteri di preferenza per quelle cantine che gestiscono le proprie attività in modo sostenibile in termini di giustizia sociale e di consapevole tutela ambientale (uso parsimonioso di acqua, energia e materiali di consumo e di imballaggio).
1.2.2
1.2.3 Gestione del rischio
L’Alto Adige negli ultimi anni è stato percussore in Italia per quanto riguarda la gestione del rischio. Il Condifesa di Bolzano nell'ultima PAC 2014 – 2022 ha garantito una copertura assicurativa a più di 5300 agricoltori per un valore complessivo di circa 420 milioni di euro, facendo fronte ad un pagamento in premi pari a 44 milioni di euro. Il cambiamento climatico, l’aumento dei costi di produzione e il calo dei prezzi, pongono il settore agricolo davanti a nuove sfide. Il Ministero dell'Agricoltura italiano ha redatto anche per la prossima PAC un insieme di misure relative alla gestione del rischio con l’intento di sostenere gli agricoltori in
queste nuove sfide. In questo contesto, le misure nazionali per la gestione del rischio andranno ad attingere maggiormente dai sussidi forniti dall'Unione Europea nell'ambito del secondo pilastro. Anche livello nazionale la PAC 2023 – 2027 prevende il sostegno della gestione del rischio con uno stanziamento previsto di 3 miliardi di euro. Una novità assoluta è la copertura minimale dei rischi catastrofali (gelo, siccità, alluvione) attraverso un fondo mutualistico nazionale. Questo nuovo fondo AgriCat sarà formato in parte da quote private (30% dell'agricoltore) ed in parte da quote pubbliche (70% dello Stato).
1.3.1 Agenda forestale 2030
1.3 Agenda forestale 2030
Foreste
Nel corso dell'ultimo anno è stata sviluppata la strategia dell'Agenda forestale 2030 insieme ai proprietari delle foreste e ai loro rappresentanti nonché ai cittadini, in numerosi dialoghi e discussioni. Il bosco altoatesino è gestito da migliaia di aziende agricole e commerciali, assicurandone la cura e la conservazione. Questo non può essere dato per scontato e richiede perseveranza e pianificazione nel lungo termine. Il bosco, infatti, trascende le generazioni: un albero piantato oggi raggiungerà la maturità
molti anni dopo, e per questo motivo è particolarmente importante impostare già oggi la strada giusta per il domani. L'Agenda forestale Alto Adige 2030 è stata creata proprio in quest’ottica, con l’obbiettivo di tradurre in misure concrete gli obiettivi della strategia di sostenibilità della Provincia di Bolzano. La gestione forestale verso la naturalità, la promozione della filiera locale del legno, la tutela della biodiversità e delle specie sono pilastri importanti per costruire l'Alto Adige sostenibile del futuro. In tutta Europa, i proprietari privati e le amministrazioni pubbliche si adoperano per preparare il bosco alle sfide del futuro e per rafforzarlo in vista del suo importante effetto mitigatore per la protezione del clima, per la tutela della biodiversità e per la salvaguardia della qualità della vita. L’importanza delle foreste non conosce confini, infatti l'Agenda forestale non è un caso isolato. Essa integra e concretizza la strategia forestale nazionale per il settore forestale e le sue filiere produttive, nonché il pacchetto "Fit for 55" dell'UE, il Green Deal dell'UE e la Strategia forestale dell'UE per il 2030. Tutti hanno in comune un obbiettivo: un'agricoltura e una silvicoltura ad impatto climatico nullo.

1.3.2 Bostrico: serate informative ben frequentate
Oltre 800 persone hanno partecipato nell'autunno 2022 alle cinque serate informative organizzate con l'Assessore provinciale Arnold Schuler e il Direttore forestale provinciale Günther Unterthiner per affrontare il problema del bostrico. Nel frattempo, ben 6.000 ettari di foresta altoatesina sono stati infestati dall’insetto. Questi incontri sono stati organizzati per spiegare le cause dell'infestazione e il sostegno finanziario disponibile per combatterla. Proprietari e proprietarie boschive, ma anche semplici cittadini hanno partecipato a queste serate a Varna, Lagundo, Brunico, Nova Levante e Malles. Günther Unterthiner, direttore provinciale della Ripartizione Foreste, ha illustrato nel dettaglio le numerose misure di controllo del bostrico, sia quelle che sono già state intraprese sia quelle in fase di pianificazione da parte del servizio competente. La collaborazione tra l'autorità forestale e i proprietari di boschi è indispensabile per il controllo dello scolitide, perché le aree forestali colpite devono essere considerate singolarmente e le misure valutate ad hoc. Quasi il 60% delle nostre foreste ricade in aree con funzione di protezione; per questo

motivo alcuni alberi infestati devono essere lasciati momentaneamente in piedi, con l’obbiettivo di scongiurare rischi ulteriori per case, strade, linee ferroviarie e altre infrastrutture presenti. Va detto che, comunque, ogni situazione è diversa e per questo deve essere valutata individualmente. L'Assessore provinciale Schuler ha ricordato che dopo la tempesta "Vaia", negli ultimi 4 anni sono stati erogati complessivamente circa 60 milioni di euro di sussidi: 23,2 milioni per le misure "Vaia" per 2.915 „domande Vaia“, 18,2 milioni per le 6.050 domande pervenute relative al legname danneggiato e 24 milioni per i lavori in economia diretta. Per il futuro, l'Assessore provinciale ha annunciato l'adeguamento dei contributi per gli alberi esca (80 euro), nonché per il depezzamento (20 euro) e la scortecciatura (40 euro). Saranno adeguati anche i contributi per la manutenzione dei boschi di protezione. Il contributo per il legname danneggiato sarà aumentato in maniera consistente. È importante che tutti i circa 23.000 proprietari di boschi a livello provinciale facciano attivamente la loro parte, perché questa sfida potrà essere vinta solo insieme.
1.3.2
300.000 euro per la ricerca sul bostrico in
Alto Adige
L'Alto Adige sta combattendo l'infestazione da bostrico a tutti i livelli. La Libera Università di Bolzano e l’Eurac Research hanno presentato un progetto di ricerca che sarà finanziato dalla Provincia con 300.000 euro fino al 2025. Il Centro di competenza fitosanitaria dell'Università di Bolzano e l'Eurac Research stanno studiando la vita e la sopravvivenza del bostrico per acquisire nuove conoscenze sulla biologia e sul possibile controllo di questo parassita. Quali antagonisti naturali del bostrico – il più importante coleottero floematico dell’abete rosso attualmente diffuso nelle foreste altoatesine – sarebbero in grado di aiutare efficacemente l'uomo nel controllo di questo parassita forestale? Questa domanda è al centro di un progetto di ricerca che sarà avviato dal Centro di Competenza per la Salute delle Piante della Libera Università di Bolzano, dagli Istituti per l'Osservazione della Terra, l'Ambiente Alpino e il Centro per Sencing solution dell'Eurac Research, anche in collaborazione con l'Università di Padova, l’Universität für Bodenkultur (BOKU) di Vienna e il Dipartimento di Scienze Forestali. L'attuale proliferazione di massa del coleottero sta causando enormi danni alle foreste dell'Alto Adige. Il danno, tuttavia, va ben oltre alla svalutazione economica del legno: aumentano infatti anche i rischi per le infrastrutture pubbliche la cui sicurezza è minacciata dall'infestazione dei boschi di protezione. D’altro canto, è anche vero che il bostrico
non è solo un parassita. Fino a pochi anni fa, nelle foreste altoatesine c'era una bassa densità di questi coleotteri che attaccavano isolatamente gli abeti rossi indeboliti. Di conseguenza, questo parassita secondario – che normalmente non attacca gli alberi sani, perché essi possono difendersi efficacemente dall'infestazione – è in realtà un insetto benefico: fa morire gli alberi indeboliti e avvia così la decomposizione del legno morto. Gli schianti da neve e quelli da vento degli ultimi anni, tuttavia, hanno causato una quantità di legname danneggiato tale, che questo coleottero di debolezza è stato in grado di proliferare e diffondersi in modo massivo. Il progetto mira a indagare importanti aspetti della biologia dell’insetto anche per prevedere nel breve termine lo sviluppo della popolazione e trovare possibili antagonisti che possano limitarne lo sviluppo. Gli obbiettivi di medio termine, invece, sono quelli di definire metodi efficaci per individuare precocemente gli alberi infestati e quindi ridurre al minimo la pressione della popolazione sull’ecosistema forestale. Infine, nel lungo termine, si vogliono sviluppare strategie per ottimizzare l’adattamento delle foreste altoatesine ai cambiamenti climatici e alle loro conseguenze.
Nuovi approfondimenti sull'ecologia e la biologia del bostrico tipografo: due progetti Interreg
I progetti DolomIps e DolomIps2, portati avanti dalla Libera Università di Bolzano, in collaborazione con

1.3.3 Iniziative di ricerca: 300.000 euro per la ricerca sul bostrico in provinciaIl bostrico è responsabile della morte di molti alberi.
Sinistra: mosaico Sentinel-2 del 2020 mostrato in colori reali; centro: mosaico Sentinel-2 del 2022, in sovrapposizione le aree di riferimento dell'infestazione da bostrico rilevate sul campo (poligoni bianchi); destra: mosaico Sentinel-2 del 2022, in sovrapposizione i cambiamenti dovuti all'infestazione da bostrico rilevati automaticamente dai dati satellitari (azzurro: cambiamenti 2020 – 2021, blu: cambiamenti 2021 – 2022).

l'Università di Vienna e l'Università di Padova, sono stati finanziati dal programma Interreg V-A Italia-Austria 2014 – 2020 CLLD Dolomiti Live, che promuove e finanzia i progetti transfrontalieri nell'area dolomitica della Val Pusteria, Tirolo Orientale e Bellunese. In Alto Adige il progetto è stato cofinanziato e sostenuto anche dalla Ripartizione Foreste e dalla fondazione privata Hermann Rubner in qualità di partner del progetto. Lo scopo dei progetti è quello di ottenere una migliore comprensione della biologia e del complesso sistema che circonda il bostrico. Successivamente, sulla base delle conoscenze acquisite, saranno sviluppati metodi di lotta al bostrico tipografo. I progetti mirano ad approfondire le conoscenze relative a batteri e funghi associati a questa specie di scolitide. Ad esempio, si sa poco del ruolo svolto da funghi e batteri nel superare le difese degli alberi. È stato scoperto che, a differenza di molte altre specie di insetti, il bostrico è legato a pochissimi batteri, ma all`interno di una località esso è associato ad una grande varietá di batteri. Ci sono risultati simili per i funghi con cui sono associati i coleotteri. Sono stati trovati numerosi nematodi e acari associati al bostrico. Poco si sa invece del loro ruolo nei confronti dei coleotteri. Tuttavia, l'interazione di batteri, funghi, nematodi e acari sottolinea la complessa biologia di questo patogeno. Funghi, batteri, nematodi e acari sono già utilizzati con successo come antagonisti biologici in agricoltura. I ricercatori vedono il potenziale per trovare una strategia contro il bostrico promuovendo in modo specifico gli antagonisti.
Uno sguardo sui boschi altoatesini dallo spazio
A livello tecnico si sta svolgendo anche un altro progetto: il telerilevamento satellitare, utilizzato per individuare tempestivamente le infestazioni dello scolitide. L'idea e la realizzazione di questo progetto sono state avviate dalla ripartizione foreste. A questo scopo, gli scienziati dell’Eurac Research utilizzano il satellite Sentinel-2, inviato nello spazio nell'ambito del programma europeo Copernicus. Questo satellite è stato progettato per registrare dettagliatamente i cambiamenti sulla superficie terrestre in brevi intervalli di tempo. Il progetto mira a scoprire se questa tecnologia sia adatta a monitorare l'infestazione da bostrico, quali bande di lunghezze d'onda consentono di rilevare precocemente l'infestazione e quali intervalli temporali di analisi siano adatti a questo scopo. Con l'aiuto di questo sistema satellitare verrà inoltre creata la base per una nuova mappa delle foreste di protezione. Nella parte conclusiva del progetto, verrà utilizzato un modello di simulazione del paesaggio forestale per illustrare gli scenari futuri di evoluzione delle foreste sotto l'influenza dei cambiamenti climatici, dei disturbi naturali come i danni causati dal vento, ma anche della gestione antropica delle foreste. Il simulatore ha dei propri parametri per ricreare l’evoluzione delle infestazioni del bostrico e il modo in cui i danni da esso causati potrebbero cambiare in presenza di un crescente stress idrico e di disturbi da vento. I dati di questo progetto saranno utilizzati anche per migliorare la modellazione dell’impatto del bostrico e fornire raccomandazioni per la gestione delle foreste.
1.3.3
Berichte der Abteilungen und Ämter Relazioni delle ripartizioni e degli uffici
2.

Nell’ambito dell’Amministrazione Provinciale la Ripartizione Agricoltura viene intesa come un’organizzazione amministrativa e di servizio a favore dell’agricoltura orientata alle esigenze dei nostri clienti e partner. Il nostro proposito è quello di voler contribuire nel modo migliore ad accrescere la competitività nonché la sostenibilità ambientale e sociale del settore agricolo. La coltivazione del territorio nella sua complessiva diversità, la produzione di alimenti di alta qualità, la creazione di un reddito adeguato per gli agricoltori e il cambiamento strutturale del mondo agricolo verso la multifunzionalità sono i più importanti obiettivi. Contemporaneamente dovrebbe essere conservato ciò che fino ad oggi si è affermato. Per questo motivo, oltre alle funzioni pubblico amministrative e di vigilanza, la sfera di competenze della ripartizione si estende anche all’erogazione di interventi di consulenza mirata e ad un’efficiente ed effettiva attuazione della politica agricola di sostegno. Competenze sociali e professionali sono i migliori presupposti per raggiungere concretamente tutti questi obiettivi. Le seguenti pagine della Relazione agraria forestale riportano le singole aree di attività, e in dettaglio i più importanti risultati e tanti numeri riferiti all’anno passato.
2.1 Agricoltura parte generale e agevolazioni
2.1.1 Zootecnia
L’anno 2022 è stato un anno molto secco, con perdite per lo più consistenti nella produzione di foraggio. La qualità del fieno è stata complessivamente soddisfacente. Questo vale per tutti i tagli. L’autunno è andato bene, tanto che il bestiame di ritorno dai pascoli ha potuto essere tenuto al pascolo. Per quanto riguarda la commercializzazione del bestiame, i prezzi dei bovini da macello, da ingrasso e dei vitelli sono stati estremamente buoni nel 2022. Anche per i capi iscritti al libro genealogico di tutte le razze, l’anno
scorso sono stati raggiunti prezzi medi più alti rispetto all’anno precedente. Per quanto riguarda la commercializzazione, si è registrato un leggero aumento del numero di animali commercializzati. Il numero di 39.153 animali commercializzati significa un aumento di 606 capi. Il prezzo medio dei bovini è aumentato del 25,3%, raggiungendo i 1.084,12 €, e il numero di bovini commercializzati è aumentato di 1.170 capi, per un totale di 10.780 capi. Il prezzo medio di vendita dei vitelli e dei cavalli è stato leggermente inferiore a quello dell’anno precedente (vitelli -3,5%, cavalli -3,3%). Per gli animali di qualità e gli ovicaprini il prezzo medio di vendita è stato leggermente superiore (animali di qualità +5,5%, ovicaprini +1,9%).

Per quanto riguarda l’apicoltura, la resa è stata superiore alla media in quasi tutte le zone della provincia. La primavera mite e l’estate calda hanno favorito lo sviluppo delle colonie in modo tale da rendere disponibili molte api bottinatrici che hanno riempito rapidamente i melari.
Nella campagna lattiero-casearia da luglio 2021 a giugno 2022, le 4.490 aziende altoatesine produttrici di latte (97 in meno rispetto all’anno precedente) hanno consegnato una media di 33,82 milioni di kg al mese e una quantità totale di 405,79 milioni di kg di latte. Ciò rappresenta una diminuzione del -0,96% rispetto allo stesso periodo dell’anno precedente.
Allevamento
Consistenza delle razze bovine in Alto Adige 2022

Il seguente grafico illustra la consistenza delle diverse razze bovine allevate in Alto Adige.
Attività del libro genealogico
La Federazione Provinciale Allevatori Razza Bruna assiste gli allevatori delle razze Bruna, Jersey e Bruna Originale.
La Federazione Sudtirolese Allevatori Razze Bovine assiste gli allevatori delle razze Grigio Alpina, Holstein, Pinzgauer, l Pezzata Rossa, Pustertaler Sprinzen, Angus, Highlands, Galloway e Blu Belga.
Commercializzazione del bestiame – Prezzi alle aste
Il consorzio per la commercializzazione del Bestiame nel 2022 ha tenuto in totale 87 aste, di cui 43 per bestiame da macello (26 a Bolzano e 17 a San Lorenzo di Sebato) nonché 44 aste per vitelli. In totale sono stati venduti 39.153 capi, di cui 466 sul programma di qualità della carne in Alto Adige.

«« Per informazioni dettagliate sui prezzi alle aste per bestiame da allevamento vedi fig. 1 a pag. 208, nonché per bestiame a macello e per vitelli vedi tab. 2 a pag. 209.
Inseminazione artificiale
Nell’anno di riferimento sono state eseguite 56.394 prime inseminazioni. Equivale ad una diminuzione di 1.763 unità rispetto all’anno precedente.
Il numero delle inseminazioni eseguite da fecondatori laici aziendali è in costante calo.
«« Per informazioni dettagliate sull’inseminazione artificiale vedi tab. 3 a pag. 209.
Dati sulle inseminazioni – Confronto dell’anno scorso
Monta naturale
Ai sensi del D.Lgs. n. 52 del 11. maggio 2018, nell’anno 2022 sono state approvate 36 nuove stazioni di monta pubblica.
«« Ulteriori dettagli sulla monta naturale vedi tab. 4 a pag. 209.
La tabella seguente riporta i risultati dei controlli funzionali per il periodo 2021/2022 effettuati dall’Associazione Provinciale Allevatori.
Produzione lattiera
Produzione e trasformazione del latte
Latte bovino
Nella lavorazione e commercializzazione del latte si sono registrati i seguenti cambiamenti: la produzione del formaggio è cresciuta del 6,5 % a 22,7 milioni kg, mascarpone e ricotta sono calati del 5 % a 11,73 milioni kg. Anche la produzione di yoghurt e skyr è cresciuta del 5,7 %. Le vendite di latte fresco sono rimaste costanti a 17,8 mi-
lioni di kg, di cui latte fieno 14,1 milioni kg e 2,02 milioni kg latte fieno bio.
Latte caprino
Il conferimento di latte caprino è calato del 10,5 % ed è arrivato a 1,43 milioni kg. Sono stati prodotti 49.554 kg di latte fresco, 54.231 kg di formaggio, 31.478 kg di yoghurt e 1.722 kg di burro.
* N.B: Al momento della redazione di questa relazione non era ancora stato stabilito il prezzo di liquidazione per il 2022.
Prezzo del latte: sviluppo dal 2006 al 2021
Trasformazione del latte nel periodo 2003/04 al 2021/2022
Sviluppo della quantità di latte consegnata alle latterie altoatesine nel periodo 2003/2004 al 2021/2022
Sviluppo delle aziende produttrici di latte e che consegnano latte a latterie altoatesine nel periodo 2003/2004 al 2021/2022
Allevamento equino
Dei cavalli registrati appartengono 3.465 alla razza Haflinger o Norico. Queste due razze di cavalli vengono assistiti dalla Federazione Provinciale Allevatori Cavalli Haflinger dell’Alto Adige. L’ufficio zootecnia amministra le stazioni di monta pubbliche e controlla se le analisi sanitarie prescritte sugli stalloni vengano eseguite annualmente.
Consistenza Haflinger e Norici 2022

Allevamento di ovini e caprini
In Alto Adige circa 4.900 aziende si dedicano all’allevamento di ovini e/o caprini.
La Federazione zootecnica Alto Adige assiste 1.970 membri che sono organizzati in 48 associazioni locali di allevatori di ovini e 11 associazioni di allevatori di caprini.

Aste ovini e caprini 2022
Sono state organizzate tutte e tre le aste previste. Nelle tre aste sono stati venduti complessivamente 199 ovini e 281 caprini. I prezzi non si sono ancora ripresi dopo la crisi dovuta a Covid. La causa è sicuramente anche l’aumento dei grandi predatori e la conseguente paura di predazione. Sfortunatamente, quindi, si investe poco nell’allevamento! I prezzi degli agnelli e dei vitelli sono invece aumentati. Uno dei fattori è sicuramente la diminuzione del numero di ovini e di caprini, con un conseguente calo della produzione di agnelli e capretti!
«« Informazioni dettagliate sull’allevamento di ovini e caprini in Alto Adige nonché sulle aste di ovini e caprini vedi tab. 5 e 6 a pag. 210.
Allevamento di galline ovaiole
In Alto Adige 86 aziende producono uova fresche per la vendita a rivenditori secondo le direttive UE del sistema all’aperto, della produzione biologica e del sistema a terra.
L’allevamento di galline ovaiole in gabbia è vietato in Alto Adige con la legge provinciale sulla tutela degli animali.

Il numero di galline ovaiole presenti in aziende varia tra i 500 ed i 6.000 capi.

76 aziende hanno un proprio centro d’imballaggio riconosciuto per la raccolta, classificazione e imballaggio delle uova, che permette la commercializzazione delle uova al dettaglio.
Le uova prodotte vengono vendute quasi esclusivamente sul mercato altoatesino, la commercializzazione viene eseguita in maggioranza diret-
Macello e animali da macello
Nell’anno 2022 la Federazione Zootecnica dell’Alto Adige, che gestisce il macello di Bolzano conforme alle disposizioni UE, ha eseguito la macellazione di 17.626 capi delle specie bovine, suine, equini, ovine e capre.
Nell’anno scorso è stata commercializzata la carne di 10.393 ovini e agnelli, nonché 3.939 caprette e capre. Acquirenti principali in Alto Adige sono le grandi catene di commercio alimentare.
tamente dal produttore al negoziante e in parte tramite cooperativa.
Anche per l’anno 2022 la richiesta di uova fresche da produzione alterna-
tiva nostrana è stata soddisfacente, sebbene l’inflazione e i suoi effetti si siano fatti sentire anche in questo settore.
Apicoltura
Dopo diverse annate con produzioni di miele scarse o addirittura pessime, le apicoltrici e gli apicoltori dell’Alto Adige ricorderanno il 2022 come un’annata con una produzione di miele eccezionalmente buona. Anche se l’inverno relativamente caldo e con poche precipitazioni non lasciava presagire una buona annata del miele, fortunatamente tutto è andato diversamente. Il clima estremamente caldo e secco ha aiutato le colonie di api a svilupparsi bene. Sorprendentemente la raccolta di melata è iniziata già a metà maggio e i melari si sono riempiti molto prima del solito.
La fine prematura e brusca della raccolta di miele a metà/fine giugno non ha potuto sminuire la buona annata di miele. Il raccolto di rododendro è rimasto un po’ al di sotto delle aspettative. È stato di breve durata a causa del clima caldo e secco ed è svanito in tempi relativamente brevi.
A parte alcune eccezioni locali, la produzione di miele in Alto Adige nel 2022 è stata significativamente superiore alla media a lungo termine.
Negli ultimi anni si è riuscito a contenere la perdita del numero di apicoltori e alveari del decennio passato. Nell’anno 2022 il numero si è mantenuto costante, anzi si può notare un leggero aumento sia di apicoltori che di alveari.
La diminuzione del passato non era sicuramente dovuta soltanto alla varroa ma anche al mancato rinnovo genera-

zionale al quale si è cercato di reagire con molte iniziative.
Con un vasto programma di informazione degli apicoltori e con la scuola per gli apicoltori “Südtiroler Imkerschule”, nata nel 2007, si è riusciti a formare una nuova generazione di apicoltori. L’interesse per i corsi supera le aspettative e può dare speranza in uno sviluppo del settore.
La pandemia di Covid 19 e le conseguenti restrizioni purtroppo hanno fortemente limitato i corsi di formazione previsti anche nel 2022.
Misure a favore del settore zootecnico
Nell’anno 2022 sono stati concessi aiuti a favore del settore zootecnico nell’ammontare totale di 25.580.090,74 €. Le varie misure compreso l’importo di finanziamento e i
Contributi per Federazioni Zootecniche (LP dd. 14.12.1999, n. 10, art. 5)
Riepilogo dei contributi 2022
beneficiari sono visibili nelle seguenti tabelle:
Contributi per l’apicoltura e per agevolazioni per meccanizzazione interna, nonché la trasformazione e la commercializzazione dei prodotti agricoli nel settore zootecnico
(Legge provinciale del 14 dicembre 1998, n. 11)
Agevolazioni per investimenti nella zootecnia 2022
Contributi a latterie e caseifici sociali
Per i contributi nel settore lattiero caseario trova applicazione la legge Provinciale n. 10, art. 4 del 14 dicembre 1999.
Aiuti a favore del benessere animale per gli allevatori
La legge provinciale del 14 dicembre 1998, n. 11, prevede all’articolo 4, comma 1, lettera g) la possibilità di concedere degli aiuti al sostegno del
benessere e della salute animale a beneficiari di imprese agricole, singole o associate, con sede operativa in provincia di Bolzano.
Aiuti per compensare gli svantaggi logistici nella consegna di latte di qualità in zona di montagna (Legge provinciale n. 10/1999)
Aiuti per compensare gli aumenti di costi per la produzione latte
Contributi concessi 2022
Aiuti per la coltivazione ecologica di cereali (Legge provinciale n. 11/1998)
Concessione di un aiuto per uccelli che nidificano a terra nella landa di Malles (Legge provinciale n. 11/1998)
Contributo concessi 2022
Contributo concessi 2022
Contributi concessi 2022
Aiuti per il miglioramento della zootecnia
Contributi concessi 2022
Assicurazione bestiame –Concessione di aiuti per la copertura assicurativa nel settore zootecnico (L.P. n. 11 del 14.12.1998)
Beneficiari
• Imprenditori agricoli
• Consorzi di cui all’articolo 11 del D.Lgs. n. 102/2004
• Compagnie di assicurazione e di brokeraggio di assicurazione
• Associazioni agrarie di cui alla legge provinciale n. 9, del 27 aprile 1995.
Tipologie di perdite assicurabili
Copertura di perdite di bovini, equini, ovini e caprini dovute a malattia e
ad infortunio, a seguito di epizoozie o infestazioni parassitarie o di avversità atmosferiche assimilabili alle calamità naturali e altre condizioni atmosferiche avverse.
Tipologia e ammontare dell’aiuto
Contributo in conto capitale fino al 50 per cento delle spese ammissibili per il pagamento dei premi assicurativi. I premi assicurativi finanziabili si possono riferire ad un valore di stima massimo pari a 2.000,00 euro per i bovini ed equini, e a 400,00 euro per gli ovini e caprini.
Misure a sostegno dell’apicoltura ai sensi del regolamento (CE)
n. 1308/2013 - disposizioni speciali relative al settore dell’apicoltura
Aiuti nel settore dell‘apicoltura –Reg. (UE) n. 1308/2013
Il programma annuale 2022 della Provincia Autonoma di Bolzano ha interessato le seguenti misure a sostegno dell’apicoltura:
in euro
Attività di controllo
Nell’ambito delle attività di controllo (aiuto a favore del benessere animale, contributi per investimenti, contributi per federazioni, mutua assicurazione del bestiame e il miglioramento della
zootecnia), a causa della situazione del Coronavirus solo le ispezioni locali più necessarie sono state effettuate dall’Ufficio Zootecnia.
«« Ulteriori informazioni, le norme e la modulistica per le domande sono disponibili sul sito: www.provincia.bz.it/agricoltura e-mail: zootecnia@provincia.bz.it
Malattie infettive e diffusive degli animali
Alla fine dell’anno il territorio della Provincia di Bolzano era in possesso del riconoscimento comunitario quale territorio indenne da diverse malattie infettive dei bovini, degli ovini, dei caprini e dei suini. Si è trattato di malattie quali tubercolosi bovina, brucellosi bovina e leucosi bovina enzootica, rinotracheite infettiva bovina (IBR), brucellosi ovicaprina, Blue Tongue (infezione da BTV), malattia di Aujeszky dei suini.
Di seguito si elenca la rispettiva base legale:
• Regolamento di Esecuzione (UE) 2021/620 della Commissione del 15 aprile 2021 recante modalità di applicazione del regolamento (UE) 2016/429 del Parlamento europeo e del Consiglio per quanto riguarda l’approvazione dello status di indenne da malattia e dello status di zona di non vaccinazione di alcuni Stati membri o di loro zone o compartimenti in relazione ad alcune malattie elencate e all’approvazione dei programmi di eradicazione per tali malattie elencate
Le principali attività, svolte dal 1° gennaio al 31 dicembre, si possono riassumere come segue:
«« Per maggiori informazioni sulle singole malattie infettive e sulle misure di prevenzione e metodi di analisi vedi fig. 2 – 8 a pagine 211 – 213.
Malattie infettive dei suini
(PSA) 2021
Influenza aviaria
Ai fini della sorveglianza dell’influenza aviaria si applica la sorveglianza passiva ed attiva secondo le modalità previste dal piano di sorveglianza nazionale. Nella sorveglianza attiva i veterinari ufficiali prelevano campioni di sangue. La sorveglianza passiva consiste nella segnalazione di casi anomali di moria di uccelli (soprattutto uccelli acquatici).
Il Piano di sorveglianza nazionale è stato avviato nel 2005. A partire dal 2015 la sorveglianza attiva è obbligatoria, grazie al ridotto rischio di insorgenza dell’infezione, nei soli allevamenti di svezzamento.
Malattie infettive dei pesci
Il programma della Provincia di Bolzano relativo al controllo delle malattie dei pesci più comuni, cioè della setticemia emorragica virale (VHS), della necrosi ematopoietica infettiva (IHN), nonché della necrosi pancreatica infettiva (IPN), è stato approvato dalla Comunità Europea con Decisione 2002/304/CE.
Disinfezioni eseguite su animali e strutture
della zoppina negli ovini Disinfezioni (soprattutto
da maggio 2021 nessun campione di sangue, solo campioni di tessuti previsti dal piano italiano di sorveglianza e prevenzione della Peste suina africana
Encefalopatie spongiformi trasmissibili
L’Istituto Zooprofilattico Sperimentale delle Venezie esegue i controlli per Encefalopatie spongiformi trasmissibili (TSE), tramite il cosiddetto test rapido, su bovini, ovini e caprini macellati, macellati d’urgenza o morti in stalla, appartenenti alle fasce di età previste dalla legge.
Sugli ovini in vita viene implementato in Provincia di Bolzano, in base alle disposizioni nazionali, un programma per la genotipizzazione. Si punta ad aumentare la resistenza alla TSE ricorrendo alla riproduzione selettiva.
Rabbia
Il sistema di allerta della Provincia di Bolzano prevede che tutte le volpi, i tassi e le martore rinvenuti morti sul territorio provinciale devono essere consegnati presso i centri di raccolta. Le carcasse raccolte vengono inoltrate al Centro di referenza nazionale per la rabbia che ha sede presso l’Istituto Zooprofilattico Sperimentale delle Venezie di Legnaro (PD) per essere esaminate relativamente alla rabbia. Inoltre devono essere immediatamente denunciati al veterinario ufficiale competente tutti i casi clinici sospetti e tutti i casi che facciano sospettare la presenza della rabbia. Ciò vale per tutte le specie animali.
L’Alto Adige è considerato zona indenne dalla rabbia ai sensi del Regolamento di Esecuzione (UE) 2021/620 della Commissione del 15 aprile 2021 recante modalità di applicazione del regolamento (UE) 2016/429 del Parlamento europeo e del Consiglio per quanto riguarda l’approvazione dello status di indenne da malattia e dello status di zona di non vaccinazione di alcuni Stati membri o di loro zone o compartimenti in relazione ad alcune malattie elencate e all’approvazione dei programmi di eradicazione per tali malattie elencate.
Prodotti alimentari di origine animale
Campionamento
negli allevamenti conferenti
latte in collaborazione con la Federazione Latterie Alto Adige
Mangimi
«« Per informazioni dettagliate sul piano nazionale per la ricerca di residui (PNR) vedi tab. 8 a pag. 214.
«« Ulteriori informazioni, le norme e la modulistica per le domande su malattie infettive e prodotti alimentari di origine animale sono disponibili sul sito: www.provincia.bz.it/agricoltura
e-mail: vet@provincia.bz.it vet@pec.prov.bz.it
2.1.2 Frutticoltura
Il raccolto del 2022 di 862.145 tonnellate è stato il sesto consecutivo al di sotto del milione. Inoltre è stato più basso alla stima (912.800 t) e uno dei più bassi rispetto ai decenni precedenti.
Le cause principali delle riduzioni negli ultimi anni sono state una quota di rinnovo più elevata e la riduzione della superficie di produzione a favore della viticoltura. Il 2022 inoltre ha portato un’estate e un autunno caldi con scarse precipitazioni, che hanno avuto un impatto negativo su qualità e calibro in particolare per la varietà Gala.
La quota della merce d’industria ammonta all’11% circa per cui risultano 765.300 t di merce da tavola. La prima posizione la ricopre sempre la Golden Delicious, seguita da Gala e Red Delicious.


L’Alto Adige ha un potenziale per avere raccolti di circa 1 milione di tonnellate, che corrisponde al 10% del raccolto europeo. Però, come abbiamo visto
negli ultimi anni, a medio e lungo termine diventerà sempre più difficile raggiungere effettivamente questo marchio.
Rispetto all’anno precedente le esportazioni verso l‘America del Sud e l’America Centrale si sono triplicate. Tuttavia, i Paesi arabi sono rimasti, con il 54% dei carichi di mele esportate verso paesi terzi, le destinazioni più importanti per le mele dell’Alto Adige.
Con complessivamente “solo” 52 casi si può considerare il 2022 come un anno relativamente tranquillo per quanto riguarda il Colpo di fuoco batterico. Tuttavia, sono stati riscontrati casi in tutte le aree frutticole della Provincia.
La superficie coltivata a fragola nel 2022 è diminuita notevolmente del 30% rispetto all’anno precedente. La maggior parte delle colture a piccoli frutti ha subito un calo della superficie di produzione con l’esclusione di quella dei mirtilli, che ha segnato un aumento quasi del 20%.
Il raccolto complessivo di albicocche, pari a 290 t, non è stato scarso come l’anno prima, ma nettamente sotto la media degli anni precedenti.
Le grandi quantità di ciliegie raccolte nei mesi di giugno/luglio hanno causato un crollo dei prezzi, che tuttavia si sono ripresi e stabilizzati verso agosto e leggermente aumentati verso la fine della stagione commerciale.
Coltivazioni di melo e di pero
Suddivisione delle superfici
Rispetto all’anno 2021 si riscontra ancora una leggera diminuzione della superficie totale, una tendenza che si nota da alcuni anni. Seguono i dettagli:
Consistenza delle varietà più importanti in Alto Adige (ettari)













Superficie delle varietà in Alto Adige
La quantità stimata dall’UE per il raccolto 2022 risulta leggermente superiore a quello del 2021, che a sua volta era simile a quello del 2020. Tuttavia, è necessario distinguere fra mela e pera: il raccolto di mele aumenterà leggermente mentre quello di pere aumenterà drasticamente dopo il raccolto estremamente basso dell’anno precedente.
La Polonia rimane leader nella produzione europea di mele con ca. 4.495.000 t (+5% in confronto a 2021), seguita da Italia (2.150.000 t, +5%), Francia (1.468.000 t, +6%), Germania (1.067.000 t, +6%), Spagna (431.000t, -23%) e Ungheria (350.000 t, -33%).
Riguardo alle varietà nella classifica della produzione europea la Golden ricopre la prima posizione con 2,06 mio t (-5% rispetto l’anno precedente), seguono Gala con 1,61 mio t (+2%), il gruppo Jonagold con ca. 1,24 mio t (+4%), Red Delicious con 0,70 mio t (+3%), Idared con ca. 0,66 mio t (-10%), Shampion con 0,46 mio t (-2%), Granny Smith con 0,37 mio t (+8%) e Elstar con 0,36 mio t (+9%).
Fuori dall’UE, la Turchia diventa sempre più importante nell’settore del commercio della mela. Per la Turchia è previsto una produzione con circa 4 mio t, un raccolto relativamente alto.
Per la produzione europea di pere è previsto con circa 2,1 milioni tonnellate un raccolto più alto in confronto all’ultimo anno, che raggiunge di nuovo il livello di 2020.
Nel mese di agosto 2022 è stato stimato per l’Alto Adige una raccolta di 912.803 t.
I frutticoltori biologici altoatesini nell’anno di riferimento hanno riscontrato una riduzionene dei quantitativi prodotti. Il raccolto di 85.643 t ha portato una riduzione di ca. 12.220 t. Il quantitativo biologico realmente prodotto è sicuramente ancora più alto, perché le mele delle aziende in conversione e quelle della raccolta dei filari di bordo non possono essere conferite come produzione biologica.
«« Per ulteriori informazioni su prezzi medi al produttore per il raccolto di varietà da tavola 2021 vedi tab. 10 a pag. 215.
Certificazione export
Nel 2022 gli ispettori del Servizio fitosanitario hanno rilasciato, in seguito ai controlli previsti dalla normativa di riferimento, complessivamente 8541 certificati fitosanitari per l’export di vegetali e prodotti vegetali verso 59 Paesi terzi. Circa il 96% dei certificati sono stati emessi per l’export di mele. I restanti certificati sono stati rilasciati per l’export di materiale vivaistico e legname, nonché prodotti in legno. La quantità totale di mele esportata ammonta a 154.371 tonnellate che corrisponde a un aumento complessivo del 26% rispetto all’anno precedente. Nell’anno 2022 i 5 mercati di destinazione più rilevanti per le mele dell’Alto Adige sono stati Arabia Saudita, India, Norvegia, Egitto e Israele con complessivamente 107.965 tonnellate, rappresentando il 77% delle esportazioni. Rispetto all’anno precedente le esportazioni verso l‘America del Sud e l’America Centrale si sono triplicate. Tuttavia, i Paesi arabi sono rimasti, con il 54% dei carichi di mele esportate verso paesi terzi, le destinazioni più importanti per le mele dell’Alto Adige.
«« Per maggiori informazioni sull’export di mele verso Paesi terzi vedi tab. 11 a pag. 215.

Situazione Colpo di fuoco batterico e Cimice Asiatica
Con complessivamente “solo” 52 casi si può considerare il 2022 come un anno relativamente tranquillo per quanto riguarda il Colpo di fuoco batterico. Tuttavia, sono stati riscontrati casi in tutte le aree frutticole della Provincia.
Anche quest’anno sono state infettate principalmente piante di melo, ma al contrario dell’anno precedente, i nuovi impianti e gli impianti in produzione sono stati colpiti più o meno nella stessa misura.
La maggior parte dei casi è stata registrata in Val Venosta, dove solo nel comune di Lasa sono stati accertati 22 casi e dove si è dovuto estirpare un impianto di pero in produzione.
A Lasa sono state inoltre registrate numerose piante di biancospino colpite in una siepe lungo la strada statale. Le piante sono state immediatamente estirpate e bruciate.
Monitoraggio di organismi nocivi da quarantena in Alto Adige
Per la prevenzione contro l’introduzione e la diffusione di organismi nocivi da quarantena la legislazione dell’Unione Europea richiede indagini annuali. Nell’ambito del programma di monitoraggio devono essere dettagliatamente programmate le attività previste che poi devono essere comunicate al Servizio fitosanitario centrale e al Ministero dell’Agricoltura. Il Piano per il 2022 è stato rispettato in tutte le sue parti e in alcuni punti è stato addirittura superato.
Nel complesso sono stati sorvegliati 73 organismi nocivi da quarantena. Di questi, 4 sono già presenti sul territorio della Provincia di Bolzano o limitati ad alcune zone. Per quanto riguarda
«« Per ulteriori dettagli su comuni con casi accertati di Colpo di fuoco batterico vedi tab. 12 a pag. 216.
Cimice Asiatica
Dal 2017 viene svolto il monitoraggio della cimice asiatica a livello provinciale e questo è continuato anche nel 2022. In stretta collaborazione tra il Centro di Sperimentazione Laimburg, il Centro di consulenza per la fruttiviticoltura dell’Alto Adige, il Centro di Consulenza per l’agricoltura montana BRING e il Servizio fitosanitario sono state installate, e controllate settimanalmente, su tutto il territorio altoatesino 38 trappole a feromoni.


In seguito a quest’attività sono state catturate oltre 4600 cimici adulte e ulteriori 6400 giovani, detti “neanidi”.
In aggiunta alle trappole convenzionali sono state installate 4 trappole di nuova generazione. La particolarità di questi nuovi modelli sta nell’attrarre le cimici, oltre che con i consueti feromoni, anche tramite vibrazioni. L’energia necessaria viene prodotta da una pic-
cola cella fotovoltaica montata sulla trappola stessa.
I danni ai frutti causati dalla cimice asiatica sono stati complessivamente limitati. Secondo le stime dei tecnici del Centro di Consulenza per la frutti-viticoltura dell’Alto Adige solo in casi isolati sono stati riscontrati danni a doppia cifra. Nel complesso la percentuale si attesta a meno del 1%.
questi organismi già presenti, quali ad esempio la Flavescenza dorata della vite e il Colpo di fuoco batterico, verrà fatto un resoconto separato. Per questi patogeni esistono inoltre delle prescrizioni specifiche.
I controlli richiesti sono stati distribuiti su tutto il territorio provinciale. In questo modo sono state ispezionate circa 130 specie di piante in diverse aziende e contesti ambientali (p.e. garden center, vigneti, verde urbano). Il più grosso impegno è rappresentato dalle ispezioni visive (4000). Oltre a ciò, sono state effettuate circa 1470 ispezioni nell’ambito del controllo delle 82 trappole attrattive e 546 campionamenti per analisi di laboratorio. A seguito di questi controlli non sono stati riscontrati nuovi organismi nocivi da quarantena in Alto Adige.
RUOP e Passaporto delle Piante
Al 31.12.2022 nel Registro Ufficiale degli Operatori Professionali (RUOP) erano iscritte 288 aziende con sede legale in Alto Adige. Com’era prevedibile il numero delle nuove iscrizioni è in continua diminuzione. Se nel 2021 sono state registrate 57 nuove aziende, nel 2022 sono solamente 15 le iscrizioni. Il numero delle cancellazioni è rimasto tut-
Piccoli frutti





to sommato stabile (10). Tre di queste cancellazioni sono dovute a passaggi di proprietà o modifiche della forma giuridica e di conseguenza sono state immediatamente reinserite con una nuova registrazione. Delle nuove aziende registrate, 7 sono attive nell’import/ export, 6 aziende producono piante e 2 sono state autorizzate ad apportare il marchio volontario secondo lo standard ISPM15 (FITOK) sugli imballaggi di legno.
Riguardo al Passaporto delle Piante, tra novembre 2022 e gennaio 2023 sono state controllate 55 aziende. Durante questi controlli non sono state riscontrate irregolarità.
17 ha
Mirtilli 18 ha
Con l’inverno poco nevoso del 2021/22 lo svernamento di tante colture a piccoli frutti è stato debole. Tante piantine di fragole sono state sostituite, mentre ci si aspettava un mancato raccolto di lamponi e mirtilli. Per fortuna si sono verificate poche gelate notturne in primavera. L’anno restante è stato segnato da precocità nello svi-
75 ha
luppo e caratterizzato da temperature elevate e mancanza di precipitazioni. A causa dell’inizio molto precoce della vegetazione si sono potuti raccogliere i frutti anche molto presto.

Il caldo persistente ha causato diametri piccoli delle bacche, fatto che si è percosso negativamente sul volume della raccolta.
Campionamento ufficiale in vivaio di piante ortive e ornamentali 2.1.2
2
ha
3 ha
Del resto la qualità della frutta, a causa della siccità, era molto buona e non ci sono stati problemi particolari con le più frequenti malattie fungine. In compenso si è fatta notare di nuovo la presenza del moscerino dei piccoli frutti (Drosophila suzukii) e di altri parassiti.


Fragole: il raccolto con piante svernanti e della produzione programmata è stato al di sotto della media pluriennale; le piante svernanti hanno avuto una produzione di 150-250gr/ pianta circa di prima qualità (grandi frutti) e la produzione programmata ha registrato 100-220 gr/pianta circa di prima qualità (bacche molto piccole, con grande disugualianza tra le singole aziende). Le varietà rifiorenti hanno avuto una produzione di 300400g/pianta.

Il ricavato è stato molto buono, risultando per il 15-20% sopra alla media dell’anno precedente.
Lamponi: la produzione è risultata sotto la media. A causa della siccità invernale si sono dovute registrare anche perdite totali. Nel complesso è stata raccolta solo la metà della produzione prevista. Il ricavato è risultato nella media degli anni passati
Ribes: hanno raggiunto nell’anno di commercio 2022 di nuovo un prezzo buono che risulta nella media pluriennale. Anche la resa è risultata nella media.
Mirtilli: dove non si sono verificate grandi perdite dei germogli per la siccità, la quantità di raccolto nelle zone basse è stata molto buona, debole invece in altitudine. I prezzi sono diminuiti notevolmente a causa dell’offerta crescente.
Commercializzazione
La richiesta sui mercati è stata di nuovo ottima, come di consueto da più anni senza interruzione. I prezzi ricavati nell’anno 2022 sono stati di nuovo molto buoni e, ad eccezione dei mirtilli, per lo più sopra la media pluriennale.
La maggior parte della produzione di piccoli frutti realizzata in Alto Adige viene commercializzata tramite la Cooperativa dei produttori della Val Martello e tramite le aste di frutta dell’Egma di Vilpiano, prevalentemente nella zona settentrionale dell’Italia, ma anche a livello regionale con la vendita al dettaglio. Fa eccezione una grande azienda nella zona di Bressanone, con luoghi di produzione in Alta Val d’Isarco e in Pusteria, che rifornisce prevalentemente supermercati italiani e in parte anche supermercati esteri.

Tante aziende vendono il proprio prodotto direttamente al consumatore tramite attività agrituristiche o mercati contadini. Ormai quasi tutti i mer-

Drupacee
Coltivazione dell’albicocco
In Val Venosta, la superficie degli impianti di produzione, con commercializzazione centralizzata tramite Vi.P, è pari a 59 ettari. Ulteriori superfici, soprattutto in forma di allevamento estensivo, vengono commercializzate tramite mercati contadini e vendita diretta al maso e di conseguenza la superficie totale ad albicocche nell’anno di riferimento, in leggera tendenza negativa rispetto all’anno precedente, ha raggiunto circa 81 ettari.

L’anno 2022 si è dimostrato un anno particolare per la coltivazione di albicocche. All’inizio caratterizzato da una buona impollinatura e fioritura, nel periodo primaverile si sono verificate meno gelate tardive in confronto all’anno precedente, ma con il mese di giugno si è verificato una notevole “cascola dei frutti” e la siccità durante l’intera stagione vegetale ha causato dei calibri dei frutti sotto la media.
Il raccolto complessivo in Val Venosta, pari a 290 t, non è stato scarso come
l’anno prima, ma sotto la media degli anni precedenti.
Il periodo di raccolta, a causa delle temperature molto elevate, è avvenuto contemporaneamente in tutte le diverse aree di coltivazione.
Fitopatologie Nell’anno di riferimento sono stati osservati meno danni causati da batteriosi (Pseudomonas) eccetto per la varietà Goldrich, dove si sono manifestate elevate infestazioni
della frutta. Le problematiche principali come la monilia, la ruggine e il corineo sono state tenute sotto controllo. Patogeni come il moscerino dei piccoli frutti (Drosophila suzukii) erano presenti, ma non hanno causato danni grazie alla rete di monitoraggio su tutta la superficie che ha garantito un rapido riscontro della loro presenza e ha permesso di reagire con le adeguate misure di contenimento.
Raccolto di albicocche negli ultimi 10 anni in Val Venosta
Ciliegio
La superfice coltivata nella provincia è leggermente aumentata a 123 ettari (+2 ettari rispetto all’anno precedente). L’annata di riferimento per la coltivazione di ciliegie si può considerare, in generale, poco problematica. Le quantità di frutta raccolte sono state però molto variabili a causa di gelate tardive locali e della siccità durante l’intera stagione vegetale che ha causato un calibro dei frutti inferiore. Anche dal punto di vista commerciale, l’anno di riferimento si può considerare nella media, nonostante le grandi quantità di prodotto raccolto nei mesi di giugno/luglio abbiano causato un crollo dei prezzi, che tuttavia si sono ripresi e stabilizzati verso agosto e leggermente aumentati verso la fine della stagione commerciale.
Coltivazione di susine
La coltivazione di susine è caratterizzata da impianti tradizionali nella Valle d’Isarco e nella zona del comprenso-
Misure nel settore della frutticoltura
Attività di controllo relativa all’organizzazione comune dei mercati nel settore ortofrutticolo come previsto dal Regolamento UE 1308/13 del 17 dicembre 2013

In base all’art. 152 del Regolamento UE 1308/13, in Alto Adige sono attive tre organizzazioni di produttori (OP), legalmente riconosciute: VOG, VIP e VOG Products.
Produttori nel settore frutta e verdura

In data 15.02.2021 è stato consegnato organizzazioni dima operativo approvato ed attuato durante l’anno 2020. In totale sono euro.
I controlli della rendicontazione sono stati effettuati per la prima volta
In data 15.02.2022 è stato consegnato da parte delle tre organizzazioni di produttori il rendiconto del programma operativo approvato ed attuato durante l’anno 2021. In totale sono stati rendicontati 54.932.062,00 euro. I controlli della rendicontazione
sono stati effettuati per la prima volta dall’organismo pagatore competente.
A settembre è stato consegnato da parte delle tre organizzazioni di produttori la domanda di approvazione della modifica in corso d’opera del pro-
gramma operativo approvato. In totale sono stati approvati 54.529.440,00 euro. Il contributo spettante, pari ad un massimo del 50% delle spese riconosciute, ammonta a 27.264.720,00 euro.
Sono stati ammessi a contributo anche altri progetti come per esempio progetti informatici, progetti per il miglioramento qualitativo dei prodotti, progetti per la ricerca di mercato, investimenti per il risparmio energetico e costi per il personale per il mantenimento e miglioramento della qualità. È stato approvato un premio fino a 720,00 euro/ettaro ai singoli produttori per la loro partecipazione al programma di produzione integrata: è stata approvata una superficie netta pari a 14.700 ettari, equivalente a circa il 95% dell’intera superficie netta coltivabile delle organizzazioni di produttori VIP e VOG.

Si sono potuti ammettere a contributo i costi per l’acquisto dei dispenser dei singoli produttori delle cooperative associate per la loro partecipazione al progetto della confusione sessuale. Inoltre, è stata esaminata e revisionata ai sensi delle disposizioni vigenti la funzionalità delle tre organizzazioni di produttori. È stata verificata la conformità alle richieste generali della CE circa l’organizzazione comune dei mercati (statuti, regole ed altro). Il risultato può considerarsi positivo.
In autunno è stato controllato a campione il valore della produzione commercializzata (VPC) nel 2020/21 presso le sedi delle OP: ne è stato ammesso
per 653 milioni di euro ed è condizione fondamentale per il programma operativo 2023.
Contributi in conto capitale per l’incentivazione delle imprese di elaborazione e di commercializzazione di prodotti agricoli
In base alla Legge Provinciale 11/98 è stato concesso a 32 aziende private un contributo in conto capitale del
30-40% per gli edifici e del 20-30% per macchine ed impianti per un valore totale di 324.000,00 euro. Le spese ammissibili ammontavano ad 994.900,00 euro.
«« Ulteriori informazioni, le norme e la modulistica per le domande sono disponibili sul sito: www.provincia.bz.it/agricoltura/ e-mail: frutti-viticoltura@provincia.bz.it obstweinbau.fruttiviticoltura@pec.prov.bz.it

Obiettivo principale dell’incentivazione sono stati i seguenticarello Rampe di carico della Cooperativa frutticola Roen
2.1.3 Viticoltura Evoluzione varietale e delle superfici vitate
La superficie vitata dell’Alto Adige dal 2000 ad oggi è aumentata di 817 ettari e secondo lo schedario viticolo, al 26 novembre 2022 la superficie adibita a vigneto ammonta a 5.718 ettari.

Se si considera che gli appezzamenti nel primo anno di vegetazione non producono uva e quelli nel secondo anno di vegetazione producono la metà in confronto a viti pienamente sviluppate, risultano 5.468 ettari di superficie vitata in produzione.
Nel corso del 2022 sono stati impiantati complessivamente 168 ettari, di cui 75 ettari ex novo, cioè su superfici finora non coltivate a vigneto. In confronto all’anno 2021, corrisponde a un aumento di 8 ettari. Anche per gli impianti complessivi si registra un aumento di soli tre ettari.
Nel 2022, le estirpazioni eseguite a causa delle riconversioni colturali o per attività edilizie ammontano a circa 27 ettari e hanno quindi avuto un aumento di 4 ettari.
Di seguito viene riportata la scelta varietale per i nuovi impianti di viti effettuati nel 2022 estrapolati dai valori
effettivi degli inserimenti nella banca dati dello schedario viticolo:
Scelta varietale per impianti 2022
Continua a prevalere la scelta di varietà a bacca bianca, anche se, sul podio, prevalgono varietà a bacca rossa come il Pinot Nero ed il Lagrein, con in tutto 39,8 ettari. Per quelle a bacca bianca troviamo le cinque varietà Chardonnay, Pinot Grigio, Pinot Bianco, Sauvignon e Traminer aromatico con ciascuna oltre 15 ettari impiantati, per un totale di 96 ettari. In confronto al 2021 è stata impianta in misura molto inferiore la varietà Pinot Nero (-7,3 ha), mentre Pinot Grigio e Chardonnay
Produzione
Secondo le dichiarazioni di vendemmia e di produzione vino, la resa del 2022 ha raggiunto 507.897 q.li di uva prodotta su superficie vitata nella provincia di Bolzano, con il conseguimento di un raccolto di 54.492 q.li di uva, ovvero il 12 % in più in confronto all’annata 2021. La produzione di vino da uve provenienti dalla Provincia di Bolzano ammonta in totale a 362.810 ettolitri di vino. La maggior parte è prodotta da cantine in provincia che raggiungono un quantitativo complessivo di 331.062 ettolitri, mentre cantine nella
hanno avuto il maggior incremento rispetto all’anno 2021 (rispettivamente 6,4 ha e 5,1 ha). La varietà Chardonnay risulta la più piantata nell’anno 2022, con quasi 29 ettari. I vigneti dedicati a varietà a bacca bianca arrivano ora al 64,57% della superficie vitata complessiva.
L’incremento delle sopra citate varietà è avvenuto a scapito principalmente della varietà Schiava, che ha registrato una diminuzione di superficie in confronto al 2021 di 48 ettari. La
sua estensione territoriale ammonta a 505 ettari, che corrispondono ad una quota di 8,8% della superficie vitata altoatesina. Per la prima volta è stata sorpassata da altre due varietà a bacca rossa, ossia dal Pinot nero e dal Lagrein con rispettivamente 557 e 529 ha. Al momento le varietà che prevalgono sono il Pinot Grigio con 685 ettari, il Traminer Aromatico con 627 ettari e lo Chardonnay con 626 ettari, seguiti dalle varietà Pinot Bianco con 599 ettari e Pinot Nero con 557 ettari.
Provincia di Trento hanno prodotto 31.748 ettolitri dalla vinificazione di uve altoatesine. I valori riportati sono riferiti al vino finito, senza fecce.
In confronto al valore complessivo dei dati dichiarati nell’ambito delle dichiarazioni di produzione vino dell’annata 2021 di 319.371 ettolitri, si registra una differenza di 43.439 ettolitri (+13,6 %). Considerando il valore medio degli ultimi 10 anni, che ammonta a 328.476 ettolitri, la produzione complessiva di vino del 2022 è collocata al di sopra della media per circa 34.334 ettolitri (+10,5 %). Del vino prodotto in Alto Adige il 93 % è a DOC.
In Alto Adige, nel 2022 la resa media per ettaro ha raggiunto un valore di
94,65 q.li/ettaro, considerando la superficie produttiva dichiarata di 5.366 ettari. Con questo la resa per ettaro è più alta di quella dell’annata 2021 di soli 9,49 q.li/ettaro. In questo contesto è da considerare che nel 2022 la riduzione della resa massima per i vini “DOC Alto Adige” e “DOC Lago di Caldaro” non è più stata applicata e quindi era possibile utilizzare i normali quantitativi massimi stabiliti nei relativi disciplinari di produzione.
«« Per maggiori informazioni sulla produzione del vino degli anni 2000 – 2022 vedi fig. 9 a pag. 216.
Situazione dello schedario viticolo al 26 novembre 2022
Giallumi della vite
I due tipi di giallumi della vite più importanti, causati da fitoplasmi, sono il Legno nero (Candidatus Phytoplasma solani) e la Flavescenza dorata (Grapevine flavescence dorèe phytoplasma), quest’ultima considerata la forma più aggressiva dei giallumi. La trasmissione dei patogeni tramite cicaline avviene da Hyalesthes obsoletus per il Legno nero e prevalentemente da Scaphoideus titanus per la Flavescenza dorata. Sussiste un obbligo di segnalazione ed estirpazione. Per questo motivo casi sospetti devono essere segnalati al Servizio fitosanitario o al Centro di Consulenza per la Frutti– Viticoltura.

Le due malattie sono diffuse in tante zone viticole europee e a causa dei danni sulla produzione, possono avere grandi conseguenze economiche. Le varietà più colpite della Flavescenza dorata in Alto Adige nel 2022 sono stati Chardonnay e Pinot grigio. Considerato che i sintomi del Legno nero e della Flavescenza dorata non sono distinguibili visivamente, per l’identificazione del patogeno sono necessarie analisi in laboratorio.
Nell’anno 2022 in ambito del programma di monitoraggio sui giallumi della vite dal Servizio fitosanitario in collaborazione con il Centro di Consulenza per la Frutti– Viticoltura sono stati prelevati in tutto 765 campioni fogliari di vite sintomatiche per analisi di laboratorio. In 570 casi è stato accertato il patogeno del Legno nero e in 92 casi il patogeno della Flavescenza dorata.
Vivaismo viticolo
Nel 2022 in Alto Adige sono stati prodotti portainnesti e marze su complessivamente 15,3 ha di superficie. Le aziende con sede legale in Alto Adige producono, in provincia, soprattutto marze, in quanto la maggior parte dei portainnesti viene prodotta al di fuori dei nostri confini. Oltre ai controlli visivi durante il periodo vegetativo nei campi di piante madri, in dicembre sono stati effettuati dei campio-
Rispetto all’anno precedente è stato segnalato nuovamente un aumento di casi di Flavescenza dorata. Nuovi casi sono stati accertati nei Comuni di Cortina, Magrè, Cortaccia, Termeno, Egna, Montagna, Caldaro, Appiano, Bolzano, Marlengo e Lagundo.
Nelle zone infette valgono specifiche prescrizioni fitosanitarie. Oltre alla lotta obbligatoria del vettore principale Scaphoideus titanus è vietato esercitare ogni forma di vivaismo. Prima dell’utilizzo di un insetticida pericoloso per le api, la vegetazione fiorita deve essere falciata o pacciamata. Ogni pianta con sintomi di giallumi della vite deve essere completamente estirpata anche in assenza di analisi di laboratorio. Se la percentuale di viti sintomatiche da Flavescenza dorata è superiore al 20 % deve essere estirpato ľ intero impianto. Per ľ elevato rischio fitosanitario tutte le superfici vitate abbandonate o con piante di vite inselvatichite nel territorio della Provincia autonoma di Bolzano devono essere estirpati a cura degli stessi proprietari o da chi ne ha la disponibilità a qualsiasi titolo. Nel corso della stagione vegetativa 2022, il Servizio fitosanitario ha effettuato numerosi controlli fitosanitari nelle zone infette e nei vigneti abbandonati. Inoltre, l’attuazione della lotta obbligatoria contro il vettore principale Scaphoideus titanus è stata controllata in modo casuale. In diversi casi le prescrizioni fitosanitarie sono state disattese. Per questo motivo, è stato necessario comminare un totale di 37 sanzioni amministrative.
Il Servizio Fitosanitario ha effettuato in collaborazione con il Centro di Sperimentazione Laimburg ed il Centro di Consulenza per la Frutti– Viticoltura da giugno a novembre nelle varie aree viticole altoatesine controlli in campo. Inoltre, in 61 posizioni all’interno delle zone viticole della provincia sono state istallate trappole cromotropiche per individuare la presenza del vettore principale della Flavescenza dorata Scaphoideus titanus. In tutto sono stati catturati 2.038 individui di Scaphoideus titanus sulle trappole cromotropiche. Le trappole cromotropiche sono state valutate, per avere informazioni sulla densità della popolazione e dell’andamento del volo di questa cicalina..
namenti di sarmenti di potatura per la verifica della presenza di virosi. Su nessuna delle partite campionate è stata accertata la presenza di virus. Va invece riportato che in 3 casi è stato riscontrato l’agente patogeno della Flavescenza dorata e di conseguenza i campi di piante madri sono stati esclusi dalla certificazione.
Nel 2022 sono state prodotte barbatelle di alta qualità con un buon grado di lignificazione, anche se ci sono state delle difficoltà causate dalle condizioni climatiche particolari, caratterizzate da un caldo anomalo e
da poche precipitazioni. La somma delle barbatelle prodotte in Alto Adige ammonta a 276.589, in calo di ca. il 22% rispetto all’annata precedente. In questo contesto c’è da dire che una parte considerevole delle barbatelle prodotte dalle ditte vivaistiche altoatesine viene coltivata al di fuori del territorio provinciale, soprattutto nel Veneto. Tra le varietà di vite maggiormente innestate si trovano in ordine decrescente Chardonnay, Pinot Grigio, Pinot Bianco, Pinot Nero, Lagrein, Traminer Aromatico e Kerner.
2.1.4 Orticoltura
Attualmente la superficie orticola altoatesina, il cui prodotto è commercializzato dalle più importanti cooperative, conta più di 295 ettari. In tutta la provincia ci sono quasi 570 ettari secondo le superfici registrate nel SIAF. Le principali colture sono le patate, i cavolfiori, gli asparagi, le rape rosse, il radicchio e il cavolo bianco. Solo poche aziende sono specializzate esclusivamente nel settore orticolo, mentre per tutte le altre esso rappresenta una fonte di reddito secondaria. Nel commercio diretto rivestono un ruolo importante la coltura protetta di pomodori, cetrioli, peperoni, melanzane e altre colture orticole mediterranee.
Superficie orticola coltivata della Cooperativa Sementi di Brunico nell’anno 2022
Superficie orticola coltivata della Cooperativa di produttori della Val Venosta (VIP coop.soc.agricola) nell’anno 2022

In Val Venosta
Il raccolto degli ortaggi nel 2022 ha portato ad una produzione complessiva di 3.146 tonnellate. La superficie coltivata complessiva è al di sopra di 102 ettari. La superficie coltivata a cavolfiore è diminuita rispetto all’anno precedente ed è di 85 ettari con una produzione di 2.744 tonnellate. L’orticoltura ha sofferto per la siccità ed il grande caldo. A causa di queste condizioni atmosferiche alcune coltivazioni hanno avuto problemi con la tignola dei cavoli (Plutella xylostella).
In Val Pusteria
Il 2022, caratterizzato da una primavera anticipata, è stato la base per condizioni ottimali di partenza e ha portato un vantaggio nello sviluppo degli ortaggi da campo, patate e rape rosse. La siccità in giugno ha però determinato una perdita della resa delle patate. Soprattutto su terreno sabbioso e roccioso i tuberi sono rimasti piccoli. Solo in luglio, quando si è verificato un breve periodo piovoso, alcuni campi si sono ripresi.
Nel magazzino si poteva osservare una germinazione precoce, riconducibile alle temperature estive elevate. Con poche eccezioni la qualità degli ortaggi da campo è stata buona.

Coltivazione di patate in Alto Adige
Le patate sono un importante prodotto di nicchia in Alto Adige, ma soprattutto la coltivazione di tuberi-seme in
Val Pusteria è di grande importanza economica.
Negli ultimi anni sono stati riscontrati notevoli danni alle coltivazioni di patate causati dalle larve degli Elateridi che scavano gallerie all’interno dei tuberi danneggiando il prodotto.
Il Servizio fitosanitario ha effettuato, nell’anno 2022, un monitoraggio con specifiche trappole a feromoni per monitorare la presenza di Elateridi. In totale sono stati catturati 441 esemplari, di cui 392 della specie Agriotes obscurus, 48 Agriotes brevis e 1 Agriotes sordidus. Anche nell’anno 2023 proseguirá nei campi di patate il monitoraggio degli Elateridi con lo scopo di acquisire maggiori conoscenze sull’insetto e sui danni causati.
Produzione di tuberi-seme di patate
I tuberi-seme di patate sono soggetti a severe disposizioni normative, solo così viene garantita la loro qualità per quanto riguarda l’origine, la germinazione, la purezza e la sanità.
Prima della raccolta dei tuberi-seme ciascun campo viene controllato almeno una volta dall’Ente responsabile per la certificazione CREA-DC sotto il profilo fitosanitario, in particolare per i virus e gamba nera.

Inoltre, vengono prelevati tuberi-seme da ciascun campo poco prima della raccolta e analizzati in laboratorio per la presenza di virus.
Il Servizio fitosanitario esegue ispezioni visive in campo e in magazzino e preleva tuberi di patate per le analisi di laboratorio per il marciume anulare della patata (Clavibacter michiganensis subsp. sepedonicus), il marciume bruno della patata (Ralstonia solanacearum) e la rogna nera della patata (Synchytrium endobioticum).
I tuberi-seme possono essere coltivati esclusivamente su terreni non contaminati da nematodi cisticoli (Globodera pallida e Globodera rostochiensis).
Questo attestato deve essere fornito tramite analisi di laboratorio.
Nell’anno 2022 la Cooperativa Sementi della Val Pusteria ha dichiarato una superficie totale di 118,28 ettari dedicati alla produzione di patate da seme. In base alla composizione del suolo vengono coltivate diverse varietà di tuberi-seme; le più coltivate sono Spunta, Kennebec, Desiree e Juwel.
2.1.5 Agricoltura biologica
In Alto Adige l’agricoltura biologica continua a mantenere un ruolo importante nell’agricoltura provinciale. Negli ultimi anni le superfici coltivate secondo i dettami del metodo biologico così come il numero delle aziende sono costantemente aumentate. Solamente nel triennio 2012-2014 si è verificata una diminuzione delle superfici adibite a fo-
raggicoltura che è però riconducibile alla recente digitalizzazione di queste colture. Nel 2020 e 2021 si è registrato un forte incremento della superficie dedicata alla viticoltura mentre quella dedicata alla frutticoltura ha subito un brusco rallentamento. L’incremento di superfici destinate a pomacee e a vite nel 2022 è stato piuttosto modesto.
Andamento della superficie totale e suddivisa per indirizzi colturali adibita ad agricoltura biologica e delle aziende dal 1993 al 2022 in Alto Adige
Superfici adibite ad agricoltura
per comune al 31/12/2022
Superfici adibite a colture frutticole biologiche per comune al 31/12/2022
Superfici adibite a prati e pascoli biologici per comune al 31/12/2022
Gli operatori biologici vengono inseriti nell’Elenco degli Operatori Biologici Italiani dalla Ripartizione Agricoltura che gestisce e aggiorna costantemente l’Elenco. Esso è suddiviso in tre sezioni e precisamente in:
1. produttori
2. preparatori
3. importatori
1. Elenco dei produttori agricoli
In questa sezione viene fatta un’ulteriore suddivisione delle aziende in
base al percorso che l’impresa deve effettuare per veder certificata la propria produzione come biologica. Le aziende vengono quindi classificate in:
• aziende agricole biologiche
• aziende agricole biologiche miste (aziende che coltivano contemporaneamente superfici a biologico e convenzionali).
2. Elenco dei preparatori
I preparatori sono gli operatori che nell’esercizio della propria attività d’impresa esercitano operazioni di trasformazione, di conservazione, di confezionamento, d’etichettatura e di
Quadro normativo relativo alle produzioni ottenute con metodo biologico
commercializzazione di prodotti biologici vegetali e animali.
3. Elenco delle aziende con importazioni
Gli operatori iscritti a questa sezione importano prodotti biologici da paesi terzi. Nell’elenco sono iscritte 16 aziende.
Organismi di controllo responsabili della certificazione di produzione biologica operanti in Alto Adige
L’Alto Adige attualmente vede operanti 21 Organismi di Controllo riconosciuti e autorizzati al controllo dell’attività biologica degli operatori. L’efficacia e l’efficienza del controllo svolta da tali Organismi viene valutata dall’Ufficio Meccanizzazione agricola e produzione biologica come autorità provinciale competente. Nel 2022 è stata controllata l’attività degli Organismi di Controllo presso gli operatori. L’attività di vigilanza ha interessato inoltre la sede operativa degli Organismi di Controllo.
«« Ulteriori informazioni, le norme e la modulistica per le domande sono disponibili sul sito: www.provincia.bz.it/agricoltura/ E-Mail: notificabio@provincia.bz.it biomeldung.notificabio@pec.prov.bz.it



2.1.6
Proprietà coltivatrice
Beni di uso civico e associazioni agrarie
I beni di uso civico (beni gravati da diritti di uso civico) di proprietà di frazioni o comuni sono per la maggior parte costituiti da boschi, pascoli e malghe. I diritti di uso civico consistono prevalentemente in diritti di pascolo e legnatico.
Sono titolari del diritto di uso civico i cittadini residenti nella relativa frazione o nel relativo comune. Caratteristica dei beni di uso civico sono l’inalienabilità e l’inusucapibilità. Solo in casi eccezionali (regolamento di confine, area accessoria, ecc.) e per superfici minime sono possibili alienazioni di beni di uso civico previo pare-
re positivo dell’assessore provinciale all’agricoltura, sempre premesso che con l’alienazione non venga leso sostanzialmente l’esercizio dei diritti di uso civico. In tali casi nell’anno 2022 sono stati emessi 133 pareri. Le associazioni agrarie sono comunioni private di interesse pubblico, anche esse prevalentemente costituite da boschi, pascoli e malghe. Pressoché 700 associazioni agrarie sono iscritte nell’elenco ufficiale. Le alienazioni di terreni, i trasferimenti e suddivisioni di quote di comproprietà nonchè altri provvedimenti devono essere approvati dall’assessore provinciale all’agricoltura. In tali casi nell’anno 2022 sono state emesse 88 approvazioni.

Sia nell’ambito dei beni di uso civico che in quello delle associazioni agrarie nel Libro fondiario vengono eseguite rettifiche e integrazioni.
Inoltre in questi settori si effettua un’intensa attività di consulenza.
La legge sui masi chiusi costituisce il quadro giuridico per la protezione del maso chiuso (legge provinciale del 28 novembre 2001 n. 17), che regola, tra l’altro, cambiamenti della consistenza, costituzione e svincolo del maso chiuso.
Le autorizzazioni delle Commissioni locali per i masi chiusi, che comportino la costituzione o lo svincolo di masi chiusi e la scorporazione di costruzioni di qualsiasi genere (comprese cubature, diritti di costruzione o parti di fabbricati), devono essere sottoposte al controllo della Ripartizione l’Agricoltura, legati ad un’eventuale possibilità di un ricorso. Le autorizzazioni diventano esecutive trascorsi 30 giorni dalla data di arrivo alla Ripartizione Provinciale l’Agricoltura, a meno che entro
questo termine detta Ripartizione non proponga ricorso alla Commissione Provinciale per i masi chiusi.
Tutte le altre delibere delle Commissioni locali per i masi chiusi, che riguardano il distacco e l’incorporazione di particelle (particelle fondiarie e particelle edificiali), non sono soggette all’attività di controllo della Ripartizione Provinciale l’Agricoltura. Nel 2022, 212 autorizzazioni delle Commissioni locali per i masi chiusi sono state controllate dalla Ripartizione Provinciale l’Agricoltura. Contro 13 decisioni la Ripartizione Provinciale l’Agricoltura ha presentato ricorso alla Commissioni Provinciale per i masi chiusi. La Commissione Provinciale per i masi chiusi ha trattato un totale di 24 ricorsi nel 2022.
Il maso chiuso –modifiche della consistenza, costituzione e svincoloPascolo dell’associazione agraria “Interessenza per le malghe di Meltina”
Masi aviti (“Erbhöfe”)
La denominazione di “maso avito” può essere riconosciuta ad un maso chiuso che è stato tramandato da almeno 200 anni all’interno della stessa famiglia e che viene coltivato e abitato dal proprietario stesso. Per la verifica storica è stato incaricato l’archivio provinciale di Bolzano. L’attribuzione avviene tramite decreto dell’assessore all’agricoltura.

Dall’entrata in vigore della legge provinciale n. 10 del 26.04.1982 fino all’anno 2022 sono state presentate all’ufficio competente 1.601 domande, di cui 8 nell’anno stesso. In totale sono state evase positivamente 1.206 istanze, di cui 9 nell’anno 2022.

Conciliazioni secondo la legge statale sugli affitti
Secondo quanto disposto dalla legge sull’affitto di fondi rustici n. 203/82, in caso di vertenze relative al rapporto di locazione è necessario esperire in primo luogo un tentativo di accordo extragiudiziale. A tale scopo è istituita presso la Ripartizione Provinciale Agricoltura una commissione di conciliazione presso l’ufficio proprietà coltivatrice. Tale norma di risoluzione delle liti è prevista a livello statale, ed in Provincia di Bolzano viene applicata con successo.
La procedura di conciliazione, attraverso il colloquio diretto tra le parti e con l’assistenza specializzata fornita da esperti nella specifica materia, ha lo scopo di raggiungere un accordo, evitando così l’avvio di una vertenza giudiziaria.
Convenzione per la disciplina dei danni da selvaggina
La legge provinciale sulla caccia del 17.07.1987, n. 14, dispone che l’ammontare dei danni causati dalla fauna selvatica viene determinato ed indennizzato secondo i termini e le modalità di una convenzione stipulata tra i rappresentanti delle riserve di caccia ed i rappresentanti dei proprietari dei fondi. In caso di mancato raggiungimento di un accordo amichevole tra la parte danneggiata e la parte obbligata al risarcimento, l’Amministrazione provinciale incarica un perito per l’effettuazione della stima del danno. Avverso tale stima può essere proposto ricorso alla Commissione provinciale per la determinazione dei danni da selvaggina. Il Presidente della commissione è il direttore dell’ufficio proprietà coltivatrice affiancato da un rappresentante dei cacciatori e dei proprietari dei terreni.
Incentivi per la proprietà contadina
Aiuti all’avviamento d’impresa per giovani agricoltori
L’aiuto all’avviamento d’impresa per i giovani agricoltori è una delle misure promosse dal Programma di Sviluppo Rurale 2014-2020. Il Programma di Sviluppo Rurale 2014-2020 è stato prorogato di due anni, fino alla fine del 2022.
Coll’aiuto si intende agevolare l’avviamento di nuove imprese agricole e di promuovere il ricambio generazionale.
L’aiuto ammonta – in dipendenza dei punti di svantaggio dell’azienda – da 7.500 a 33.000 Euro. La liquidazione dell’aiuto avviene in due rate.
Sono ammessi giovani agricoltori che presentano la domanda entro un anno dall’inizio dell’attività in agricoltura (apertura della partita IVA) e si trovano in possesso di una delle qualifiche professionali richieste.
L’azienda, assunta dal giovane, deve realizzare un valore di produzione standardizzato tra 20.000 euro (8.000 euro per aziende con punti di svantaggio) e 100.000 euro.
I giovani agricoltori, al momento della presentazione della domanda devono presentare anche un piano aziendale nel quale prevedono misure in riferimento a investimenti, consulenze e perfezionamenti professionali da assolvere nei tre anni dall’inizio dell’attività.
Inoltre i giovani agricoltori sono obbligati a frequentare per un periodo di tre anni 75 ore di aggiornamenti professionali sotto forma di consulenze, corsi oppure convegni.
Nell’anno 2022 sono stati concessi a 223 giovani agricoltori 5.095.500 Euro.
Per masi chiusi con punti di svantaggio che non raggiungono un valore standardizzato della produzione di 8.000 Euro è stato introdotto un incentivo finanziato esclusivamente dalla Provincia Autonoma di Bolzano - Alto Adige. Queste aziende devono raggiungere una soglia minima di 3.500 euro di valore standardizzato della produzione.
Nell’anno 2022 questo incentivo è stato concesso a 26 giovani per un ammontare di 756.000 Euro.
Imprenditore agricolo professionale
Le agevolazioni fiscali e altri benefici in agricoltura vengono concesse a „imprenditori agricoli professionali“ e „societá agricole“ in possesso dei requisiti stabiliti dal decreto legislativo 29.03.2004, n. 99, e successive modifiche. L’imprenditore agricolo professionale quale persona fisica, anche ove socio e/o amministratore di società agricole, deve iscriversi nella gestione previdenziale ed assistenziale per l’agricoltura.
Nell’anno 2022 sono state presentate 19 domande per il riconoscimento della qualifica di “imprenditore agricolo professionale” o “società agricola”. 11 domande sono state evase con esito positivo, 1 domanda è stata respinta e 2 domande sono state ritirata.
«« Ulteriori informazioni, le norme e la modulistica per le domande sono disponibili sul sito: www.provincia.bz.it/agricoltura/ E-Mail: proprieta.coltivatrice@provincia.bz.it lweigentum.agriproprieta@pec.prov.bz.it
2.1.7 Edilizia rurale
In totale dal 2005 fino al 31.12.2022 sono state classificate
3.013 aziende agrituristiche nel seguente modo

Agriturismo
Per le aziende che successivamente alla prima classificazione abbiano migliorato qualitativamente l’azienda, il legislatore prevede la possibilità di richiedere una nuova classificazione. Il decreto del presidente della provincia del 27. agosto 1996, n. 32 regola l’affitto di appartamenti per ferie e camere per ospiti e le modalità di classificazione delle aziende agricole (attribuzione fiori) che svolgono l’attività
agrituristica ai sensi della legge provinciale n. 7, del 19. settembre 2008. Nell’anno di riferimento sono stati concessi contributi per investimenti per un importo di 1,56 mio. di euro a 40 aziende.

Incentivazioni relative all’edilizia nel settore agricolo
Interventi a favore dell’agricoltura
Nell’anno 2022 sono state presentate ai sensi della legge provinciale del 14.12.1998, n. 11, 375 nuove domande per la concessione di contributi. I progetti presentate dalle aziende agricole riguardano in prima linea case d’abitazione, stalle, fienili, ricoveri per macchine ed attrezzi, strade poderali e meccanizzazione interna.
Confronto fra le domande presentate e finanziate negli ultimi anni
Ripartizione dei fondi distinti per sezioni distaccate e progetti nell’anno 2022 (L.P. 1/74, L.P. 11/98, L.P. 7/08) – Numero die contributi concessi per tipo di opere e distretti con importi complessivi in milioni di euro:
Programma di sviluppo rurale (PSR)
La misura relativa al PSR 2014-2020 –art. 17 del regolamento UE 1305/2013MISURA 4 “Investimenti in immobilizzazioni materiali” - SOTTOMISURA 4.1 “Sostegno a investimenti nelle aziende agricole della Provincia Autonoma di Bolzano” disponeva di un budget di 10.500.000,00 Euro, che è stato impegnato completamente già nell’anno 2017. Per il 2019/20 sono stati messi a disposizione ulteriori 20.000.000,00 Euro di risorse provinciali per gli “investimenti TOP UP” e i “finanziamenti COF” con cofinanziamento comunitario sono stati aumentati di un milione (in totale 11.500.000 Euro), per la sottomisura 4.1.
Nell’anno 2021 sono state messe a disposizione ulteriori risorse e i “finanziamenti COF” sono stati aumentati di 3.065.420,12 Euro e inoltre sono stati messi a disposizione “finanziamenti EURI” di ulteriori 8.934.579,88 Euro. Nell’anno seguente, si sono potute aprire due finestre temporali previste e la commissione per la selezione dei progetti ha potuto scegliere ulteriore 19 domande. Dopodiché le risorse della sottomisura 4.1 erano completate e la misura è stata chiusa.
Sono stati concessi complessivamente con le “risorse TOP UP” contributi per un importo complessivo di 210.540,00 Euro, con il “finanziamento COF” per un importo complessivo di 6.089.755,00 Euro e con il “finanziamento EURI” per un importo complessivo di 4.000.945,00 Euro.
In aggiunta sono state liquidate 36
domande con le “risorse TOP UP” per un importo di 7.628.319,25 Euro, 3 domande con i “finanziamenti COF” per un importo di 283.904,00 Euro e 7 domande con i “finanziamenti EURI” per un importo di 1.409.084,13 Euro.
Consorzi
Nell’anno 2022 sono stati concessi contributi per gli investimenti ai consorzi di bonifica per un totale di € 3.080.346,00 per gli esercizi finanziari 2022, 2023 e 2024 e a consorzi di miglioramento fondiario per un totale di € 3.935.550,00 per gli esercizi finanziari 2022, 2023 e 2024.
Contributi ai consorzi di bonifica
L’articolo 31, comma 5 della legge provinciale 28 settembre 2009, n. 5, prevede la concessione d’aiuti per la manutenzione ordinaria e l’esercizio delle opere di bonifica di interesse provinciale. Sono stati concessi contributi per la manutenzione ordinaria e l’esercizio delle opere di bonifica di interesse provinciale nonché contributi ai consorzi di bonifica per le spese di gestione per un importo di € 1.539.650,00.
Durante l’anno di riferimento sono state presentate 10 domande.
Consorzi di bonifica e di miglioramento fondiario
L’Ufficio Edilizia rurale svolge la vigilanza sui consorzi di bonifica e di miglioramento fondiario. Nell’ambito di questi compiti l’ufficio nel 2022 ha provveduto al controllo dei bilanci
dei consorzi di bonifica dell’Alto Adige e della Federazione provinciale dei consorzi di bonifica, di irrigazione e di miglioramento fondiario. Inoltre ha autorizzato le modifiche delle loro proprietà immobiliari. Nell’anno 2022 sono stati ampliati o ridelimitati 5 consorzi e per un consorzio di miglioramento fondiario stato approvato il nuovo statuto. Attualmente nella Provincia di Bolzano esistono 289 consorzi di miglioramento fondiario, cinque consorzi di bonifica e un consorzio di bonifica di II grado.
Nel 2022 è stato emesso 1 decreto del direttore d’ufficio per la revoca parziale del vincolo di indivisibilità ventennale nell’ambito di ricomposizioni fondiarie e piani di rettificazione. Sono state inoltre convocate due riunioni del comitato tecnico per la bonifica.
Infine è stata avviata una nuova ricomposizione fondiaria nel Comune Catastale Tesido.
«« Ulteriori informazioni, le norme e la modulistica per le domande sono disponibili sul sito: www.provincia.bz.it/agricoltura/ e-mail: edilizia.rurale@provincia.bz.it lwbauwesen.agriedilizia@pec.prov.bz.it


2.1.8 Meccanizzazione agricola
Il parco macchine dell’Alto Adige
Rientrano nelle competenze dell’Ufficio meccanizzazione agricola e produzione biologica anche la tenuta e l’aggiornamento continuo dello schedario delle macchine agricole, la consulenza, l’immatricolazione ed i passaggi di proprietà e l’assegnazione del carburante agevolato. Inoltre, l’ufficio concede contributi a fondo perduto e prestiti a tasso agevolato per l’acquisto di macchine agricole e le relative
Incentivazioni per l’acquisto di macchine agricole e carburante
L’Ufficio meccanizzazione agricola e produzione biologica è stato anche nel 2022 un interlocutore per le agevolazioni per l’acquisto di macchine agricole e l’assegnazione di carburante agevolato.
Contributi a fondo perduto
A partire dal 01/01/2022 fino al 31/03/2022 è stato nuovamente possibile presentare le domande di aiuto per l’acquisto di macchine ed attrezzature agricole per l’anno 2022.
In questi 3 mesi sono state presentate 798 domande per un totale di 955 progetti, di cui 565 riguardanti la meccanizzazione esterna e 390 la meccanizzazione interna. Sono state approvate 728 domande con una spesa ammissibile di 12.992.600,00 Euro, concedendo contributi pari a 3.651.670,00 Euro, destinati in particolar modo all’acquisto di motofalciatrici, spingi-
attrezzature, con particolare riguardo a quelle destinate ad un impiego extraaziendale nell’ambito di un’associazione utenti macchine agricole.
Nel 2022 sono state immatricolate 641 trattrici nuove, 370 rimorchi nuovi, 26 macchine agricole semoventi nuove e 194 trainate e 1 mietitrebbia. Per 9 macchine agricole è stata fatta richiesta di demolizione o esportazione e sono stati emessi 2916 duplicati di carte di circolazione, inclusi i passaggi di proprietà. Le reimmatricolazioni di macchinari sono state 18, mentre sono state fatte 477 richieste per l’emissione di targhe ripetitrici. I richiedenti si sono recati anche presso le agenzie automobilistiche che hanno redatto ulteriori 195 targhe per trattrici agricole, così che nell’anno 2022 sono state rilasciate in totale 889 targhe per trattrici.
«« Informazioni dettagliate sul parco macchine agricole in Alto Adige, acquisto di trattrici nuove, nonché la media dei CV delle trattrici vedi tab. 16, 17 e fig. 10 da pag. 219 e 220.

fieno e voltafieno per il settore della meccanizzazione esterna, mentre per il settore della meccanizzazione interna l’incentivazione ha supportato soprattutto l’acquisto di attrezzature per la preparazione del liquame, di gru per il fienile e di macchinari per l’essicazione del fieno.
Carburante e combustibile agevolato
Nel 2022 sono stati assegnati a 11.808 aziende agricole complessivamente 29.387.156 litri di gasolio e 429.121 litri di benzina.
«« Ulteriori informazioni, le norme e la modulistica per le domande sono disponibili sul sito: www.provincia.bz.it/agricoltura/ e-mail: uma@provincia.bz.it uma@pec.prov.bz.it
2.1.9 Servizi generali
Sistema informativo agroforestale (SIAF) e gestione dell’Anagrafe provinciale delle imprese agricole
Il Sistema informativo agro-forestale (SIAF) è lo strumento informativo per la gestione dell’Anagrafe provinciale delle aziende agricole.
L’Anagrafe provinciale contiene tutte le imprese agricole con sede sul territorio della Provincia Autonoma di Bolzano – Alto Adige, oppure lavora
Ulteriori misure in agricoltura
Incentivazione per il trasferimento di conoscenze ed azioni di informazione nonché per servizi di consulenza in agricoltura
Nell’anno 2022 sono stati concessi ai sensi della L.P. 14/12/1998 n. 11 ad associazioni ed organizzazioni agricole, per le loro attività di trasferimento di
Tentativi di conciliazioni ai sensi della legge sui masi chiusi
Chi intende proporre in giudizio una domanda relativa al diritto vital natural durante a un adeguato mantenimento secondo le condizioni di vita locali e la capacità produttiva del maso chiuso, alla successione suppletoria,
no terreni agricoli nella provincia. Le informazioni raccolte nell’anagrafe sono la base per i pagamenti di aiuti comunitari, statali e provinciali, oltre ad essere un punto di riferimento nei rapporti tra l’amministrazione pubblica e le imprese agricole. Inoltre, i dati contenuti sono messi a disposizione delle amministrazioni statali, dell’Organismo pagatore della Provincia, i comuni, oltre a varie organizzazioni attive nel settore agricolo (associazioni di categoria e di consulenza, organizzazioni di produttori, ecc.). Tutti i dati gestiti nell’Anagrafe provinciale delle imprese agricole che sono rilevanti per il fascicolo aziendale vengono continuamente sincronizzati nel sistema informativo agricolo nazionale (SIAN).
L’anagrafe contiene tra l’altro le seguenti informazioni:
- dati anagrafici delle imprese agricole;
- dimensione totale delle superfici, dimensione dei terreni coltivati, titolo giuridico dei terreni coltivati, dati catastali, ed inoltre i seguenti dati di dettaglio:
• delle superfici coltivate a melo
• delle superfici vitivinicole
• delle categorie di premi per la tutela del paesaggio
• relativi all’aratura dei prati avvicendati
- punti di svantaggio;
consistenza bestiame e carico bestiame
giorni alpeggio e carico alpeggio
- superfici foraggere calcolate
Al 31/12/2022 l’anagrafe contava
28.442 aziende con coltivazione di terreni agricoli o forestali oppure allevamento di bestiame. Nel corso dell’anno 2022 sono state variate i dati di 19.720 imprese (variazioni di superfici, di titoli di conduzione, variazioni in base a nuova ortofoto, ecc.)
«« Ulteriori informazioni, le norme e la modulistica per le domande sono disponibili sul sito: www.provincia.bz.it/agricoltura/ email: apia.lafis@provincia.bz.it lafis.apia@pec.prov.bz.it
2.1.9
conoscenze ed azioni di informazione nonché per i servizi di consulenza, contributi per un importo pari a € 3.955.600,00.
Incentivi per il ripristino e l’indennizzo di danni causati da avversità atmosferiche
Nell’anno 2022 sono state compensate con un sostegno finanziario diverse situazioni d’emergenza derivanti da frane o inondazioni.
«« Ulteriori informazioni, le norme e la modulistica per le domande sono disponibili sul sito: www.provincia.bz.it/agricoltura/ email: lamagr.bio@provincia.bz.it lamagr.bio@pec.prov.bz.it
all’integrazione della quota riservata ai legittimari o alla divisione ereditaria, nei casi in cui il maso chiuso costituisca parte dell’asse ereditario, oppure proporre in giudizio una domanda di usucapione del diritto di proprietà di un maso chiuso o parte di esso oppure concernente la determinazione dell’assuntore o dell’assuntrice del
maso chiuso e la determinazione del prezzo di assunzione è obbligato a esperire un tentativo di conciliazione presso la Ripartizione Agricoltura. Nell’anno 2022 sono state presentate 21 domande per l’esperimento di un tentativo di conciliazione.
Metà della superficie provinciale in Alto Adige è coperta dal bosco – di cui ca. il 58% è bosco montano con funzione protettiva diretta che svolge un’azione a tutela del suolo dall’erosione e delle zone abitate da slavine, caduta massi e colate detritiche. Solamente un bosco di protezione sano, ecologicamente stabile può svolgere efficacemente le sue funzioni, al contrario invecchiamento, mancata rinnovazione e pressione da selvaggina (ungulati) ne compromettono le prestazioni. Anche lo stato e lo sviluppo degli alpeggi riveste in Provincia di Bolzano grande valenza ecologica e culturale. Questi paesaggi culturali unici rappresentano elementi di inestimabile valore naturale e ricreativo per la società del giorno d’oggi. La fruizione delle malghe deve tuttavia tener conto delle esigenze ecologiche e della limitata stabilità di queste sensibili zone alpine.
Ai Servizi Forestali, ovvero alla Ripartizione provinciale Foreste sono demandate esclusivamente competenze e funzioni di carattere istituzionale. In quanto autorità responsabile del settore foreste, caccia e pesca, i Servizi Forestali sono attivi su oltre il 90% del territorio provinciale.
L’ Agenzia demanio provinciale al contrario è responsabile per gli aspetti operativo-gestionali delle superfici montane e boscate di proprietà provinciale, che copre ca. il 10% della superficie dell’Alto Adige,
La Ripartizione Foreste provvede ad una durevole ed equilibrata gestione e conservazione degli habitat naturali, in particolare di boschi, pascoli, malghe e delle acque. L’assistenza qualificata e professionale contribuisce a minimizzare i conflitti di interesse, così da garantire la tutela e la conservazione di questi habitat. Il contatto diretto con la popolazione e la sorveglianza di tutto il “territorio naturale” – aree rurali, boschi, pascoli e pascoli alberati, verde alpino, ghiacciai e rupi – consentono di prevenire la commissione di numerosi reati.
I nostri boschi e le malghe, creati da una decennale gestione sostenibile e naturalistica assieme ai massicci montuosi costituiscono oggi un elemento di valorizzazione straordinaria del paesaggio culturale altoatesino. Rilevanza ancora maggiore spetta peró alla funzione protettiva del paesaggio boschivo e alpicolo - intatto e stabile; colui garantisce la sicurezza del nostro spazio vitale in montagna. Gli avvenimenti catastrofici dell’ ultimo anno hanno rilevato con massima chiarezza la sensibilità e fragilità dell`ambiente alpino.
2.2.1 Bosco
2.2 Foreste, malghe ed
L'Alto Adige è una regione montana; lo testimonia il fatto che ben il 40 % della superficie è collocata al di sopra dei 2.000 m s.l.m. Nel rispetto della legge forestale, che prevede la tutela dei terreni di qualsiasi natura e destinazione d’uso, più del 90 % della superficie provinciale è sottoposta a vincolo idrogeologico-forestale. Questo vincolo si pone come obiettivo la conservazione della stabilità del suolo e il regolare deflusso delle acque per garantire la tutela di aree particolarmente suscettibili, ma va anche oltre sostenendo
una gestione attenta dei boschi, dei prati e dei pascoli di montagna, il loro miglioramento, la conservazione degli ecosistemi e della fauna e della flora che li popolano. Tutto ciò viene perseguito per garantire un elevato livello di tutela per la natura e il paesaggio altoatesini. Gli abitati, la rete stradale e le colture intensive non sono invece sottoposti a questo vincolo. Secondo i risultati ufficiali del terzo Inventario Nazionale Forestale (INFC 2015 – Inventario Nazionale delle Foreste e dei serbatoi forestali di Carbonio)
l’Alto Adige è coperto per 339.270 ha da bosco e per 36.081 ha da „altre terre boscate” (terreni boscati che non rientrano nei parametri della categoria precedente). Secondo l’Inventario Forestale Nazionale la definizione di bosco é quella di una superficie coperta da specie arboree, di estensione superiore ai 5.000 m², larghezza massima maggiore di 20 m, altezza media delle piante maggiore di 5 m e un grado di copertura delle chiome superiore al 10 %. Per altre terre boscate si intendono, invece, le superfici coperte da specie

arboree con estensione superiore a 5.000 m², larghezza massima superiore a 20 m, con altezza media delle piante compresa fra 2 e 5 m e grado di copertura delle chiome superiore al 10 %

(gli arbusteti di alta quota, come le mughete) oppure, in alternativa, con altezza superiore a 5 m e grado di copertura delle chiome compreso fra il 5 e il 10 % (i cosiddetti “boschi radi”).
Superficie boscata secondo le categorie di proprietà
Per la classificazione della superficie boscata in base alla tipologia di proprietà e di specie presenti, si fa riferimento alla banca dati della Ripartizione Provinciale Foreste:
<1 % Latifoglie
1 %
19 %
61 % Abete
3 % Abete bianco LariceIl bosco di protezione
In un territorio montano come quello della provincia di Bolzano, l’azione protettiva svolta dai boschi è di fondamentale importanza per qualsiasi attività umana. Se si considera l’azione di protezione del bosco in riferimento ai fenomeni valanghivi, di caduta massi e di regimazione delle acque, si può affermare che ben il 58 % della superficie boscata (197.000 ha circa) ricade in aree con una prevalente funzione protettiva. Di questi, il 24% dei boschi è collocato direttamente a monte di infrastrutture (es. strade e ferrovie) ed insediamenti, svolgendo quella che viene definita funzione eteroprotettiva.

Gestione boschiva & eventi calamitosi
Il bosco dell’Alto Adige in cifre
m3= metri cubi, ms = metri steri
* i valori sono riferiti a >= 4,5 cm diametro a petto d’uomo (1,30 m);
** i valori sono riferiti a >= 17,5 cm diametro a petto d’uomo (1,30 m);
Fonte dei dati: MIPAAF/CRA-ISAFA Inventario Nazionale Forestale e dei serbatoi di carbonio [INFC 2015], dalla banca dati forestale provinciale 2022 (Forest.Management@provinz.bz.it). Ulteriori dati sul bosco in Alto Adige è sul sito www.provincia.bz.it/foreste.
Dopo l’evento calamitoso Vaia, avvenuto nell’ottobre del 2018, a prevalere sono nettamente le utilizzazioni di legname su superfici colpite da calamità. Dal 2018 in provincia di Bolzano sono stati utilizzati ca. 6,5 milioni di metri cubi lordi di legname; di questi, ca. 5,2 milioni di metri cubi si riferisco-
no al legname danneggiato, mentre i restanti 1,3 milioni di metri cubi alle utilizzazioni normali. Queste ultime sono quelle rientranti nelle categorie martellata normale, tracciati per le strade, tagli colturali, cambi di coltura, altri.
Schianti da vento: ottobre 2018 (Vaia) e luglio 2019
Oltre la tempesta Vaia, risalente ai giorni compresi fra il 27 e il 30 ottobre 2018, nel luglio 2019 si è verificato uno schianto da vento localizzato in Val d’Ega, in particolare nella stazione di Nova Ponente.
I lavori di sgombero del legname atterrato da Vaia sono iniziati tempestivamente il mese successivo all’evento e si sono sovrapposti ai lavori di sgombero degli schianti da vento del luglio successivo. A fine dicembre 2022, quindi quasi 4 anni dopo l’evento, è stata esboscata complessivamente una massa legnosa di ca. 2,3 milioni di metri cubi lordi. I rilievi utili a cartografare gli schianti, compresi i voli con elicottero, sono stati effettuati su tutto il territorio provinciale. L’individuazione degli schianti Vaia si può considerare conclusa. La superfice colpita ammonta complessivamente a 5.918 ha; se confrontata con la superficie forestale dell’Alto Adige, con riferimento i dati dell’inventario forestale nazionale del 2015, essa risulta pari all’ 1,7 % del totale. Nel complesso sono stati digitalizzati 1.463 poligoni, con una dimensione massima di 280 ha. Il valore medio delle superfici schiantate si attesta attorno ai 4 ha. I danni diffusi, ovvero quelli su singoli alberi o su piccoli gruppi, non sono stati ancora rilevati. Circa 2/3 della massa risulta concentrata in 4 Stazioni Forestali: Nova Levante, Nova Ponente, Fontanefredde e Marebbe.
In accordo con i proprietari boschivi e di pari passo con il rilievo dei danni, sono stati realizzati interventi di ripristino. Particolare attenzione è stata dedicata ai boschi con prevalente funzione eteroprotettiva dove si rendono necessarie opere di protezione
combinate con rimboschimenti. Nei boschi con funzione autoprotettiva ci si può limitare all’impianto di giovani piantine, mentre le rimanenti superfici vengono lasciate a rinnovazione naturale. Eventuali rimboschimenti integrativi ritenuti necessari vengono valutati e realizzati di volta in volta in base alle esigenze sito-specifiche.
Schianti da neve:
novembre 2019 e dicembre 2020
Nei due anni successivi a Vaia, in particolare nel novembre del 2019 e nel dicembre del 2020 una serie di basse pressioni mediterranee ha causato in provincia ingenti schianti da neve. La differenza sostanziale fra il legname danneggiato dalla neve e quello danneggiato dal vento è il fatto che i danni di quest’ultimo sono concentrati, mentre i primi sono diffusi. Il vento, infatti, tende ad agire su ampie superfici abbattendo interi popolamenti, mentre la neve danneggia singoli individui o gruppi di piante sparse sul territorio. È evidente, quindi, come il recupero delle piante schiantate dalla neve sia per questo motivo generalmente più costoso. Inoltre, analizzando l’andamento del mercato, va considerato anche il fatto che il prezzo del legname ha subito una notevole contrazione connessa agli schianti da vento. A fine dicembre 2022, ossia dopo circa 3 anni dal primo evento, è stata esboscata una massa legnosa riconducibile ai danni da neve pari a ca. 2,3 milioni metri cubi lordi con oltre i 2/3 della massa concentrata nella parte orientale della provincia (Ispettorati di Brunico, Monguelfo e Bressanone).

Danni da bostrico: Nel 2020 ha avuto inizio la gradazione del bostrico tipografo, il quale ha ini-
ziato ad attaccare il legname ancora a terra per gli schianti da neve e da vento. A questo sono andate ad aggiungersi le condizioni ambientali favorevoli, con un’ondata di caldo nel giugno del 2021 che ha permesso al bostrico di proliferare ulteriormente. Lo scolitide ha iniziato così ad attaccare non solo le piante a terra, ma anche quelle in piedi. Nel 2022 una primavera poco piovosa ed un’estate molto calda e secca hanno permesso al bostrico di continuare la sua proliferazione, divenuta ormai epidemica. Particolarmente colpite sono state la Val Badia e l’alta Val Pusteria. In molti casi la stabilità dei boschi di protezione è stata fortemente compromessa. A fine dicembre 2022, la massa legnosa esboscata ascrivibile ai danni dello scolitide ammonta a ca. 0,5 milioni metri cubi lordi.
2.2.2 Alpeggi ed Economia Montana
In Alto Adige esistono ca. 1.600 alpeggi attivi. Ben oltre 2/3 sono alpeggi pri-
vati, il 20% sono proprietà di interessenze e in comproprietà, altri 8% fanno parte di enti pubblici, quali Comuni e Amministrazioni S.B.U.C. Una piccola parte è di proprietà del demanio, di enti ecclesiastici ed altri.
Le proprietà in provincia divergono storicamente presentando in Val Venosta a ponente di Naturno poche, malghe molto grandi, solitamente di proprietà di Comuni o Amministrazio-

ni S.B.U.C. e invece ad oriente di Naturno, compresa la Val Senales, quasi tutta la superficie e anche la maggioranza numerica delle malghe è in proprietà di privati o è in comproprietà. Ad esempio, nel Comune di Malles e in quello di Sarentino vengono alpeggiati all’incirca la stessa quantità di UBA (2.900), a Malles gli animali vengono gestiti in 20 diversi alpeggi, mentre in Val Sarentino sono distribuiti su non meno di 144 alpeggi.
Negli ultimi tre anni su quasi 1.400 alpeggi ogni anno sono stati monticati bovini, ovini o caprini. Sugli alpeggi più piccoli solo pochi capi, nelle malghe più grandi oltre 100 UBA, in 18 malghe altoatesine vengono monticate più di 300 UBA.
Il mondo alpicolo sudtirolese é contraddistinto da molte malghe piccole con un carico di bestiame inferiore a 20 bovini o con meno di 50 ovini.
Nelle 276 malghe più estese dell’Alto Adige – il 17 % del totale – durante i mesi estivi pascolano in media più di 50 UBA e complessivamente i due terzi di tutte le UBA alpeggiate. Molto più numerose sono le piccole malghe di proprietà privata: 55 % delle malghe altoatesine, complessivamente 1.040 unità, contano meno di 20 UBA. In queste piccole, ma paesaggisticamente caratteristiche malghe troviamo ca. il 15% di tutti gli animali alpeggiati. Circa un terzo dei bovini vengono monticati durante i mesi estivi. I vantaggi dell’alpeggio sul benessere di manzi e manzette sono indiscutibili. In ca. 70 malghe altoatesine vengono monticate almeno 5 vacche da latte in lattazione, in 45 malghe piú di 15. In generale, la monticazione dei bovini segue la tendenza degli allevamenti di bovini. Da alcuni anni vengono alpeggiati numeri inferiori di bovini, nell’anno scorso ca. 44.600 bovini sono stati in malga per almeno 30 giorni. Gli ovini alpeggiati numericamente sono stabili da alcuni anni, mentre il numero di caprini alpeggiati da alcuni anni sono in crescita.
*animali monticati più di 30 giorni
Nell’anno trascorso sono state registrate 89.800 movimentazioni di bestiame in malga con una permanenza
di almeno 30 giorni. Ben 8% di queste riguardano aleggi in provincie limitrofi o in Tirolo. Confrontando i dati geo-
grafici delle diverse specie alpeggiate si possono ricavare le seguenti considerazioni: per quanto riguarda i bovi-
ni, soprattutto i bovini in asciutta non ci sono grosse differenze geografiche. Diversamente è la monticazione degli ovini, che infatti vengono alpeggiati maggiormente nei settori occidentali dell’Alto Adige. Ben 55% di questa specie viene monticata nei distretti della Val Venosta e di Merano. Nei caprini questa concentrazione è ancor più evidente: quasi la metà dei caprini sono alpeggiati nel distretto di Mera-
no e precisamente in Val Passiria e nel Gruppo di Tessa. Anche in Val Venosta e in alta Val d’Isarco vengono monticate molte capre. Diversamente, nella parte orientale dell’Alto Adige, nei distretti di Bressanone, Brunico e Monguelfo vengono alpeggiati solo pochi caprini. Le grandi malghe sul Renon, sull’Alpe di Villandro, in Val Sarentino e nel Comune di Curon in Val Venosta sono i luoghi preferiti per il soggior-

no estivo dei cavalli. Considerato l’alto numero di progetti finanziati nel settore alpestre si deduce la grande importanza dell’alpeggio in Alto Adige. Annualmente in media vengono erogati contributi pubblici per lavori inerenti agli alpeggi di ca. 2.000.000 euro, nell’anno 2022 si sono conclusi lavori di 42 progetti con un ammontare contributivo di ~1.894.000 euro.

Protezione delle mandrie e greggi
Su questa tematica nell’anno passato sono stati svolti numerosi sopralluoghi e incontri di consulenza. Negli anni a venire la protezione dai grandi carnivori delle greggi di ovi-caprini e delle mandrie di bovini avrà un’importanza sempre maggiore. La protezione delle mandrie e greggi però è molto dispendiosa e necessita di molta preparazione. La protezione da grandi carnivori
necessita imprescindibilmente di un pascolo organizzato e controllato. Le greggi di pecore necessitano, per essere protette dal lupo, della presenza costante di un pastore, che con l’aiuto dei cani da pastorizia riesca a portare in appositi recinti gli ovini nelle ore notturne. In alternativa il perimetro del pascolo deve essere delimitato con apposito recinto elettrificato. Solo in poche malghe le greggi ovine vengono continuamente sorvegliate dei pastori e possibilmente delimitate in un apposito recinto nelle ore notturne. Attualmente in Alto Adige scarseggiano pastori con cani da pastorizia

addestrati, anche le baite per pastori in molti luoghi sono in pessimoi stato o addirittura mancano.
Nell’anno 2022 sono state inoltrate 5 nuove domande di contributo per la costruzione di recinti di protezione. Con questo materiale vengono eretti in posizioni favorevoli dei recinti per la stabulazione notturna delle greggi. Dall’anno 2020 la percentuale di contributo per la messa in opera di recinzioni di protezioni è passata dal 70 al 100%. Il prezzo standard per l’acquisto, il trasporto e il posizionamento del recinto di protezione è rimasta invariata a 8,00 € a metro lineare.
2.2.3 Gestione forestale Assegni al taglio
In provincia di Bolzano gli alberi possono essere tagliati o prelevati dal bosco solamente dopo essere stati precedentemente assegnati dal personale forestale mediante la cosiddetta “martellata”. Le piante destinate al taglio vengono scelte tenendo conto della possibilità del bosco di rinnovarsi naturalmente e cercando di conferire ai popolamenti forestali anche stabilità e resistenza.

L’assegno delle piante rappresenta per il forestale un’importante occasione di consulenza con il proprietario boschivo. In occasione di ogni martellata si redige un verbale d’assegno, nel quale si documentano fra l’altro dati e prescrizioni per conferire l’autorizzazione e la successiva utilizzazione. Quando viene fatta la martellata normale il proprietario può, assieme all’autorità forestale competente, accordarsi sul legname da prelevare.
Nel caso di eventi calamitosi (vento, neve, bostrico), invece, il proprietario boschivo perde questa capacità ed è costretto a concentrare le utilizzazioni solo sulle piante colpite. Nonostante ciò, il legname danneggiato prelevato dal bosco dev’essere quantificato, classificato e registrato per poter aggiornare le banca dati provinciale sulle
provvigioni, così da predisporre una migliore pianificazione e una gestione forestale accorta. Tutti i verbali d’assegno vengono archiviati periodicamente nella banca dati della Ripartizione Foreste, dando così la possibilità di elaborare delle statistiche che tengano traccia dell’andamento inter-annuale delle utilizzazioni.
Nel corso del 2022 sono stati effettuati complessivamente 9.912 assegni (martellate) di taglio. La quantità di legname assegnata mediante “martellata”

è stata pari a 1.654.443 m³. Le specie maggiormente utilizzate sono state
l’abete rosso (84,4%), il pino silvestre (5,9%) e il larice (5,8%). Le latifoglie sono state interessate da assegni di taglio per una quota pari al 0,7% rispetto alla massa complessiva.
«« In tab. 18 (pag. 222) sono visualizzate le utilizzazioni 2022 per ispettorati forestali ed in tab. 19 (pagina 222) le specie arboree assegnate nell’anno 2022.
Ripartizione della massa assegnata al taglio per tipologia di taglio (periodo 2018 – 2022)
2.2.3
*Banca dati forestale provinciale, aggiornato al 31.12.2022


Nella statistica per tipologia di taglio gli effetti degli eventi calamitosi risultano evidenti nelle rispettive colonne
(schianti da neve, schianti da vento, attacchi parassitari).

14,3 % Teleferica
>300 m
27,2 % Teleferica
<300 m
6,1 % Trattore
49 % Verricello
2,0 % Harvester/ Forwarder

1,3 % Altri
<<< Informazioni dettagliate sulla gestione forestale sono disponibili sul sito della Ripartizione Foreste: https://www.provincia.bz.it/agricoltura-foreste/bosco-legno-malghe/default.asp
Aiuti per la gestione forestale
In Alto Adige sono tradizionalmente impiegate varie forme di esbosco, in relazione alla morfologia molto variabile del territorio ed in relazione all’accessibilità delle aree forestali. Le tipologie d’esbosco maggiormente diffuse sono l’esbosco con verricello, teleferica e con trattore.
a) Piani di gestione silvo-pastorali
La redazione di piani di gestione silvo-pastorali è regolata dall´art. 13 della L.P. del 21 ottobre 1996, nr. 21 (legge forestale). L'articolo 20 di questa legge prevede per la redazione e la revisione dei piani di gestione contributi fino ad un massimo del 50% dell'importo di spesa riconosciuta.
Nell'anno 2022 sono stati revisionati 30 piani di gestione, di cui 19 sono stati ammessi a finanziamento per un ammontare complessivo di contributi pari a 49.435,19 Euro.
b) Piano di sviluppo rurale 2014-2020 – Sottomisura 8.5.1: Investimenti per aumentare la resilienza di ecosistemi boschivi – investimenti selvicolturali. Con questa misura vengono incentivati interventi di miglioramento boschivo su superfici di minimo 1 ha. Nel 2021 sono stati liquidati 37 diradamenti con un aumentare contributivo di ~92.000 Euro.
c) Programma di sviluppo rurale 20142020: misura 8.3.B2: Sostegno alla prevenzione dei danni arrecati alle foreste da incendi, calamità naturali ed eventi catastrofici – aiuti graduali per
la rimozione rispettosa del terreno di legname di piante morte, deperite o danneggiate.
In boschi in condizioni stazionali estreme e in casi accessibilità boschiva insufficiente, i costi di rimozione del legname superiori sono supportati dall’aiuto maggiore. Si tratti dunque di un aiuto graduale per la rimozione rispettosa dal terreno di legname di piante morte, deperite o danneggiate. Nell’anno 2022 sono state finanziate 2.979 richieste di contributo con un valore complessivo di ~10.750.000 €. In confronto con l’anno 2021 la somma corrisposta è triplicata, dato che nel 2021 sono state accettate 1.605 domande con una somma di 3.750.000 euro. La motivazione sono gli attacchi massici di bostrico con il conseguente recupero di legname danneggiato.
A queste vanno aggiunte 562 misure per la rimozione di legname danneggiato da “Vaia” che sono state finanziate da fondi provinciali. Per le 562
misure sono stati versati contributi pari a € 4.161.000.
d) Programma di sviluppo rurale 20142020: misura 8.6 – Sostegno agli investimenti in tecnologie silvicole e nella trasformazione, mobilitazione e commercializzazione dei prodotti delle foreste. Nel corso del 2022 sono state ammesse a finanziamento 177 domande di aiuto a proprietari boschivi e microimprese per l’acquisto di macchinari per l’esbosco. Il contributo ammesso a finanziamento di queste pratiche ammonta a ~1.295.000 euro (40 % dell’importo ammesso).


Negli ultimi 5 anni (2018-2022) sono state accolte complessivamente 1.177 domande di contributi per l’acquisto di macchinari forestali e concessi contributi per 8.017.000 €.

2.2.4 Stato del bosco –tutela boschiva e danni boschivi
Servizio vigilanza di tutela boschiva
Da più di 40 anni lo stato di salute del bosco viene osservato e monitorato con cura dal Servizio forestale provinciale. In tale ambito si rilevano tutti i sintomi evidenti e i danni che compaiono nei popolamenti forestali. Accanto a tali rilievi vengono condotte prove chimiche su campioni fogliari e di terreno per identificare eventuali inquinamenti dovuti a sostanze nocive. Si è potuto verificare come la comparsa di molti danni boschivi trae la sua origine nell’andamento climatico sfavorevole; inverni poveri o molto ricchi di neve, gelate tardive, primavere troppo piovose, estati calde e siccitose o molto piovose, danni da vento e da grandine. Questi fenomeni mostrano spesso i loro effetti anche a distanza di anni, predisponendo le piante debilitate all’attacco da parte di alcuni patogeni, come il bostrico, la ruggine vescicolosa dell’abete, la processionaria del pino e altri insetti o funghi. Per questo motivo è utile un cenno preliminare sull’andamento climatico complessivo dell’anno.

Il meteo, una panoramica dei mesi del 2022 (*)
L'anno 2022 è iniziato in modo relativamente mite e asciutto; come nel dicembre precedente, a gennaio ci sono state solo poche piogge e poca neve. Febbraio ha seguito gennaio come mese più mite della media e un po' troppo secco. Di conseguenza, il bilancio complessivo dell'inverno è stato decisamente troppo secco, con precipitazioni diffuse e nevicate solo tra un terzo e la metà della media. Marzo è stato ancora più secco, con un po' di pioggia caduta in alcune zone solo alla fine del mese. A differenza degli altri mesi, tuttavia, le temperature sono state leggermente inferiori
alla media. Anche aprile è stato un po' più fresco del solito, ma per la prima volta c'è stata più pioggia. L'estate è iniziata presto, a maggio; questa prima ondata di caldo ha avuto ai fini della dinamica di popolazione di alcune specie di insetti una forte rilevanza.
Non solo il mese è stato fin troppo caldo, ma Bolzano ha anche registrato le prime due notti tropicali con minime non inferiori ai 20 gradi, un nuovo record. A giugno il clima ha continuato a essere più caldo della media, con precipitazioni equilibrate. A luglio l'estate ha raggiunto il suo apice, con un'ondata di caldo estremo durata ben dieci giorni. Anche questo è un momento che spiega molto di quanto si riporta nelle righe seguenti.
Il mese di agosto ha continuato a portare temperature di mezza estate, con piogge leggermente inferiori alla media. Settembre è stato per la prima volta un mese medio, cioè le temperature sono state vicine ai valori comparativi a lungo termine, e ci sono state differenze a livello regionale nelle precipitazioni, ma nel complesso i valori sono stati normali.
Grazie a condizioni di alta pressione di lunga durata, ottobre passerà alla storia del clima come uno dei più caldi dall'inizio delle rilevazioni. Di conseguenza, la pioggia è diminuita. Quest'anno i mesi umidi sono stati rari e persino a novembre ha piovuto o nevicato la metà del solito. Dicembre ha portato due nevicate a bassa quota e una breve ondata di freddo. Alla fine, tuttavia, è stato di nuovo un mese più mite della media.
Danni abiotici
Schianti da neve invernali
A fronte delle modeste precipitazioni nevose dell’inverno, non si sono registrati schianti da neve.
Schianti da vento
Nel 2022 non si sono registrati eventi di questo tipo in provincia.
Danni biotici
Coleotteri scolitidi
Una evidente relazione tra danni abiotici e biotici è riscontrabile nel caso degli attacchi di coleotteri scolitidi, favorito dagli schianti da vento e neve e dalla siccità. Per questo occorre risalire a fine 2018. Dopo la tempesta Vaia 2018, il 2019 è stato un anno di attesa. A fronte di un risultato lusinghiero in termini di massa sgomberata (ca il
70% a fine anno), il clima ha dato una mano, con una primavera ricca di precipitazioni e caratterizzata da basse temperature, condizioni sfavorevoli al volo degli adulti svernanti e all’accoppiamento. È stato un anno di incremento della popolazione di bostrico, che comunque ha potuto approfittare della disponibilità di legname fresco a terra. In seguito gli schianti di novembre 2019 hanno messo a disposizione degli adulti svernanti un ulteriore substrato alimentare fresco e facilmente disponibile, sul quale si sono potuti sviluppare per un secondo anno senza attaccare le piante in piedi. Nel 2021, a seguito di una primavera fredda e prolungata, l’ondata di caldo a partire dall’inizio di giugno ha determinato un volo simultaneo e massiccio degli adulti svernanti del bostrico dell`abete rosso (Ips typographus) chiamato anche bostrico tipografo, che, non trovando più substrato alimentare a terra, hanno rivolto le loro pericolose attenzioni sulle piante in piedi e hanno potuto contare su un andamento dell’estate favorevole alla loro attività riproduttiva, rendendo possibile in molti casi lo sviluppo di due generazioni.
Lo sgombero del legname derivante dagli schianti da neve del 2019 e 2020 si è rivelato cruciale in termini di effetti. Dove lo sgombero è stato eseguito in modo completo e tempestivo, la popolazione di scolitidi è stata ridotta in maniera drastica e i danni da scolitidi, pur presenti, si sono mantenuti entro i limiti di infestazioni puntuali e diffuse; laddove invece -per motivi orografici o di scarsa disponibilità di
imprese di utilizzazione- il legname è rimasto in gran parte a terra, i danni sono su ampia superficie e – per la prima volta da Vaia – chiaramente visibili sulle piante in piedi. Nel 2021 si sono contati su tutta la provincia 871 ha di danni da bostrico, concentrati perlopiù nella parte orientale della provincia. Nel 2022 la popolazione, già numerosa, ha subito un ulteriore incremento, indotto da un andamento climatico favorevole al volo e dunque alla riproduzione del bostrico; va poi aggiunto che quelle stesse condizioni climatiche, particolarmente l’ondata di siccitá a cavallo tra giugno e luglio, hanno posto l’abete rosso in condizioni di stress idrico. L’infestazione si è così estesa, con intensità differenti da zona a zona, anche a comprensori che finora erano rimasti indenni; è per esempio il caso dell’alta Val d’Isarco e dell’alta Val Venosta. Complessivamente si registra una superficie colpita superiore ai 4.300 ha.
La rete di monitoraggio di Ips typographus ha registrato dati di cattura in linea con il fenomeno; se si condensano le rilevazioni nel dato riassuntivo di catture medie per trappola, l’andamento negli ultimi 4 anni è il seguente:
predittive sulla fenologia del bostrico tipografo sulla base dei dati meteo delle stazioni presenti sul territorio provinciale. In questo modo si potranno pianificare in modo più preciso gli eventuali interventi di contenimento. Sempre in collaborazione con l’Università di Bolzano, nell’ambito di una tesi di laurea si sono condotti esperimenti in campo e test di laboratorio per valutare la diversa attrattività di composti volatili presenti in natura da parte del bostrico tipografo; i risultati hanno confermato le osservazioni empiriche dando loro fondamenta più solide e fornendo preziose informazioni, anche di rilevanza pratica. Tale linea di ricerca verrà ulteriormente approfondita.
Un ulteriore progetto, che vede coinvolti accanto all’Università di Bolzano l’Universität für Bodenkultur e l’università di Padova, indaga a livello genetico i simbionti del bostrico tipografo, la loro composizione (nematodi, funghi, batteri) e le variazioni della stessa nel corso delle stagioni. Tale ricerca ha fornito nella sua prima fase una mole enorme di informazioni, il cui valore sarà apprezzato solo nel medio periodo.
Per rendere il monitoraggio più efficiente e coprente su tutta la superficie provinciale, la Ripartizione Foreste ha attivato una convenzione con l’Universität für Bodenkultur di Vienna per l’estensione alla nostra provincia della rete Phenips, che dà informazioni


Una trattazione a parte merita Ips cembrae, il coleottero scolitide specifico del larice. A seguito dei pesanti danni subiti dai lariceti puri della V. Senales, si è ritenuto prudente monitorare l’eventuale comparsa di questo ospite con l’installazione di alcune trappole poste in punti strategici. I primi 2 anni di osservazione danno risultati incoraggianti; l’esperienza indica che questo insetto attacca in modo massiccio solo larici al di sotto del loro optimum altimetrico. Non ha dunque sorpreso la comparsa di questo coleottero attorno alla piana di Malles, dove la popolazione ha attecchito e
si è moltiplicata con successo a carico dei lariceti di bassa quota. Qui si sta monitorando la popolazione con l’installazione di 4 trappole con feromone specifico, si cerca di frenare la pullulazione con abbattimenti mirati e, parallelamente, si lavora per una successione verso un bosco biologicamente più stabile. Nel 2022 si è avuta una modesta gradazione in V. Senales, mentre nella piana di Malles l’intensità dell’attacco è stazionaria; è invece un elemento di novitá l’attacco su larici maturi in quota sul Sonnenberg; tale attacco per ora è puntuale e sparso. Allo stesso genere appartiene anche Ips amitinus, specifico del pino cembro, per il quale non si registrano segnalazioni.
Gli attacchi di Tomicus spp. a carico dei getti di pino, che provocano vistosi arrossamenti osservati spesso su ampie superfici, non hanno nell’immediato rilevanza dal punto di vista forestale. Tale fenomeno è da ricondurre all’attività minatoria del medesimo scolitide a carico dei getti di accrescimento, ne-

cessaria all’insetto per raggiungere la maturità sessuale. Tale tipo di danno, concentrato nelle pinete della media Val d’Isarco e a Rio Pusteria, copriva nel 2021 una superficie totale di 1217 ha e 781 ha di superficie effettiva. Tali attacchi, ancora non letali per la pianta, sono oggetto di attenta osservazione, anche a fronte della significativa superficie colpita, in quanto possono preludere a un attacco a carico del tessuto corticale del tronco, quest’ultimo letale per la pianta. Tale attacco si è mantenuto nel 2022 entro livelli rassicuranti (32 ha di superficie complessiva per 12 ha di superficie ridotta). Altri 30 ha di danno sono dovuti a altri coleotteri scolitidi del pino (Ips sexdentatus e Ips acuminatus). In combinazione con i sopra citati danni si riscontra sul pino, soprattutto nelle stazioni più calde, la presenza del coleottero buprestide Phaenops (Melanophila) cyanea.
Coleotteri scarabeidi
Nel 2022 il maggiolino (Melolontha melolonta L.), che episodicamente puó rendersi responsabile di forti pullulazioni a carico di piante da frutto e forestali, si mantiene in latenza.
Coleotteri curculionidi
Di tale famiglia è oggetto di particolare osservazione Rhynchaenus fagi, insetto minatore delle foglie del faggio, di cui può determinare vistosi arrossamenti, non letali per la pianta ospite. Di questa specie, dopo una serie di anni in continuo regresso, per il quarto anno non si registrano attacchi. È stato invece segnalato in Bassa Atesina sui rimboschimenti nelle superfici colpite dalla tempesta Vaia Hylobius abietis, che sulle piantine di abete rosso compie la nutrizione per la maturazione delle gonadi.
Microlepidotteri
La tortrice grigia del larice (Zeiraphera griseana), che nelle valli alpine è caratterizzata da pullulazioni a cicli di 8 anni, a seguito di una gradazione nel 2009/2010 ha avuto il suo ultimo picco nel 2011 in Val Venosta, nel Meranese ed in Val Passiria, con estesi ingiallimenti delle chiome e centinaia di migliaia di piante colpite. L’attacco si è poi andato esaurendo verso est, senza lasciare danni permanenti. Il 2017 segna il ritorno puntuale di questo microlepidottero, ricomparso in alta

Val Venosta a Curon e Tanas su una superficie ridotta di 535 ha. L’attacco si è ripetuto nel 2018. La pianta ospite reagisce all’attacco con l’emissione di foglie meno appetibili; tale decadimento della qualità del substrato alimentare provoca di fatto la fine della pullulazione. Dal 2019 infatti non si sono più registrati attacchi.
Un parente stretto della tortrice grigia del larice, la tortrice verde della quercia (Tortrix viridana), nel 2020 ha dato notizia di sé con pullulazioni principalmente a carico della quercia, attaccando peró in misura minore anche altre latifoglie (castagno, tiglio, orniello, ciliegio) nel bosco di Monticolo. Per ora resta allo stato di latenza.
Coleophora laricella, altro microlepidottero minatore specifico del larice protagonista di pullulazioni cicliche, segnalata nel 2020 in V. Aurina e in misura minore a Chienes, latente nel 2021, è ricomparsa nel 2022 a Rio Pusteria su una superficie complessiva di 48 ha (36 di superficie ridotta).
Macrolepidotteri
Non si registrano per il 2022 attacchi di Lymantria dispar; tali eventi da noi hanno una frequenza tra i 10 e i 20 anni e colpiscono per lo più i cedui delle Valli d’Adige e d’Isarco.
Processionaria del pino
(Thaumetopoea pityocampa)
Dopo l’estate 2015, caratterizzata da siccità e alte temperature, si è registrato un forte aumento degli attacchi di questo macrolepidottero, con attacchi particolarmente acuti nella
parte occidentale della provincia, la Val Venosta, zona endemica di diffusione di questo insetto. I valori raggiunti, rispetto all’anno precedente, arrivavano al quadruplo di piante attaccate e a otto volte per quanto riguarda il numero di nidi per pianta. Nel 2017, a fronte di una superficie interessata mantenutasi pressoché costante, si è invece registrato un vistoso decremento delle piante attaccate, che passano dalle 884.732 del 2015 alle 374.348 del 2016 e alle 159.200 del 2017, per scendere sotto la soglia delle 100.000 nel 2018 e contrarsi ulteriormente nel 2019. Per il 2020 si registrano, su una superficie ridotta di 62 ha, meno di 10.000 piante colpite, per poco più di 2 nidi per pianta. Nel 2021 si registra un’improvvisa, ripida gradazione di questo insetto, indotta verosimilmente dalla congiuntura climatica favorevole di fine estate, che può aver provocato il massiccio sfarfallamento della generazione del 2020 e l’interruzione della diapausa di molti altri individui delle annate precedenti. Si consideri a questo proposito che la diapausa alle nostre latitudini può durare fino a 8 anni, il che rende molto difficile definire una relazione causa – effetto nelle gradazioni. Nel 2022 la gradazione si è mantenuta a livelli inaspettatamente alti, con piante completamente defogliate e in alcuni casi decine di nidi per pianta in V. Venosta. Ulteriore elemento di novità è l’anticipo nello sviluppo delle larve; nella prima metà di novembre già un 80% di larve aveva raggiunto il quinto e ultimo stadio.
Per il 2022 si registra un totale di 793 ha di superficie colpita (398 ha di superficie ridotta).
Al netto della dannosità per la pianta, che è in realtà modesta, resta la pericolosità dei peli urticanti della larva dal terzo stadio in poi per uomo e animali domestici. Contro questo inconveniente il migliore provvedimento è la corretta informazione, e in questo senso la ripartizione Foreste e gli ispettorati forestali interessati dal fenomeno si adoperano da anni. Esente da attacchi resta, per ora, la Val Pusteria, a causa del clima più continentale.
Patologie fungine
I funghi sono parte integrante dell’ecosistema forestale dove svolgono numerose funzioni essenziali al benessere del bosco. Alcune specie fungine, tuttavia, sono anche i principali patogeni e provocano alcune delle malattie che colpiscono le piante. Nel 2022 sono state rilevate numerose infezioni legate a funghi patogeni fra le specie arboree forestali tipiche. La siccità e il caldo dell’ultimo anno hanno limitato la diffusione di numerose malattie fungine. D’altro canto, però, l’azione di questi eventi estremi ha incrementato in maniera diffusa il livello di stress degli stessi ecosistemi forestali. Nei prossimi anni gli effetti dei danni causati dalla siccità avranno un ruolo determinante nel condizionare l’evoluzione delle foreste del futuro.
Limitatamente alle patologie fungine, comunque, nel corso del 2022 non ne sono state rilevate di nuove.
Sphaeropsis sapinea o Diplodia sapinea: deperimento su pino nero (Pinus nigra)

L'inverno 2021-2022 è stato caratterizzato da temperature miti e scarse precipitazioni. A questo è seguita un'estate calda con precipitazioni altrettanto scarse. Ai danni già evidenti sul pino nero, soprattutto in Val Venosta, si sono aggiunti quelli da alimentazione della processionaria del pino. Questo ha creato le condizioni favorevoli alla diffusione della Sphaeropsis sapinea, agente patogeno saprofita, comunque presente in questi popolamenti e responsabile del deperimento dei getti. A contraddistinguere l’attacco del fungo ascomicete è il caratteristico imbrunimento degli aghi. Il legno de-
gli alberi infestati, inoltre, si distingue per l’evidente colorazione bluastra del legno.
Caratteristici della presenza della malattia sono anche i piccoli corpi fruttiferi neri in cui si sviluppano le spore necessarie alla riproduzione e alla diffusione della Sphaeropsis sapinea. Essi si trovano non solo sugli aghi, ma anche sulle squame dei coni. Le spore vengono rilasciate durante tutto il periodo vegetativo, ovvero da marzo-aprile (a seconda della quota) fino ad ottobre.
I danni alle piante sono stati più contenuti sui versanti esposti a nord e a nord-ovest rispetto a quelli esposti a sud e a sud-est.
Il clima di queste aree è caratterizzato da periodi di siccità come dimostrato dalle serie di dati a disposizione. Questo fa sì che il deterioramento dei germogli sia un fattore limitante per i pini neri, per cui è lecito aspettarsi ulteriori deperimenti in futuro. I pini, in generale, riescono a riprendersi anche da danni gravi se il tempo è favorevole: per questo motivo, gli alberi meno colpiti all’interno del popolamento dovrebbero essere lasciati a libera evoluzione così da consentire ulteriori osservazioni.
Dothistroma septosporum – Malattia delle bande rosse su pino cembro (Pinus cembra) e pino mugo (Pinus mugo)

L'infezione legata alla malattia delle bande rosse provoca una grave perdita di aghi, in particolare di quelli più vecchi. Le specie di pino sono quelle maggiormente colpite da questa malattia. La caduta degli aghi inizia nei rami più bassi per poi diffondersi gradualmente verso la cima dell'albero. Nei casi più gravi, a rimanere sono solo gli aghi dell’anno.
I sintomi variano da singole macchie e/o le punte degli aghi marroni nei casi più lievi fino ad arrivare ad aghi completamente imbruniti nei casi più gravi. Al centro delle macchie e sui segmenti colpiti si formano corpi fruttiferi fungini neri all’interno dei quali si formano i conidi, spore derivate da riproduzione asessuata necessari alla moltiplicazione e diffusione del fungo. È proprio a causa di queste bande che la malattia prende il suo nome, quello di “malattia delle bande rosse”.
La presenza della malattia in Italia è nota dal 2017. In Alto Adige, invece, la presenza di questo patogeno è stata rilevata per la prima volta nel 2018 su alcuni individui di pino cembro e pino mugo della Val Sarentino; non è




chiaro, tuttavia, quando il fungo sia effettivamente arrivato in provincia. Alcuni controlli effettuati nel 2022, seguiti dalle relative analisi di laboratorio svolte presso l’Università di Firenze, hanno accertato la presenza del

patogeno in questione (Dothistroma septosporum) anche in altre valli altoatesine, e non solo. L’area principale di diffusione della malattia è nelle valli dolomitiche, soprattutto nella zona del Trentino. Nelle aree fortemente infestate, comunque, la malattia delle bande rosse si è limitata alle specie di pino attaccate e non si ‘e diffusa sugli abeti e larici vicini.
L’effetto dell’attacco fungino sulla vitalità degli alberi è notevole. Infestazioni ripetute per diversi anni possono comportare un rischio estremamente elevato per gli alberi danneggiati, soprattutto se ancora nella fase giovanile. Le contromisure sono tuttavia difficili da attuare soprattutto a causa dell'ampia diffusione della malattia.
Melampsorella caryophyllacearum –Scopazzi dell’abete bianco (Abies alba)

Questa malattia è causata da un fungo della ruggine autoctono, la Melampsorella caryophyllacearum.
Le aree dei giovani ramoscelli infestate dal patogeno sono caratterizzate da rigonfiamenti e crescite anomale dei germogli che provocano la formazione di una struttura che prende il nome di “scopa delle streghe”
La malattia è diffusa in tutto l'areale dell'abete bianco e quindi anche in Alto Adige, ed è parte integrante della biodiversità naturale tipica di queste foreste.

Gli abeti dall'età dal novelleto alla spessina possono essere infettati in primavera iniziando dagli aghi più giovani. Attraverso la produzione di ormoni vegetali, nell’area infettata il fungo provoca inizialmente un ispessimento, dove negli anni successivi si svilupperà la cosiddetta "scopa della strega" che continuerà ad estendersi sempre di più.
Gli aghi infettati sono tozzi, di colore più chiaro, solo annuali e cadono a fine estate; questi rami anomali sono quindi spogli durante i mesi invernali. In primavera, gli stessi rametti che avevano perso gli aghi germogliano nuovamente e in maniera precoce, già ad aprile, circa quattro settimane prima del normale germogliamento. Il fungo della ruggine ha bisogno di due piante ospiti. Per questo ad essere coinvolti nel ciclo di sviluppo del fungo non sono solo gli abeti ma anche le Caryophyllaceae: le spore sono prodotte nella parte inferiore degli
aghi cresciuti sul rametto infettato e si diffondono sugli individui di una famiglia di piante erbacee (Caryophyllaceae) che crescono in prossimità di queste aree. Il fungo passa l’inverno fra le loro foglie e li steli, per poi infettare nuovamente gli abeti la primavera successiva.
In Alto Adige, la diffusione degli scopazzi dell’abete bianco è molto limitata. Pertanto, l'importanza economica è esigua e il controllo non è necessario.
Ailanto (Ailanthus alitssima): L’ailanto è un albero deciduo invasivo originario della Cina e del Vietnam. Il così chiamato “Albero del paradiso”, utilizzato in passato come pianta ornamentale, è ormai molto diffuso anche in Alto Adige. Nella sua zona d’origine questa specie viene colpita
da numerosi organismi patogeni; tuttavia, al di fuori del suo areale naturale di diffusione, non ha quasi nessun antagonista. Le misure introdotte per il contenimento dell’ailanto hanno avuto successo solo parzialmente. Vent’anni fa in Europa e Nord America è stata osservata la morte di numerosi individui di questa specie, riconducibile ad un’infezione da Verticillium. Nell’estate del 2017 la stessa infezione, caratterizzata da avvizzimento delle foglie e disseccamento di rami, è stata riscontrata per la prima volta in Italia. Il fungo è stato identificato anche nel territorio della regione, sia a Covelano che a Rovereto. L’anno successivo, nel 2018, la patologia fungina aveva raggiunto una diffusione tale da essere stata osservata in oltre 40 siti sparsi per tutto il Trentino-Alto Adige. Attualmente, con i nuovi focolai
identificati nel 2022, si sono raggiunti i 170 punti di presenza accertata fra la provincia di Trento e quella di Bolzano. In generale, si è assistito sia all’allargamento dei vecchi focolai sia alla morte di numerose piante all’interno degli stessi.
Frassino maggiore (Fraxinus excelsior)


Il deperimento del frassino, presente ormai da un decennio su tutto il territorio provinciale, è collegato alla diffusione di un organismo patogeno fungino: l’Hymenoscypus pseudoalbidus. In tutta la provincia sono stati osservati gravi danni, in particolare a carico del frassino maggiore (Fraxinus excelsior), anche se vi è comunque una buona fetta di piante sane e prive di sintomi. Nel frattempo, sono stati fatti diversi studi, i quali hanno evidenziato una caratteristica interessante: la genetica della pianta contribuisce a contrastare il diffondersi della malattia. Tale resistenza può quindi essere trasmessa per via ereditaria alle giovani piante, per cui in futuro si potrebbe instaurare un equilibrio fra agente patogeno e piante, con la percentuale di individui resistenti che aumenterebbe per selezione. È molto importante quindi conservare e contribuire alla diffusione di quelle resistenti. Tali piante si riconoscono perché parzialmente o totalmente sane in un ambiente infestato; saranno proprio questi individui ad essere determinanti nel percorso di ricostituzione futura dei popolamenti di frassino.
Per l’analisi e l’identificazione delle patologie fungine la Ripartizione Foreste viene supportata dal prezioso lavoro del dott. Giorgio Maresi, ricercatore presso la Fondazione Edmund Mach di San Michele all’Adige.
Non è superflua a questo punto una visione d’insieme sull’incidenza dei danni boschivi 2021 a livello provinciale. Il risultato dell’elaborazione delle segnalazioni provenienti dalla capillare rete di stazioni forestali è sintetizzato nel diagramma che segue.
Incendi boschivi - Servizio di reperibilità forestale
Nel corso del 2022 si sono verificati 104 incendi boschivi e di sterpaglie per una superficie totale pari a 16,90 ha. Il tempestivo intervento delle squadre di vigili del fuoco e del personale forestale ha inoltre evitato l’estendersi del fuoco su più vaste superfici. In media la
superficie persa per incendio (indice di efficienza dell’azione di spegnimento) risulta essere limitata a soli 0,21 ha. Nel caso di incendi boschivi ed eventi di pericoli naturali o di protezione civile viene attivato il servizio di reperibilità forestale – attivo 24 ore su 24, che allerta i servizi forestali localmente competenti ed organizza l’eventuale intervento dell’elicottero per i lavori di spegnimento.(19 interventi con l’elicottero, 5 per esercitazioni).

Nel 2022 il servizio di reperibilità forestale è stato allertato complessivamente 538 volte, di cui 384 volte per il recupero di animali selvatici feriti o morti - soprattutto coinvolti in incidenti stradali. 2.2.5
2.2.5 Lavori eseguiti in economia
I lavori in economia comprendono provvedimenti rivolti ad un generale
miglioramento delle condizioni sostanziali dei nostri complessi boschivi e rivolti a salvaguardia gli ecosistemi come rimboschimenti e cure selvicolturali, misure di ingegneristica ambientale per la stabilizzazione di erosioni e la deviazione controllata delle acque, sistemazioni antivalanga per la sicurezza delle infrastrutture, strade di allacciamento dei masi, costruzione di strade forestali ed alpicole, costru-

zione di sentieri, misure di tutela boschiva contro danni biotici ed abiotici, misure di prevenzione antincendio boschivo, miglioramenti di pascolo e misure gestione/separazione pascolo-bosco, rivitalizzazione di boschi cedui e castagneti, miglioramenti e ripristino di particolari habitat boschivi, misure di pronto intervento in caso di eventi di pericoli naturali. I progetti vengono elaborati dal servizio foresta-

le ed eseguiti in gran parte dagli operai forestali. Anche la direzione lavori durante l’esecuzione dei lavori viene svolta dai tecnici della Ripartizione Foreste. Il servizio forestale realizza i lavori con massima sensibilità ambientale e con l’uso di materiali naturali tipici, per raggiungere la massima integrazione delle opere nel paesaggio. Gli interventi si riferiscono ai lavori in economia dei distretti forestali, a quelli nei vivai forestali, alle iniziative per l’impiego dei disoccupati, come da

L.P. n.11/86, al rilevamento dei danni boschivi e all’elaborazione di piani di gestione dei beni silvo-pastorali. Poiché trattasi in gran parte di attività manuali, presso i Servizi Forestali Provinciali è impiegato ogni anno un gran numero di operai.


L’ammontare finanziario complessivo dei 504 progetti di lavori in economia svolti nel 2022 da parte della ripartizione foreste era pari ad un importo totale di 15.496.300 euro. Di questi 11.580.250 euro finanziati dall’am-
ministrazione provinciale e i rimanenti 3.916.050 euro da parte di terzi. Inoltre, nell’anno 2022 sono stati realizzati progetti in parte per la sistemazione di danni da avversità atmosferiche e in parte per infrastrutture in zone rurali con una somma complessiva di 697.700 euro.
Per misure di pronto intervento sono stati incentivati e realizzati 20 progetti. Per progetti dovuti ad avversità atmosferica stati finanziati 7 progetti.
2.2.6 Economia montana ed infrastrutture rurali
getti giá precedentemente inoltrati. Negli ultimi anni 2020 – 2022 sono stati finanziati ben 456 progetti con una somma erogata di ~99.000.000 euro.
2.2.6
La manutenzione e il risanamento della rete viaria rurale è molto costosa e in alcuni casi tecnicamente difficoltosa.
a) Viabilità rurale e collegamento dei masi
I masi montani altoatesini e la maggior parte delle malghe e dei boschi in provincia sono raggiungibili con una strada camionabile o una strada silvo-pastorale. Nella rete viaria rurale sono inserite tutte le strade aperte al pubblico che portano a degli insediamenti abitati per tutto l’anno. In comuni rurali la rete viaria agricola è molto estesa. Una buona e sicura accessibilità é una prerogativa per la futura gestione dei
masi. A titolo esplicativo il Comune di Castelrotto conta ben 155 strade che allacciano ben 209 masi, il Comune di Sarentino comprende una rete viaria che raggiunge 342 masi con una lunghezza complessiva di 198 chilometri.

Senza questa capillare rete viaria probabilmente anche in Alto Adige molti masi sarebbero stati abbandonati, con il conseguente ripercussione sul paesaggio e sull’attrattività turistica. La manutenzione, il miglioramento, la messa in sicurezza e il risanamento
di spezzoni di rete viaria rovinati da eventi climatici distruttivi costituisce oggigiorno la maggior parte dell’attività costruttiva nelle strade rurali. La creazione di nuovi tratti riguarda, in prima linea nuovi tracciati per migliorare la viabilità già esistente.
La realizzazione è garantita da enti pubblici e privati
In tutto l’Alto Adige i contadini di montagna di piccoli territori o di frazioni si sono aggregati in interessenze o
associazioni agrarie. Queste associazioni rappresentano i diversi borghi montani o aggregazioni di masi e si preoccupano per la costruzione e il mantenimento delle infrastrutture necessarie. I vantaggi di queste organizzazioni sono evidenti: il diretto interessamento per i progetti con il conseguente coinvolgimento nelle decisioni con soluzioni pragmatiche. Un risvolto da non sottovalutare è lo sgravio delle amministrazioni comunali.
Tuttavia, negli ultimi anni sempre più interessenze e associazioni agrarie si ritirano. Le motivazioni di questo fenomeno sono le restrizioni sempre più vincolanti per la realizzazione di progetti tecnici nonché la sproporzionata burocrazia.
Nell’anno 2022 sono sati finanziati 73 progetti, l’aumentare del contributo é stato di ~21.700.000 Euro.
L’incidenza tendenzialmente in aumento di fenomeni climatici estremi e l’aumento contestuale del traffico pesante si ripercuotano su una maggiore sollecitazione della rete viaria rurale.
b) Misure di sostegno per l’economia montana
Nell’anno 2022 i contributi versati per il miglioramento delle infrastrutture, come fondamenta per le attività produttive e per la salvaguardia del sostentamento degli agricoltori di montagna, sono distribuiti, come segue:
L'anno 2022 ha dimostrato che l'acqua sta diventando scarsa anche in montagna e quindi anche in Alto Adige. La scarsità d'acqua sta costringendo molti concessionari a progettare e
Progetti 2015-21 (Rete viaria rurali LP-50)
Progetti 2022 (Rete viaria rurali LP-50)
realizzare progetti per garantire l'approvvigionamento di acqua potabile e antincendio. Da un lato la domanda è aumentata notevolmente in alcune aree, dall'altro molti sistemi di fornitura stanno invecchiando e devono essere rinnovati.

Nell'ultimo anno sono stati presentati solo per le zone rurali 44 progetti per l'approvvigionamento di acqua potabile e antincendio nelle aree rurali, che in ragione dell'urgenza e dell'inderogabilità sono state finanziate (contributo complessivo: 20.523.384 euro).

c) Sussidi in casi di emergenza (L.P. del 21 ottobre 1996, Nr. 21, Art. 50)
La legge forestale prevede sussidi per iniziative dirette atte all’eliminazione
2.2.7 Caccia e pesca
Fauna selvatica e gestione della fauna
La situazione attuale della fauna selvatica, e quindi la gestione della stessa, con il fine primario di tutelare e di migliorare la natura, ma anche l’agricoltura, la selvicoltura ed in generale le attività umane, rappresenta una continua sfida per l’autorità venatoria, per i cacciatori ed ingenerale per la comunità, poiché bisogna tener conto, oltre che degli equilibri ecologici e biologici, anche degli aspetti socioeconomici. Da un lato, una parte molto preziosa della nostra fauna alpina - in parte utilizzata per la caccia -, dall'altro, alcuni animali selvatici causano anche situazioni di conflitto, se le pretese di utilizzo dell'uomo sono limitate o gli interessi di protezione dei gruppi di tutela degli animali sono prioritari. A causa della complessa normativa e degli opposti punti di vista assumere decisioni che contemperino i diversi interessi e le diverse sensibilità è problematico, anche riguardo alla fauna selvatica cacciabile.
L’Ufficio caccia e pesca conduce censimenti in collaborazione con gli agenti venatori, con gli ispettorati forestali e con l’Associazione Cacciatori Alto Adige al fine di monitorare lo sviluppo delle popolazioni di fauna selvatica. Queste informazioni supportano la pianificazione degli abbattimenti e le misure di tutela e gestione delle specie di fauna selvatica.

di danni causati da avversità atmosferiche, alluvioni, valanghe e smottamenti di terreni ad infrastrutture e per la prevenzione di danni forestale causati da infestazioni di insetti e funghi.
Nel corso dell’anno 2022 sono state concessi 225 sussidi d’emergenza con una somma totale di 2.153.371 euro.
Gestione della fauna selvatica protetta
La maggior parte delle specie di fauna selvatica, sia di mammiferi che dell’avifauna, è protetta e non cacciabile. Particolare attenzione viene riservata alle specie rare e minacciate, nonché a quelle che si trovano all’interno delle aree protette: il parco nazionale dello Stelvio, i parchi naturali, i biotopi e le zone Natura 2000. La conservazione degli habitat viene comunque garantita anche al di fuori di queste zone attraverso le norme urbanistiche e ambientali.
Per alcune specie di fauna selvatica non cacciabile lo status della tutela non è di natura ecologica e gestionale, bensì stabilito giuridicamente. Molte specie a suo tempo minacciate se non estinte, come ad esempio alcuni rapaci diurni e notturni, sono oggi presenti con numeri rassicuranti. Dopo la sua reintroduzione nelle Alpi, il gipeto (Gypaetus barbatus) nidifica con successo nella parte occidentale della provincia, mentre nel territorio provinciale vivono almeno 70 coppie di aquile reali (Aquila chrysaetos). Insieme alla Stazione Ornitologica Svizzera ed al Max-Planck-Institut è in atto
uno studio su giovani aquilotti dotati di sensore GPS.
Val d’Isarco; spesso è minacciato dalle attività antropiche, per esempio nel caso di impatti con le linee elettriche aeree. L’airone cinerino (Ardea cinerea) si spinge fino all’interno delle valli alpine, mentre alcune colonie nidificanti sono stabilizzate nei fondivalle principali.
Risulta, di contro, problematica la situazione per quelle specie che necessitano di habitat particolari, in provincia quasi del tutto assenti: principalmente quelle che frequentano le zone umide. Anche il gallo cedrone (Tetrao urogallus) diventa sempre più raro. Una recente rilevazione delle arene di canto storiche nei distretti occidentali, effettuata dalla Forestale coadiuvata dagli agenti venatori e dai cacciatori, ha dimostrato che diverse tra esse risultano abbandonate. Ciò avviene per cause diverse e molteplici, di regola però di origine antropica.
I grandi predatori orso (Ursus arctos) e lupo (Canis lupus), invece, si dimostrano estremamente adattabili e riconquistano in continuazione nuovi spazi, generando spesso conflitti con le attività umane.
Degna di nota è la sempre più spesso confermata presenza dello sciacallo dorato (Canis aureus), immigrato naturalmente in Alto Adige, dove si sta rapidamente espandendo. La faina (Martes foina) è molto diffusa nei pressi ed anche all’interno degli insediamenti urbani. Sempre più raramente viene segnalata la presenza della martora (Martes martes). Il tasso (Meles meles) si sta espandendo nelle aree di mezza montagna. Soprattutto nel Nord e nell’Est della provincia è stata riscontrata la presenza di puzzole (Mustela putorius). Nella Drava si è stabilizzata una piccola popolazione di lontra (Lutra lutra), specie endemica un tempo assai diffusa in Alto Adige. Nell’estremo oriente della provincia è comparso anche il più grande roditore europeo, il castoro (Castor fiber), proveniente dalla vicina Austria dove è ormai una specie stabile, mentre l’individuo avvistato in Alto Adige è per ora l’unico sul territorio. La presenza della faina nei centri urbani è frequentemente causa di conflitti con le attività umane. Con decreto è stato perciò prevista la possibilità di catturarla con trappole a cassetta in corrispondenza di edifici sia pubblici che privati, per ragioni di sicurezza e per prevenire danni. Gli animali vengono in tal caso catturati dagli organi di vigilanza venatoria per essere liberati lontano dagli insediamenti urbani.
Sulla base di un parere dell’osservatorio faunistico provinciale, tramite decreti dell’Assessore competente, possono essere autorizzati prelievi di controllo di capi di specie non cacciabili o l’ampliamento del periodo di caccia per specie già cacciabili, se queste si sono espanse in modo tale da danneggiare l’equilibrio ecologico, le produzioni agricole e selvicolturali, la pesca, altri selvatici, ed infine nel caso in cui sussiste il rischio di pregiudicare la sicurezza o la salute delle popolazioni umane. Nel corso del 2021 sono stati emessi tre decreti che hanno autorizzato l’abbattimento di complessivi 5 tassi.


A tutela della specie ittiche autoctone, in particolare il temolo (Thymallus thymallus) e la trota marmorata (Salmo marmoratus) sono stati prelevati tra gennaio e marzo 2021 56 esemplari di cormorano (Phalacrocorax carbo) al fine di contenerne la presenza in co-

stante crescita lungo i nostri sensibili corsi d’acqua alpini.
Lo sciacallo dorato: un nuovo abitante
Gli sciacalli dorati (Canis aureus) sono in piena avanzata in tutta Europa e si espandono dal sud-est Europa in direzione nord. Nell’anno 2022 sono stati ritrovati cinque sciacalli deceduti. Tutti gli esemplari sono deceduti a causa di incidenti automobilistici, in particolare due esemplari nella zona di San Giorgio/Brunico, un esemplare in zona Campo Tures, Monguelfo-Tesido. Ulteriori accertamenti sono stati effettuati ad Aldino, Villandro, Fortezza, Naz-Sciaves, Dobbiaco, Campo di Trens e Gais.
È regolare in Alto Adige l’afflusso di orsi bruni maschi
Negli ultimi anni, la presenza di orsi bruni (Ursus arctos) nella provincia di Bolzano è diminuita notevolmente. Solo nella parte sud-occidentale del Paese, classificata come area di migrazione, sono stati raccolti nuovamente singoli record. Nell’anno 2022, nella provincia di Bolzano, è stato possibile possibile riconoscere due esemplari di orsi maschi. Si tratta in questo caso degli esemplari M75 (3 anni) e M86 (2 anni).
Le prime evidenze del grande plantigrado sono state nella zona del bosco di Monticolo. Tra la fine di aprile e l’inizio di maggio sono stati certificati diversi attacchi ad alveari.
A metà maggio l’orso M75 ha saccheggiato diversi alveari nella zona di Tarres. Questo orso dell’età di tre anni era già stato riconosciuto tramite un’analisi genetica, nel 2021, attraverso la zona di Marlengo. Anche all’ora era stato riconosciuto tramite un’analisi genetica, anche in quel caso si trattava di un attacco a degli alveari, mentre l’orso M86 è stato acquisito il patrimonio genetico solamente nel 2022. L’avvistamento dell’animale è stato grazie a delle fotografie mentre si stava nutrendo in un prato a San Pancrazio. L’animale era molto scheletrico e ferito. Ulteriori avvistamenti sono stati effettuati verso la fine di luglio/inizio agosto nella zona di Malles e Senales. Lì è stata confermata la morte di alcune pecore per un attacco di un grande carnivoro.
L’ultimo avvistamento dell’orso nel 2022 è stato sul Renon. A metà otto-
bre è stato fotografato un esemplare tramite fototrappola.
Per i danni causati dall’orso la provincia ha pagato una retribuzione di 6.379, -€.
Grazie all’analisi genetica, negli ultimi 22 anni, è stato possibile riconoscere 34 orsi differenti all’interno della provincia di Bolzano. Fino ad ora (ad eccezione dell’orsa Vida) sono stati identificati solamente esemplari di sesso maschile. Gli anni con la più alta presenza di orsi sono stati rispettivamente il 2011 ed il 2013 con ognuno 7 esemplari.

Il lupo prende sempre più piede
Su tutto il territorio dell’Alto Adige è stato possibile acquisire il patrimonio genetico di ventotto diversi lupi

(Canis lupus) durante il 2022. Di questi esemplari diciannove erano di sesso maschile e nove di sesso femminile. Di ventotto esemplari, ventiquattro discendono dalla popolazione italiana, mentre gli altri quattro esemplari discendono dalla popolazione dinarica. Di questi ventotto esemplari, sette erano già stati rilevati negli anni precedenti. Sulla base dei dati del 2022 si può stimare una popolazione minima di 50 individui. Sulla base delle prove raccolte e le discussioni con le province vicine che anch’esse hanno branchi di lupi, si è arrivati alla conclusione che si tratta di branchi interprovinciali. Quest´ultimi di trovano nelle zone dell’Alta Val di Non, alta Val d’Ultimo, Latemar, alta Val Gardena e Dobbiaco. I danni causati dal lupo verso animali
2.2.7
da produzione, hanno generato una retribuzione per i danni di 103.007, -€.
Attraverso alle analisi genetiche, negli ultimi 13 anni, è stato possibile riconoscere 74 lupi differenti all’interno della provincia di Bolzano.
Management delle specie invasive di mammiferi
A livello europeo e nazionale è stata redatta una lista delle specie animali non autoctone invasive, che a causa dell’impatto negativo che esercitano sugli ecosistemi locali devono essere tenute sotto controllo e se possibile del tutto eliminate. Nel Sud della provincia si trova con una certa frequenza la Nutria (Myocastor coypus). Nell’ultimo anno ci sono state anche singole prove di nittereute o cane procione (Nyctereutes procyonoides) e procione o meglio conosciuto come orsetto lavatore (Procyon lotor).
Management delle specie di fauna selvatica cacciabili
Il capriolo (Capreolus capreolus) rappresenta la specie numericamente prevalente di ungulato allo stato libero, è presente su tutto il territorio provinciale e viene cacciato in tutte le riserve di caccia. Il prelievo annuale si aggira intorno a 7.017 capi. La diffusione del camoscio alpino (Rupicapra rupicapra) è condizionata dalla rogna sarcoptica, per cui varia da zona a zona; si sta oltretutto espandendo sempre più in basso, raggiungendo i pendii ed i fondivalle anche delle Valli d’Adige e Isarco. La rogna sarcoptica provoca in alcune zone gravi perdite: in tutta la provincia sono stati segnalati nel 2022 187 casi di rogna, un evidente incremento a confronto dei 155 casi

dell’anno precedente, causando però gravi perdite in ambiti locali come nei monti di Fundres, la parte orientale delle Dolomiti e la val Badia. Dai dati recenti si può ipotizzare una diffusione della malattia altamente infettiva della selvaggina causata dall'acaro della rogna nelle aree forestali di camoscio della bassa Atesina. L'areale di caccia nel 2022 è di 3144 animali. La gestione professionale del camoscio richiede indagini sulla popolazione per consentire un prelievo venatorio conforme al mantenimento del buono stato di conservazione.
«« Lo sviluppo della rogna sarcoptica del camoscio in Alto Adige è visualizzato in figiura 11 su pagina 221.

Anche il cervo (Cervus elaphus) è presente in tutto il territorio provinciale, con un aumento progressivo di consistenza sia nelle zone vocate che in quelle periferiche. Nei piani di abbattimento è stato sensibilmente incrementato il numero di prelievi nelle
riserve di caccia dell’alto Adige, per tenere anche conto dei danni arrecati alle foreste. Nelle riserve di caccia dell'Alto Adige non sono mai stati abbattuti tanti cervi quanti nel 2022, ovvero ci sono stati 4.223 abbattimenti. Nonostante ciò, il piano di abbattimento del cervo dell’anno 2022 è stato completato per l´83%. Oltre al fatto che le popolazioni di selvaggina ungulata generalmente traggono vantaggio dai cambiamenti climatici, la mancanza di regolamentazione in alcune parti del Paese potrebbe causare un ulteriore aumento di questa specie di selvaggina. Deve essere inoltre tenuto conto che, l'aumento della pressione venatoria si traduce in una cacciabilità sempre più difficile. I cervi si stanno trasformando da ruminanti originariamente diurni e da specie di selvaggina delle campagne aperte, in animali notturni e sono stati ricacciati nelle aree forestali soggette a conflitti. Con l’aumento dell'uso ricreativo, i disturbi di ogni tipo e la pressione

Lepre bianca o variabile
Stambecco liberato sull'habitat del cervo la situazione si sta aggravando sempre di più. A lungo termine, sarà necessaria una gestione integrale del cervo per tenere sotto controllo questa specie di selvaggina in un'area montana come l'Alto Adige.
«« Lo sviluppo della presenza del cervo in provincia di Bolzano è visualizzato in figiura 19 su pagina 222.
Nelle zone con maggior presenza di cervi quali la Val Venosta bisogna prendere provvedimenti più concreti, in modo da preservare i boschi di protezione e l’equilibrio fra la fauna selvatica e l’agricoltura. Le recinzioni per le colture agrarie, anche solo per i prati, sono in continuo aumento benché questo non corrisponda all’ indirizzo colturale provinciale.
Dal 2012 viene condotto un rilievo sistematico degli incidenti stradali con ungulati. Nel 2022 sono stati registrati dagli agenti venatori di professione 908 incidenti con conseguenze mortali per l’animale selvatico (717 caprioli, 119 cervi, 40 volpi, 28 tassi e 2 camosci), mentre nell’anno precedente erano 931. In molti dei tratti incidentati sono stati attivati dei progetti pilota
Statistica dei prelievi 2022
in collaborazione con il servizio stradale, per testare l’efficacia delle misure di prevenzione. I distretti di caccia sono supportati dall'amministrazione provinciale nell'acquisto di riflettori di segnalazione della selvaggina per i tratti stradali particolarmente critici. Le misure per collegare gli habitat e ripristinare i corridoi faunistici interregionali possono includere anche la costruzione di ponti per la fauna selvatica.
Occasionalmente s’incontra il cinghiale (Sus scrofa), che qua e là si fa notare per i danni che provoca all’agricoltura. Con un totale di 9 capi (1 femmina, 8 maschi), sono stati uccisi più del doppio dei cinghiali rispetto all'anno precedente (4 capi nel 2021).
Nella confinante Valle di Fassa è da tempo presente una popolazione di muflone (Ovis musimon), dalla quale questa specie alloctona di ungulato in diverse occasioni sconfina nella zona del Catinaccio e dalla quale, negli ultimi anni, sono stati prelevati alcuni individui. La specie di selvaggina alloctona è ecologicamente problematica e compete con altri ruminanti selvatici.
Nella zona da Appiano fino a Tesimo alla cresta della Mendola nel 2019 è inspiegabilmente nata una piccola popolazione di mufloni. La rimozione completa di questi animali di origine sconosciuta è stata effettuata immediatamente dagli organi di protezione della caccia dell'autorità forestale.
La lepre comune o europea (Lepus europaeus) trova un habitat ad essa confacente soprattutto fra gli impianti frutticoli nei fondivalle ed è negli stessi diventata ovunque numerosa. Meno numerosa risulta nelle zone di montagna.
Poco si sa della lepre bianca o variabile (Lepus timidus) ma dagli abbattimenti effettuati si presume il numero degli esemplari della specie essere costante. La specie arcto-alpina dovrà affrontare problemi con l'aumento delle temperature e probabilmente risulterà perdente nei cambiamenti climatici, motivo per cui è necessario prestare particolare attenzione alle tendenze della popolazione.


Innanzitutto, va ribadito che, con l’adeguamento del periodo di prelievo alla legge quadro statale avvenuto nel 2013, la popolazione di volpe (Vulpes vulpes) è cresciuta. Con decreto dell’Assessore competente è stato anticipato l’inizio della stagione di caccia alla volpe a partire dal 15 luglio 2022, per incrementarne il prelievo nel periodo in cui si verificano più numerose le predazioni di pollame e negli habitat dei tetraonidi. Del complessivo prelievo venatorio di 1.805 volpi ben 1.149 sono state abbattute durante il periodo aggiuntivo di apertura della caccia sancito col decreto predetto assessorile.
La norma di attuazione allo Statuto d’Autonomia approvata con D.lgs. 11 dicembre 2016, n. 240 ha consentito all’Amministrazione Provinciale per la prima volta di autorizzare il prelievo venatorio di specie protette dalla Legge statale.
Di questa eccezionale possibilità, unica in Italia, ha fatto uso l’Alto Adige a partire dal 2017 per quanto riguarda lo stambecco (Capra ibex) e la marmotta (Marmota marmota). Dopo aver ottenuto i pareri degli esperti e l'approvazione del Ministro dell'Ambiente e dell'Agricoltura, il Governatore ha emesso il decreto per il "Piano di gestione del cervo 2022-26" e il "Piano di gestione della marmotta 2022-26" nel luglio 2022.
La popolazione di stambecchi in Alto Adige, che nel frattempo è cresciuta fino a circa 2.000 esemplari, consente una caccia prudente. Oltre alla caccia, il concetto di gestione prevede anche il prelievo o la cattura per la marcatura o la reintroduzione in piccole colonie
di selvaggina di roccia in Alto Adige. L'obiettivo è raccogliere nuove conoscenze scientifiche su questa specie di selvaggina d'alta montagna per migliorare ulteriormente la gestione e contribuire alla ricerca su questa specie di bovidi.


Nella primavera del 2022 sono state effettuate 14 catture. Di questi, 10 giovani femmine e maschi di stambecco sono stati catturati nella metapopolazione di Resia-Brennero e rilasciati a Pfunders (colonia di Eisbrugg), mentre 2 individui sono stati trasmessi per scopi scientifici nell'ambito del progetto Interreg Terra Raetica nel Weißkugel. Tre individui sono stati marcati a livello nazionale. Nella metapopolazione tra Resia e Brennero sono stati abbattuti un totale di 70 esemplari di stambecco. Il nuovo concetto di gestione approvato per lo stambecco 2022-26 non esclude più un prelievo venatorio nella colonia di Sesvenna, che è collegata alla popolazione dei vicini Grigioni.
Il Piano prevede, insieme alla costituzione ed al rafforzamento di nuove colonie, anche il prelievo venatorio dello stambecco. Nella primavera 2021 ne sono stati catturati complessivamente 16 tra giovani maschi e femmine, poi liberati in Val d’Ultimo. Da ciò è derivata la possibilità di un assegnare un prelievo venatorio di 38 capi nella metapopolazione tra i Passi Resia e Brennero, che è stato effettuato. Le linee guida ISPRA per la valutazione dello stato di conservazione sono soddisfatte perché la colonia è considerata affine alle colonie svizzere. Da questa colonia, 2 individui sono stati prelevati
con la caccia nel 2022 come parte del concetto di gestione.
Molto diffusa nel territorio provinciale è la marmotta: la popolazione stimata è dell’ordine dei 57.000 individui. Con analogo modus operandi è stato predisposto per 92 riserve di caccia un piano di prelievo venatorio della marmotta, nel quale un terzo dei prelievi previsti erano da effettuarsi nelle zone dove la Forestale aveva certificato casi di danni da marmotta.

Complessivamente sono state prelevate 1.184 marmotte, di cui circa la metà in zone dove infrastrutture e/o prati falciabili erano stati danneggiati in modo consistente dagli scavi delle marmotte.
Alcuni galliformi e anatre possono essere oggetto di prelievo venatorio sostenibile. Per i tetraonidi e per la coturnice è prevista una valutazione d’incidenza per prevenire qualsiasi rischio per lo stato di conservazione soddisfacente delle specie interessata.
Dal 2008 i galliformi vengono sistematicamente censiti. I censimenti annuali dei galli forcelli o fagiani di monte (Lyrurus tetrix), delle pernici bianche (Lagopus muta) e delle coturnici (Alectoris graeca) costituiscono il presupposto per i piani di abbattimento di tali specie e vengono eseguiti dalle stazioni forestali e dal personale esperto dell’Ufficio Caccia e Pesca. Al momento la popolazione di fagiani di monte ha una consistenza stabile con poche eccezioni, quella delle pernici bianche è stagnante, mentre la coturnice è in regresso anche a causa dell’inverno particolarmente nevoso e sta recuperando lentamente. Per questa ragione nel 2022 solo i piani di abbattimento
del Gruppo di Tessa e Ultimo-Maddalena è stata data la possibilità di abbattere alcuni esemplari di coturnici, mentre nell’anno precedente non era stato concesso a nessuno su tutto il territorio della provincia. Ulteriori dettagli e sviluppi sono contenuti nelle relazioni sulla situazione dei volatili selvatici in Alto Adige pubblicate annualmente in autunno dall'Ufficio Caccia e Pesca.
Per il controllo delle malattie della fauna selvatica annualmente numerose carcasse di animali abbattuti o trovati morti vengono inviati all’istituto zooprofilattico per essere analizzati. È stato intensificato il monitoraggio
2.2.8 Caccia
In Alto Adige l’attività venatoria è possibile in poco più di 623.200 ettari di territorio (84% della superficie provinciale), suddivisi in 145 riserve di caccia di diritto e 51 riserve private. Queste ultime si estendono per circa 14.000 ettari (2% della superficie provinciale). Della superficie provinciale rimanente, 65.000 ettari sono oasi di protezione faunistica demaniale e 52.500 ettari (tra cui il Parco Nazionale dello Stelvio) bandite, in cui la caccia è proibita. I complessivi 2.963 ettari che rappresentano la superficie dei 226 biotopi protetti, che sono per la legge venatoria oasi di protezione faunistica, sono ricompresi nelle rispettive riserve ovvero nella superficie della bandita in cui si trovano. Nei biotopi la caccia è assolutamente proibita, se di superficie inferiore ai 10 ettari; nei 56 biotopi con superficie maggiore di 10 ettari è invece consentito il controllo degli ungulati e, per motivi sanitari, quello della volpe.
Nelle riserve di diritto la sorveglianza viene garantita dall'attività di 66 agenti venatori di professione, dipendenti delle singole riserve di caccia e dell'Associazione Cacciatori Alto Adige. Nelle riserve private invece il servizio di
Presenza di galliformi a livello provinciale, piano d’abbattimento e prelievo:
dell’echinococcosi alveolare, facendo analizzare cadaveri di volpe rinvenuti in tutto il territorio provinciale al fine di migliorare le conoscenze sulla diffusione di questo parassita. In Val di
Fleres gli stambecchi si ammalano di pedaina in misura sempre più consistente.
vigilanza è garantito soprattutto da agenti venatori volontari. Nel Parco Nazionale dello Stelvio, invece, la sorveglianza è garantita dagli appartenenti al Corpo Forestale provinciale. Nell’anno 2022 nelle riserve di diritto 5.622 cacciatori erano detentori e detentrici di permessi annuali e permessi d’ospite; di essi 383 erano donne.
La legge provinciale sulla caccia stabilisce che gli obiettivi della politica venatoria sono la conservazione della biodiversità e di un buono stato di salute nella fauna nonché la protezione ed il miglioramento degli ambienti naturali mediante una gestione attiva della fauna selvatica. Il prelievo ecosostenibile degli ungulati e dei galliformi è determinato dai piani di abbattimento. Dal dialogo “Feld-Wald-Wild” (=campo-bosco-fauna) tra l’Unione Agricoltori e Coltivatori diretti Sudtirolesi (=SBB), l’Associazione Cacciatori Alto Adige e le Ripartizioni Foreste e Agricoltura escono periodicamente linee guida per contemperare gli interessi legittimi
Danni da fauna selvatica
Uno dei principali compiti della caccia è evitare che si verifichino danni da fauna selvatica. Il risarcimento dei danni causati da fauna selvatica cacciabile viene effettuato, di norma, dalle riserve competenti per territorio. A parziale copertura di danni causati da mammiferi non cacciabili, rapaci e lepri, sono previsti contributi da parte
dell’amministrazione provinciale. Di rilevanza economica risultano essere i danni al raccolto causati dal ghiro e i danni alle galline ovaiole da parte di volpe e faina.
Per danni da orso, lupo e sciacallo dorato tempestivamente denunciati e confermati dall’autorità venatoria è previsto il risarcimento nella misura del 100% del danno subito.
È fondamentale che vengano poste in essere tutte le misure di prevenzione, in modo da prevenire situazioni conflittuali. Per questo l’amministrazione provinciale concede contributi per opere di prevenzione di danni, come recinzioni, griglie antiselvaggina nonché recinzioni elettriche. Ciò principalmente a protezione dei frutteti e delle vigne da danni da cervo e capriolo. Nel 2022 alcune malghe hanno realizzato nuove opere di prevenzione contro danni causati da grandi carnivori.2.2.9
2.2.9 Acque da pesca e popolamenti ittici
Geograficamente, l'Alto Adige occupa una posizione climatica particolare a causa della sua posizione interna alpina sul bordo meridionale delle Alpi, che si riflette nella diversità dei suoi corpi idrici. La successione di diverse altitudini in un'area molto limitata ha permesso lo sviluppo di numerosi tipi diversi di corpi idrici, ognuno con la sua flora e fauna caratteristica. Ogni specie ittica ha requisiti molto specifici per il suo habitat e le condizioni ambientali associate. Affinché una specie ittica possa stabilirsi permanentemente in un luogo, nell’ecosistema acquatico ivi presente devono essere presenti le condizioni idonee a tutti gli stadi di vita di un pesce. Solo una ridotta frazione delle acque dell'Alto Adige ha le caratteristiche per essere considerata un habitat ittico sostenibile.

Acque da pesca in Alto Adige
L'Alto Adige ha un sistema di corsi d'acqua di oltre 9.500 chilometri che si estende dai bacini montani e comprende anche i fossi della vallata. Di questi, solo circa 1.600 chilometri possono essere utilizzati per la pesca. Ciò corrisponde a una superficie d'acqua di circa 1200 ettari.

Le acque ferme sono distribuite a tutti i livelli altitudinali della provincia. In totale esistono circa 350 acque ferme, di cui solo il 20% utilizzabili per la pesca. I laghi naturali con una superficie complessiva di 520 ettari ne costituiscono la parte più piccola. La maggior parte delle acque ferme è composta dai laghetti artificiali e costituiscono all’incirca 1200 ettari.

La maggior parte delle acque viene classificata come acque salmonicole. Si tratta di acque a scorrimento veloce e a bassa temperatura, nonché di laghi di alta montagna e di montagna tipici del paesaggio alpino. Le acque ciprinicole, sono principalmente i laghi della bassa atesina, i fossi a lento scorrimento con un profilo a temperatura calda e i singoli stagni, invece,

rappresentano solo il 6% delle aree acquatiche per pesci. Non tutte le acque dell'Alto Adige sono soggette alla legge provinciale sulla pesca: lo sono le acque che erano già registrate nella "vecchia" lista delle acque pubbliche, relativa all’anno
1943, e quelle collegate in modo diretto con le suddette. La legge provinciale sulla pesca non viene invece applicata in alcuni laghi montani e alpini, negli stagni senza afflusso e deflusso o solo con afflusso, e nei laghetti realizzati artificialmente con opere di scavo.
Più del 90% delle acque da pesca è soggetto ad un diritto esclusivo di pesca. Il diritto può essere posseduto da persone private o da associazioni private o pubbliche. In Alto Adige i diritti di pesca non dipendono dalla proprietà delle particelle fondiarie interessate e pertanto possono essere venduti liberamente a chiunque in qualsiasi momento. Il diritto di pesca sulle acque da pesca non gravate da diritti privati appartiene alla Provincia Autonomia di Bolzano, che lo assegna in concessione alle associazioni di pesca locali.
Consistenza ittica
Nella primavera del 2022 sono stati effettuati in tutta la provincia dall'Ufficio della caccia e pesca i rilievi per quantificare la densità degli avannotti nelle acque salmonicole. È stata confermata una buona riproduzione naturale di trote (74 individui/100m), mentre è stata confermata una ripro-




duzione naturale moderata di temoli (33 individui/100m) nelle acque principali dell'Alto Adige. In generale le acque correnti naturali non soggette ad eventi che incidono negativamente su di esse, come l’innalzamento e l’abbassamento repentino del livello, lo svaso dei bacini idroelettrici, la canalizzazione, la mancanza di habitat

idoneo, la mancanza di materiale ghiaioso, gli uccelli ittiofagi e le inondazioni naturali, hanno popolazioni ittiche ben strutturate.
La trota marmorata (Salmo marmoratus) e il temolo (Thymallus thymallus) sono le specie ittiche principali delle acque correnti più grandi situate nel bacino acquifero dell'Adige. Entram-

be le specie denotano un’insufficiente strutturazione delle classi di età ed una biomassa molto bassa. Soprattutto nei corsi d'acqua principali la situazione diventa particolarmente acuta per effetto della complessa combinazione di numerosi fattori negativi. Questo rende particolarmente difficile qualsiasi misura per proteggere e sostenere le specie ittiche autoctone. Nel caso della trota marmorata, la situazione è ulteriormente aggravata dal fatto che le popolazioni sono fortemente ibridate con la trota fario e in molti casi solamente le analisi genetiche consentono di distinguere le due specie.
Lo stato di qualità dei corpi idrici dell’Alto Adige viene tenuto costantemente sotto controllo, così come stabilito dalle normative europee ed italiane. In oltre 100 punti di campionamento distribuiti nelle maggiori
2.2.10
Pesca La gestione delle acque è curata da più di 100 acquicoltori. Tra i diritti di pesca si trovano ancora alcuni diritti di mensa risalenti al Medioevo, vale a dire diritti di pesca originariamente
acque correnti dell’Alto Adige vengono raccolti con continuità molteplici parametri biologici e chimici, inclusi quelli relativi alla fauna ittica tramite campionamento con elettrostorditore
effettuato dall’Ufficio caccia e pesca. Ciascun punto stabilito deve essere sottoposto a campionamento ogni sei anni. Nel 2021 il popolamento ittico è stato monitorato in 26 acque diverse.


limitati al fabbisogno di una famiglia. Le diverse associazioni di pesca ed i titolari di diritti esclusivi garantiscono la sorveglianza tramite guardiapesca volontari.

Nell’anno 2022 sono state emesse 4499 permessi annuali e 14573 permessi giornalieri. In totale sono state registrate 37439 uscite di pesci, che corrispondono ad una biomassa di 15204kg. Le specie preferite sono state la trota fario e la trota iridea, men-
tre il coregone e il salmerino alpino sono stati i più popolari sui laghi.
Obiettivi della pesca
L’obiettivo principale della pesca altoatesina è la protezione, la conservazione e, dove possibile, il miglioramento della qualità e della quantità delle acque da pesca come base per un esercizio sostenibile della pesca. Un altro obiettivo importante è la protezione della trota marmorata, una specie di salmonide autoctona tipica dei grandi fiumi dell'Alto Adige. Nel rispetto delle disposizioni previste dal documento iniziale elaborato nell’anno 2016 che indica le misure di sostegno per la trota marmorata, la produzione di materiale di ripopolamento viene effettuata utilizzando un controllo totale della qualità genetica di tutti i pesci utilizzati.
È stato anche concordato che in futuro solo le uova fecondate e i primi stadi giovanili della trota marmorata potranno essere usati per il ripopolamento delle acque da pesca. Come pesci madre saranno utilizzati quasi esclusivamente pesci selvatici catturati poco prima della stagione della deposizione autunnale delle uova e controllati geneticamente prima della spremitura, per essere liberate subito dopo nelle loro acque originarie. Eventuali pesci madre di allevamento devono appartenere alla prima generazione di pesci selvatici: ulteriori generazioni di pesci madre di allevamento non sono consentite. La custodia dei pesci madre, la deposizione e la crescita degli avannotti avvengono in condizioni naturali o seminaturali.
Misure di sostegno della specie autoctona trota marmorata
Essendo la tutela e la promozione della trota marmorata uno dei punti di forza della politica alieutica in Alto Adige, dal 1994 sono stati individuati dei cosiddetti “tratti da marmorata” per i quali sono state previste le semine di giovani marmorate allevate con il sostegno dei fondi finanziari provenienti dalle rendite da produzione idroelettrica delle acque altoatesine. Dall’inverno 2017/2018 sono state effettuate in collaborazione con gli acquicoltori competenti catture di trote marmorate ed è stato prodotto materiale di semina della stessa specie secondo degli standard di qualità predefiniti. Tale materiale di semina è stato assegnato a seguito di una valutazione comparata, su basi oggettive,
delle diverse acque e tenendo conto delle linee guida elaborate per la pesca, sia in forma di uova che di avannotti, alle acque-marmorata. Complessivamente, tenendo conto anche degli incubatoi privati di valle, negli ultimi anni sono stati allevate e seminate le seguenti quantità di trota marmorata:
l'unica specie di gambero autoctona in Alto Adige. Lo stato di conservazione delle popolazioni autoctone del gambero di fiume deve essere classificato come critico con l'identificazione di solo sei luoghi con rilevamenti positivi in tutta la provincia nel periodo dal 2016 al 2022. Per garantire che questa
Per mezzo di queste articolate misure i popolamenti selvatici autoctoni di trota marmorata sono sostenuti in modo consistente, tale da grantirne la conservazione nel lungo periodo.
Gamberi di fiume
Nell'ambito del progetto di conservazione delle specie "Gamberi di fiume dell'Alto Adige", l'Ufficio caccia e pesca coordina i rilevamenti a livello provinciale sulla distribuzione delle specie di gamberi di fiume e sullo stato del pericolo di estinzione del gambero di fiume (Austropotamobius pallipes),
specie di gamberi non corra il rischio di scomparire del tutto si è già iniziato, dopo apposite analisi genetiche, ad eseguire una protezione del patrimonio genetico di due areali nell’area del Centro Tutela Specie Acquatiche provinciale a Scena. Sulla base della prima riproduzione di questi patrimoni genetici, il progetto sembra promettente. Oltre al gambero europeo (Astacus astacus), classificato come naturalizzato, si trovano sul territorio provinciale tre "specie invasive aliene d'importanza comunitaria europea": il gambero dal segnale, il gambero
americano e il gambero rosso della Louisiana. Per queste specie sono state pianificate e attuate misure specifiche per controllare e contenere la loro diffusione e, dove possibile, per eradicarle. Per esempio, come lotta biologica contro il gambero rosso della Louisiana è stata effettuata una semina di anguille giovani nel lago di Caldaro e nella fossa di Caldaro.
In altri posti il prelievo di gamberi di fiume invasivi è stato effettuato usando delle nasse. In questo contesto sono stati prelevati in un affluente dell’Aurino vicino il paese San Giorgio nel periodo dal 2019 fino al 2022 e ogni anno le seguenti quantità di gamberi dal segnale; 607, 1.097, 744 e 1.321. Nello stesso periodo, individui di tutte le classi di età di gambero rosso della Louisiana, recentemente identificato, sono stati prelevati, dalle fosse della Bassa Atesina nel 2022, circa 224 esemplari. Infine, ai sensi del regolamento UE n. 1143, viene data grande importanza alle misure preventive. Queste comprendono la regolamentazione con restrizioni delle semine e dell’esercizio dell’attività alieutica facendo uso delle esche naturali, nonché la sensibilizzazione della popolazione attraverso un programma articolato di pubbliche relazioni.
Esami di caccia e di pesca, rilascio di attestati

L’esercizio della caccia e della pesca sono vincolati all’ottenimento di un documento di idoneità conseguente al superamento dei rispettivi, appositi esami organizzati dall’Ufficio caccia e pesca.
Gli esami di caccia hanno avuto luogo regolarmente. Nel 2022 sono state emesse 219 nuove abilitazioni all’esercizio venatorio.
La richiesta di un permesso di caccia fuori provincia è stata inoltrata da 203 cacciatori residenti in Alto Adige. Da novembre 2021 gli esami di pesca sono organizzati in da non avere più un’unica sessione d´esame, bensì in modo da avere più sessioni in un anno con un massimo di 57 candidati a sessione, che nell´anno 2022 sono state sette.

Nel 2022 sono state emesse 272 nuove licenze ministeriali per la pesca, mentre 666 sono state rinnovate. Inoltre, l’Ufficio competente per la pesca ha emesso 933 licenze per stranieri. Circa 13.100 persone sono in possesso di una licenza di pesca valida.
Sorveglianza e controllo
Siccome nell’anno 2021 è stato organizzato un corso per le guardie di sor-
veglianza, non ne è stato organizzato uno per l’anno 2022.
I decreti di nomina a guardia giurata particolare per il settore caccia e pesca, di durata biennale, sono di competenza del direttore dell’Ufficio caccia e pesca. Nel corso del 2022 sono stati emessi 183 decreti.
Sostegni economici nel settore caccia e pesca
a) Risarcimento danni da selvaggina e contributi per la prevenzione di danni
Gli articoli 37 e 38 della legge provinciale sulla caccia (nr.14 del 17/07/1987) prevedono risarcimenti per i danni da selvaggina, nonché l'erogazione di contribuiti per la prevenzione degli stessi.
Riguardo alle misure di prevenzione contro i danni da animali selvatici (recinti, barriere e reti di protezione) sono state finanziate in tutto 82 richieste (21 recinti, 53 opere di difesa per apiari, 3 rete e 5 opere di prevenzione contro i grandi predatori) con una spesa complessiva di 171.986,04 €.
Nel 2022 sono state corrisposte 213 richieste di indennizzo immediato per un ammontare complessivo di 157.707,28 €:
• 165 richieste con riferimento a danni provocati da grandi predatori. Sono stati indennizzati con complessivi
138.066,16 € 3 apiari, 506 pecore, 9 capre e 2 daini. I danni agli apiari sono stati provocati dall’orso. 5 casi di danno si riferiscono a predazioni dello sciacallo dorato (12 pecore).
Circa il’92% dei danni hanno riguardano predazioni di pecore e capre da parte del lupo.
• 43 richieste con riferimento a danni provocati da piccoli predatori come
volpi o faine. Sono stati indennizzati 1.108 polli e 5 agnelli, con un costo complessivo 10.623,20 €.
• 5 richieste con riferimento a danni alle culture. Sono stati indennizzati, con complessivi 9.017,92€ per danni da morso causati da ghiri.
b) Contributi per la conservazione del patrimonio faunistico ed ittico Per la conservazione e la tutela del patrimonio faunistico ed ittico e per sostenere le corrispondenti misure intraprese sono previsti sussidi sia dalla legge provinciale sulla pesca che dalla legge provinciale sulla caccia.
Nel 2022 sono stati erogati contributi all’Associazione Cacciatori Alto Adige ed alle Riserve per interventi di gestione faunistica, compresa la costruzione di celle frigo, per complessivi 707.250,00 €, a centri di recupero per l’avifauna autoctona per 30.000 €, all’Unione Pesca Alto Adige e ad alcuni acquicoltori per la conservazione ed il miglioramento dei popolamenti ittici per 45.514,14 €.
Sanzioni nel settore della caccia e pesca L'Ufficio istruisce i procedimenti amministrativi delle sanzioni conseguen-
Sanzioni amministrative 2022 nei settori caccia, pesca e CITES
2.2.11 Autorizzazioni e pareri
Cambiamento di coltura
Per cambio di coltura si intende la trasformazione di un bosco in altra qualità di coltura (p.es. prato, pa-
scolo, vigneto…) o in superficie con altre destinazioni d´uso (es. pista da sci, parcheggio, zona per insediamenti produttivi…). Un cambiamento di cultura è un cambiamento definitivo e permanente dell’utilizzazione di un terreno boscato. Nell’anno 2022 sono stati autorizzati cambiamenti di coltura per una superficie boschiva complessiva di 52,00 ha.
Commissione tecnica
Nella commissione tecnica secondo l’art. 2 della L.P. 23/1993 sono
ti all'attività di sorveglianza svolta dai Forestali, dai guardiacaccia e dai guardiapesca. Nel corso del 2022 sono stati portati a compimento e quindi notificati - vedasi tabella sopra - 216 procedimenti di sanzione. Sono stati inoltre sanzionati con la sospensione del permesso di caccia, una sanzione accessoria prevista per diverse infrazioni alla legge sulla caccia, 123 cacciatori.
stati valutati nel 2022 complessivamente 381 progetti - progetti della Ripartizione Opere idrauliche, della Ripartizione Foreste, dell’Agenzia per l’ambiente, della Ripartizione Agricoltura e della Ripartizione Protezione civile e antincendi. Inoltre è stato approvato un Listino Prezzi per l’anno 2022 della Ripartizione Opere idrauliche e delle Ripartizioni Foreste, Agricoltura e dell’Agenzia per l’ambiente e sono state approvate 12 graduatorie per le misure forestali del PSR.
Autorizzazioni per movimenti di terra, interventi non sostanziali, pareri per la conferenza dei servizi ambientale e per la valutazione di impatto ambientale
Nel 2022 gli ispettorati forestali hanno fornito 348 pareri riguardanti la stabilità idrogeologico- forestale e l’ufficio caccia e pesca ha fornito 86 pareri riguardanti la regolamentazione sulle acque da pesca/pesca per la valutazione di progetti a livello della conferenza dei servizi - settore ambiente e per la valutazione di impatto ambientale. Inoltre gli ispettorati forestali hanno rilasciato 1667 autorizzazioni per movimenti di terra e 558 parerei per interventi non sostanziali.

Permessi speciali per la raccolta di funghi
Il direttore di ripartizione, su delega dell'assessore provinciale alle foreste,
2.2.12 Servizio di vigilanza e controllo 2022
Rientra nei compiti istituzionali del servizio forestale anche la sorveglianza ed il controllo sull’osservanza dell’or-
può rilasciare permessi di raccolta di funghi per scopi scientifici o didattici, validi per zone determinate o anche per tutto il territorio provinciale, esclusi i fondi espressamente interdetti dai rispettivi proprietari. Nel 2022 sono stati rilasciati 108 permessi di questo tipo.
Autorizzazioni al transito su strade chiuse al traffico
Il direttore di ripartizione, su delega dell'assessore provinciale alle foreste, può autorizzare il transito con veicoli a motore, per motivi di studio o di altra natura e che abbiano manifesto carattere di pubblico interesse, sulle strade chiuse al traffico.
Nel 2022 sono state rilasciate 337 autorizzazioni di questo tipo.
dinamento forestale e delle leggi provinciali sulla caccia rispettivamente pesca. Oltre a ciò, negli ultimi decenni è stato demandato all’autorità forestale anche il controllo di ulteriori leggi a tutela dell'ambiente e del paesaggio; gli accertamenti eseguiti da parte del personale del Corpo forestale provinciale vengono poi elaborati dai rispettivi uffici competenti nelle ripartizioni provinciali 28, 29 e 35. Il Corpo forestale provinciale esegue vigilanza e controllo nei seguenti settori:
• Diritti d’ uso civico (LP 16/1980)
• Tutela del paesaggio (LP 16/1970)
• Tutela della natura (flora, fauna, habitat, minerali; LP 6/2010)
• Traffico con mezzi aeromobili motorizzati (LP 15/1097)
• Gestione rifiuti e protezione del suolo (LP 4/2006)
• Protezione delle acque (LP 8/2002)
• Combustione di materiale biologico (LP 8/2000)
• Protezione dei corsi d’ acqua (LP 35/1975)
* 4 Servizi:
• Servizio Referendum provinciale - Maggio 2022 / 30 personale LFK (á 2 gg)
• Servizio Referendum Giustizia - Giugno 2022 / 30 personale LFK (á 2 gg)
• Servizio elezioni - Settembre 2022 / 30 personale LFK (á 2 gg)
• Servizio GG del Autonomia Merano – Settembre 2022 / 8 personale LFK (1 gg)
Statistica delle Notizie di Reato ad opera del CFP
Il Corpo forestale della Provincia Autonoma di Bolzano – Alto Adige (CFP), attraverso l’attività operativa svolta dalle proprie strutture distribuite in modo capillare su tutta la provincia,

persegue lo scopo di prevenire e reprimere, oltre le violazioni amministrative anche i reati commessi a danno del patrimonio forestale, faunistico, paesaggistico e ambientale del territorio provinciale.

COVID-19
C.P. artt. 650, 483, 495 e 651
Inosservanza dei provvedimenti dell’Autorità (in campo urbanistico)
C.P. art. 650
Delitti dei privati contro la Pubblica amministrazione violenza, minaccia, resistenza a P.U., rifiuto generalità, ecc.; C.P. artt. 336, 337 e 651
totale notizie di reato per tipologia
Controlli 2022 in riferimento a premi agroambientali e indennità compensative
Durante l’estate e in ottobre - novembre 2022 sono stati eseguiti il 5 % die controlli sui pagamenti agroambienta-
2.2.13 Informazione e relazione pubblica
Nell’anno passato 2022 sono state indette 73 sessioni forestali pubbliche ossia giornate d’ informazione forestali; quest’ ultime di regola si eseguono una volta all’ anno in ciascun comune. Nella sessione forestale vengono presentate le novità del settore, vengono concordati obiettivi e programmi annuali in collaborazione con altre amministrazioni e si rilasciano diverse autorizzazioni.


Nel 2022 sono state organizzate a livello provinciale le feste dell’albero con 9.450 bambini delle scuole elementari, 92 escursioni e seminari tematici, 5 presentazioni in fiera, 200
li e sulle indennità compensative 2022 dal corpo forestale provinciale in collaborazione con l’organismo pagatore. Questi controlli riguardano il rispetto degli impegni delle varie misure ed il rispetto della buona pratica (Cross
Compliance) ossia il controllo delle superfici, registrazione degli animali ed il premio aziendale. In totale sono state ispezionate 778 aziende agricole. 2.2.13
2.2.14 Attivitá di formazione
A novembre è iniziato un corso di formazione di cinque mesi per 25 guardie forestali presso la Scuola forestale del Latemar - Passo Carezza.

2.2.15 Vivai forestali
Nel 2022 dai vivai forestali provinciali sono state distribuite in totale 423.689 piantine a proprietari boschivi privati, enti pubblici e per i cantieri in amministrazione diretta del servizio forestale:

bisogno di piante con un adeguato anticipo: da 2 a 3 anni per le latifoglie e da 4 a 5 anni per le conifere, al fine di poter fornire le quantità necessarie di piante. La fornitura di piante per i lavori di rimboschimento ha sempre la priorità assoluta.

L'obiettivo è quello di creare popolamenti misti stabili e strutturat,i che offrono una maggiore resistenza agli eventi meteorologici straordinari ed estremi e sono in grado di affrontare meglio le mutate condizioni climatiche .
Rimboschimenti
Hanno priorità i lavori di rimboschimento nei boschi con funzione protettiva qualora la rinnovazione naturale non sia quella desiderata. Ciò è particolarmente importante per le aree sulle quali sono state realizzate opere protettive e dove l'effetto della funzione protettiva del bosco deve essere ripristinato il più presto possibile. Tuttavia per pianificare la produzione di piante nei vivai forestali, è estremamente importante conoscere il fab-
Come specie arboree stabilizzanti in media e bassa quota e condizioni stazionari idonei, sono da prendere in considerazione soprattutto l’ abete bianco ed alcune specie di latifoglie (acero montano, ciliegio selvatico). Invece nelle quote più alte si può contare sul pino cembro. Il larice è specie adatta ovunque. Negli ultimi decenni lo sviluppo del larice a causa di utilizzazioni ridotte è stato soppresso dall'abete rosso. Pertanto, sarebbe auspicabile che la presenza percentuale del larice aumenta nei popolamenti futuri. Il larice è una specie arborea sia eco-
logicamente che paesaggisticamente desiderata ed anche la betulle, ontani, sorbi, sambuco sono specie secondarie molto utili ed hanno il pregio di migliorare il terreno.
Periodo di rimboschimento
Per la messa a dimora delle piantine a radice nuda in primavera dopo lo scioglimento delle nevi, il periodo buono per garantire il successo di attecchimento (=terreni umidi e giornate non troppo calde) è breve e si estende solamente su 4-6 settimane. La messa a dimora in autunno non sembra sempre vantaggiosa e dipende molto dall’andamento climatico in inverno (danni causati da siccità e gelate). In estate, se il tempo (umidità del suolo) lo consente, possono essere messe a dimora solo le piantine invasate. Ciò è necessario soprattutto nelle fasce ad alta quota, dove lo scioglimento della neve avviene molto tardi. Per questo si produce in vaso l’abete rosso, pino cembro, varie
ed il larice.
Prezzi del legname
Nel 2022 le stazioni forestali hanno inserito nella statistica complessivamente 49 lotti di legname venduti da enti pubblici per complessivi 17.852 mc. Di questi 14 lotti sono stati venduti in piedi, 1 su letto di caduta ed i rimanenti 34 franco strada o piazzale. Sono stati ottenuti i seguenti prezzi medi di vendita: 2.2.16

* Per il 2021 il dato non è disponibile
** Prezzo 2022 più alto del prezzo 2021, perchè nel 2021 non si aveva il pino cembro fra il tondame
2.2.16 Studi e Progetti
Arboricoltura e silvicoltura: via libera a una cattedra convenzionata
Alla Libera Università di Bolzano sorgerà una cattedra convenzionata nel campo delle scienze e delle tecnologie della arboricoltura e della silvicoltura.
C’è l’approvazione della Giunta provinciale
Studiare l’ecosistema del bosco è un obiettivo condiviso dalla Libera Università di Bolzano e dalla Ripartizione Foreste. Con le loro ricerche le due istituzioni vogliono difendere e valorizzare il territorio boschivo quale fattore di equilibrio e di tute -

la ambientale, anche in relazione ai cambiamenti climatici. Nell’ambito del programma di ricerca comune,
il ruolo dei boschi dell’Alto Adige dev’essere studiato in funzione del contenimento dei mutamenti am -
bientali. Questo progetto di ricerca sarà messo in pratica attraverso una cattedra convenzionata. La Giunta provinciale ha approvato il 17 maggio 2022 l’istituzione di questa cattedra convenzionata nel campo delle scienze e delle tecnologie della arboricoltura e della silvicoltura per il periodo compreso tra il 2022 e il 2025. Per la creazione della cattedra la Provincia stanzierà 130.000 euro per ognuno degli anni accademici 2022/2023, 2023/2024 e 2024/2025. L’accordo per l’istituzione della cattedra convenzionata, che è stato approvato anche dal consiglio dell’Università, entra in vigore dopo le firme del presidente della Giunta provinciale, Arno Kompatscher, e della presidentessa della Libera Università di Bolzano, Ulrike Tappeiner.
Bosco e cambiamenti climatici: cattedra convenzionata all’Unibz
“Il valore ecologico del bosco quale importante elemento per il contenimento dei cambiamenti climatici è indiscutibile”, spiega il presidente della Giunta Arno Kompatscher. Il quale sottolinea come il ruolo delle foreste in relazione all’assorbimento dell’anidride carbonica ed ai servizi ecosistemici sia stato a lungo studiato a livello provinciale. “Adesso vogliamo approfondire e sviluppare ulteriormente queste ricerche grazie alla collaborazione con la facoltà di Scienze naturali e tecnica della Libera Università di Bolzano”, dice il presidente Kompatscher, che in Giunta provinciale ha anche la competenza dell’innovazione e della ricerca.

Un ruolo particolare in questa cooperazione alla ricerca è svolto dalla stazione di misurazione di Selva Verde, sull’altipiano di Renon, già gestita dalla Ripartizione Foreste della Provincia. Qui vengono osservati lo scambio energetico tra il bosco e l’atmosfera e quello di vapore acqueo e anidride carbonica tra ecosistema e l’atmosfera stessa. La stazione di monitoraggio situata ad alta quota fa parte di diverse reti europee ed è una delle tre più importanti accreditate dall’IOS (Integrated Carbon Observation System) in Italia ed un elemento chiave per lo studio del ciclo del carbonio a livello regionale.
Stazione di misura Selva Verde quale centro di osservazione del cambiamento climatico Nell’ambito del progetto di ricerca e della cattedra, i dati della stazione Selva Verde dovranno essere raccolti, analizzati, convalidati, memorizzati, elaborati e trasmessi. Parte del progetto è anche la pubblicazione dei risultati della ricerca “In questo senso il centro di osservazione del Renon deve svilupparsi quale un punto di attrazione per i ricercatori europei e fungere da centro di osservazione del cambiamento climatico” informa il presidente della Giunta provinciale Kompatscher, sottolineando come la stazione del Renon giocherà un ruolo importante anche per il raggiungimento dei traguardi climatici.
La Giunta provinciale ha dato oggi luce verde anche ad un secondo progetto di cooperazione con l’Università di Bolzano: la Provincia co-finanzierà la cattedra convenzionata triennale istituita dalla rete Automotiv Südtirol (AES) nel settore dei sistemi e delle tecnologie di produzione, per portare avanti il progetto “Sustainable Manufactoring”.
Neofite
Le specie vegetali non autoctone, introdotte dall’uomo in un dato territorio dopo la scoperta dell’America, vengono definite “neofite”.
Di tutte le neofite, solamente una parte riesce a sopravvivere nei nuovi ambienti e a riprodursi. Un numero
ancora più esiguo di specie infine, si trova talmente bene nei nuovi habitat, da diffondersi rapidamente e diventare invasiva. Le specie invasive dimostrano una grandissima capacità concorrenziale nei confronti delle specie autoctone, arrivando a soppiantarle in molti ambienti. Oltre a produrre un impoverimento nella biodiversità tipica di un luogo, alcune specie invasive possono avere effetti negativi sulla salute di uomini ed animali. Tra le specie maggiormente problematiche attualmente diffuse in provincia, si annoverano il panace di Mantegazza, il senecione sudafricano, il poligono del Giappone, la balsamina dell’Himalaya, la verga d’oro del Canada, oltre alla robinia e all’ailanto.
La Ripartizione Foreste ha avviato nel 2012 due progetti per il contenimento del panace di Mantegazza e del senecione sudafricano. Mentre la prima specie può provocare pericolose ustioni cutanee, la seconda risulta altamente tossica per gli animali al pascolo e per le api. Anche altri neofiti invasivi vengono combattuti dal servizio forestale su alcune aree protette.
Tutti i focolai noti di panace vengono costantemente monitorati ed annualmente trattati. Questi provvedimenti hanno permesso di limitare fortemente l’ulteriore espansione della specie a livello provinciale. Anche nel 2022, in un’area di saggio della Val d’Ega sono state testate diverse tipologie di interventi meccanici (sradicazione,
ritaglio, escavazione, rimozione delle infiorescenze, ecc.). I risultati di tali interventi verranno elaborati e valutati nella primavera del 2023.
Il senecione sudafricano è stato controllato con successo da diversi interventi di sradicazione manuale nelle due zone di maggiore diffusione: Castelfeder e val Venosta. Anche nel 2022 sono stati organizzati diversi interventi di sradicazione a livello provinciale, soprattutto all'interno della Ripartizione Foreste.
La presenza del poligono del Giappone è stata sempre più osservata nel 2022. Nel territorio di Vipiteno, Bressanone e Merano sono state sperimentate misure di contenimento di piccole aree con poligongo del Giappone definibili localmente
Per quanto concerne l’ailanto sono state eseguite prove di contenimento della specie in diverse aree test nei boschi cedui della Bassa Atesina. Queste prove hanno portato alla pubblicazione di una prima tesi di laurea nel 2019 (Masterarbeit_Tratter_Lukas(2). pdf (provincia.bz.it). Una seconda tesi, prosecuzione della prima è stata completata nel 2021 (Masterarbeit_ Goetterbaum_Frenes(1).pdf (provincia.bz.it)). Qui possono essere letti i risultati delle tesi.
Rilevamento degli ostacoli al volo

Secondo la Legge Provinciale 1/06 gli ostacoli alla navigazione aerea esistenti, quelli di nuova costruzione, nonché quelli smantellati devono essere comunicati dai gestori alla Ripartizione provinciale Foreste.

Tali comunicazioni serviranno per creare una carta digitale aggiornata quotidianamente di tutti gli ostacoli presenti in Alto Adige.
La carta fornirà ai piloti dei velivoli tutte le informazioni necessarie per evitare tali ostacoli e con ciò contribuire sensibilmente ad aumentare la sicurezza aerea.
Nel 2022 sono stati comunicati attraverso le stazioni forestali e l’Ufficio Pianificazione forestale 1.244 nuove linee e 1.233 smantellamenti.
Questo grande numero di nuove comunicazioni e smantellamenti è da ricondurre all’esbosco delle aree dan-
neggiate da Vaia nell’autunno 2018, degli schianti da neve nell’autunno/ inverno 2019 e 2020 e del legname successivamente danneggiato dal bo-
strico negli anni 2021 e 2022. Quindi si tratta prevalentemente di comunicazioni di teleferiche temporanee per il trasporto di legname.

Comunicazione di ostacoli al volo tramite le stazioni forestali e l’Ufficio Pianificazione forestale

2.2.16
Attualmente (situazione al 31.01.2023) la carta digitale degli ostacoli al volo contiene 4.027 ostacoli lineari e 991 ostacoli verticali.
In generale nel corso degli anni proseguono a diminuire gli impianti fissi utilizzati nell’agricoltura (piccole teleferiche, fili a sbalzo). In generale sono
in declino gli impianti fissi utilizzati nell’agricoltura (piccole teleferiche, fili a sbalzo).
Gli ostacoli al volo finora rilevati ed aggiornati quotidianamente dall’Ufficio Pianificazione forestale, sono pubblicati sul Geobrowser Maps della Provincia e possono essere visualizzati in qualsiasi momento.
Attualmente 70 persone ossia gruppi di persone hanno richiesto il servizio download degli ostacoli al volo.
Ulteriori informazioni relative a questo progetto e l’accesso al Geobrowser Maps si possono trovare al seguente indirizzo: http://www.provincia.bz.it/foreste/studi-progetti/rilevamento-ostacoli.asp
*Dal 2020 in poi gli ostacoli al volo rilevati come “teleferiche per il trasporto esclusive di cose” sono stati suddivisi tra teleferiche piccole (carico < 1.000 kg) e teleferiche grandi (carico > 1.000 kg).
Progetto Strade
L’interesse per dati affidabili, riguardanti le strade forestali e poderali, è elevato. La conoscenza esatta della viabilità svolge un ruolo importante per i diversi enti pubblici, per la centrale provinciale d’emergenza, i comuni, i corpi dei vigili del fuoco volontari e permanenti e per diverse aziende private. Le strade poderali e forestali rappresentano la vera struttura portante del catasto stradale in forma digitale. Il servizio forestale aggiorna e gestisce attualmente 16.108 km di strade (strade forestali e poderali). Il numero dei singoli tratti ammonta a 25.132. La classificazione delle strade chiuse al traffico ai sensi della L.P.n.10/90 è proseguita per dare in quest’ambito una migliore visione d’insieme e in modo che fosse possibile uniformare la cartografia.
La verifica lineare e la correzione dei parametri descritti è stata attualizzata per tutte le strade poderali della provincia. Attualmente ammontano 3.937 km di strade poderali corrispondenti a 7.799 singoli tratti, di cui 3.692 km camionabili e 281 km trattorabili. Inoltre, sono stati gestiti digitalmente dal 2018, 20.448 km percorsi escursionistici, divisi tra 4.186 km nelle aree
protette e 16.262 km fuori di essi. Ciò include la raccolta dei dati, emissione dei dati e il miglioramento continuo dei dati, sia graficamente che correzioni nella banca dati.
Monitoraggio degli spostamenti superficiali del versante di frana di Corvara in Badia e Trafoi
Frana di Corvara
Da più di 20 anni l’Ufficio Pianificazione Forestale effettua misurazioni GPS per monitorare la frana di Corvara. Dei 52 punti di misurazione che furono materializzati all’inizio del progetto, oggi ne sono rimasti 33, 11 dei quali sono stati temporaneamente dati in uso all’Eurac per il progetto “Lawina”.
I 22 punti restanti vengono misurati dall’Ufficio Pianificazione Forestale una volta all’anno. I dati vengono trasmessi all’Ufficio Geologia e prove materiali.
Frana di Trafoi
La prima misurazione RTK è stata eseguita durante la seconda metà del mese d’ottobre 2007, mentre 3 misurazioni sono state eseguite durante il 2008 e per gli anni seguenti sono state effettuate 2 misure per anno. Dal 2012 è stato cambiato il metodo di misurazione introducendo il metodo “stati-
co- rapido”. Con tale metodo è possibile prendere contemporaneamente, per ogni punto, misure riferite alle due stazioni di riferimento.
Nell’anno 2022 sono state effettuate 2 misurazioni nei mesi di giugno e ottobre. In 4 dei 11 punti si notano dei movimenti che sono in linea con l’andamento degli anni precedenti. I punti restanti invece non si muovono.
In totale l’Ufficio Pianificazione Forestale per l’osservazione di due frane ha effettuato nel 2022 su 15 punti una misurazione GPS.
Ulteriori informazioni si trovano in Internet sotto il seguente indirizzo:
https://www.provincia.bz.it/agricoltura-foreste/bosco-legno-malghe/studi-progetti/ gps-monitoring.asp

“Proteggiamo e utilizziamo le risorse naturali che ci vengono affidate. In maniera sostenibile e responsabile”. Questa è la mission dell’Agenzia Demanio provinciale, formatasi nel gennaio 2017 a seguito della riorganizzazione del Centro di Sperimentazione Laimburg e dell’Azienda provinciale Foreste e Demanio. Essa continua a impegnarsi per la sostenibilità, in una logica di economia circolare e di preservazione delle risorse naturali in materia di agricoltura, selvicoltura e giardinaggio. Il novello ente è meglio definito come ente strumentale della Provincia autonoma di Bolzano, però dotato di caratteristiche da impresa di tipo privato. Tramite l’Azienda agricola Laimburg e l’Azienda forestale, esso provvede alla gestione dei terreni demaniali, siano essi agricoli, forestali e alpini, e delle relative infrastrutture. Inoltre, si occupa dei venti poderi di proprietà demaniale, di quattro stazioni di vigilanza forestale, dei Giardini di Castel Trauttmansdorff a Merano, della Scuola forestale Latemar e della Segheria demaniale Latemar a Nova Levante, nonché del rinnovato Centro Tutela Specie Acquatiche a Scena.
Oltre a ciò, l’Agenzia segue lo sviluppo di più di 1.500 progetti facenti capo alla ripartizione Natura, Paesaggio e Sviluppo del territorio, al dipartimento Foreste e all’Agenzia per l’ambiente; inoltre, si occupa della realizzazione di importanti lavori per l’Alto Adige: cura delle foreste, rimboschimenti, stabilità delle pendici, difesa dalle valanghe, protezione dei biotopi, sentieri per escursionisti, interventi d’urgenza in caso di danni causati da fenomeni climatici e molto altro.
2.3 Agenzia Demanio provinciale
L’Agenzia Demanio provinciale è costituita da 5 settori, con funzioni sia organizzative che di servizi: l’Azienda agricola Laimburg, l’Azienda forestale, i Giardini di Castel Trauttmansdorff, l’Amministrazione e l’Amministrazione immobili. L’attività principale dell’Agenzia consiste nella gestione e nella tutela sia delle zone di alta montagna che delle superfici agricole e forestali, facenti parte del patrimonio indisponibile della Provincia, nonché dei beni immobili ad essi pertinenti. Oltre ai suddetti settori, fanno parte dell’Agenzia anche la Scuola forestale Latemar, la Segheria demaniale Latemar e il Centro Tutela Specie Aquatiche. È compito dell’Agenzia conservare e impiegare al meglio le proprietà
demaniali della Provincia. Con oltre 140 ettari di frutticoltura, 50 ettari di viticoltura, 15 ettari di prati, 5 ettari di
orticoltura e ca. 5.070 ettari di bosco, l’Agenzia è l’azienda agricola e forestale più grande della Provincia.

2.3.1 Azienda agricola Laimburg
All’Azienda agricola Laimburg appartengono 20 poderi situati in varie zone dell’Alto Adige: dalla Val Venosta passando per il Burgraviato, l’Oltradige, la Bassa Atesina fino alla Val Pusteria. Tutte le diverse tipologie di coltivazione locale trovano così una loro applicazione: agricoltura alpina, frutticoltura, viticoltura, orticoltura, cereali, coltivazione di piccoli frutti e piante officinali e aromatiche, apicoltura. Inoltre, nei 4 masi di Freiberg-Monte-

franco sopra Merano, vengono coltivate le castagne mentre al maso Ölleiten di Caldaro e ai Giardini di Castel Trauttmansdorff crescono gli olivi. La produzione di frutta viene venduta a diversi consorzi frutticoli, ma l’uva vendemmiata viene destinata all’azienda vinicola Cantina Laimburg e ad altre cantine.
È difficile fare un paragone tra l’Azienda agricola Laimburg e le altre aziende agrarie della provincia, poiché gran parte delle superfici agricole sono affidate al Centro di Sperimentazione Laimburg e destinate ai fini della ricerca scientifica; inoltre, l’azienda agricola è parte di un ente pubblico e deve quindi rispettare delle direttive diverse da quelle di un’azienda di tipo privato.

Obiettivo: un sistema di irrigazione di precisione per tutti i poderi
L’Agenzia Demanio provinciale, oltre alla produzione ecologica ed economicamente efficace di alimenti sicuri, sani e di alta qualità, ha un ulteriore obiettivo nell’utilizzo parsimonioso delle risorse. I sistemi di irrigazione dell’Azienda agricola Laimburg vengono costantemente convertiti a sistemi di irrigazione a goccia e quindi, gradualmente, si passerà a un sistema d’irrigazione erogata al bisogno, tramite monitoraggio con sensori.
Nel 2022 il Moarhof di Labers è stata la prima azienda a usufruire del sistema di irrigazione automatica di precisione. Di conseguenza, in un’annata molto secca come l’attuale, si è potuto risparmiare una gran quantità di acqua, se paragonata al precedente anno 2021, senza causare impatti negativi in termini di resa e di qualità. Grazie a tali risultati molto positivi, anche tutte le altre aree frutticole e viticole dell’Azienda agricola Laimburg, nel 2023, saranno dotate di sensori di rilevamento dell’umidità del suolo, oltre che di sistemi di irrigazione a goccia.
Stagione agricola 2022
Nel 2022, il raccolto di mele presso l’Azienda agricola Laimburg è stato quantitativamente inferiore alla media e parzialmente carente, in termini di qualità. Soprattutto la varietà Gala ha avuto problemi con il caldo record dell’estate 2022.
Al contrario, in viticoltura, l’annata è stata eccezionalmente buona, con
quantitativi a volte molto elevati e una qualità per lo più eccellente.
Parassiti e malattie
La stagione agricola 2022 è stata ancora una volta abbastanza facile da gestire, in termini di rischi da infestazioni parassitarie e di insorgenza di malattie. Si sono verificati problemi con l’afide lanigero, la cimice e altri parassiti, ma solo in determinate zone e singoli episodi. Tuttavia, si può osservare che il problema dell’afide lanigero sta au-
mentando, in conseguenza alla riduzione dell’utilizzo di sostanze pesticida, e ciò rappresenterà sicuramente una delle maggiori sfide in agricoltura, in futuro.
La flavescenza dorata ha continuato a diffondersi in Alto Adige; inoltre, rispetto agli anni precedenti al 2022, piuttosto tranquilli, va ora osservata con attenzione l’infestazione superiore alla media di avvizzimento dei grappoli, soprattutto nella varietà Sauvignon.

Nuovi impianti I nuovi impianti, programmati per il 2022, hanno potuto essere realizzati, ma non nei tempi previsti, in quanto i fondi necessari a tal fine sono stati resi disponibili in ritardo.
Dei 10 ettari di nuovi impianti nei frutteti, la maggior parte sono stati destinati a colture di nuove varietà moderne, come WA38-Cosmic Crisp® o Nicoter-Kanzi®; altrimenti, a sistemi multiasse, che dovrebbero generare entrate redditizie in futuro.
2.3.2 I Giardini di Castel Trauttmansdorff
La famosa meta escursionistica dell’Alto Adige, che si estende su una superficie di 12 ettari, da più di vent’anni mette in mostra oltre 80 diversi paesaggi botanici ispirati a tutto il mondo. Nell’area dei Giardini si trovano, oltre a diverse coltivazioni a tema e collezioni di piante, anche numerosi padiglioni artistici e stazioni sensoriali da sperimentare. Premiato come uno dei giardini più belli a livello internazionale, i Giardini di Castel Trauttmansdorff a Merano oggi puntano soprattutto al loro ruolo di struttura modello, in senso ecologico.
I Giardini registrano nuovi successi.
Nel 2022, i Giardini hanno riaperto le loro porte il 1º aprile e, fino al 15 novembre, hanno registrato 387.035 visitatori e visitatrici; ciò ha consentito loro di tornare ai livelli di pubblico delle annate pre-pandemia. Il mese più importante della stagione ai Giardini è stato agosto, con 63.410 ospiti, seguito da aprile, con 55.500 persone; tra essi, la partecipazione di nuclei famigliari è aumentata in modo significativo.
Le 1.366 visite guidate si sono pure svolte nella consueta forma, grazie al team didattico dei Giardini. Di queste, il 24% era costituito da attività didattiche, ossia visite guidate per le scuole; il 37% da visite di gruppi e il 39% circa
era dedicato a visite guidate individuali a data prestabilita.
Tema annuale ed eventi
Il 2022 ai Giardini è stato all’insegna del tema “Regalati del tempo — Il giardino come luogo di benessere”. Un percorso dedicato conduceva attraverso luoghi speciali e angoli nascosti, dove gli ospiti dei Giardini potevano sostare o dedicarsi ad attività. A maggio si è svolta l’annuale Giornata per le famiglie “Primavera ai Giardini”. In estate, il programma concertistico internazionale del World Music Festival ha attirato 4.927 appassionati di musica nei Giardini. Oltre ai concerti e alle lunghe serate del venerdì, sono state proposte anche tre serate per i pic-nic al Laghetto delle ninfee. In autunno, ha avuto luogo la Giornata dei cori, la Giornata delle Porte aperte per le persone con disabilità e la Giornata per le famiglie “Autunno ai Giardini”. Per la prima volta, ai Giardini sono anche stati proposti dei laboratori di decorazione, grazie al personale di Trauttmansdorff.

Pianificazione, tecnologia e cura dei Giardini
Anche nel 2022 i Giardini hanno saputo deliziare i propri ospiti con l’attraente offerta botanica, sia primaverile che estiva, coltivata presso la Giardineria Laimburg. Oltre alle fioriture stagio-
nali, in primavera è anche stata ripristinata la prima sezione delle pareti in argilla, con la messa a dimora di circa 27.000 perenni.

Grazie ai contatti con un gruppo di collezionisti, è stata raccolta e trapiantata una collezione completa di Trachycarpus. L’obiettivo dei Giardini è quello di piantare in loco ulteriori varietà di palme, resistenti al freddo, per testarne lo sviluppo e completare l’assortimento delle Yucca e di altre piante originarie di zone aride.

I Giardini di Castel Trauttmansdorff sono cresciuti fino a diventare, ad oggi, un centro di riferimento in tema di rafforzamento delle piante. Nel 2022 sono stati testati nuovi prodotti e migliorate le miscele esistenti; al fine di ottimizzare la struttura del suolo, si lavora già da diversi anni con la micorriza e, per la prima volta nel 2022, sono stati rilasciati nel terreno altri lombrichi. Oltre a queste pratiche, si ricorre all’utilizzo di compost di produzione propria, arricchito con microrganismi vivi e biochar: nel 2022 ammontava a 450m³. Nell’autunno 2021 ai Giardini è
stato assegnato lo “European Award for Ecological Gardening” per l’eccezionale impegno nel giardinaggio ecologico. A luglio 2022, ha fatto seguito l’assegnazione della targa “Giardino naturale – giardino espositivo” da parte della rete austriaca “Natur im

Garten”: i giardini, che vengono inclusi nella rete partner di giardini espositivi “Natur im Garten” soddisfano una serie di criteri di qualità nel settore del giardinaggio ecologico.

2.3.3 Azienda forestale
L’Azienda forestale dell’Agenzia Demanio provinciale amministra oltre 75.000ha di territori in area alpina, di cui 5.070ha sono costituiti da boschi, proprietà della Provincia. La supervisione e la gestione delle superfici forestali sono affidate a quattro stazioni forestali.


I lavori sono condizionati dagli enormi quantitativi di legname danneggiato Presso l’Azienda forestale i lavori di selvicoltura si sono concentrati su quelli resi necessari dagli effetti della tempesta di vento VAIA nel 2018 e per le precipitazioni nevose nel 2019 e 2020. Il tasso annuo sostenibile di prelievi dalle foreste demaniali, di circa 11,000m³, si è concretizzato invece in
una produzione pari a totali 25,000m³ di legname. Dopo lo smaltimento del legno a terra, nel 2022 il bostrico ha provocato un’infestazione del fustame corrispondente al doppio degli esemplari destinati annualmente al prelievo in tutte le foreste demaniali. Circa l’80% del legno infestato è stato asportato, diminuendo in tal modo i rischi di un’ulteriore infestazione. A causa di questi considerevoli lavori di smaltimento, non si aveva più manodopera sufficiente per gli ordinari lavori di cura e diradamento. Inoltre, gli interventi di rimboschimento sono attualmente esposti a rischio di infestazione, in quanto durante un massiccio intervento di posa, ogni terreno dissodato favorisce l’infestazione da bostrico.
La stazione di vigilanza forestale Aica ha organizzato la tradizionale consegna dell’albero di Natale per il capoluogo Bolzano. In questa occasione, l’albero per piazza Walther è arrivato da Castelrotto.
Grave infestazione da bostrico nella foresta del Latemar
Nel 2022 si è verificata una massiccia infestazione di bostrico nel bosco di Carezza. Gran parte del legno danneggiato, che ammontava a circa 18.000 metri cubi, più di quattro volte il tasso annuo, è stato asportato dalla foresta. Poiché un quantitativo così imponente non poteva essere lavorato tutto presso la Segheria demaniale Latemar, parte del legname da sega
è stato venduto all’asta. La raccolta del legno ha potuto essere realizzata grazie al lavoro dei nostri forestali e dei nostri macchinari, ma anche con il supporto di ditte esterne.
Monitoraggio della fauna selvatica e altri compiti
Tra gli innumerevoli compiti degli agenti forestali dell’Agenzia Demanio provinciale si può menzionare il monitoraggio di marmotte, ungulati e galliformi, nonché di grossi predatori. Nella foresta del Latemar, molto probabilmente anche a causa della ricchezza di prede, un branco di lupi della vicina Val di Fassa ha fatto sosta con frequenza regolare. Tuttavia, lì e in altre foreste demaniali, soprattutto in seguito alla recente distruzione delle aree boschive, è stato necessario il prelievo di fauna selvatica per mantenere una corretta rigenerazione delle foreste.

D’altra parte, la popolazione di camosci presente nelle aree boschive, al momento, viene per la maggior parte preservata, in quanto la loro presenza attualmente è condizionata dalla rogna.
Le zone di alta montagna, all’infuori delle foreste demaniali, sono assegnate a loro volta in concessione, in qualità di riserve di caccia; in tal caso, i forestali devono limitarsi ad attività di supervisione e controllo delle concessioni.

La stazione di vigilanza forestale di Funes ha collaborato intensamente con la Scuola forestale Latemar per l’organizzazione e l’allestimento dei corsi di
lavoro forestale. Per i corsi di caccia è particolarmente utile il recinto per selvaggina Zannes.
Collaborazione scientifica Utilizzando metodi di indagine e di valutazione moderni e molto complessi, l’Ufficio di Pianificazione forestale, in collaborazione con la Libera Università di Bolzano, ha elaborato il piano di gestione forestale Funes: con l’ausilio del laser scanner sono stati compiuti, via elicottero, dettagliati rilevamenti delle aree boschive, che ora sono a disposizione per la raccolta di dati sul legname. In tal modo, questo piano di gestione, similmente a quello ef-

fettuato sulla foresta del Latemar, rappresenta il secondo caso in cui il quantitativo di legname è stato calcolato utilizzando il metodo LiDAR. I dati sono stati convalidati sulla base di 60 punti di campionamento terrestri. Il lavoro di ricerca della Libera Università di Bolzano continua a concentrarsi soprattutto sulla distinzione, la più precisa possibile, delle diverse specie arboree, in condizioni di interpretazione automatizzata dei dati.
Nella primavera del 2022 è stato realizzato un progetto di ricerca dedicato al bostrico, condotto nella foresta demaniale presso Valgenauna, nel comune di Campo di Trens, in colla-
borazione con la ripartizione Foreste e la Libera Università di Bolzano. In quell’occasione la ricerca scientifica si è concentrata sui diversi livelli di intensità dell’infestazione, a seconda delle varie tipologie di legno, provenienti da differenti specie arboree.

Ambito di attività nelle aree demaniali di alta
montagna
In passato, lo sviluppo e le attività sulla proprietà fondiaria non sono sempre stati realizzati con la dovuta attenzione, in materia di natura e ambiente. Oggi, però, nessuno si sente più responsabile per le vecchie mancanze e l’Amministrazione provinciale si ritrova a gestire rifiuti abbandonati nell’ambiente da estranei. A fine esta-
te 2022, il personale della stazione di vigilanza forestale di Aicha, in collaborazione con il personale della stazione forestale di Cadipietra, in valle Aurina, e i volontari dell’Associazione Alpina Ahrntal si sono adoperati nella raccolta di rifiuti presso la Vedretta di Rio Torbo (ghiacciaio) in valle Aurina. A seguito del ritiro dei ghiacciai, erano riemerse notevoli quantità di rifiuti. Questi sono stati quindi raccolti in dieci grandi sacchi e asportati con l’intervento di un elicottero.
Vivaio forestale Aica
Il vivaio forestale Aica si adopera per incrementare la produzione di flora selvatica autoctona, in particolare latifoglie e arbusti, così da andare incontro
a un pubblico più ampio. Il vivaio forestale vuole così promuovere il patrimonio culturale del “paesaggio a siepe”, contribuendo alla sua conservazione e a quella dell’ambiente naturale in Alto Adige. Nel 2022 il personale del vivaio forestale ha raccolto sementi rinforzate per la produzione di arbusti rustici autoctoni nei prossimi anni.
Circa 35.000 larici sono stati coltivati nei cosiddetti container: essi saranno destinati sia al rimboschimento delle foreste altoatesine sia alla vendita a privati ed enti pubblici.
Per il resto, sono stati prodotti 1.000 arbusti selvatici e 300 latifoglie. Oltre a ciò, il vivaio forestale produce varie piante, tra cui salici da vimini e hotel per insetti.

2.3.4 Centro Tutela Specie Acquatiche
La missione principale del Centro Tutela Specie Acquatiche consiste nella salvaguardia della fauna ittica autoctona.
Preservazione della molteplicità e delle caratteristiche genetiche delle specie ittiche
Il compito principale del Centro Tutela Specie Acquatiche è preservare la fauna ittica dei fiumi altoatesini, anche tramite ripopolamento. Il lavoro del Centro si focalizza in particolare sulla trota marmorata, la regina dei principali corsi d’acqua altoatesini. Rispetto alla genetica, ci si occupa innanzitutto della preservazione delle caratteristiche genetiche naturali delle specie. Il
concetto di base consiste nel sostenere la popolazione esistente grazie a un’opera di incremento e allevamento di giovani esemplari selvatici. A questo scopo, ogni anno vengono catturati esemplari di trote marmorate cresciute allo stato naturale, da cui ottenere uova per la riproduzione. Nel 2022 sono state fecondate complessivamente 18.000 uova, di cui la maggior parte ha potuto già essere reintrodotta nelle acque d’origine. Una piccola parte di questa discendenza viene allevata in condizioni simil-naturali, così che negli anni a venire si possa contare su un numero sempre maggiore di uova per la riproduzione. Per evita-
re effetti di addomesticamento, si è provveduto ad adeguare progressivamente sia il mangime utilizzato che le strutture proprie del Centro, affinché corrispondano sempre più a un habitat naturale. Per l’allevamento degli esemplari da riproduzione di trota marmorata è stato costruito un canale, cui nel 2022 è stato aggiunto un bacino, affinché anche gli esemplari più grandi godessero di sufficiente spazio. Nel 2022 circa 100.000 uova sono state deposte nell’impianto per l’incubazione, ricavandone circa 45.000 giovani avannotti. Il resto delle uova di trota marmorata è stato distribuito direttamente in acque naturali, grazie anche alla collaborazione con l’ufficio Caccia e pesca.
Temoli, gamberi di fiume e pesciolini
Un secondo importante progetto del Centro Tutela Specie Acquatiche è la conservazione della popolazione autoctona di temolo adriatico. A questo scopo, negli anni passati si è provveduto a rilasciare diverse centinaia di esemplari, geneticamente tracciati, nel Lago di Valdurna. Adesso, per dirla semplicemente, starà ai pesci stessi riuscire a crescere adeguatamente e provvedere a costituire una progenie, facendo così di questo progetto di preservazione genetica un vero successo. Per questo motivo, si sta attendendo con trepidazione la primavera del 2023, quando i primi esemplari di temolo, rilasciati nel lago di Valdurna, dovrebbero essere ormai maturi per la riproduzione.
Si sono fatti progressi anche negli sforzi riguardanti la sanguinerola (Phoxinus phoxinus), nella varietà autoctona dell’Alto Adige. Grazie a esami genetici si è riusciti a identificare gli esemplari autoctoni e a farli riprodurre in un bacino. Nell’ estate 2022 si è potuto rilasciare i primi esemplari nel lago Haider, così da avviare il futuro processo di ripopolamento di tutta la regione.
Altrettanto buona appare la situazione dei gamberi di fiume, che si sono più o meno adattati allo stagno naturale. Grazie a un buon tasso di riproduzione, si è potuto prelevare alcune centinaia di larve e trasferirle in una vasca d’allevamento. Queste larve sono ora diventate giovani gamberi, grandi a sufficienza per essere impiegati in nuovi insediamenti.



2.3.5 Scuola forestale Latemar
La Scuola forestale Latemar è un centro di formazione forestale, venatoria e ambientale. In attività dal 1973, oggi essa fa parte dell’Agenzia Demanio provinciale. Dal 2006 la sua sede si trova a Carezza, nel comune di Nova Levante.
Una prudente riapertura
Il 2022 è stato solo in parte meno gravato dalle conseguenze della pandemia di Covid, ma grazie agli allentamenti nelle misure restrittive, a poco a poco si è potuto tornare ai livelli normali di attività. La struttura è tornata ad essere impiegata appieno e le attività organizzate, come corsi e seminari, si sono finalmente svolte senza regole di distanziamento e riduzioni del numero dei partecipanti.
Cacciatrici e cacciatori ben formati
Nell’ambito venatorio vengono organizzati corsi in lingua tedesca e italiana a tutti gli interessati, siano essi provenienti dall’Alto Adige, come dal resto d’Italia. L’obiettivo principale di questi corsi è ampliare le competenze e le conoscenze di cacciatori e cacciatrici. I corsi venatori in lingua tedesca, ad es. il corso per neo-cacciatori e il corso per accompagnatori al camoscio, sono stati particolarmente richiesti e frequentati in buon numero. Ma sono stati proposti anche nuovi corsi. Apprezzati in modo particolare sono stati i corsi per il completo utilizzo e lavorazione della selvaggina. I corsi venatori in lingua italiana sono stati frequentati da
cacciatori e cacciatrici provenienti da tutto il territorio nazionale, che hanno dimostrato completa soddisfazione.
Corsi di lavoro boschivo in via di
recupero
La formazione continua professionale per persone impegnate nel lavoro boschivo, sia come attività principale che secondaria, rappresenta un settore di grande importanza per il territorio altoatesino. Obiettivo primario è impedire il verificarsi di incidenti, con conseguenze spesso gravi.
Purtroppo, malgrado la pur crescente richiesta, nel 2022 non si sono potute soddisfare tutte le domande di formazione a causa di impedimenti di gestione, come ad esempio nel caso dei lavori boschivi per le scuole agrarie della provincia, che non hanno avuto luogo. Ad ottobre 2022 si è tenuto un concorso per selezionare quei partecipanti che, a inizio 2023, avrebbero potuto frequentare un corso per diventare istruttori. I prescelti devono assolvere una formazione di tre settimane e vari tirocini nel corso della primavera 2023, così da essere pronti, presumibilmente nella seconda metà dell’anno, per iniziare la loro carriera da istruttori.
Utilizzazioni boschive ed esbosco del
legname
Nel 2022 sono stati realizzati diversi corsi relativi al taglio e all’esbosco del legname con trattore e verricello o con gru a cavo; un altro corso ha riguardato lo svolgimento di lavori di taglio sugli alberi
cifre riguardanti gli anni precedenti sono tra parentesi.)* dopo la fine della pandemia e con la formazione ad agenti forestali
Formazione di agenti ed assistenti forestali

Nell’ottobre 2022 è iniziato un corso di formazione della durata di sei mesi per 25 giovani agenti forestali, che sarà completato nell’aprile 2023. Poiché altri corsi sono stati organizzati dalla scuola forestale contemporaneamente allo svolgimento della formazione ad agenti forestali, una parte dei partecipanti è stata ospitata esternamente alla scuola forestale.
Danni da infestazione da bostrico
Nell’autunno 2022 è stata organizzata una giornata informativa dedicata al bostrico, in collaborazione con la ripartizione Foreste. Le persone interessate hanno potuto essere informate sulle cause del problema attuale, sulle caratteristiche biologiche dell’insetto e sui provvedimenti in essere e finanziamenti disponibili.
Progetti innovativi
In collaborazione con l’Istituto Zooprofilattico Sperimentale delle Venezie, la Scuola forestale Latemar ha sviluppato un’applicazione web gra-
tuita per monitorare la diffusione della cisticercosi e del suo patogeno Taenia pisiformis sulle lepri, ospiti intermedi del parassita. Tramite l’applicazione, i cacciatori possono aiutare a tener traccia della diffusione della malattia

nella regione. Una tale forma di monitoraggio potrebbe essere utilizzata in futuro per monitorare la presenza e la diffusione di altri agenti patogeni in Alto Adige e oltre.

Regionalità e diversità: sono i due pilastri dell’agricoltura e della silvicoltura in Alto Adige, che saranno sostenuti e consolidati anche con il nuovo Programma di Sviluppo Rurale.
2.4 Programma di sviluppo rurale
2.4.1
Programma di Sviluppo Rurale 2014-2020 della Provincia Autonoma di Bolzano – Regolamento (UE) n. 1305/2013 del 17 dicembre 2013
Misure previste 2014 – 2020
Approvazione del PSR da parte della CE
Il Programma di Sviluppo Rurale 2014-2020 della Provincia Autonoma di Bolzano n.2014IT06RDRP002 è stato approvato dalla Commissione dell’Unione Europea con decisione n. C(2015) 3528 del 26.05.2015 modifica-
to con decisione n. C(2022) 5586 del 27.07.2022, e dalla Giunta provinciale con delibera n. 727 del 16.06.2015, ultimamente modificata con delibera n. 13263 del 03.08.2022.
2.4.1
La visura attuale dell’opuscolo del Programma di Sviluppo Rurale 2014 –2020 è pubblicata sulla pagina web della Ripartizione Agricoltura (http://www.provincia.bz.it/agricoltura/service/pubblicazioni.asp).
Approvazione del PSR da parte della Giunta Provinciale:
La Giunta Provinciale ha approvato il PSR con Deliberazione del 16 giugno 2015, n. 727, modificata con delibera n. 13263 del 03.08.2022.
Pubblicazione delle deliberazioni di Giunta sul Bollettino della Regione
Trentino/Alto Adige:
La Deliberazione del 16 giugno 2015, n. 727 è stata pubblicata nel Bollettino Ufficiale n. 25/I-II del 23/06/2015.
La Deliberazione n. 1280 del 21.11.2017
è stata pubblicata nel Bollettino Ufficiale n. 48/I-II del 28/11/2017.
La Deliberazione n. 1122 del 17.12.2019
è stata pubblicata nel Bollettino Ufficiale n. 52/Sez. gen. del 27/12/2019
La Deliberazione n. 382 del 09.06.2020
è stata pubblicata nel Bollettino Ufficiale n. 25/Sez. gen. del 18/06/2020
Riunione del Comitato di Sorveglianza:
L’8 giugno 2022 si è tenuta a Bolzano l’ottava riunione annuale del Comitato di Sorveglianza. Punti presi in esami durante il Comitato di Sorveglianza:
• Presentazione della Relazione Annuale di Attuazione anno 2021
• Presentazione delle modifiche proposte per il PSR 2014-2022:
- Aumento del premio base 10.1.1
- Introduzione costi semplificati per la misura 16.1 PEI con intervento del Valutatore Indipendente
• Avanzamento del PSR 2014-2020:
- Al 30 aprile 2022
- Verifica del disimpegno automatico n+3
• Presentazione al Comitato delle attività di comunicazione
• Informativa sul tasso di errore
• Stato dell’arte della nuova programmazione 2023-2027
Dati di sintesi - liquidazioni al 31 dicembre 2022
Totale spesa pubblica al 31 dicembre 2022
2.4.2
Piano strategico nazionale della PAC 2023-2027 – Regolamento (UE) n. 2021/2115 del Parlamento europeo e del Consiglio del 2 dicembre 2021
Il Piano strategico nazionale della PAC 2023-2027 è stato approvato dalla Commissione Europea con Decisione n. C(2022)8645 finale del 2 dicembre 2022.
Il Regolamento (UE) n. 2021/2115 del Parlamento europeo e del Consiglio del 2 dicembre 2021 reca le norme sul
sostegno ai piani strategici che gli Stati membri devono redigere nell’ambito della politica agricola comune (piani strategici della PAC) e finanziati dal Fondo europeo agricolo di garanzia (FEAGA) e dal Fondo europeo agricolo per lo sviluppo rurale (FEASR) e che abroga i regolamenti (UE) n. 1305/2013 e (UE) n. 1307/2013.
Il Regolamento (UE) n. 2021/2116 del Parlamento e del Consiglio del 2 dicembre 2021 regola il finanziamento, sulla gestione e sul monitoraggio della politica agricola comune e abroga il regolamento (UE) n. 1306/2013.
La Giunta provinciale con Delibera n. 959 del 13.12.2022 ha approvato la
Interventi di sviluppo rurale attivati dalla Provincia Autonoma di Bolzano
SRA08 - gestione prati e pascoli permanenti
SRA09 - impegni gestione habitat natura 2000
SRA14 - allevatori custodi dell’agro biodiversità
SRA29 - pagamento al fine di adottare e mantenere pratiche e metodi di produzione biologica
SRA30 - benessere animale
SRB01 - sostegno zone con svantaggi naturali montagna
SRD01: Investimenti produttivi agricoli per la competitività delle aziende agricole
SRD04: Investimenti non produttivi agricoli con finalità ambientale
SRD11: Investimenti non produttivi forestali
SRD12: Investimenti per la prevenzione ed il ripristino danni foreste
SRD13: Investimenti per la trasformazione e commercializzazione dei prodotti agricoli
SRD15: Investimenti produttivi forestali
SRE01: Insediamento giovani agricoltori
SRG01: Sostegno gruppi operativi PEI AGRI
SRG05: Supporto preparatorio LEADER- sostegno alla preparazione delle strategie di sviluppo rurale
SRG06: LEADER - attuazione strategie di sviluppo locale
Costituzione del Comitato di Monitoraggio regionale per l’attuazione degli elementi regionali della Provincia Autonoma di Bolzano – Alto Adige del Piano Strategico nazionale della PAC 2023-2027 ai sensi del Regolamento (UE) n. 2021/2115.
La prima riunione del Comitato di Monitoraggio regionale per l’attuazione degli elementi regionali della Provincia Autonoma di Bolzano è stata convocata il 19 gennaio 2023.
SRH03: Formazione degli imprenditori agricoli, degli addetti alle imprese operanti nei settori agricoltura, zootecnia, industrie alimentari, e degli altri soggetti privati e pubblici funzionali allo sviluppo delle aree rurali
SRH05: Azioni dimostrative per il settore agricolo, forestale ed i territori
Il Centro di Sperimentazione Laimburg, fondato nel 1975, è un ente pubblico controllato dalla Provincia Autonoma di Bolzano dotato di propria personalità giuridica, che realizza attività di ricerca e sperimentazione negli ambiti delle scienze agrarie e delle scienze degli alimenti. La ricerca svolta dal Centro di Sperimentazione Laimburg promuove la coltivazione e la realizzazione di prodotti agricoli e alimentari altoatesini di qualità. Al Centro Laimburg lavorano ogni anno oltre 200 collaboratrici e collaboratori a circa 350 progetti di ricerca sia nei propri laboratori a Vadena e al NOI Techpark, sia sui campi sperimentali dell'Agenzia
Demanio Provinciale, con la quale è attiva una storica collaborazione. La ricerca scientifica spazia in tutti i settori dell’agricoltura altoatesina: dalla frutticoltura, alla viticoltura, dall’agricoltura montana fino alle colture specializzate come ortaggi, piccoli frutti e frutta con nocciolo.
Nel settore delle scienze alimentari, sviluppatosi in concomitanza con il NOI Techpark, il Centro di Sperimentazione Laimburg continua a incrementare le proprie competenze tecniche negli ambiti della trasformazione degli alimenti, della qualità e dell’innovazione di prodotti, ampliando l’offerta dei servizi alle aziende operanti nel settore alimentare. Con il suo lavoro sostiene così l’intera filiera alimentare, dal campo fino al prodotto finito. I laboratori del Centro forniscono a questo scopo un contributo importante nei vari settori di competenza: effettuano analisi di terreni, organi vegetali e foraggi, così come analisi dei residui, analisi chimico-fisiche e microbiologiche di mosti, vino, succhi di frutta e distillati.
2.5
Centro di Sperimentazione Laimburg

2.5.1 Programma di attività
Il Programma di attività del Centro di Sperimentazione Laimburg viene stilato a stretto contatto con i Comitati scientifici di settore, nei quali, accanto ai ricercatori del Centro, sono presenti i portatori d’interessi del mondo agricolo e della trasformazione alimentare altoatesina. In questo modo si assicura che i programmi di ricerca e sperimentazione siano indirizzati verso le richieste concrete dell’attività agricola in Alto Adige.
Nel 2022 sono stati invitati a contribuire alla stesura del Programma di attività del Centro 139 rappresentanti di gruppi di interesse locali dei settori agricoltura e trasformazione alimentare consegnando 113 proposte di progetto. Nel 2022, il team scientifico del Centro Laimburg ha realizzato complessivamente 397 progetti di ricerca e attività di sperimentazione. Le collaboratrici e i collaboratori del Centro sono impegnati fortemente anche nell’insegnamento e nella divulgazione delle conoscenze, per trasmettere agli studenti della Libera Università di Bolzano e degli istituti professionali agrari le loro conoscenze tecniche e quanto appreso nell’ambito delle attività di ricerca.
Tutti i progetti, le attività e le pubblicazioni del Centro di Sperimentazione
Laimburg possono essere scaricati dal sito www.laimburg.it. A cadenza biennale viene edito il “Laimburg Report”, che offre un quadro d’insieme della struttura e delle attività del Centro. L’ultima edizione è disponibile anche in forma digitale navigabile al link: https://report.laimburg.it/it. Inoltre, sul Laimburg Journal (www.journal. laimburg.it), rivista digitale open access del Centro Laimburg, vengono pubblicati articoli originali e relazioni.
Informazioni per il pubblico:
• 293 conferenze
• 186 pubblicazioni
• 134 eventi
• 298 visite guidate al Centro di Sperimentazione Laimburg
2.5.1
2.5.2 L’andamento meteorologico nel 2022
Lorenzo Panizzon, Andreas Wenter, Martin ThalheimerGennaio
Il decorso climatico del mese è stato nettamente più mite rispetto ai valori abituali per questa stagione. La temperatura media mensile è stata più alta di 1,2 gradi, superando chiaramente la media pluriennale di 0,0 °C. Comunque, le 28 giornate di gelo registrate - ovvero quelle giornate che raggiungono valori minimi inferiori allo zero - corrispondono al valore di riferimento pluriennale. Sia il valore minimo (-7,7 °C) che il valore massimo (15,9 °C) assoluto misurati alla stazione meteorologica di Laimburg sono lontani dai rispettivi valori storici estremi di -17,9 °C e 20,7 °C. Le scarse precipitazioni di 14,1 mm si collocano nettamente al di sotto rispetto a una media pluriennale di 35,8 mm. In più, un periodo con molteplici periodi di föhn e insolazione molto alta hanno portato all’innalzamento delle temperature. La durata di soleggiamento di 147 ore mensili è stata più alta del sessanta per cento rispetto alla media, portando a un decorso dallo stampo tutt’altro che invernale.
Febbraio
Come l’anno precedente, anche quest’anno il mese ha avuto un andamento più mite rispetto a quanto è consono per questa stagione. Con 4,1 °C la temperatura media mensile è stata più calda di 1,2 °C rispetto alla media pluriennale. Le 19 giornate di gelo occorse raggiungono quasi la media pluriennale di 20.
Dopo un mese di mancate precipitazioni, il 7 febbraio si è finalmente verificato un debole rovescio. A causa del passaggio di correnti fredde è stata registrata anche una breve e rapida diminuzione delle temperature, che ha raggiunto il suo minimo il 13 febbraio con una temperatura di -6,6 °C misurata alla stazione meteorologica di
Laimburg. Intorno alla metà del mese la regione è stata raggiunta da masse di aria provenienti da sud, recanti polvere del Sahara.
Nei due giorni seguenti si sono concentrate il novanta per cento delle precipitazioni mensili di 29,3 mm.
Date le temperature rigide, anche nella bassa atesina le precipitazioni si sono presentate in forma nevosa e hanno sbiancato il paesaggio per poco tempo. Durante il restante periodo del mese, le aree meridionali sono state avvantaggiate da estese situazioni di föhn, risultando in 144 ore di insolazione, il che corrisponde a un aumento del 25 % rispetto alla media.
Inverno 2021/2022
un inverno con scarse precipitazioni nevose e con temperature conformi ai valori tipici per la stagione in dicembre, seguiti da temperature più miti a gennaio e febbraio. Le precipitazioni sono risultate nettamente più scarse rispetto alla media pluriennale.
Marzo
Il clima secco che ha caratterizzato l’inizio dell’anno si è protratto anche a marzo. Anche se delle perturbazioni atmosferiche hanno attraversato il territorio, non si sono registrati rovesci se non negli ultimi due giorni del mese, che hanno portato modesti 3,4 mm di pioggia. In alcuni giorni polvere rossastra proveniente dal deserto del Sahara ha offuscato il cielo, rimasto altrimenti prevalentemente soleggiato per tutto il mese.
Anche se le temperature miti durante l’inverno avrebbero fatto pensare ad un precoce inizio della stagione vegetativa, il germogliamento nel 2022 non è iniziato in anticipo se paragonato ai cinque anni precedenti. A inizio mese forti gelate fino a -4,7 °C hanno caratterizzato il periodo. È seguito un innalzamento delle temperature che di conseguenza ha portato a un innalzamento della temperatura del suolo attorno a metà mese. La varietà Golden Delicious a Laimburg ha raggiunto lo stadio di bottoni verdi il 29 marzo, un giorno prima rispetto alla media pluriennale.
La temperatura media è risultata di 8,0 gradi e di conseguenza leggermente al di sotto della media pluriennale di 8,7 gradi. La media dell temperature minime si è collocata addirittura di 1,9°C sotto il relativo valore di riferimento
di lunga durata. Non sono invece avvenute gelate notturne che avrebbero reso necessario l’uso dell’irrigazione antibrina.
Aprile
Diversi fenomeni piovosi hanno caratterizzato l’inizio del mese, portando abbondanti precipitazioni. Gli 81 mm di pioggia misurati alla stazione meteorologica di Laimburg hanno fatto registrare un incremento del 41% rispetto alla media pluriennale. Questi rovesci hanno mitigato il deficit di precipitazioni accumulato da inizio anno, senza però pareggiarlo.
È seguito un periodo di debole alta pressione, durante il quale masse d’aria miti hanno caratterizzato il decorso climatico. Per brevi momenti si sono registrate temperature massime quasi estive, raggiungendo un picco di 26,6 °C. La seconda metà del mese è stata invece nuvolosa e instabile.
In generale, aprile si è presentato come di consueto molto variabile: il primo temporale dell’anno (l’8 aprile), la prima giornata estiva (il giorno 14), forti venti e alcune gelate notturne si sono verificate in breve successione. Non si sono registrate importanti diminuzioni di temperatura con rischio di gelate, per cui a Laimburg l’irrigazione antibrina è stata attivata solo tre volte. La temperatura media mensile di 12,5 °C si colloca nella media pluriennale.
Lo sviluppo vegetativo è avanzato rapidamente. La piena fioritura per la varietà Golden Delicious è stata raggiunta come l’anno precedente il 15 aprile. Questo dato corrisponde a un anticipo di due giorni rispetto alla media pluriennale.
Maggio
Durante questo mese le precipitazioni si sono limitate a un totale di 58,6 mm, corrispondenti a un deficit del 30% rispetto alla media pluriennale. È interessante notare, come già successo per il mese di febbraio, che la maggior parte della pioggia è caduta durante due soli giorni. Infatti, il sessanta per cento dei rovesci è stato misurato tra il 24 e 25 maggio.
Per quanto riguarda le temperature, dopo un primo periodo leggermente al di sotto della media l’arrivo verso metà del mese di masse d’aria subtropicali hanno fatto bruscamente salire la colonnina di mercurio. La tempera-
tura media di 19 °C è stata una tra le più calde finora registrate a Laimburg, e si colloca 2,2 °C al di sopra della media pluriennale. Il prolungato periodo di caldo durante la seconda e terza decade del mese ha causato otto giornate estive, con temperature massime al di sopra dei 25 gradi, con punte fino a 30 gradi. La prima notte tropicale, durante la quale la temperatura minima non è andata sotto i 20 °C, è stata registrata già il 19 maggio. È la data più precoce mai registrata alla Laimburg da inizio delle misurazioni.

Primavera 2022
Per lunghi periodi la primavera si è presentata come molto secca, specialmente durante il mese di marzo, trascorso senza alcuna precipitazione. L’andamento delle temperature è stato nella media durante marzo e aprile, mentre a partire dalla seconda decade di maggio è stata registrata la prima ondata di caldo del 2022.
Giugno
Con un valore medio di 22,9 °C, il mese si è mostrato più caldo rispetto alla media pluriennale di 20,5 °C.
Anche se non sono stati raggiunti valori massimi record come nel 2019 (con 38,5 °C misurati il 27 giugno), i valori hanno avuto un percorso comunque alto, con una massima di 34,9 °C. Allo stesso modo del 2021, si sono verificate venti giornate estive, a confronto della media pluriennale di sei. Durante le notti, la temperatura è comunque costantemente scesa sotto i 20 gradi.
Le precipitazioni sono state più abbondanti sia rispetto all’anno precedente che alla media pluriennale, con 117,5 mm di pioggia a confronto dei 30 mm del 2021 e dei 90 mm della media a lungo periodo. Nella parte orientale della provincia il tempo variabile è riuscito a colmare il deficit di precipitazioni. In particolare, la prima decade del mese ha portato a intense piogge locali, in alcuni casi con forti grandinate. Nell parte occidentale della regione invece si è protratta la mancanza di precipitazioni. In Val Venosta, ad esempio, si ha avuto un 45 % in meno di acqua piovana rispetto alla media. Le misurazioni di accrescimento dei frutti a Laimburg hanno rivelato diametri mediamente maggiori di 2 mm
rispetto all’anno precedente, ma leggermente sotto alla media.
Luglio
Per questo mese, dall’inizio delle misurazioni nel 1965 non si erano mai registrate temperature massime così alte. I 38,1 °C registrati il 22 luglio sono più alti di 0,2 °C rispetto al valore massimo registrato finora (e che risale al 12.7.1991). Rispetto alla media di 16, sono state misurate 27 giornate tropicali, un numero eccezionale finora verificatosi solo nel 2015. La soglia dei 35 °C è stata superata in undici occasioni, mentre le 293 ore di presenza di sole si collocano al secondo posto dopo quelle record del luglio 2013. Una ondata di calore simile si era verificata solo nel 2003. La pioggia è caduta solo in otto occasioni e i 52,7 mm di precipitazione sono per il 46 % al di sotto della media pluriennale. La temperatura media mensile di 25,3 °C è risultata la seconda più alta da inizio delle misurazioni, con valori ancora più elevati registrati solo nel 2015. A causa del prolungato periodo di siccità, a metà mese è stato proclamato lo stato di emergenza idrica in tutta
2.5.2
la provincia di Bolzano. Specialmente nelle zone montane la foraggicoltura
è stata messa a dura prova dalla mancanza di acqua, mentre la frutti- e viticoltura hanno approfittato dei sistemi di irrigazione per preservare i raccolti.
Agosto
Con i suoi 23,5 °C di media mensile, il mese è stato più caldo di 1,9 gradi rispetto alla media, continuando così il trend di eccezionale calura cominciato a fine maggio. La temperatura massima è stata misurata il 05.08. ed è stata di 36,6°C.
Anche la siccità si è ulteriormente protratta, con le precipitazioni che non hanno raggiunto più di 36,3 mm, rispetto alla media di 97,6 mm. Nelle parti settentrionali della provincia ripetute precipitazioni locali hanno attenuato l’emergenza idrologica. La raccolta è cominciata in anticipo, per la varietà Gala nella seconda settimana di agosto. A causa delle alte temperature la maturazione è avvenuta in modo rapido, penalizzando così la colorazione dei frutti.
Estate 2022
L’estate del 2022 si colloca tra i periodi più caldi e secchi da inizio delle registrazioni, andando a contendere il primato all’estate record del 2003. Straordinarie 70 giornate tropicali, di cui 13 con temperature massime sopra i 35 °C, e una temperatura media di 23,9 °C (2,4 °C sopra la media pluriennale) dimostrano l’eccezionalità di questa stagione estiva.
Settembre
Dopo diversi mesi con livelli di temperatura nettamente superiori alla media, all'inizio di settembre si è verificato un significativo abbassamento delle stesse. La temperatura media ha raggiunto i 17,2 °C, restando di 0,4 gradi al di sotto della media pluriennale. Soprattutto nella seconda metà del mese, le temperature notturne sono scese ben al di sotto dei dieci gradi, raggiungendo una minima assoluta di 3,3 °C. Questi sbalzi di temperatura hanno favorito la colorazione dei frutti delle varietà bicolori.
Per quanto riguarda le precipitazioni, queste sono risultate in linea con la media pluriennale, raggiungendo una somma di 80,3 mm. La raccolta della varietà Golden Delicious, che a Laimburg raggiunge la maturazione a
settembre, è iniziata con anticipo rispetto al consueto.
Ottobre
Un tipico clima autunnale si è instaurato in regione all'inizio di ottobre. Le 164 ore di presenza di sole sono state nettamente superiori alle 138 della media pluriennale, collocando questo mese al primo posto se paragonato ai 5 anni passati.
L'andamento delle temperature non ha fatto registrare eventi di rilievo, con nessuna giornata di brina e nessuna giornata estiva occorsa. La temperatura media mensile è stata nettamente superiore alla media, con 1,8 gradi in più rispetto al valore di riferimento pluriennale. Il mese di ottobre si è quindi rivelato uno dei più caldi dall'inizio delle registrazioni. Le precipitazioni invece sono state solo la metà rispetto al valore di riferimento pluriennale (83,7 mm).
Novembre
Dopo un ottobre caldo, novembre è iniziato con un sensibile calo delle temperature, che è proseguito per tutto il mese. Soprattutto le temperature dell’ultima decade sono state inferiori ai valori consueti per la stagione, facendo registrare otto dei tredici giorni di brina occorsi nel mese. Complessivamente, la temperatura media di questo mese (5,6 °C) ha superato di 0,6 °C il rispettivo valore di riferimento pluriennale.
Nonostante l'elevato numero di giorni di pioggia (12), a novembre sono caduti solo 43,6 mm di precipitazioni, pari al 54% della somma abituale. Di conseguenza, il livello della falda freatica è rimasto basso.
Autunno 2022
come già in estate, il totale delle precipitazioni della stagione è stato inferiore alla media. Ottobre e novembre hanno fatto registrare solo la metà delle precipitazioni rispetto alla media pluriennale, mentre settembre è nella media. Le temperature sono state superiori alla media per tutto il periodo - in modo significativo in ottobre, solo leggermente in settembre e novembre.
Dicembre
Un dicembre tipicamente invernale con precipitazioni nevose e basse temperature ha chiuso il 2022. Inizialmen-
te il mese ha presentato condizioni variabili, con due forti precipitazioni il 9 e il 15 dicembre con nevicate fino a fondovalle. La temperatura minima di -8,0 °C del 13 dicembre è stata moderata rispetto all'anno precedente (-10,9 °C) o al valore minimo mai registrato (-13,8 °C). La temperatura media mensile è risultata di 0,7 °C, di poco al di sopra rispetto al valore di riferimento pluriennale di 0,4 °C. Il numero di ore di insolazione e la radiazione globale hanno fatto misurare valori appena inferiori alla media.
Durante la settimana di Natale si è verificato uno stato di inversione termica, con un chiaro spostamento della linea di zero gradi verso quote più elevate ed un conseguente scioglimento del manto nevoso. Le precipitazioni mensili di 46,8 mm hanno avuto un decorso in linea con la media.
L'anno 2022 in breve
L'anno appena passato può essere riassunto come caldo e secco. L'elevata temperatura media annuale di 12,8 °C (è di 11,6 °C la rispettiva media pluriennale) è dovuta principalmente al decorso climatico generalmente caldo oltre che alle ripetute ondate di calore che si è sviluppato da metà maggio in poi fino alla fine di agosto. La temperatura massima misurata nel 2022 è stata registrata il 22 luglio ed è stata di 38,1 °C, lontana dalla temperatura record del 2009 (39,7 °C). 79 giornate tropicali sono un numero elevato rispetto a una media pluriennale di 41, e riflettono l'andamento generale del clima durante l'anno.
In termini di precipitazioni, l'anno 2022 è iniziato all'insegna della siccità, con un deficit di acqua a causa degli scarsi fenomeni piovosi che è aumentato da luglio in poi, man mano che l'anno procedeva. In particolare, i mesi di luglio, agosto, ottobre e novembre, caratterizzati da scarse precipitazioni, hanno contribuito in modo significativo alla bassa precipitazione totale annuale di 607 mm, significativamente inferiore alla media a lungo termine di 816 mm.
2.5.3
Istituto di Fruttie Viticoltura
2.5.3.1 Prove varietali per una coltivazione di successo dell'albicocco in Val Venosta
Gasserte dopo la metà di agosto, il che rende ancora più difficile la vendita delle albicocche venostane a maturazione tardiva provenienti dai siti di coltivazione più alti. Per contrastare questo fenomeno, è essenziale una selezione che individui la giusta varietà in funzione del sito pedoclimatico.
Prova sperimentale a Tomberg
Nel 2016 sono state piantate presso il Kühsteinhof (Tomberg, Castelbello-Ciardes, 700 m.s.l.m.) le prime novità varietali internazionali di albicocco sul portainnesto standard St. Julien A, in triplice ripetizione. Ogni anno si sono aggiunte numerose altre varietà. Per valutare la loro attitudine alla coltivazione sono stati rilevati produzione in kg per pianta, dimensione, forma e colore dei frutti, fenologia, compatibilità d’impollinazione, maturazione/finestra di raccolta e caratteristiche qualitative.
Oltre 70 varietà testate fino ad oggi
La superficie coltivata ad albicocche in Val Venosta ammonta a circa 70 ettari ed è rimasta relativamente costante negli ultimi anni. Con una quota del 55%, la varietà locale "Vinschger Marille" (fig. 1) occupa il primo posto nell'elenco delle varietà e viene commercializzata soprattutto a livello regionale. A causa della loro ridotta conservabilità, questa varietà deve essere commercializzate entro un periodo di tempo molto breve dopo la raccolta. Ciò porta a un'eccessiva saturazione del mercato locale nelle annate di piena produzione. Inoltre, il consumo di questo frutto diminuisce drasticamen-

Nel sito di prova, negli anni passati sono state raccolte e valutate oltre 70 varietà diverse (fig. 2) da metà giugno a fine luglio. Oltre al tempo di maturazione, sono state riscontrate forti differenze nella colorazione dei frutti (fig. 3). Questa caratteristica ha permesso di classificare le varietà di albicocco in cinque classi di colore. Da un lato, la varietà "Vinschger" con classe di colore 1 (colore di base giallo chiaro; vedi foto) si distingue in modo chiaro dalle varietà "Luxared" e "Rubista" con classe di colore 5 (colore di fondo rosso). Nel mezzo ci sono varietà con un colore di fondo aran-
cione (classe di colore 2), una guancia leggermente rossa (classe di colore 3) o un sovracolore prevalentemente rosso (classe di colore 4; vedi foto). La classificazione in base alle classi di colore facilita la scelta delle varietà in base alle possibilità di commercializzazione. Inoltre, sono state riscontrate differenze significative tra le varietà in termini di dimensioni dei frutti. Da un lato, le varietà "Monstercot" e "Luxared" hanno raggiunto dimensioni notevoli con quasi 90g per frutto. D'altra parte, le varietà "Pieve", "Visalia" e "Bergeval", con poco meno di 35g per frutto, appartengono al gruppo delle varietà con pezzatura ridotta.

Sette varietà entreranno nella seconda fase di selezione Delle 70 varietà finora esaminate, sette sono state valutate molto positivamente ed entreranno nella seconda fase di selezione. Tra le varietà pre-

coci, “Pricia”, “Spring Blush” e “Tsunami” si sono distinte positivamente per le caratteristiche eccezionali dei frutti. Le varietà “Sefora” (fig. 4), “Orange Rubis”, “Flash Cot” e “Clarina” hanno dato ottimi risultati nelle varietà a maturazione medio-tardiva. Tutte queste varietà saranno piantate in numero più elevato in varie località della Val Venosta e saranno valutate in modo più approfondito con ulteriori sperimentazioni.
Elias Holzknecht, Walter Guerra Gruppo di lavoro Pomologia Christian Andergassen, Daniel Pichler Gruppo di lavoro Fisiologia Frutticolturascarsa illuminazione. Sul mercato si stanno affacciando numerose nuove applicazioni digitali. Il Centro di Sperimentazione Laimburg è impegnato già dal 2018 nel testare questi sistemi per verificarne la precisione e la riproducibilità nella pratica agricola.
Valutazione di quattro sistemi disponibili sul mercato
Deviazioni presenti in tutti i sistemi testati
La previsione di parametri economicamente rilevanti è un aspetto importante nella produzione melicola. Le stime previsionali manuali delle rese sono molto impegnative e costose, richiedono molto tempo e spesso forniscono risultati imprecisi. Con l'aiuto di moderni sistemi di riconoscimento delle immagini e dell'intelligenza artificiale è potenzialmente possibile fare previsioni sulle rese e sulla distribuzione dei calibri dei frutti in tempi più brevi. I dati raccolti potrebbero poi essere utilizzati per ottimizzare o modificare le tecniche di coltivazione e risparmiare risorse. Le sfide di questi sistemi sono soprattutto il riconoscimento e il conteggio di frutti nascosti nella chioma in condizioni di
Sono stati valutati tre sistemi digitali per la previsione della resa (“Intelligent Fruit Vision”, “Perfrutto” e “Pixofarm”) e l'applicazione “Clarifruit”, ideata per stimare direttamente nel cassone della raccolta la distribuzione dei calibri e la qualità dei frutti. I sistemi sono stati valutati su varietà diverse per una o due stagioni dal 2018 al 2021. Il sistema di telecamere “Intelligent Fruit Vision” è stato montato su un trattore e testato a una velocità di 8 km/h. Nel sistema “Perfrutto” i dati sono stati raccolti con un calibro e ulteriormente elaborati da HkConsulting per fare previsioni sulla distribuzione delle classi dimensionali. Le applicazioni “Pixofarm” e “Clarifruit” sono state installate su uno smartphone. Un adesivo sul frutto e una pallina da ping-pong nella cassetta servivano rispettivamente come riferimento durante le misurazioni. Per determinare la distribuzione del calibro, i dati sono stati confrontati con i risultati effettivi della cernita o con il diametro effettivo, determinato in loco con un calibro digitale (fig. 2).
I sistemi di previsione della resa testati hanno mostrato deviazioni fino al 29%. Le deviazioni variavano a seconda della località e della varietà. “Intelligent Fruit Vision” ha mostrato deviazioni dal 2% (Cripps Pink/Pink Lady®) fino al 29% (Gala). In quasi tutte le date di misurazione sono stati contati meno frutti. Anche tra le varietà sono state osservate diverse deviazioni, che potrebbero essere causate dalla differente dinamica di crescita delle varietà. In aggiunta, è stato osservato una maggiore precisione con i valori determinati manualmente all'avvicinarsi della data di raccolta (Fig. 3).
La misurazione del sistema “Perfrutto” è stata effettuata manualmente con un calibro. Rispetto al sistema “Intelligent Fruit Vision”, sono state trovate fluttuazioni minori nella deviazione in tutte le posizioni. La deviazione per le varietà Golden Delicious e Cripps Pink/Pink Lady® è stata inferiore al 10%, nei limiti di tolleranza segnalati dagli utenti. Con Gala, invece, sono state osservate deviazioni superiori al 10%. Da agosto in poi, la deviazione media nella distribuzione complessiva è stata inferiore al 10%, indipendentemente dalla varietà e dalla località. Tra tutte le varietà e le località, le differenze maggiori sono state riscontrate in media a un diametro di 70-80 mm.

Validazione di sistemi digitali per la previsione della resa e del calibro dei fruttiFig. 3: Classificazione delle varietà di albicocco in cinque classi di colore
L'applicazione “Pixofarm” ha mostrato grandi deviazioni tra i diametri registrati dall'applicazione e quelli del calibro. La differenza massima tra tutte le date di indagine per Cripps Pink/Pink Lady® è stata di 8,5 mm, mentre la più piccola è di -0,8 mm. Poiché non sempre è stato riconosciuto il contorno dei frutti, è stato necessario correggere manualmente fino al 38% dei diametri registrati. La causa principale di questo disfunzionamento potrebbe essere la disomogeneità delle condizioni di luce durante la misurazione. Inoltre, non deve essere sottovalutato il tempo necessario per trovare i frutti nascosti, per applicare gli adesivi sui frutti (fig. 4) e per correggere i diametri. Per quanto riguarda l'applicazione “Clarifruit”, nel complesso sono state riscontrate solo lievi deviazioni. Sono stati riscontrati scostamenti fino al 9% in più scansioni dello stesso cassone. Il confronto tra i risultati dell'applicazione e quelli della cernita ha mostrato solo differenze medie minime dell'1%. È stato, inoltre, notato che le deviazioni si sono verificate più frequentemente con i calibri più grandi che con quelli più piccoli.



È necessario un ulteriore sviluppo
Alcune applicazioni e sistemi forniscono già previsioni relativamente accurate. Tuttavia, la maggior parte dei sistemi testati mostra ancora deviazioni eccessive. Il tempo necessario per raccogliere i dati è stato spesso superiore a quello necessario per
le misurazioni manuali con i calibri. I risultati dei calibri sono stati generalmente più precisi di quelli dei sistemi testati. Per questo motivo, è necessario sviluppare ulteriormente tali tecnologie e, soprattutto, migliorare i sistemi di riconoscimento di oggetti e immagini. 2.5.3

Cambiamenti nella maturazione delle uve secondo i
test annuali
Barbara Raifer Settore Viticoltura Andreas Sölva Laboratorio di Analisi Vino e BevandeRispetto ad alcuni decenni fa, la vendemmia in molte annate è nettamente anticipata, il grado zuccherino delle uve più alto e l’acidità più bassa. Quale è realmente l’entità di questi cambiamenti? Per dare una risposta a questa domanda sono stati elaborati i dati dei test annuali di maturazione delle uve effettuati dal 1985 ad oggi dal Laboratorio di Analisi Vino e Bevande del Centro di Sperimentazione Laimburg per le varietà più rappresentative, coltivate in diverse zone dell’Alto Adige. Questi dati provengono da campionamenti d’uva raccolti in maniera uniforme ogni lunedì nelle tre/sei settimane prima della vendemmia e poi preparati e analizzati in laboratorio.
Lo sviluppo del Pinot bianco ad Appiano Monte come esempio
Prima del 2000, i gradi zuccherini al primo di settembre si aggiravano tra 8 e 14 °Babo. Dopo il 2000 tra i 13 e 19 °Babo (fig. 1). In molte annate degli ultimi decenni, spesso già nella prima metà di settembre, si sono raggiunti 19 e 20 °Babo; eventi che precedentemente accadevano molto di rado.

Per quanto riguarda l’acidità totale, il quadro che si presenta è un po’ diverso. Prima dell’inizio di settembre i valori comparati di annate diverse sono molto eterogenei, ma in prossimità della raccolta si uniformano (fig. 2). Complessivamente non sono emerse modifiche dell’acidità così evidenti come per il grado zuccherino.
I valori del pH hanno mostrato un quadro simile a quello dell'acidità totale. Sebbene i valori al 1° settembre fossero significativamente più alti rispetto al passato nelle annate successive dal 2000, se si osservano i


valori in prossimità della vendemmia, essi erano più alti rispetto al passato solo in alcune annate particolarmente calde. La varietà Pinot bianco nella
zona di Appiano Monte, nella metà degli anni ‘80 raggiungeva 16 °Babo tra il 25 e il 30 di settembre, mentre oggi questi valori si registrano
già inoltro al 20 di agosto. Sorprendentemente, dopo il 200 a parità di concentrazione zuccherina, l’acidità totale è tendenzialmente più elevata (fig. 3) e i valori di pH a parità di acidità totale sono inferiori. Questo soprattutto in prossimità della raccolta. L’anno 2003 rappresenta un’eccezione per i valori elevati del pH dei mosti, mentre il grado zuccherino e l’acidità totale sono nella media.
Conclusioni
Le variazioni rintracciate non sono da attribuire solamente al cambiamento climatico, ma anche a tutte le tecniche di viticoltura attuate per migliorare la qualità dei vini, come ad esempio, le modifiche sui sistemi di allevamento, le rese di produzione, l’impiego di nuove varietà e cloni. Risulta, inoltre, difficile riuscire a distinguere il peso del cambiamento climatico da quello
2.5.3.2 Istituto di Agricoltura Montana e Tecnologie Alimentari
Christoph Wedmann, Markus Gatterer, Giovanni Peratoner Gruppo di lavoro ForaggicolturaNella produzione di latte nella Provincia di Bolzano si è affermato l’allevamento in stalla per tutto l'anno. L’allevamento al pascolo può contribuire ad un’alimentazione efficiente degli animali. Il pascolamento continuo a superficie variabile (tedesco: Kurzrasenweide) è una forma intensiva di gestione, nella quale l’erba viene mantenuta ad un'altezza media di 5-6 cm durante la stagione vegetativa. L’obiettivo è quello di fornire costantemente un foraggio di alta qualità

con un basso fabbisogno di manodopera e minimo spreco di foraggio. Per questo motivo le dimensioni dell’area pascolata vengono adattate costantemente alla crescita dell'erba, che cambia con l’andamento meteorologico e stagionale. Questa forma di gestione del pascolo — praticata con successo nell’arco alpino, ma relativamente poco conosciuta nella Provincia di Bolzano — è oggetto di studio nell’ambito del progetto "Confronto di sistemi di allevamento" del Centro di Sperimentazione Laimburg in collaborazione con la Libera Università di Bolzano presso l'azienda "Mair am Hof" a Teodone.
Rilevamento dei parametri del pascolo
Nell’ambito del progetto viene praticata una forma di gestione particola-
delle pratiche viticole sull’andamento della maturazione.
I risultati completi dell’analisi dei dati storici di maturazione sono visualizzabili qui: https://doi.org/10.23796/ LJ/2021.003
re, nella quale la superficie è compartimentata in lotti. La pianificazione del pascolo dipende dall’altezza dell’erba in ciascun lotto, che viene misurata settimanalmente in 75 punti scelti casualmente (Fig. 1). In ogni lotto c'è una superficie esclusa dal pascolo, della quale una metà viene sfalciata ogni due settimane per quantificare le variazioni del tasso di accrescimento dell'erba nel corso della stagione vegetativa.
Risultati
Il periodo di pascolamento a Teodone va da fine marzo a fine ottobre. La crescita dell'erba determina il numero di lotti che vengono offerti agli animali ogni settimana. Di conseguenza, il numero di lotti utilizzati non segue un modello rigido (Fig. 2). Ad esempio, negli anni 2019 e 2020 sono stati
Valori guida per la gestione del pascolo mediante pascolamento continuo a superficie variabileFig. 1: Misura dell’altezza dell’erba mediante erbometro 2.5.3
utilizzati solitamente tre lotti, mentre negli anni 2021 e 2022 spesso ne sono stati utilizzati solo due. Il tasso medio di accrescimento dell’erba differisce a seconda degli anni di prova e del lotto (Fig. 3). I tassi più elevati (circa 90 kg di s.s./ha/giorno) sono stati osservati da fine aprile a inizio maggio del 2022, mentre nello stesso periodo del 2021 si sono registrati i tassi più bassi (circa 40 kg/ha/giorno). Dopo il mese di mag-

gio l’accrescimento è diminuito rapidamente in tutti gli anni ed è rimasto relativamente costante fino alla fine della fase estiva del pascolo. Nel 2021 e nel 2022 si è registrato in estate un secondo picco di crescita.
Conclusione / Prospettiva Con queste indagini sono stati prodotti per la prima volta valori guida per la gestione mediante pascolamento
continuo a superficie variabile nella Provincia di Bolzano. I risultati mostrano che la crescita dell’erba durante il periodo di pascolamento e anche tra gli anni può variare fortemente. Di conseguenza, un continuo e tempestivo adattamento della superficie pascolata è un elemento essenziale di una buona gestione del pascolo.


I funghi epifiti con sintomi come le fumaggini o la malattia delle chiazze di pioggia (Fig. 1) possono causare importanti perdite durante conservazione. La contaminazione avviene in campo, ma non è stato finora possibile trovare una difesa soddisfacente contro queste specie fungine patogene nel frutteto. I funghi possono formare un prato ifale ben visibile sui frutti già presenti sull'albero o moltiplicarsi solo durante la conservazione (Fig. 2).


È possibile frenare lo sviluppo dei funghi epifiti durante lo stoccaggio?
È noto che la modifica convenzionale dell'atmosfera durante lo stoccaggio in CA-ULO (atmosfera controllata) non impedisce in modo significativo lo sviluppo di questi microrganismi, ma può ritardarlo. Pertanto, è stata studiata l'influenza dell'umidità, solitamente piuttosto elevata nelle celle di stoc-
caggio, sulla varietà suscettibile Cripps Pink/Pink Lady®. Inoltre, è stato studiato l'effetto dell'atmosfera ionizzata in collaborazione con l'azienda Isolcell di Laives. Sono stati installati degli ionizzatori d'aria in una cella frigorifera della cooperativa BioSüdtirol (Fig. 3), con i quali le molecole d'aria vengono caricate elettrostaticamente mediante un'alta tensione elettrica. In collaborazione con l’istituto di ricerca svizzero Agroscope, è stato anche studiato l'effetto di un'atmosfera di stoccaggio arricchita con basse concentrazioni di ozono.
Quali fattori di conservazione riducono i danni da epifiti?
Una riduzione dell'umidità ha mostrato un effetto positivo già dopo un periodo di conservazione molto breve. Questa
tendenza è proseguita durante la conservazione più lunga in atmosfera controllata (CA-ULO). In questo contesto, bisogna tenere conto dell'effetto collaterale negativo di una maggiore perdita di peso del frutto. La ionizzazione dell'atmosfera ha mostrato un certo potenziale di riduzione dei sintomi, in altri casi una variazione dei generi fungini coinvolti nel sintomo: invece delle fumaggini, nell'atmosfera ionizzata è stata osservata prevalentemente una patina bianca. Il trattamento con ozono è stato in grado di sopprimere più chiaramente lo sviluppo del sintomo, con un effetto che è durato a lungo dopo il trattamento, cosa che non è avvenuta con la ionizzazione.
Conclusioni e prospettive
L'indagine microbiologica e di biologia molecolare dei microrganismi presenti sulla buccia ha dimostrato che un'alta percentuale è formata da funghi ubiquitari, che sono favoriti dall'aumento dell'umidità durante la conservazione. Una riduzione significativa è stata ottenuta con l'ozono, mentre la ionizzazione dell'aria ha portato a variazioni delle specie fungine. Tuttavia, entrambi hanno mostrato un diverso grado di untuosità della buccia come effetto collaterale, le cui cause devono ancora essere indagate in modo più approfondito. Inoltre, restano da chiarire numerose questioni per l'applicazione dei risultati sperimentali su scala pratica.
Influenza delle tecnologie di conservazione su fumaggini e patologie simili della melaFig. 2: Il magazzino sperimentale del Centro di Sperimentazione Laimburg Fig. 1: Diversi sintomi di fumaggini e simili. 2.5.3 Bianchi, Noreen Faller, Elena Venir Gruppo di lavoro Trasformazione dei Prodotti Ortofrutticoli
si producono grossi volumi di liquidi da smaltire. È opportuno considerare metodi di applicazione più sostenibili per ridurre l'impatto ambientale e i costi. In questo studio, a carattere preliminare e su scala di laboratorio, è stata confrontata su mele Golden Delicious l’efficacia antiossidante delle tecniche di immersione e spraying (irrorazione).
Confronto tra metodi
La produzione di mele fresh cut prevede l’immersione del prodotto in soluzioni antiossidanti per inibirne l’imbrunimento. La tecnica presenta limiti microbiologici, economici ed ecologici: ripetuti cicli di immersione, infatti, determinano sia un aumento della carica microbica sia una riduzione della concentrazione di principi attivi nella soluzione. Inoltre,
Le mele sono state immerse per 5 minuti in una soluzione contenente sali e acido ascorbico o irrorate - con 12, 16, 20 e 24 spruzzi di una soluzione a concentrazione doppia rispetto la precedente (Fig. 1A). La frutta trattata è stata conservata a 4 °C per 99 ore. È stato quindi misurato e valutato l’assorbimento di acido ascorbico, nonché l’evoluzione del colore nel tempo con colorimetro e visivamente (macchie scure). Infine, sono state calcolate le differenze di luminosità, croma, tinta e colore totale.
Risultati: efficacia antiossidante
Fino a 50 ore di conservazione (circa 2 giorni) i due trattamenti hanno mo-
strato un'efficacia paragonabile, ad eccezione del trattamento spraying con soli 12 spruzzi, che è risultato inefficace. A fine stoccaggio (99 ore), il trattamento di immersione ha tendenzialmente esibito un lieve vantaggio sullo spraying, che tuttavia ha dato risultati simili (Fig. 1B). Anche visivamente (macchie scure) le mele irrorate con un numero pari o maggiori a 16 irrorazioni non differivano da quelle trattate per immersione (Fig. 1C). Tale risultato non sembra dovuto alla sola quantità di acido ascorbico assorbita, in quanto gli spicchi immersi non mostravano una concentrazione superiore rispetto a quelli sottoposti a spraying (Fig. 2).
Conclusioni: potenzialità della tecnica dello spraying
Si deduce che la distribuzione dell’antiossidante gioca un ruolo pari o maggiore rispetto alla sua concentrazione e che la procedura di immersione degli spicchi di mela agevoli una capillare distribuzione dei soluti nel tessuto del frutto. Si ipotizza che modulando le concentrazioni dei soluti e la tecnica

Uso dello spraying come alternativa sostenibile all’immersione per il trattamento delle mele fresche tagliate
FlaviaFig. 3: Il sistema di ionizzazione dell'aria nella pratica.
di applicazione spraying, sia possibile compensare questa minor distribuzione.

Nel presente studio, lo spraying è risultato efficace contro l’imbrunimento delle mele quanto il trattamento di

immersione. L’irrorazione della superficie con antiossidanti può presentare diversi vantaggi: evita la contaminazione e non produce soluzione in eccesso da dover smaltire. Sono necessarie ulteriori indagini per ottimizzare
la procedura e valutare
scalabilità a livello industriale.
2.5.3.3 Istituto
della Salute delle Piante
Una serra tropicale al Centro di Sperimentazione Laimburg
Helga Salchegger Settore Floricultura e Paesaggistica
questo scopo è stato creato un database contenente informazioni sull'origine e la manutenzione delle piante, oltre a interessanti nozioni di botanica, ecologia, impiego e curiosità.
La zona asciutta e la zona umida
petizione per la luce è molto alta. Ci sono specie che sfuggono a questa competizione come piante rampicanti o epifite. Specie tropicali, piante utili e ornamentali, specie provenienti dall'America centrale e meridionale, dall'Asia, dall'Africa e dall'Australia, crescono qui a stretto contatto.
Alla fine degli anni '80 si sono aggiunte sempre più specie vegetali esotiche alla Giardineria Laimburg che necessitavano della protezione di una serra. Per offrire a queste piante condizioni ottimali, nel 1996 è stata costruita l'attuale serra tropicale, con un'altezza di 8 metri e una superficie di 750 m². Dato che il patrimonio vegetale ha continuato ad aumentare grazie alle donazioni e alla produzione interna, nel 2022 sono state etichettate e catalogate digitalmente le diverse specie e varietà per renderle così più fruibili. A
La serra tropicale è divisa in una parte asciutta, modellata sul clima delle regioni aride, in cui sono rappresentati paesaggi dove le precipitazioni medie annue ammontano a soli 100 mm sul lungo periodo. Qui si trovano diverse specie di agave provenienti dal deserto di Sonora in Messico (Agave titanota, A. attenuata) e un'euforbia a candelabro del Sudafrica (Euphorbia conspicua). Sono presenti anche specie provenienti dei deserti dell'Australia e dell'Asia. Il lato sinistro della zona secca della serra è dominato da un albero del drago (Dracaena draco), seminato nel 1990, e da una palma da dattero delle Canarie (Phoenix canariensis), le cui dimensioni stanno lentamente raggiungendo i limiti della serra.
Pochi passi portano i visitatori da un'atmosfera desertica direttamente ai tropici caldi e umidi. Qui si trova la seconda parte della collezione. Foreste pluviali tropicali di pianura coadiuvate da un clima caldo e umido. A causa della crescita molto rapida delle piante in questo habitat, la com-
Una collezione di oltre 200 specie e varietà di piante tropicali
La catalogazione ha contato oltre 200 specie e varietà tropicali, che crescono nella serra presso il Centro di Sperimentazione Laimburg da più di 35 anni. Questo patrimonio offre una panoramica generale sul tema delle piante tropicali, ma anche approfondimenti su argomenti particolari: da piante utili tropicali più o meno note (cacao) a piante piuttosto sconosciute (pitaya), passando per le spezie, le classiche piante da appartamento, le epifite, le felci e le piante adattate ai climi secchi.
Chi vuole esplorare il mondo della botanica può conoscere le metamorfosi, la struttura dei fiori o l'evoluzione tra pianta e impollinatore. Il presupposto per la conservazione e lo sviluppo sano delle piante è la cura quotidiana e professionale in modo che questa collezione possa continuare a svilupparsi.
Marciume lenticellare asciutto: una nuova patologia delle mele in post-raccolta
Stefanie Maria Primisser, Evi Deltedesco, Sabine Öttl
Gruppo di lavoro Fitopatologia
I sintomi del marciume lenticellare asciutto sulle mele sono stati descritti per la prima volta circa dieci anni fa, ma solo negli ultimi anni sono aumentate le segnalazioni da parte delle cooperative frutticole
a livello locale. La varietà Golden Delicious sembra essere particolarmente colpita e i sintomi tipici sono tacche a chiazze di colore bruno-rossastre, che compaiono dopo alcuni mesi di conservazione nelle celle frigorifere (fig. 1). Il fungo del genere Ramularia è stato identificato come l'agente causale di questo danno. I rappresentanti di questo genere causano malattie da macchie fogliari su numerose colture, tra cui orzo, barbabietola da zucchero e fragole. Nella coltivazione del melo, tuttavia, questo parassita ha una caratteristica particolare, in quanto i sintomi si sviluppano sulla frutta solo dopo lo stoccaggio e non sono visibili sulle foglie in campo. Poiché la malattia è comparsa solo di recente sul melo e finora solo poche aree di coltivazione sembrano essere colpite, le in -
formazioni sulla biologia del fungo e sullo sviluppo di questa malattia sono scarse.
Indagini sistematiche sull’occorrenza del danno nelle cooperative frutticole altoatesine

Per poter valutare meglio l'entità dell'infestazione da Ramularia in Alto Adige è stata avviata, in collaborazione con le cooperative di produttori Vi.P. e VOG, un'indagine sistematica sulla presenza dei sintomi nel raccolto 2021 al momento dell’apertura delle celle di frigoconservazione. Alla fine di giugno 2022, sono state segnalate più di 150 partite colpite, di cui quasi il 97 % riguardava la varietà Golden Delicious. Per queste segnalazioni, non è evidente alcun legame con il momento della raccolta o la metodologia di conservazione. Dalla
2.5.3
metà dei campioni sono stati ottenuti isolati fungini sottoposti a ulteriori indagini.
Caratterizzazione genetica del genere fungino Ramularia
Degli isolati fungini, 35 sono stati selezionati, caratterizzati tramite metodi di biologia molecolare sulla base di una sezione di DNA e paragonati con i database internazionali per l'identificazione. Tutti gli isolati sono stati assegnati inequivocabilmente al genere Ramularia. Una precisa identificazione del fungo a livello di specie, tuttavia, richiede un'analisi più approfondita di ulteriori porzioni del genoma. Inoltre, è necessaria un numero maggiore di isolati provenienti dai diversi distretti di melicoltura altoatesina. I primi risultati di queste indagini su circa 90 isolati fungini indicano che in Alto Adige diverse specie di Ramularia possono avere un ruolo nello sviluppo dei sintomi.
Ricerca di base e applicata per combattere il marciume lenticellare asciutto
La determinazione esatta della specie di Ramularia che causa i sintomi in Alto Adige è la base per lo sviluppo di una possibile strategia di controllo futura. Grazie all'indagine sistematica sulla presenza dei danni nelle cooperative frutticole, che proseguirà con i prossimi raccolti, si potranno identificare le zone di coltivazione particolarmente colpite e sviluppare misure preventive.
Un anno intenso per il Laboratorio di Virologia e Diagnostica
Yazmid Reyes
Domínguez, Andreas Gallmetzer, Christian Springeth Laboratorio di Virologia e DiagnosticaIl Laboratorio di Virologia e Diagnostica si occupa della diagnosi delle malattie delle piante causate da batteri, virus, viroidi, fitoplasmi e funghi. Esegue test sul materiale di propagazione per la frutticoltura e la viticoltura, la coltivazione di ortaggi e le piante ornamentali nell'ambito dei controlli fitosanitari regolamentati per legge. Esso è anche il laboratorio di riferimento del Servizio fitosanitario provinciale della Provincia Autonoma di Bolzano e quindi responsabile dei controlli ufficiali di laboratorio e di altre attività nell'ambito della pro-

tezione e della salute delle piante in Alto Adige. Di particolare interesse sono i controlli per gli organismi da quarantena (OQ).
Gli OQ sono organismi che possono danneggiare le piante, ma che non sono ancora presenti in un'area specifica o hanno una distribuzione limitata e sono soggetti a monitoraggio e controllo ufficiale. Si tratta di organismi nocivi particolarmente pericolosi e potenzialmente di grande importanza economica, sociale o ecologica. Contro di essi sono disponibili misure efficaci per prevenirne l'introduzione
e la diffusione e per mitigare i danni che causano.
Accreditamento, organismi invasivi da quarantena e nuove specie di insetti
Nel 2022 il laboratorio ha ottenuto l'accreditamento secondo la norma ISO/IEC 17025 "Requisiti generali per la competenza dei laboratori di prova e taratura" per la diagnosi di due importanti organismi nocivi da quarantena: per il batterio Xylella fastidiosa e per il fitoplasma che causa la flavescenza dorata della vite. Per la rilevazione di questi patogeni sono stati accreditati due diversi metodi, il test ELISA (ingl.: enzyme-linked immunosorbent assay) e il metodo della PCR in tempo reale (ingl: real-time PCR).
Nel 2022 è stata, inoltre, istituita una rete di laboratori a livello italiano per standardizzare, revisionare,
sviluppare e verificare i protocolli nazionali per la diagnosi dei patogeni vegetali. Il Laboratorio di Virologia e Diagnostica fa parte di questa rete e ha anche partecipato allo sviluppo di nuovi protocolli. Nel 2022 è stato realizzato il protocollo per il rilevamento del patogeno batterico delle piante Pantoea stewartii subsp. stewartii, l'agente causale della malattia di Stewart nel mais ( Zea mays L. ). La presenza di questo patogeno è presente negli Stati Uniti, ma non è ancora nota in Europa ed è quindi considerato un organismo da quarantena.

Nell'ambito delle analisi interne per i casi sospetti di insetti invasivi da quarantena, dopo una prima determinazione morfologica da parte del gruppo di lavoro Entomologia del Centro di Sperimentazione Laimburg, sono state effettuate determinazioni biologiche molecolari più approfondite.
Queste analisi hanno escluso la presenza di insetti invasivi da quarantena. Inoltre, in stretta collaborazione con il gruppo di lavoro Valutazione Fitofarmaci del Centro, è stato identificato per la prima volta l'afide asiatico dell'albicocco, Myzus mumecola, potenziale vettore del Plum Pox Virus (PPV), causante della malattia di Sharka sulle albicocche.
Numero di campioni analizzati e prospettive
Ogni anno, vengono esaminati in media 3.500 campioni di melo, vite, piante orticole e piante ornamentali. A causa dei crescenti requisiti legali, ma anche delle nuove fitopatologie emergenti e dei parassiti invasivi, il numero di esami continuerà ad aumentare. L'implementazione e la validazione di metodi di rilevamento innovativi e rapidi è quindi una parte centrale dei compiti del laboratorio.
2.5.3
3500 campioni analizzati
Cooperative e vivai; 3% Contadini e privati; 2%
Centro di Sperimentazione Laimburg; 11%


2.5.3.4 Istituto di Chimica Agraria e Qualità Alimentare
Rosy Glow/Pink Lady®
La sfogliatura pneumatica/meccanica è una nuova tecnica agricola che mira a ridurre la massa fogliare dei meli. Questa procedura ha come risultato un aumento della colorazione rossa dei frutti e viene applicata, per esempio, sulla varietà Rosy Glow/Pink Lady® (Fig. 1). Le prove effettuate in campo dimostrano che l'uso di questa tecnica poco prima della raccolta, in combinazione con la potatura estiva d’illuminazione, ha un effetto significativo sulla colorazione dei frutti, senza diminuire la produttività dell’impianto.

Determinazione del contenuto di antociani nella buccia delle mele
Gli antociani sono responsabili per la colorazione rossa di frutta e verdura. Ad esempio, le more presentano il caratteristico colore rosso scuro grazie all'elevato contenuto di antociani. Per determinare l'efficacia della sfogliatura ad alta pressione sull'aumento del colore rosso desiderato nelle mele Rosy Glow/Pink Lady®, è stata misurata la quantità di antociani nella buccia delle mele (Fig. 2). A tal fine sono stati prelevati campioni di mele da al-


La sfogliatura pneumatica aumenta il contenuto di antociani nelle meleDaniela Hey, Peter Robatscher, Laboratorio per Aromi e Metaboliti Christian Andergassen, Gruppo di lavoro Fisiologia Frutticoltura Fig. 1: Sfogliatura pneumatica/meccanica in combinazione con la potatura estiva di illuminazione (sopra) e testimone non trattato (sotto). Fig. 2: Analisi degli antociani nelle bucce di mele. 2.5.3
beri che non erano stati trattati e da alberi, che erano stati trattati con potatura estiva d’illuminazione manuale seguita da sfogliatura pneumatica due settimane prima della raccolta. Il contenuto di antociani nella buccia delle mele è stato determinato con un metodo foto-spettrometrico.
Effetti della sfogliatura sul contenuto di antociani È stata riscontrata una differenza notevole degli effetti della sfogliatura sul contenuto di antociani a seconda della posizione del frutto sull'albero (lato est, lato ovest, interno, esterno - Fig. 3). Nello specifico, l'aumento maggiore del contenuto di antociani si riscontra nei frutti sul lato interno dell'albero, che normalmente sono tenuti in ombra dalle foglie. Anche i frutti sul lato ovest dell'albero mostrano una colorazione significativamente aumentata grazie al trattamento. Questo aumento è probabilmente dovuto al fatto che le mele sul lato ovest della pianta sono solitamente meno esposte all’irraggiamento solare al momento della raccolta a fine ottobre.

Conclusioni e prospettive L'aumento di antociani nella buccia di mele provenienti da alberi sfogliati conferma che la sfogliatura pneumatica poco prima della raccolta, in combinazione con la potatura estiva d’illuminazione, aumenta significativamente la colorazione della buccia di
mele Rosy Glow/Pink Lady®. Ulteriori ricerche puntano ad approfondire gli effetti a lungo termine di questo trattamento sulla produttività dell’impianto e sul ciclo dei nutrienti degli alberi trattati.
Alberto Ceccon Laboratorio di Spettroscopia NMRData la sua capacità di ottenere informazioni dettagliate sulla struttura molecolare dei composti in esame, osservando il comportamento dei nuclei atomici in un campo magnetico, la spettroscopia di Risonanza Magnetica Nucleare (NMR) si è affermata in questi ultimi anni come una delle tecniche più potenti e veloci per lo studio di prodotti naturali e alimenti al fine di stabilirne l’autenticità, la tipicità e l’origine. Questo grazie alla sua capacità di risolvere spettri di miscele complesse fino ad individuare marcatori molecolari che consentano l’accertamento dell’origine del composto di interesse. Nella filiera del latte fieno (Heumilch), prodotto di spicco del settore lattiero-caseario dell'Alto Adige, gli acidi grassi ciclo-
propanici (CPFA) sono considerati importanti marcatori molecolari, in quanto sono stati individuati nel latte di bovine alimentate con insilati, ma non nel latte fieno. Di conseguenza l’ottimizzazione di metodi analitici in grado di identificare la presenza di CPFA risulta essenziale per palesare eventuali non conformità nella produzione di latte fieno e garantirne così l’autenticità.
L’impronta digitale degli acidi grassi ciclopropanici mediante NMR
La spettroscopia NMR permette di ottenere con risoluzione atomica uno spettro rappresentativo per ogni molecola. Nella Figura 1 è mostrato lo spettro 1H-NMR dell’acido diidro-
La Risonanza Magnetica Nucleare (NMR): una potente tecnologia a garanzia dell’autenticità del latte fienoFig. 3: Aumento del contenuto di antociani nelle bucce di mele da alberi trattati con la sfogliatura pneumatica in combinazione con la potatura estiva d’illuminazione in confronto a quelli non trattati.
sterculico (DHSA), uno dei due CPFA individuati nel latte derivante da insilati. Ogni segnale dello spettro può essere attribuito ad uno specifico protone (1H) che costituisce il DHSA, rendendo lo spettro 1H-NMR una vera e propria impronta digitale della mo-
lecola. Ciò che rende la classe dei CPFA importanti marcatori molecolari in NMR è la posizione caratteristica del segnale di uno dei protoni ( 1HC, riquadro rosso di Fig. 1A). Anche in matrici articolate (per esempio, nella componente grassa del latte), dove

molti segnali sono sovrapposti, la posizione del segnale di 1HC risulta univoca. Ciò nonostante, l’intensità del segnale derivante da un unico protone risulta bassa e l’individuazione rimane complessa (Fig. 1B).

Una strategia per rendere più facile l’individuazione del CPFA
L’applicazione di un semplice accorgimento tecnico chiamato “disaccoppiamento” durante l’acquisizione del segnale NMR permette di amplificare il segnale di 1Hc, aumentando il limite di rilevazione del DHSA. In Fig. 2, l’effetto del disaccoppiamento è particolarmente visibile dal confronto dei segnali corrispondenti a 1Hc del DHSA
acquisiti senza (evidenziato in nero) e con (evidenziato in rosso) disaccoppiamento. Se negli spettri acquisiti sullo standard l’introduzione del disaccoppiamento comporta un aumento del segnale di circa due volte, negli spettri acquisiti in matrice (dove il contenuto di DHSA è più basso) l’applicazione del disaccoppiamento è condizione necessaria per poter identificare il segnale del DHSA, altrimenti sotto il limite di rilevabilità.
Conclusioni e prospettive
Lo sviluppo di tecniche capaci di amplificare il segnale corrispondente ai marcatori molecolari risulta di fondamentale interesse ai fini della certificazione di prodotti alimentari. Questo studio dimostra come la spettroscopia NMR è un valido aiuto nell’autenticazione di prodotti agroalimentari dell’Alto Adige.
Il controllo dei patogeni e delle malattie nelle piante ricopre un ruolo centrale nella produzione agricola. Allo stesso tempo, i trattamenti di difesa delle piante possono avere effetti negativi sull'ambiente. Un obiettivo importante per il futuro è quello di ridurre al minimo necessario l’utilizzo di prodotti fitosanitari chimici. A tal scopo, l’individuazione precoce di una malattia, ovvero uno stato di "stress" della pianta, apporterebbe un contributo significativo. Quanto più precocemente avviene l’individuazione, tanto meno saranno necessari strumenti di difesa delle piante. In questo senso, un approccio promettente per il rilevamento precoce ed efficiente consiste nell'uso dei cosiddetti sensori iperspettrali o spettroradiometri.

Individuare precocemente lo stress dovuto a malattie delle piante
I sensori spettrali misurano le onde elettromagnetiche riflesse, ad esempio, dalle foglie. Queste onde elettromagnetiche ci sono già familiari
nella vita di tutti i giorni, come la luce visibile, le onde infrarosse, le microonde o le onde radio. Se le piante sono esposte a stress, ad esempio a causa di una malattia, può verificarsi un cambiamento nella radiazione elettromagnetica riflessa dalle foglie
Analisi spettrale delle foglie per il rilevamento di fitopatologie spiegata attraverso l'esempio degli “scopazzi del melo”Katrin Janik, Cameron Cullinan Gruppo di lavoro Genomica Funzionale Fig. 1: Raccolta dei profili spettrali delle foglie di un melo.
che si traduce in un'alterazione del profilo spettrale delle stesse. Rilevare questi cambiamenti significherebbe individuare lo stress precocemente.
Primi promettenti risultati nell'individuazione precoce di alberi affetti da “scopazzi del melo”

L’obiettivo del progetto si focalizza sull’individuazione precoce attraverso l’analisi spettrale di piante colpite dalla malattia degli “scopazzi del melo”. I risultati si sono dimostrati molto promettenti: le prove sul campo hanno, infatti, dimostrato che l’analisi spettrale può essere utilizzata per distinguere efficientemente alberi infetti da quelli sani prima ancora della comparsa di sintomi visibili. Questa tecnica avrebbe quindi molti vantaggi per la pratica agricola, risultando in un metodo rapido ed economico per individuare gli alberi malati da estirpare prima che la patologia si diffonda e prima di ricorrere a prodotti fitosanitari a contrasto degli insetti vettori della malattia
2.5.3
Conclusioni e prospettive Nonostante i primi risultati siano promettenti, è ancora necessaria molta ricerca e, soprattutto, molte misurazioni prima che il sistema possa essere applicato sul campo. L'agricoltura sta diventando sempre più complessa e il
cambiamento climatico porta con sé nuove situazioni di stress per le piante. Lo sviluppo di queste tecnologie è in grado di offrire un importante contributo per affrontare queste sfide.

La Libera Università di Bolzano è stata fondata nel 1997 con una vocazione internazionale e multilingue (tedesco, italiano, inglese e ladino). Inoltre, dispone di cinque Facoltà (nel marzo 2023, le Facoltà di Scienze e Tecnologie e di Informatica sono diventate Facoltà di Scienze e Ingegneria Agraria, Ambientale e Alimentare) con un’alta percentuale di docenti (35 %) e studenti (17 %) provenienti dall'estero che studiano, insegnano e fanno ricerca nei campi delle scienze economiche, naturali, ingegneristiche, sociali, dell’educazione, del design e delle arti. In media sono iscritti 4.100 studenti a più di 30 corsi di laurea e post-laurea.
L’offerta formativa e i progetti di ricerca sono collegati a reti internazionali e interregionali – ad esempio, nell’ambito dell’Euregio, con le Università di Innsbruck e Trento – e si orientano verso elevati standard qualitativi. L’insegnamento e la ricerca sono organizzati all’interno di cinque facoltà e sette centri di competenza.
2.6
Poiché il Rapporto Agricoltura e Foreste si riferisce all'anno 2022, il nome della facoltà è stato mantenuto. A partire dal 2023 sarà la Facoltà di Scienze Agrarie, Ambientali e Alimentari a riferire qui. La sostenibilità e l'interdisciplinarità nella facoltà di Scienze e Tecnologie rappresentano il punto di partenza per la soluzione di problemi complessi che riguardano lo sfruttamento dei territori di montagna, il settore dell’efficienza energetica, la produzione alimentare e il controllo di qualità degli alimenti, le innovazioni di processo e prodotto per l’industria. Il focus della ricerca della facoltà si colloca nei settori dell’efficienza energe-
La Facoltà di Scienze e Tecnologie
tica, dell’innovazione nel settore della produzione primaria ed industriale, dell’automazione, delle tecnologie alpine e delle scienze e tecnologie alimentari. Le attività di ricerca sono di base e in parte orientato all'applicazione. Molti progetti sono realizzati insieme alla Provincia Autonoma di Bolzano e ai partner industriali per l’applicabilità pratica degli stessi. Di seguito si presentano alcuni esempi.
La facoltà dispone complessivamente di 16 laboratori in cui un team formato da giovani ricercatori affronta tematiche strategiche, con particolare attenzione alla realtà altoatesina.
La Facoltà di Scienza e Tecnologia in cifre:
• 5 Corsi di laurea di primo livello

• 6 Master
• 4 programmi di dottorato
• Oltre 300 studenti
• 34 professori
• 38 ricercatori
• 49 progetti di ricerca attivi con un volume totale di 7,0 milioni di euro
2.6
PIWI)
E. Boselli1,2, E. Longo1,2, A. Ceci1,2, G. Duley1,2, G. Windisch1,2, F. Viganò3, A. Piccoli3, S. Cesco2, G. Orzes4
1) Oenolab unibz, NOI TechPark Alto Adige/Südtirol, 2) Facoltà di Scienze Agrarie, Ambientali ed Alimentari unibz, 3) Facoltà di Scienze della Formazione unibz, 4) Facoltà di Ingegneria e Centro di Competenza sulla Salute delle Piante unibz
le risorse e promuovere il benessere dei lavoratori e delle comunità:
1. Gestione del vigneto: La gestione sostenibile del vigneto permette di ridurre al minimo l'uso di prodotti chimici e pesticidi, i consumi idrici, di ridurre il passaggio di mezzi agricoli (e, di conseguenza, il consumo di carburante), e promuove la fertilità del suolo, la salute della fauna e della flora del vigneto.
2. Tutela della salute: il ridotto utilizzo di prodotti chimici di sintesi permette di ottenere un elevato livello di tutela della salute dei lavoratori, consentendo anche alle lavoratrici in stato interessante di accedere al vigneto senza danni alla salute.
3. Efficienza energetica: l’azienda può ridurre la loro impronta di carbonio attuando pratiche di efficienza energetica, come l'utilizzo di fonti di energia rinnovabili, l'investimento in attrezzature ad alta efficienza energetica e il miglioramento dell'isolamento termico.

4. Riduzione dei consumi dell'acqua: è possibile ridurre al minimo il consumo idrico attraverso l'irrigazione a goccia, la raccolta dell'acqua piovana e il riciclo delle acque reflue.
sostenendo le comunità locali e promuovendo la diversità e l'inclusione; in questo modello rientra la promozione del consumo consapevole e critico, attraverso l’educazione dei consumatori a distinguere tra un prodotto a basso impatto ed uno ad alto impatto.
7. Tutela della biodiversità: la coltivazione sostenibile promuove la presenza di una vegetazione multi specie che attira e nutre insetti impollinatori ed altri organismi.
Uno degli approcci proposti è quello di espandere l'uso di cultivar di uve ibride resistenti alle malattie (uve "PIWI") e di introdurre nuove varietà resistenti, che possono contribuire all'attuazione della politica del Green Deal europeo 2050. Le varietà PIWI sono state quindi autorizzate nel 2021 per i vini a denominazione di origine, dando vita a una prospettiva completamente nuova nella produzione di vini di qualità (Regolamento (UE) 2021/2117).
La strategia per la sostenibilità nel settore vitivinicolo dell'Unione Europea si basa su un insieme di pratiche che mirano a ridurre al minimo l'impatto negativo delle produzioni sull'ambiente e sulla sostenibilità sociale ed economica. Per raggiungere l’obiettivo di una produzione vitivinicola sostenibile si può adottare una serie di strategie volte a ridurre gli sprechi, conservare
5. Packaging e spedizione: le aziende vinicole sostenibili mirano a ridurre l'impatto ambientale della logistica utilizzando materiali riciclati, riducendo al minimo i rifiuti da imballaggio e le emissioni da trasporto.
6. Responsabilità sociale: le aziende vitivinicole sostenibili danno priorità anche alla responsabilità sociale, trattando i lavoratori in modo equo,
Le varietà resistenti consentono di ridurre fortemente il numero di trattamenti con agrofarmaci nel vigneto e quindi possono limitare le conseguenze negative dirette (minore esposizione dei lavoratori a sostanze nocive) ed indirette di tali trattamenti (migliore sicurezza sul lavoro grazie ad una minore manodopera nei vigneti); minore compattamento del suolo nel vigneto; salvaguardia della flora e fauna del vigneto (che aiutano a mantenere il suo fertile e le vigne in buona salute), impatti positivi sul turismo responsabile e sulle attività limitrofe, in particolare nel contesto della viticoltura
2.6.1 Progetto SUWIR: il potenziale enologico e di sostenibilità dei vini prodotti da cultivar resistenti alle malattie (viniFigura 1: attività del progetto SUWIR.
urbana e periurbana tipiche dell’Alto Adige. Tuttavia, le caratteristiche dei vini da uve resistenti sono diverse rispetto a quelli convenzionali, il che rende necessario apportare modifiche alle pratiche di vinificazione per mantenere un'elevata qualità. L'enologo deve tenere conto degli elevati valori sia dell’acidità titolabile, che dell'acido malico, del pH e dell’azoto assimilabile, oltre che delle proteine e dei polisaccaridi, e dei bassi livelli di tannini che caratterizzano i vini PIWI:
ciò può renderli vulnerabili all’attacco microbico, oltre a ridurre il carattere astringente. In alcuni casi è possibile pensare ad una vendemmia scalare della stessa varietà ed a fermentazioni separate, per poi comporre il vino nella fase immediatamente successiva. Il progetto interdisciplinare SUWIR di unibz ha l’obiettivo di produrre un case test su diversi gruppi target: produttori, rivenditori e acquirenti, operatori del settore turistico e consumatori, per sviluppare un modello

2.6.2
Produzione di ingredienti alimentari con tecnologie innovative
G. Ferrentino, K. Morozova e M. ScampicchioFacoltà di Scienze Agrarie, Ambientali ed Alimentari, Gruppo di lavoro: Tecnologia alimentare
natura e, quindi nella nostra dieta quotidiana, aventi effetto benefico sulla salute umana e con importanti funzioni nutrizionali e fisiologiche. Esse, infatti, sono definite anche sostanze nutraceutiche. Queste sostanze comprendono vitamine, oli essenziali, polifenoli e altri composti vegetali secondari che influenzano il metabolismo umano. Ad esempio, gli alcaloidi, come la teobromina dei semi di cacao o la caffeina dei semi di caffè, possono aumentare l'attività metabolica ed essere utilizzati per ridurre l'assunzione di cibo, in quanto possono aumentare il senso di sazietà. Le vitamine e i polifenoli, invece, sono noti per i loro effetti antiossidanti.
che identifichi e valorizzi vantaggi ambientali, sociali e le peculiarità qualitative che caratterizzano i vini ottenuti da varietà di uve resistenti.
Ingredienti alimentari costituiti da composti bioattivi sono, come suggerisce il nome, sostanze presenti in
Tuttavia, i composti bioattivi sono sensibili all'ossidazione e devono essere protetti per mantenere le loro caratteristiche nutrizionali a lungo
tempo. Per questo motivo, vengono incapsulati e quindi protetti da condizioni sfavorevoli come luce, umidità e ossigeno. Nell'industria alimentare, tecniche che hanno come scopo quello di incapsulare e proteggere un principio attivo sono state sviluppate con l´obiettivo principale di stabilizzare il rilascio di composti volatili (aromi). In seguito, queste tecniche sono state applicate per incapsulare sali minerali, ingredienti per la cottura, oppure per stabilizzare vitamine e altri integratori alimentari. Oggi esiste una vasta gamma di ingredienti alimentari sviluppati in questo settore nati per soddisfare le esigenze dei consumatori sempre più attenti alla salute e che richiedono prodotti alimentari con particolari proprietà funzionali e salutistiche. In linea di principio, esistono diverse tecniche per incapsulare le sostanze
bioattive: lo spray drying, la liofilizzazione, la coacervazione, l'estrusione o la nanoemulsione sono alcuni esempi. Tuttavia, a seconda dell'applicazione e delle proprietà chimiche e fisiche degli ingredienti e degli eccipienti, ogni tecnologia presentai vantaggi e svantaggi in termini di caratteristiche di prodotto finale.
Una tecnica per incapsulare composti bioattivi particolarmente interessante è la tecnologia PGSS (Particles from Gas Saturated Solutions). Essa prevede l'utilizzo di anidride carbonica supercritica (CO2) (vedi figura 1). In questo processo, un composto bioattivo viene miscelato con un materiale di supporto e caricato in un reattore riscaldato e resistente alla pressione. La miscela viene, quindi, sciolta in condizioni di alte pressioni ed in presenza di anidride carbonica supercritica. I materiali di supporto adatti per questo processo includono lipidi, acidi grassi, grassi solidi, monogliceridi, cere o fosfolipidi. Lavorando ad una temperatura di 31,1°C e pressione di 73,8 bar, l'anidride carbonica nel reattore cambia il suo stato di aggregazione e passa allo stato supercritico. In questo stato, acquisisce proprietà intermedie tra quelle di un liquido e quelle di un gas. Le condizioni di processo all´interno del reattore vengono quindi regolate in modo da raggiungere la pressione e la temperatura de-


siderate. Dopo la fase di saturazione con l´anidride carbonica supercritica, la miscela costituita dal composto bioattivo e dal materiale di supporto viene depressurizzata passando in una camera di atomizzazione attraverso un ugello. La riduzione della pressione dalle condizioni supercritiche a quella ambiente provoca un forte effetto di raffreddamento che fa solidificare la miscela formando particelle solide mentre l'anidride carbonica viene allontanata dalla miscela in fase gassosa.
Il grande vantaggio di questa tecnica è che l'anidride carbonica supercritica, grazie alle sue proprietà chimico-fisiche, si presta in modo ottimale all'incapsulamento di sostanze simili ai grassi, rendendo superfluo l'uso di solventi organici tossici. Ciò comporta il vantaggio che il prodotto finale non richiede ulteriori fasi di purificazione per rimuovere solventi indesiderati. Il processo risulta, quindi, privo di residui tossici ed il materiale prodotto è già disponibile in forma di polvere. Un altro vantaggio è rappresentato dalle condizioni di processo miti costituite da una temperatura di poco superiore a quella ambiente. Queste condizioni di processo sono particolarmente vantaggiose se si processano molecole sensibili al calore, come le vitamine o i grassi insaturi, che hanno così una maggiore durata di conservazione.
Inoltre, il processo è molto semplice e consente di regolare le proprietà finali delle particelle cambiando le condizioni di pressione e temperatura dell´anidride carbonica. Ciò è molto importante in termini di applicazione finale e di efficacia degli ingredienti incapsulati.
Oltre a proteggere gli ingredienti incapsulati, la tecnica offre di per sé molti altri vantaggi. Da un lato, è possibile mascherare un sapore indesiderato attraverso il materiale di supporto o regolare la solubilità dell´ingrediente prodotto in base all'applicazione finale. Un aspetto ancora più importante è il controllo della biodisponibilità, l'aumento della bioattività e il rilascio controllato della sostanza bioattiva, che possono essere controllati tramite l'incapsulamento. Infine, gli ingredienti che consumiamo con il cibo devono essere assorbiti dal nostro organismo per poter esplicare il loro effetto positivo. Questo l´ulteriore aspetto rende le tecniche per incapsulare di grande interesse industriale.
H. A. Gamper1), F. Mairhofer2), M. Gauly1), G. Peratoner2)
1) Facoltà di Scienze Agrarie, Ambientali ed Alimentari unibz, gruppo di lavoro: Foraggicoltura e seminativi; 2) Centro di Sperimentazione Laimburg, gruppo di lavoro: Agricoltura Montana
Per quanto riguarda l'insediamento e la resa nel primo anno di raccolta, questi risultati preliminari suggeriscono che nelle condizioni del presente studio sia sufficiente testare le varietà di trifoglio violetto in un solo miscuglio, nonostante grandi differenze della percentuale di trifoglio violet-
to nei diversi miscugli (KG: 27,3%, IR: 13,3% e WW: 5,0%). – Resta da chiarire con ulteriori analisi dei dati e prove in campo se i risultati dello studio siano validi per l'intera durata del periodo di coltivazione e se risultino simili anche in altre condizioni di suolo, clima e nutrienti.
A questa conclusione hanno portato i risultati del progetto Leg4Mix, finanziato da unibz e condotto in collaborazione con il Centro di Sperimentazione Laimburg, in una prova in campo presso l’azienda sperimentale Mair am Hof a Teodone, sul tema della selezione combinata di miscugli di semente e cultivar. Le varietà di trifoglio violetto Milvus, Semperina e Spurt sono state confrontate in diversi miscugli leguminose e graminacee (IR, KG e WW) per verificarne l'idoneità in termini di produzione foraggio e proteina grezza. Nella prova concimata con 40 kg/ha di azoto in forma di nitrato di ammonio e 2 x 15 m3/ha di liquame da biogas, l'azoto fissazione simbiotica ha contribuito al 56,7 1,1% della resa totale di proteina grezza al terzo taglio nel primo anno di coltivazione, come dimostrato da una stima approssimativa dell’abbondanza naturale di d15N nella frazione del trifoglio violetto e del trifoglio bianco rispetto all’abbondanza di d15N nella frazione delle graminacee.
Il miscuglio di trifogli e graminacee KG è stata la più produttiva grazie all'elevato contributo del trifoglio violetto (Fig. 1A). La cultivar di trifoglio violetto Spurt ha prodotto la quantità più elevata di proteina grezza (Fig. 1B).


2.6.3 Intensivo ma sostenibile: le cultivar di trifoglio violetto e i miscugli per prati avvicendati influenzano la resa e la proteina grezzaA) B) Fig. 1. Resa in sostanza secca e proteina grezza del terzo taglio di tre miscugli di leguminose e graminacee per prati avvicendati nel primo anno di raccolta all'inizio di agosto 2021. (A) Effetto dei miscugli (B) effetto delle cultivar di trifoglio violetto, studiati mediante un disegno a blocchi randomizzati completi presso l’azienda sperimentale Mair am Hof a Teodone. Percentuali di trifoglio violetto nei miscugli impiegati: KG: 27,3%, IR: 13,3% e WW: 5,0%. * Graminacee: Loietto, Erba mazzolina, Coda di topo e Festuca dei prati 2.6.3
Prova varietale di trifoglio violetto in miscugli di leguminose e graminacee in un disegno a blocchi randomizzati completi presso l’azienda sperimentale Mair am Hof a Teodone, agosto 2021
Raccolta mediante raccoglitrice parcellare di foraggio per determinare la resa di vari miscugli di leguminose e graminacee presso l’azienda sperimentale Mair am Hof a Teodone, agosto 2021

Spiegazione della determinazione della resa dei pascoli a erba corta da parte del dott. Giovanni Peratoner, responsabile della sezione agricoltura di montagna del Centro Sperimentale Laimburg, in occasione del convegno sui pascoli di Bioland Alto Adige presso l’azienda sperimentale Mair am Hof a Teodone, settembre 2021



La tendenza attuale e le proiezioni climatiche indicano che nel prossimo futuro assisteremo ad un aumento dell’intensità e della frequenza degli eventi climatici estremi, incluse le ondate di calore. Pur esistendo diversi metodi per indentificare le ondate di calore, le possiamo definire come periodi della durata di almeno 3-5 giorni, in cui la temperatura giornaliera supera il 90 o o il 95o percentile delle temperature di riferimento del periodo. Anche nei nostri ambienti di coltivazione, soprattutto nei mesi di luglio
ed agosto, le temperature massime durante le ondate di calore superano per diversi giorni i 35oC, con picchi prossimi ai 40 oC. Da una nostra recente analisi della serie storica dei dati meteorologici estivi (giugno-agosto) raccolti presso la stazione di Laimburg tra il 1986 e il 2022, emerge chiaramente come prima del 2000 le ondate di calore fossero eventi assai rari (solo una nel 1996) mentre la frequenza aumenta a partire dall´anno 2000 e continua nell’ultimo decennio (Figura 1). Se escludiamo l’eccezionale annata 2003, in cui in estate si è verificata un’ondata di calore ad agosto di ben 11 giorni e con temperature massime di circa 39 oC, ben 16 eventi (su un totale di 23) si sono infatti verificati a partire dal 2010. Sia nel 2019 che nel 2022 si sono verificati due eventi di lunga durata (7-8 giorni) con picchi di temperatura massima tra 38 e 39 °C. Gli ecosistemi terrestri, incluse le colture agrarie, risentono negativamente delle ondate di calore, in quanto la vegetazione esposta a temperature eccessivamente elevate tende a diminuire il tasso di fotosintesi netta e la produzione di biomassa, mentre i flussi di evapotraspirazione possono aumentare o diminuire in funzione della disponibilità di acqua nel suolo. Spesso, le alte temperature estive sono accompagnate anche da perio-
di di scarsa piovosità, generando così uno stress multiplo per le piante, di natura termica e idrica, che influenza negativamente la produttività sia degli ecosistemi naturali che delle colture agrarie non irrigate. In una nostra recente ricerca, pubblicata su European Journal of Agronomy (2022), abbiamo cercato di chiarire se e in quale misura, la coltura del melo risponde alle ondate di calore quando questa viene regolarmente irrigata considerando due possibili ipotesi. La prima ipotesi prevede la chiusura degli stomi ed il conseguente calo della fotosintesi associato ad un aumento della temperatura delle foglie. In alternativa (seconda ipotesi) la pianta mantiene gli stomi aperti aumentando i flussi traspirativi. Da altri studi condotti in climi più caldi, sappiamo che nel melo la fotosintesi netta dovrebbe raggiunge il suo massimo intorno ai 25–30 °C, mentre l’apparato fotosintetico viene gravemente compromesso se si verificano temperature superiori a 40 oC. Le alte temperature estive accompagnate da elevata radiazione solare causano anche altri effetti che preoccupano i coltivatori, come ad esempio scottature e necrosi della buccia ed un decadimento della qualità delle mele.
La nostra analisi è partita dai valori di temperatura massima giornaliera in estate, che sono stati messi in relazione ai flussi di evapotraspirazione (ET)

2.6.4 Effetto delle ondate di calore estive sul consumo idrico e sulla capacità fotosintetica del meloD. Zanotelli, T. Callesen, C. Andreotti, L. Montagnani e M. Tagliavini Facoltà di Scienze agrarie, ambientali e alimentari, gruppo di lavoro: Ecofisiologia ed Ecosistemi Arborei Fig. 1. Frequenza, intensità e durata delle ondate di calore estive tra il 1985 e il 2022, ottenute dall´analisi dei dati della stazione meteorologica del Centro di Sperimentazione di Laimburg. Ogni barra, o frazione di essa, indica un’ondata di calore; la sua altezza rappresenta il numero di giorni che la caratterizza; l’intensità del colore indica la media delle temperature massime registrate durante l’ondata di calore. 2.6.4
ed alla capacità del meleto di fissare CO2 tramite la fotosintesi (produzione primaria lorda, GPP). GPP ed ET sono stati misurati attraverso la tecnica micro-meteorologica detta “eddy covariance” durante un arco temporale di sei anni (2013-2018) in un meleto nella fase di piena produzione (cv. Fuji) situato nella bassa atesina. Come emerge dalla figura 2, le perdite idriche da parte del meleto crescono all’aumentare delle temperature massime giornaliere, con un’intensità di circa 0.17 mm per ogni grado di aumento della temperatura massima. In genere, abbiamo registrato i massimi valori di ET sempre durante le ondate di calore. In sintesi, se irrigato, il meleto reagisce alle ondate di calore estive (alle temperature registrate finora), aumentando la traspirazione e riuscendo così a garantire la funzionalità fisiologica e la termoregolazione della chioma.
Se la riposta in termini di evapotraspirazione è risultata chiara in tutti gli anni, il calo della fotosintesi (GPP) nei periodi più caldi (Figura 3 b) non è invece risultato molto marcato quando abbiamo esaminato insieme l’intera serie di dati. Tuttavia, gli effetti delle ondate di calore sulla la fotosintesi (GPP) sono stati osservati nei due anni più caldi della serie analizzata (il 2013 ed il 2015), quando all’aumentare delle Tmax, la fotosintesi ha mostrato un calo statisticamente significativo (circa 7 kg di CO2 per ettaro in meno al giorno per ogni grado di aumento di temperatura massima, approssimabile ad un calo di circa il 2,5% di GPP per ogni aumento di grado centigrado al giorno (equivalente a circa 15 kg di biomassa fresca prodotta in meno ad ettaro al giorno).
In conclusione, se le ondate di calore causano un aumento delle perdite idri-
che, sia che esse causino o meno anche una riduzione della fotosintesi, ciò si traduce in un calo dell'efficienza di utilizzo dell'acqua del meleto durante i periodi estivi eccezionalmente caldi. Servirà quindi più acqua per produrre la stessa biomassa da parte degli alberi di melo e delle altre specie vegetali presenti nel meleto. Il nostro studio è terminato nel 2018 e la strumentazione per le misure è stata trasferita in un vigneto nel comune di Caldaro. Non ci è stato quindi possibile studiare gli effetti delle due eccezionali ondate di calore verificatesi nel 2019 e nel 2022 (Fig. 1). Se e in che misura le ampie aree dedicate ai meleti irrigati possano esercitare un ruolo di mitigazione diretta sulle temperature estreme del clima locale proprio grazie alla traspirazione delle foglie, come dimostrato per altri contesti, merita ulteriori indagini.

I. Poulopoulou1, M. J. Horgan2, B. Siewert2, M. Siller3, L. Palmieri3, E. Martinidou3, S. Martens3, P. Fusani4, V. Temml5, H. Stuppner2, M. Gauly1 1Facoltà di Scienze agrarie, ambientali e alimentari, Gruppo di lavoro: Zootecnica, 2Istituto di Farmacia/Farmacognosia, Università di Innsbruck, 3Centro di ricerca e innovazione, Fondazione Edmund Mach, 4Consiglio Per La Ricerca in Agricoltura E L’analisi Dell’economia Agraria, Centro Di Ricerca Foreste E Legno, 5 Istituto
di Farmacia, Dipartimento di Chimica Farmaceutica e Medicinale, Università Medica Paracelso di Salisburgo
Gli strongili gastrointestinali (MDS) sono parassiti comuni negli allevamenti. Le infezioni sono inevitabili negli animali allevati all'aperto e a terra, poiché entrano in contatto diretto con i loro escrementi. Gli animali infestati vengono solitamente trattati
2.6.5
Le piante alpine come strumento per promuovere le prestazioni e la salute delle galline ovaioleFig. 2. Flussi di evapotraspirazione (ETa) e produzione primaria lorda (GPP, che riflette la fotosintesi netta della vegetazione) giornaliera del meleto misurati nei giorni senza pioggia dei mesi estivi di sei anni consecutivi (2013-2018) e mostrati per gruppi di 1°C di temperatura massima. Il box racchiude il 50 % dei dati, le barre rappresentano il quartile inferiore e quello superiore mentre i punti sono outliers.
con antielmintici sintetici, che rischiano di sviluppare resistenza a causa di programmi di trattamento impropri e di un uso eccessivo. Per questo motivo, lo studio presentato ha analizzato l'azione antielmintica (AH) delle erbe della regione alpina. A questo scopo, nove estratti di erbe sono stati o sono in corso di selezione per il progetto HERBAL e sono stati testati in vitro e in vivo (progetto in corso). Le piante selezionate sono Achillea millefolium (AM), Artemisia absinthium (AA), Artemisia vulgaris (AV), Cicerbita alpina (CA), Cichorium intybus (CI), Inula helenium (IH), Origanum vulgare (OV), Tanacetum vulgare (TV), Tanacetum parthenium (TP). Sono state prima testate in vitro a diverse concentrazioni sulle uova del parassita Ascaridia galli e il loro effetto è stato confrontato con quello dell'antielmintico flubendazolo. I risultati hanno mostrato che le piante CA, TV e IH hanno ottenuto i migliori risultati (Tabella 1).
È stato inoltre analizzato se gli estratti influenzano anche le caratteristiche di produzione, ad esempio l'assunzione di mangime e il numero di uova deposte dalle galline ovaiole, e specifici parametri sanitari. I primi risultati mo-
strano che le galline ovaiole che hanno ricevuto la TV mangiavano di più (Figura 1). Inoltre, gli estratti hanno influenzato anche diversi parametri ematici (Tabella 2).
SE) nelle settimane di prova. I diversi apici indicano differenze statistiche (P < 0,05) tra le settimane di prova dello stesso campione.

montagna
F. Mazzetto, L. Becce, G. Carabin, A. MandlerFacoltà di Scienze agrarie, ambientali e alimentari, Gruppo di lavoro: Tecnologia agricola
(semina e raccolta); b) post-raccolta e conservazione della granella direttamente al maso; c) trasformazione, con micro-linee di panificazione. Il tutto, seguendo approcci che hanno portato a valutazioni integrate capaci di tenere contestualmente conto di prestazioni economiche e operative, condizioni di sicurezza per gli operatori, controllo dei fenomeni erosivi e salvaguardia del paesaggio, livelli di sostenibilitá dell’intera filiera.
Il progetto, coordinato da unibz, e´stato svolto anche in collaborazione con imprese private che hanno contribuito alla realizzazione e prova dei prototipi (Geier, Marlengo; Neuero Italiana, Merano; Taser Alm, Scenna), nonché con Fraunhofer Italia che ha poi supportato le analisi integrate di filiera.
transitabilità; b) necessitá di limitare la biomassa raccolta per semplificare le operazioni logistiche, nonché la transitabilità dei mezzi in pendio; c) gestire frequenti situazioni di colture allettate; d) limitare l´impiego di manodopera in raccolta, possibilmente evitando di dover gestire manualmente singoli covoni (es. mietilegatrici). La testata é costituita da un rotore con otto ranghi di pettini “stripper” per l´asportazione delle spighe/infiorescenze apicali, avvolto in un apposito “carter” in cui alloggia anche un sistema di convogliamento verso un sistema di carico, dotato di un sollevatore a tazze per il deposito del prodotto raccolto in un serbatoio metallico, ribaltabile idraulicamente per le successive operazioni di scarico.
Il progetto BROTWEG, finanziato col programma EFRE/FESR 2014-2020, e´stato realizzato con l´obbiettivo di sviluppare innovazioni radicali e incrementali per la coltivazione dei cereali in contesti estremi di montagna. In particolare, si è operato su pendenze molto elevate (anche oltre 80%), in cui la coltivazione dei cereali fino ad oggi risultava preclusa a ogni forma di meccanizzazione, con conseguenti abbandoni per le elevate richieste di manodopera.
La necessitá di individuare nuovi modelli di sviluppo per l’agricoltura montana, integrativi a quelli zootecnici oggi prevalenti, ha rimesso in primo piano l’alternativa della “filiera cerealicola” (cereale-farina-pane), rispetto alla “filiera casearia” (fieno-latte-formaggio) per i notevoli vantaggi che la prima comporta in termini di riduzione di manodopera e carichi di lavoro annuali, investimenti e impatti ambientali. Tuttavia, l´attuazione della filiera cerealicola richiedeva la preventiva soluzione dei principali ostacoli all’adozione di idonee soluzioni tecnologiche per la meccanizzazione di campo e la conservazione/gestione nei piccoli masi.
Il progetto Brotweg ha, quindi, previsto lo sviluppo di prototipi da adibire ad attivitá di: a) coltivazione, con nuove macchine idonee per le pendenze elevate nelle operazioni piu´ critiche
La meccanizzazione di campo è stata impostata sull´allestimento di un trattore portattrezzi cingolato giá munito di trazione a cavo (tramite verricello a bordo) per consentire transiti e lavorabilità anche nelle condizioni piú estreme. La realizzazione dei prototipi ha poi riguardato:
1. Una seminatrice per sod-seeding, necessaria ad evitare le arature per il rischio di fenomeni di erosione dei suoli; è dotata di due serbatoi, rispettivamente per sementi e concime organico (granulare o pellettato), indipendenti ed ermeticamente chiusi per bloccare le fuoriuscite di prodotto su pendenze estreme; la deposizione del seme viene effettuata tramite distribuzione pneumatica che contribuisce anch´essa a contenere le perdite di prodotto sui pendii, garantendo nel contempo una maggiore regolarità di distribuzione; nel caso di interventi su prati permanenti, il lavoro della seminatrice puo´ essere combinato con un erpice rotante, che facilita l´arieggiamento del terreno senza tuttavia compromettere la vitalitá del prato nei cicli colturali successivi e i rischi erosivi.
2. Una testata di raccolta ”a strappo” (stripper), per realizzare una raccolta limitata alla sola parte apicale della pianta con le infiorescenze a seme. I principi operativi alla base di tale idea hanno trovato fondamento nei seguenti aspetti: a) impossibilità di accedere in zone montane con mietitrebbie convenzionali, per problemi di ingombro, accessibilità,
Le tecnologie di post-raccolta, dal canto loro, hanno riguardato tutto l´insieme di macchine e impianti deputati alla gestione delle operazioni comprese tra la raccolta e il trasporto dai campi della granella al suo prelievo per la molitura (trebbiatrice a punto fisso, sistema di pulitura e decorticazione, essiccatoio continuo a nastro, sili verticali a sezione rettangolare, dedicati alla conservazione a lungo termine del prodotto e muniti di sistema di aereazione per garantirne ottimali condizioni igienico-sanitarie).
In tal caso, la versa sfida è stata quella di riuscire ad allestire l´intero sistema all´interno della vecchia struttura di un fienile giá esistente, in modo da non lasciare nulla di esposto all´esterno dell´edificio per non alterare le caratteristiche architettoniche preesistenti, nonche´ per non creare impatti visuali negativi sul paesaggio.
Le prove di campo condotte durante due stagioni di raccolta hanno evidenziato: a) rese di granella soddisfacenti, nonostante frequenti condizioni climatiche avverse, e pari a 3,2-4,1 t/ ha per avena e segale, e a 2,2-2,4 t/ha per orzo e farro; b) perdite di raccolta accettabili (benché perfezionabili) e pari al 7-25% della produzione primaria; c) tempi di lavoro pari a 6-8 e 7-10 ore/ha, rispettivamente per le attivitá di semina e raccolta, con consumi di gasolio di 50-62 e 90-98 l/ha, variabili in funzione della pendenza.
In conclusione, la filiera cerealicola –pur con dei limiti oggettivi – si dimostra un valido modello alternativo per conseguire miglioramenti dei livelli di
2.6.6 Brotweg: la via del pane in ambienti alpini. Nuove soluzioni meccanizzate per la filiera cerealicola in alta
reddito agrario anche nelle zone montane piu´ critiche. Il principale rischio rimane la possibilitá di condizioni meteo-climatiche avverse che, specie sopra i 1000 m di altitudine, potrebbero
comportare la necessitá di risemine primaverili con conseguenti riduzioni di resa e aggravio dei costi. Il progetto, tuttavia, ha offerto in modo inedito numerose risposte e soluzioni ai
numerosi problemi tecnologici (specie in relazione alla meccanizzazione di campo) che sempre hanno bloccato ogni forma cerealicola montana.




2.6.7 Rigenerazione forestale nella pecceta e nelle sue
aree soggette alla tempesta
Vaia al Passo di Lavazè
C. Wellstein e G. S. Giberti
Facoltà di scienze e agrarie, ambientali e alimentari, Gruppo di lavoro Gestione della vegetazione e del paesaggio
Il progetto MoniVa
Il progetto MoniVa (Monitoring of areas affected by storm Vaia; Comiti et al. 2023), presentato in questo numero della Relazione agraria e forestale, nasce dalla collaborazione tra il Dipartimento Foreste e la Libera Università di Bolzano e include tra i suoi obiettivi anche il monitoraggio della vegetazione delle aree danneggiate dalla tempesta. In questo articolo vogliamo riportare i primi risultati del monitoraggio della rigenerazione naturale nella foresta subalpina di abete rosso nelle aree danneggiate, confrontandoli con quelli della foresta intatta. Per noi era importante capire quali specie arboree contribuiscono alla rigenerazione naturale, se questa differisce in diverse strutture forestali associate a diverse gestioni e quale ruolo gioca il substrato.
L‘esperimento
Nel lavoro qui presentato, la rigenerazione naturale nelle aree interessate dalla tempesta e nella foresta intatta è stata studiata 2,5 anni dopo la tempesta Vaia dell'autunno 2018. Nella prima tipologia di gestione, tutto il legno morto è stato lasciato dopo l'abbattimento causato dalla tempesta, nella seconda tipologia, i tronchi del legno morto sono stati eliminati e sono stati lasciati i ceppi, mentre nella terza tipologia non si è verificato alcun abbattimento causato dalla tempesta (Fig. 1).
Abbiamo testato l'ipotesi che queste diverse varianti di gestione potessero
influenzare la rigenerazione naturale di piantine e giovani alberi delle specie arboree più comuni. Come seconda domanda di ricerca, abbiamo analizzato come la rigenerazione di piantine differisca nei diversi micrositi (Fig. 2). I micrositi comprendono suolo minerale, lettiera, legno morto, muschi e altra vegetazione. È stato incluso un ulteriore tipo di strutture forestali esistenti, in cui le specie arboree (principalmente abete rosso e larice misto) sono state piantate dopo la tempesta Vaia o dopo eventi temporaleschi precedenti (nel 2001 e nel 2003). Le parcelle di studio sono situate sullo stesso versante con esposizione a est a 1650-1800 m s.l.m. In ogni tipologia di gestione (sito) sono state distribuite in modo casuale 8 parcelle di studio circolari con un raggio di 5 metri. In ognuna di queste parcelle è stata registrata la rigenerazione di tutte le specie arboree con un DBH inferiore a 5 cm; le piante fino a un'età di 2 anni sono state indicate come piantine, quelle più vecchie come giovani. Tutte le piantine registrate in questo disegno sperimentale sono emerse cronologicamente dopo l'evento Vaia, mentre le piante giovani erano già presenti prima della tempesta. Per rispondere alle nostre domande di ricerca sono stati analizzati i dati di due tesi di laurea (Delaiti 2022, Santuari 2022).
Risultati
Nel complesso, l'abete rosso (Picea abies) ha rappresentato il 95% di tutte le piantine osservate nelle parcelle di studio e il sorbo (Sorbus aucuparia) il 5%. Altre specie arboree, come il larice (Larix decidua) o il pino cembro (Pinus cembra), erano presenti solo sporadicamente e non sono state quindi oggetto dell'analisi statistica presentata di seguito. Nella rigenerazione naturale, c'erano significativamente più piantine di abete rosso nella foresta intatta (media di 0.5 individui/m²) rispetto alle aree danneggiate dalla tempesta, indipendentemente dal fatto che il legno morto fosse stato rimosso (0 individui/m²) o meno (0.005 individui/m²)
(Tukey post-hoc test dopo ANVOA: F=50.73, p <0.0001). Non ci sono state differenze significative per le piantine di sorbo (0.02 individui/m²). Per quanto riguarda la presenza di piante nello stadio giovanile, il sorbo risulta avere più individui nella foresta intatta (0.8 individui/m²) e differisce significativa-
mente rispetto alle parcelle ripulite da legno morto (0.003 individui/m²), mentre la rigenerazione nelle parcelle non ripulite è stata intermedia (0.05 individui/m²) (Tukey post-hoc test dopo ANOVA: F=3.739, p <0.05). Non sono state riscontrate differenze significative per le giovani piante di abete rosso (0.1 individui/m²). Per le piantine di abete rosso e di sorbo, la lettiera è stata il microsito più importante (Fig. 2). In questo substrato è stato trovato l'70% delle piantine di abete rosso e l'86% delle piantine di sorbo. La lettiera del microsito differiva significativamente da tutti gli altri substrati, ossia suolo minerale, legno morto, muschio, vegetazione erbacea, per quanto riguarda il numero di piantine (Tukey post-hoc test dopo ANOVA: F=4.841, p<0.001). Nella foresta intatta, lo strato di lettiera aveva una superficie media del 30%, nelle altre varianti di gestione dall'1 al 6%.
Discussione
Innanzitutto, va notato che il legno morto causato da Vaia aveva solo 2.5 anni al momento dello studio e non era ancora in uno stadio di decomposizione avanzato. Per questo, non presentava ancora le caratteristiche positive tipiche del legno in avanzato stadio di decomposizione come substrato idoneo alla germinazione degli alberi. D'altra parte, i nostri risultati hanno mostrato chiaramente che lo strato di lettiera tipico delle foreste di abete rosso ha un effetto positivo sulla rigenerazione naturale. Infatti, la competizione dello strato erbaceo e arbustivo risulta essere uno dei fattori più importanti che influenzano negativamente la rigenerazione naturale delle specie arboree. In generale, è soprattutto la presenza di alberi da seme a determinare la presenza di semi e quindi la possibile rigenerazione. Ciò è particolarmente vero per specie come l'abete rosso, che si diffondono grazie al vento, ma anche per il sorbo, che, pur essendo endozoocoro, non si diffonde troppo. Il sorbo può anche formare banche di semi persistenti a breve termine nel terreno. L'abete rosso ha una banca di semi più transitoria e germoglia presto. Un altro fattore importante che influenza la rigenerazione è la brucatura da parte degli animali selvatici. In questo caso, abbiamo osservato soprattutto danni al sorbo al Passo Lavazè.
I nostri risultati suggeriscono che la rigenerazione naturale dell'abete rosso nella foresta intatta produce una quantità significativa di piantine e che il numero di piantine nelle aree aperte è drasticamente ridotto. La lettiera come substrato è stata particolarmente importante per l'esistenza di piantine della principale specie arborea di abete rosso in tutte le varianti di gestione. Nelle aree aperte, la rigenerazione dipende dalla presenza di piante giovani prima della tempesta.





2.6.7

2.6.8 Le fermentazioni come risorsa per il Sistema alimentare altoatesino
Latte altoatesino fermentato con starter altoatesini: un abbinamento vincente per sviluppare nuove formulazioni di gelato con migliori proprietà antiradicali e antinfiammatorie.
Negli ultimi decenni, lo sviluppo di nuovi alimenti con proprietà salutari per i consumatori è stato uno dei principali trend delle scienze alimentari. Spesso, questo obiettivo può essere raggiunto sfruttando il potenziale delle fermentazioni microbiche, soprattutto dei batteri lattici. In questo modo, il valore aggiunto è sia diretto, in quanto l'alimento fermentato funge da vettore dei microrganismi funzionali utilizzati come starter della fermentazione, sia indiretto, grazie ai metabolismi adottati dai microrganismi starter e, di conseguenza, dall'ingestione di metaboliti microbici salutari. Oltre a questi aspetti, la fermentazione rappresenta anche una biotecnologia naturale e sostenibile per modulare e migliorare le proprietà organolettiche e prolungare la durata di conservazione degli alimenti. In questo contesto è stato sviluppato il primo gelato fermentato, completamente prodotto in Alto Adige! Infatti, sono stati isolati batteri lattici dal latte vaccino locale e sono stati selezionati quelli che mostravano le migliori prestazioni nella fermentazione del latte e nella lavorazione del gelato. Successivamente, è stato ottimizzato un processo di fermentazione del latte sfruttando diverse combinazioni di

batteri selezionati come starter. Il latte fermentato è stato utilizzato come ingrediente per produrre prototipi di gelato. I prototipi non solo sono stati percepiti molto bene dai potenziali consumatori (valutazione effettuata attraverso una valutazione sensoriale da parte di panelisti addestrati), ma hanno anche mostrato proprietà antiradicali e antinfiammatorie su linee cellulari umane che simulano la mucosa intestinale. Inoltre, questi nuovi gelati fermentati consentono di veicolare milioni di batteri lattici sani nel nostro intestino, che rimangono vivi e metabolicamente attivi nel prodotto anche dopo diversi mesi di congelamento (Figura 1). Lo studio dimostra che il latte altoatesino e gli starter autoctoni, insieme alle competenze locali (della Libera Università di Bolzano) e all'attitudine imprenditoriale (delle aziende che hanno sostenuto i progetti di sviluppo) sono un mix vincente per sviluppare un promettente gelato fermentato di produzione altoatesina.
Sviluppo di un processo biotecnologico ecosostenibile per la produzione di succhi di frutta a basso contenuto di zucchero
Le malattie cardiovascolari, il cancro, l'obesità, le malattie polmonari croniche e il diabete rappresentano un grande problema di salute pubblica a livello mondiale. L'aumento della prevalenza di questi disturbi è stato collegato anche al consumo eccessivo di zucchero. Date le implicazioni del consumo eccessivo di zucchero, l'Organizzazione Mondiale della Sanità (OMS) ha pubblicato una linea guida che raccomanda una assunzio-
ne giornaliera di "zuccheri liberi" da alimenti e bevande non superiore al 10% dell'apporto energetico totale. Numerosi Paesi nel mondo hanno introdotto il pagamento di tasse sulle bevande zuccherate, per scoraggiare la produzione e ridurne il consumo. I produttori sono quindi orientati allo sviluppo di nuove bevande a base di frutta con un ridotto contenuto di zuccheri, pur preservando le caratteristiche nutrizionali e sensoriali della frutta. Dall'Alto Adige proviene circa la metà delle mele prodotte in Italia e quasi un decimo di quelle prodotte in Europa. La competitività del settore frutticolo nazionale e locale può ulteriormente aumentare se si punta a una diversificazione dell'offerta, garantendo prodotti ad alto contenuto di servizio/tecnologia che preservino i principi nutrizionali della frutta. Partendo da queste premesse, la biotecnologia della fermentazione ha permesso di ottenere, in collaborazione con le aziende Zuegg Com e Zipperle nell’ambito di un progetto FESR EFRE, prodotti a base di frutta altoatesina fermentati a ridotto contenuto di zuccheri. I batteri lattici e i lieviti sono stati isolati da diverse matrici vegetali, tra cui varietà di mele locali, e sono stati selezionati quelli che hanno mostrato le migliori prestazioni pro-tecnologiche nella fermentazione di succo di mela e pera. I succhi di frutta fermentati sono stati realizzati in laboratorio utilizzando un processo di fermentazione ottimizzato (Figura 2). L'effetto della tecnologia applicata è stato rilevante non solo per la riduzione dello zucchero nel succo, ma anche per la modifica delle sue proprietà organolettiche.
tati modificano positivamente il microbiota intestinale e mostrano proprietà antiradicali e antinfiammatorie su colture cellulari umane che imitano la mucosa intestinale. La fermentazione, opportunamente disegnata e guidata può quindi rappresentare una fonte di innovazione e competitività in un mondo in continua evoluzione.
Gli arabinoxylan-oligosaccharides (AXOS) fermentati modulano il microbioma intestinale e mostrano un'azione prebiotica: una ricerca altoatesina I ricercatori stanno esplorando modi per migliorare le proprietà prebiotiche degli alimenti per promuovere un microbioma intestinale più sano. Gli studi hanno dimostrato che un microbioma intestinale sano è collegato a numerosi benefici per la salute, come una migliore digestione, un sistema immunitario rafforzato e persino una migliore salute mentale. Per raggiungere questo obiettivo, presso i laboratori Micr4Food della Libera Università di Bolzano sono stati studiati nuovi modi per migliorare le proprietà prebiotiche degli alimenti. Una di queste strade è l'impidego degli arabinoxylan-oligosaccharides (AXOS). Gli AXOS sono un tipo di fibra alimentare presente in alcuni cereali come avena, segale e grano. È stato dimostrato che hanno proprietà prebiotiche, ovvero aiutano a stimolare la crescita di batteri benefici nell'intestino e, a loro volta, possono aumentare la sintesi di acidi grassi a corta catena (SCFA) da parte
dei batteri del colon, noti per la loro funzione proattiva a livello intestinale e per i benefici immunomodulatori per l'uomo. Tuttavia, finora non erano stati esplorati gli effetti di diversi pretrattamenti (come la fermentazione e l’idrolisi) sulle proprietà prebiotiche dell'AXOS. In questo contesto, sono stati prodotti AXOS fermentati e idrolizzati con batteri lattici selezionati e sono stati studiati i loro effetti sul microbioma intestinale umano mediante il simulatore dell'ecosistema microbico intestinale umano (SHIME). SHIME è l'unico modello in vitro scientificamente validato che simula l'intero tratto gastrointestinale. Lo studio ha rilevato che l'assunzione a medio termine (due settimane) di diverse formulazioni di AXOS idrolizzato e fermentato aumentano significativamente la sintesi di SCFA da parte del microbiota del colon, e quello da cru-
sca di segale idrolizzata e fermentata mostra l'effetto più elevato. Tutte le formulazioni fermentate e idrolizzate di AXOS hanno mostrato migliori proprietà probiotiche rispetto alla controparte non fermentata usata come controllo. Anche il microbioma è stato influenzato, con un aumento significativo dei gruppi di Lactobacillaceae dopo l'alimentazione con tutte le formulazioni fermentate e idrolizzate. La famiglia delle Lactobacillaceae, a cui appartengono i batteri lattici, è il gruppo di microbi più benefico, noto per la sua capacità di modulare il microbiota intestinale. In conclusione, lo studio altoatesino fornisce prove promettenti del fatto che gli AXOS idrolizzati e fermentati specialmente della segale possono essere un ingrediente utile per lo sviluppo di nuovi alimenti sani.


2.6.9 Monitoraggio
delle
conseguenze della tempesta
Vaia su erosione, produzione di sedimenti e idrologia forestale in Val d’Ega.


F. Comiti, A. Andreoli, E. Tomelleri Facoltà di scienze e agrarie, ambientali e alimentari, gruppi di lavoro: Idrologia e gestione dei bacini idrografici, Ecologia forestale
di Bolzano per il monitoraggio di lungo periodo di alcune aree in accordo con i proprietari boschivi. In particolare, è stato avviato un progetto di collaborazione, chiamato MoniVa (Monitoring of areas affected by storm Vaia, “Moni-
toraggio delle aree colpite dalla tempesta Vaja”), che prevede il monitoraggio a lungo termine delle dinamiche della vegetazione, dell’erosione, del deflusso idrico e del trasporto solido superficiale nelle aree interessate da Vaia. Mo-
La tempesta Vaia ha abbattuto quasi 6000 ha di superficie forestale in Alto Adige, più del 20% delle quali in Val d’Ega. In questa zona i lavori di sgombero sono stati molto rapidi per motivi orografici e fitosanitari. In questo contesto, la Ripartizione Foreste della Provincia di Bolzano ha avviato una stretta collaborazione con l’Università
niVa punta a valutare le conseguenze delle diverse opzioni di esbosco sulla rinnovazione e il recupero della vegetazione e delle dinamiche vegetazionali che seguono eventi di precipitazione che danno luogo a fenomeni di ruscellamento e conseguente erosione. A tale scopo sono state installate quattro parcelle sperimentali (Figura 1), sottoposte ad altrettanti diversi trattamenti di raccolta e di riforestazione degli alberi abbattuti da Vaia. In queste parcelle, l’acqua e il sedimento mobilizzati a seguito delle precipitazioni vengono raccolti in una cisterna,
e pesati da celle di carico. Un idrometro a pressione permette di misurare il livello e quindi il volume di acqua raccolto e, per differenza con il peso, si ricava il volume di materiale solido, ovvero il suolo eroso. Un pluviometro permette poi di associare l’intensità dell’evento di pioggia alla quantità di sedimenti e al deflusso idrico generato. I dati misurati vengono inviati in tempo reale ad un server tramite rete telefonica GSM permettendo di intervenire velocemente in caso di necessità di svuotamento della cisterna o di malfunzionamenti del sistema.
I risultati preliminari evidenziano che la presenza di una copertura forestale è capace di limitare l’erosione del suolo, ma anche che il rilascio di un certo livello di residui legnosi al suolo contribuisce a rallentare lo scorrimento dell’acqua sulla superficie del suolo e, di conseguenza, l’erosione (Figura 2). Tali indicazioni, se verranno confermate nei prossimi anni, saranno utili ad orientare la gestione forestale anche in termini di mitigazione dell’erosione del suolo e quindi di miglioramento della qualità dell’acqua nei corpi idrici a valle.
2.6.10 Pianificazione forestale di precisione e tecnologia LiDAR

Enrico Tomelleri, Michele Torresani, Giorgio Alberti
Facoltà di scienze e agrarie, ambientali e alimentari, gruppo di lavoro: Ecologia forestale
Come ha dimostrato la tempesta Vaia e l’attuale epidemia di bostrico, i cambiamenti climatici possono mettere a dura prova le foreste nell’arco alpino.
Per renderle più resilienti occorre una gestione di precisione. Con questo scopo, la libera Università di Bolzano, assieme alla Ripartizione foreste e all’Agenzia Demanio Provinciale, ha lanciato una serie di progetti pilota nelle foreste demaniali per la stesura dei piani di gestione forestale con il supporto della tecnologia LiDAR. Gli enti pubblici (Province Autonome e Regioni) ogni 10 anni sono chiamati a elaborare lo strumento di gestione
del patrimonio boschivo, denominato “Piano di assestamento forestale”. Questo documento ufficiale traccia la strada per preservare la salute delle foreste, permette di sapere quante e quali piante sono presenti nei boschi e quanto e quando sia possibile abbattere alberi per mantenere le funzioni dell’ecosistema.
La tecnologia LiDAR è diventata sempre più popolare negli ultimi anni per i piani di gestione forestale. LiDAR è l'acronimo di Light Detection and Ranging e utilizza i laser per misurare le distanze e generare mappe 3D precise dell'ambiente (Figura 1). Questa tecnologia trova numerose applicazioni nel campo della selvicoltura, dalla valutazione dell'altezza degli alberi alla stima della ripresa forestale fino all'identificazione di potenziali pericoli e quindi alla pianificazione dettagliata di strategie di gestione forestale. Uno dei vantaggi più significativi dell'utilizzo della tecnologia lidar per i

piani di gestione forestale è la sua capacità di generare modelli 3D altamente dettagliati e accurati dell'ambiente forestale. Le tecniche di mappatura tradizionali si basano sulla fotografia aerea o sui rilievi a terra, che possono richiedere molto tempo, essere costosi e spesso produrre dati incompleti. La tecnologia LiDAR, invece, è in grado di acquisire milioni di misurazioni al secondo, fornendo una rappresentazione più completa e accurata della foresta in forma di nuvole di punti (Figura 2).
Grazie a queste informazioni, i gestori possono determinare il volume di legname che può essere raccolto in modo sostenibile, identificare le aree ad alta densità di alberi che potrebbero richiedere un diradamento ed ottimizzare i futuri sforzi di gestione. Un'altra importante applicazione della tecnologia LiDAR nella gestione delle foreste è l'identificazione di potenziali pericoli, come pendii instabili,
cadute di massi e frane. I modelli del terreno generati dal lidar possono aiutare a identificare queste aree, dove le operazioni selvicolturali possono essere orientate a migliorare la funzione protettiva del bosco.
Nel complesso, attraverso i progetti pilota per i piani di Piano di assestamento per la foresta del Latemar, di Funes e di Chiusa, la tecnologia LiDAR utilizzata in maniera operazionale sta rivoluzionando gli approcci di pianificazione forestale fornendo dati accurati e completi sul sistema bosco. Questa tecnologia si è dimostrata fondamentale per i gestori forestali al fine di prendere decisioni informate in merito al mantenimento delle funzioni produttive e protettive del bosco, supportando, in ultima analisi, pratiche di gestione forestale sostenibili ed efficienti.
VOG
C. Fischer, Facoltà di Scienze Agrarie, Ambientali ed Alimentari, Gruppo di lavoro: economia agro-alimentare; C. Tappeiner, VOG Products

Secondo l'Organizzazione delle Nazioni Unite per l'alimentazione e l'agricol-
tura (FAO), circa il 22% della frutta e della verdura mondiale viene perso durante il tragitto dall’azienda agricola al supermercato. Oltre alla perdita di sostanze nutritive, questo comporta anche costi ambientali in termini di perdita di terra, acqua, fattori produttivi e manodopera e comporta emissioni di gas serra che contribuiscono
2.6.11

2.6.11
Products come azienda modello per la minimizzazione delle perdite alimentariFig. 2: nuvola di punti di un bosco d'abete Fig. 1: Volumi di raccolta, perdite alla raccolta e in post-raccolta nella produzione italiana di mele
al riscaldamento globale. Gli Obiettivi di Sviluppo Sostenibile delle Nazioni Unite (“SDGs”) chiedono esplicitamente di ridurre significativamente le perdite alimentari lungo le catene di produzione e di approvvigionamento entro il 2030.
Obiettivi e metodologia di ricerca
Questo caso studio empirico, in collaborazione con l'organizzazione di produttori VOG Products, mirava a descrivere i punti di intervento per la riduzione delle perdite di raccolto e post-raccolta nella filiera delle mele. L'azienda innovativa riduce in modo significativo le perdite alimentari in una delle più grandi regioni di coltivazione delle mele al mondo (Alto Adige-Trentino) attraverso le sue varie attività di trasformazione e sviluppo dei prodotti. Descrivendo le attività dell'organizzazione di produttori VOG Products, viene mostrato l'impatto delle innovazioni organizzative e tec-
nologiche sulla riduzione delle perdite alimentari e viene effettuata una valutazione della sostenibilità.
Risultati
VOG Products lavora circa 300.000 tonnellate di mele all'anno, che si stima rappresentino il 70–80% delle mele trasformate a livello nazionale. Abbiamo dimostrato che la lavorazione delle mele che non soddisfano gli standard di qualità della frutta fresca e delle mele scartate dallo stoccaggio riduce in modo significativo le perdite di raccolto e post-raccolta del settore. I calcoli hanno dimostrato che l'azienda ridurrà le perdite italiane di raccolto e post-raccolta nella filiera delle mele dalla consueta quota internazionale di oltre il 20% del raccolto al 7–12% (a seconda dell'anno nel periodo 2016–2019), dimezzandole all'incirca.
Conclusione
Nei suoi 55 anni di attività, VOG Products è diventata leader di mercato e
2.6.12 Il cancro corticale del castagno in Alto Adige
Farooq Ahmad e Sanja Baric
Facoltà di Scienze Agrarie, Ambientali ed Alimentari, Gruppo di lavoro: Patologia vegetale
Il castagno europeo (Castanea sativa) è ampiamente colpito dal fungo invasivo Cryphonectria parasitica, introdotto in Europa negli anni Trenta.

L'agente patogeno penetra nella corteccia dell'albero attraverso fessure o ferite e provoca lesioni necrotiche che nel tempo possono evolvere in un cancro della corteccia. In Europa, il controllo biologico del cancro corticale del castagno riveste un ruolo particolare. Si basa sulla diffusione di ceppi fungini ipovirulenti, infettati da
un ipovirus. L'infezione con l'ipovirus riduce la virulenza del patogeno fungino, in modo che il fungo non possa più penetrare negli strati più profondi del tessuto dell'albero. Così il castagno riesce a isolare il patogeno fungino attraverso la formazione di un callo e a guarire le lesioni cancerose corticali. L'ipovirus si diffonde in natura tramite le spore e i filamenti fungini (o ife), che germinano da esse. Le ife ipovirulenti possono mergersi con quelle dei ceppi fungini virulenti, trasmettendo così l'ipovirus, ma solo in casi che i ceppi fungini rappresentano lo stesso tipo di compatibilità. La compatibilità vegetativa è determinata geneticamente e sono noti almeno 64 tipi diversi di compatibilità. La conoscenza della distribuzione dei diversi tipi di compatibilità in un'area di coltivazione è quindi necessaria per valutare l'efficacia della strategia di controllo biologico del patogeno del castagno.
In Alto Adige, la struttura di popolazione del fungo e dell'ipovirus è stata studiata applicando diversi metodi di genetica molecolare nell'ambito del progetto di ricerca "ChestnutBlight".
figura di riferimento a livello mondiale nel settore della lavorazione della frutta. Questa attività di trasformazione industriale dimezza all'incirca le perdite di raccolto e post-raccolta delle mele a livello regionale e nazionale. Oggi VOG Products è un'azienda redditizia che genera un significativo valore finanziario per i suoi proprietari (organizzazioni di produttori e cooperative, che si basano su circa 6.000 aziende familiari). L'azienda contribuisce in modo sostenibile al successo economico dei piccoli frutticoltori, sviluppando nuovi prodotti. Le perdite alimentari non sono quindi inevitabili. I cambiamenti organizzativi e gli investimenti tecnologici lungo la filiera possono ridurre significativamente le perdite di prodotto. Questo caso studio descrive una situazione di “tripla vittoria” per i produttori, i consumatori e l'ambiente. Altri possono trarne insegnamento.
Nel 2017, 2018 e 2019, sono stati raccolti campioni di corteccia da circa 400 castagni che presentavano sintomi di cancro corticale. Per poter ottenere campioni anche dai rami dei castagni più alti, il campionamento si è concen-
trato sui castagneti in cui sono stati effettuati interventi di risanamento istituzionale da parte del corpo forestale. Per le attività di campionamento si riconosce l'impegno e si ringrazia per il supporto dato da parte del personale delle stazioni forestali, dei membri delle associazioni castanicole, dei proprietari dei castagneti e del personale incaricato per le misure di sanificazione.
In 35 castagneti provenienti da tutto l'Alto Adige e dal Bosco di Monticolo, sono stati trovati in totale 23 diversi tipi di compatibilità di C. parasitica, con i tre tipi di compatibilità più comuni rilevati nel 73% dei campioni. In relazione alle dimensioni dell'area e
in confronto con le altre regioni europee, la diversità dei tipi di compatibilità in Alto Adige è molto elevata. Poiché i dati genetici molecolari indicano che il fungo in Alto Adige si riproduce in gran parte per via sessuale, ciò potrebbe aver contribuito a un aumento della diversità. Inoltre, i risultati dell'analisi mostrano che in Alto Adige potrebbero essersi verificati almeno tre distinti eventi di introduzione del fungo, scaglionati nel tempo.
L'ipovirus è stato rilevato in circa il 30% degli isolati fungini esaminati, con una frequenza variabile tra i diversi distretti e castagneti. Nel complesso, lo studio suggerisce che la prevalenza dell'ipovirus in Alto Adige è bassa rispetto

a molte altre popolazioni dell'Europa centrale e occidentale e che sarebbe necessario adottare misure attive per sostenere la lotta biologica. Il progetto di ricerca ha identificato alcune varianti dell'ipovirus che potrebbero essere interessanti in termini di potenziale utilizzo nel controllo biologico del cancro corticale e che saranno quindi oggetto di ulteriori ricerche nel prossimo futuro. 2.6.12

2.6.13
Tipologie di latte a confronto: impatti economici ed ambientali.
Risultati di uno studio presso
l'azienda agricola sperimentale
Mair am Hof a Teodone sulla realtà altoatesina
T. Zanon1), G. Peratoner2), M. Gauly1),
1) Facoltà di Scienze Agrarie, Ambientali ed Alimentari unibz, gruppo di lavoro: Foraggicoltura e seminativi; 2) Centro di Sperimentazione Laimburg, gruppo di lavoro: Agricoltura Montana
Il progetto Sistema Latte a Confronto è stato avviato nell'ambito del Piano d'azione per l'agricoltura di montagna 2015/2016. La Libera Università di Bolzano e il Centro di Ricerca, affiancati da altre istituzioni agricole altoatesine, sono stati incaricati della realizzazione del progetto. Dopo un'ampia ristrutturazione della stalla esistente a Mair am Hof a Teodone e l'installazione di tecnologie all'avanguardia, come le mangiatoie automatiche per la pesatura del mangime, nel 2019 sono iniziate le prove di confronto dei due sistemi di produzione. Prima dell'inizio delle prove, la mandria da latte esistente
è stata ristrutturata. La stabulazione libera è stata inizialmente separata in due parti uguali. Le razze a duplice attitudine sono state deliberatamente considerate per entrambi i sistemi, poiché in futuro la duplice attitudine al latte e alla carne sembra essere vantaggiosa in termini di efficienza delle risorse e di impronta di carbonio. Il numero di animali è stato scelto in base al numero possibile di unità di allevamento nell'azienda. I sistemi sviluppati nel sito di Teodone rappresentano due diversi sistemi di produzione. Il sistema intensivo (High-Input) comprende bovini di razza Pezzata Rossa (n = 15), senza pascolo, con una razione a base di insilati di mais e alte percentuali di mangimi concentrati, con l'obiettivo di ottenere la massima produzione. Il sistema estensivo (Low-Input) comprende bovini di razza Grigio Alpina (n = 15), pascolo stagionale e una razione a base di foraggio (fieno) senza insilati (Tabella 1).
Estate
Uso intensivo di mangimi concentrati e insilati di mais
Inverno Uso intensivo di mangimi concentrati e insilati di mais
I risultati sono presentati di seguito. Il periodo preso in considerazione va dal 29.01.2019 al 30.01.2023. I risultati mostrano una chiara differenza nella produzione media giornaliera di latte tra le razze e i sistemi. Le vacche di
Produzione di latte fieno; accesso al pascolo: 2/3 foraggio per pascolo, 1/3 foraggio (fieno) in stalla, uso limitato di mangimi concentrati secondo il regolamento della produzione di latte fieno
Produzione di latte fieno; uso di foraggio (fieno), uso limitato di mangimi concentrati secondo il regolamento della produzione di latte fieno
razza Fleckvieh hanno mostrato una produzione di latte giornaliera di circa 31 kg, mentre le vacche di razza Grigio Alpina (in condizioni estensive) hanno raggiunto una produzione giornaliera di latte di circa 21 kg. Le vacche di raz-
za Fleckvieh hanno prodotto latte con una maggiore percentuale di grasso e di proteine rispetto le vacche Grigio Alpine (Tabella 2).
La Figura 1 mostra le differenze di razza nella produzione di latte nel corso dell'anno. A differenza delle vacche
Fleckvieh, le vacche Grigio Alpine mostrano un rendimento leggermente superiore nei mesi invernali. Al con-
Produzione di latte giornaliera
trario, il rendimento è stato inferiore nei mesi estivi.
Oltre all'analisi dei parametri tecnici di produzione, è stata effettuata un'analisi economica sotto forma di calcolo dei costi completi per entrambi i sistemi. I risultati finali non sono ancora disponibili. Tuttavia, la valutazione preliminare mostra che la strategia Low-Input può sicuramente competere economicamente con la produzione intensiva (High-Input), a condizione che il latte sia commercializzato in maniera differenziata a un prezzo più alto. Le principali differenze nei costi di produzione tra i due sistemi sono dovute principalmente alle minori spese per i mangimi concentrati e i servizi veterinari a favore della strategia Low-Input. A prescindere da ciò, il calcolo della redditività mostra che sono necessari prezzi di pagamento più elevati da parte delle cooperative
e ulteriori sussidi mirati per migliorare la redditività dell'industria lattiero-casearia altoatesina per garantirne la sua continuità.
Un altro obiettivo dell'analisi del sistema è la quantificazione delle emissioni di metano. I sistemi zootecnici con ruminanti svolgono un ruolo importante nell'emissione del gas serra metano (CH4), che notoriamente contribuisce in modo significativo al riscaldamento globale. Pertanto, lo sviluppo di strategie per ridurre queste emissioni è una preoccupazione importante per la società. Oltre all'allevamento di vacche a bassa emissione di metano, anche le strategie di gestione potrebbero contribuire a ridurre le emissioni di gas serra degli allevamenti da latte. Tuttavia, sono necessarie informazioni per prendere decisioni appro-
priate. Nell'ambito del confronto tra sistemi a Teodone, è stata calcolata l'emissione di metano di entrambe le strategie di produzione (Low-Input vs. High-Input) utilizzando i parametri di produzione. I risultati mostrano che la gestione dell'alimentazione ha un'influenza significativa sulla quantità di CH4. Il sistema Low-Input produce meno metano per vacca e per giorno rispetto al sistema High-input. Tuttavia, calcolando le emissioni di metano per chilogrammo di latte, lo scenario High-Input ha prodotto proporzionalmente meno CH4 rispetto a quello Low-Input. I risultati di questo studio contribuiscono al dibattito sul futuro della produzione sostenibile di latte nelle regioni montane.

Le scuole professionali offrono percorsi di formazione professionale nel settore agricolo e forestale, dell’economia domestica, della frutti-, viti-, orti- e floricoltura e nel settore della trasformazione alimentare e tecnologia agroalimentare.
Ulteriori informazioni alla pagina web
http://www.provincia.bz.it/formazione-lingue/formazione-professionale/
Scuole professionali agricole
www.fachschule-fuerstenburg.it
www.fachschule-laimburg.it
www.fachschule-salern.it
www.fachschule-dietenheim.it
Scuola professionale per la frutti-viticoltura e il giardinaggio in lingua italiana
www.agraria.fpbz.it
Scuole professionali di economia domestica e agroalimentare
www.fachschule-tisens.it
www.fachschule-kortsch.it
www.fachschule-haslach.it
www.fachschule-neumarkt.it
www.fachschule-dietenheim.it
Formazione professionale 2.7
2.7.1 Scuola professionale Laimburg
Scuola professionale Laimburg: la prima scuola del consumatore consapevole e responsabile in Italia
mamente e con successo, nel sempre più complicato mondo della vita professionale e della quotidianità. Si tratta della Scuola del consumatore responsabile e consapevole nella quale sono coinvolti non solo gli studenti della Laimburg, ma anche il personale docente e non docente e persino i genitori degli studenti stessi.
2.7.1
È
ormai già il terzo anno che presso la Scuola professionale Laimburg di Vadena (BZ) viene realizzato un progetto che ha l’obiettivo di preparare tutti gli studenti a muoversi, autono-
In collaborazione con il Centro tutela consumatori e utenti dell’Alto Adige e del Centro europeo dei consumatori con sede a Roma e a Bolzano gli studenti della Laimburg hanno avuto e avranno la possibilità di seguire, nell’ambito del loro percorso scolastico, un corso di formazione tenuto da esperti/e delle due associazioni sopra citate, con successivi approfondimenti sulle tematiche da parte dei docenti della Laimburg.

Per poter realizzare al meglio questo progetto è stato creato, all’interno della Scuola Laimburg, un gruppo di lavoro di insegnanti coordinato dal prof. Luca Malopri. A tal proposito va sottolineata anche l’importanza data all’apprendimento linguistico; molte attività vengono, infatti, svolte sia in tedesco, la lingua principale, che in italiano e, nelle classi superiori, anche per una minima parte in inglese. Gli studenti, insieme con gli esperti e alcuni dei loro insegnanti, hanno affrontato le seguenti tematiche: le prime classi hanno lavorato sull’importanza della salute, sull’alimentazione sana, corretta e sostenibile e sullo spreco alimentare. Dopo aver ricevuto, sempre lavorando in modo creativo e pratico le necessarie informazioni, realizzano in modo concreto quanto appreso. In questo ambito hanno imparato, con la relatrice Silke Rafffeiner a fare la spesa in modo responsabile, cioè a farsi una lista di ciò che è veramente necessario comprare prima di andare al supermercato, di andarci a stomaco pieno, di stare attenti alla disposizione della merce negli scaffali (quella di marca è più costosa e solitamente all’altezza del busto), a non acquistare prodotti mentre si attende in fila vicino alle casse, ai tranelli che vengono usati per farci acquistare di più come i riflettori rossi dove c’è la carne, agli imballaggi e alla provenienza dei prodotti ecc. Inoltre, non lasciano più cibo nei piatti in mensa, ma consapevolmente prendono solo ciò che mangiano, non esiste più a scuola un distributore per

merendine e bevande che sono vere e proprie bombe caloriche, ma hanno a disposizione frutta fresca di stagione, un dispenser per l’acqua con eventuali sciroppi da loro prodotti. Per due settimane hanno partecipato al progetto “Bere solo acqua dal rubinetto” per diventare più consapevoli sull’inutilità dell’acquisto di bottiglie d’acqua che sono spesso pure di plastica. Le seconde e terze classi hanno affrontato e affrontano le tematiche social-media e sostenibilità con il relatore Francesco Imbesi e hanno ulteriormente approfondito il tema dell’alimentazione sana e corretta, sempre con la relatrice Silke Raffeiner. Dopo aver misurato con apposite attrezzature le radiazioni all’interno dell’edificio scolastico si è deciso di sistemare in ogni aula degli appositi contenitori protettivi dove depositano i loro cellulari all’inizio di ogni lezione. Inoltre, si
è ridotto drasticamente l’utilizzo della plastica, per esempio in quanto vengono utilizzati da tutti solo bicchieri di vetro e un’unica bottiglia termos che gli studenti acquistano all’inizio dell’anno scolastico. Nel corso di una giornata di work shop hanno anche ideato e realizzato degli adesivi e un prospetto informativo, il tutto bilingue, per sensibilizzare e fare qualcosa per la tutela dell’ambiente. Con le quarte classi si sono affrontati gli argomenti finanze e assicurazioni e i rapporti con le banche e le agenzie con la relatrice Stefanie Unterweger e il relatore Florian Oberhuber. In questo ambito gli studenti imparato a confrontare le varie offerte bancarie e assicurative, a trattare con gli istituti bancari prima di firmare un qualsiasi contratto, a capire ciò che per loro e il loro maso o vivaio è veramente necessario ecc.
Infine, le quinte classi hanno lavorato sul tema dei diritti dei consumatori a livello europeo, in particolare sulle problematiche riguardanti i viaggi all’estero con la relatrice Monika Nardo e il relatore Stefano Albertini. Tali informazioni si sono rivelate molto utili, anche quando si trattava di organizzare il loro viaggio d’istruzione a Roma e il loro viaggio di maturità. Tutte le attività sono state svolte durante il normale orario scolastico e si è cercato di coinvolgere il più possibile gli studenti con lavori di gruppo, video, ma soprattutto attività ed esempi pratici. Inoltre, si sono create delle “classi aperte” per permettere ai ragazzi di lavorare insieme anche con i loro compagni di altre classi. Purtroppo, negli anni con misure anti Covid non è stato possibile organizzare escursioni al

di fuori della scuola: in supermercati, banche, al centro sperimentale, ecc. e work shop creativi su tematiche specifiche, attività che invece si sono svolte con grande successo sia quest’anno che negli anni precedenti.
Ma in questo progetto non sono coinvolti sono gli studenti, bensì anche tutto il personale della scuola e, almeno in parte, i genitori. Si sono organizzati, infatti, vari incontri, in presenza e online, aperti al personale scolastico (insegnanti, segretarie, bidelle ecc.) e ai rappresentanti dei genitori su tematico come: l’alimentazione sana con Silke Raffeiner, come risparmiare e investire con la direttrice del CTCU Gunde Bauhofer e su come risparmiare energia e soldi con l’ex direttore del CTCU Walther Andreaus.
Nell’ambito del progetto si cerca di sviluppare anche le competenze linguistiche dei partecipanti per cui, ad esempi, vedono un video in inglese, fanno la discussione in tedesco e scri-
vono poi un protocollo in italiano. Alla fine di ogni attività sono stati richiesti ai partecipanti un feed back dal quale è emerso un alto gradimento e una partecipazione attiva e costruttiva da
Sentire – odorare –gustare!
Lezioni interdisciplinari di pratica nella seconda classe
Nel corso dell’anno scolastico passato le scolare della seconda classe della scuola professionale per l’economia domestica e agroalimentare Corces, hanno realizzato un progetto speciale, frutto di un perfetto connubio fra sapere pratico e teorico. Le scolare della seconda classe guidate dalle loro insegnanti Susanne Federspiel (conduzione della cucina, scienza dell’alimentazione), Karoline Ratschiller (servizio di pietanze e bibite) e Sinja Telser (allestimento d’interni) hanno lavorato ai contenuti didattici sul tema “buffet”.

Durante la prima unità didattica di pratica, le scolare hanno realizzato un buffet di antipasti all’italiana. Il fulcro delle attività è consistito nella preparazione di diversi tipi di ortaggi e salse e degli antipasti tipici italiani, nonché della loro sapiente presentazione su diversi tipi di vassoi. Nella materia allestimento d’interni, le alunne hanno
parte di tutti, motivo per cui si pensa di poter continuare con questo progetto anche nei prossimi anni.
ricercato diverse possibilitá di decorare i tavoli e hanno realizzato dei set da tavolo in stile mediterraneo, molto creativi e in armonia con il tema. Nella materia servizio di pietanze e bibite, le scolare si sono occupate di creare un buffet, di allestire il tavolo del buffet, di apparecchiare i tavoli e di piegare i tovaglioli in modo adeguato alle decorazioni dei tavoli.
La seconda unità didattica aveva come motto “ Pietanze tipiche sudtirolesiinterpretate in modo nuovo”. L’assortimento era veramente grande, infatti i piatti spaziavano dagli Schlutzkrapfen (mezzelune ripiene) fatti da loro, alla minestra d’orzo, allo strudel di crauti, agli gnocchetti di grano saraceno, alla rosticciata del contadino, fino al dolce con Kaiser-Schmarrn (crespelle spezzettate dolci), frittelle di mele e gli straboli (dolce fritto).
Per questa unità didattica le discenti, con la consulenza esperta della loro insegnante di allestimento di interni, hanno scelto una decorazione per i tavoli semplice, con i toni naturali e con erbette in bicchieri di vetro. Anche i cartoncini per i tavoli sono stati realizzati in uno stile discreto e naturale in sintonia con il soggetto. Il tavolo del
2.7.2 Scuola professionale per l’economia domestica e agroalimentare Corces e per l’agricoltura e le foreste Fürstenburg (con sede a Burgusio)
buffet invece, è stato allestito in modo ricco e generoso, in modo da offrire agli invitati un’ impressionante varietà e scelta.
Sempre con grande competenza le scolare hanno messo in scena anche le posate e con i tovaglioli dalle tonalità marroni, hanno creato delle originali tasche porta posate. ”Last but not least” le partecipanti hanno dimostrato il loro sapere e le loro capacità nell’ultima unità didattica di pratica. Si trattava infatti di confrontarsi con gli obbiettivi didattici sul tema “brunch”. In cucina hanno preparato pane, spremute fresche, piatti freddi, pietanze a base di uova, bastoncini di verdura, waffeln, pancakes e molto di più. Per la decorazione degli ambienti hanno usato i primi boccioli e fiori offerti dalla primavera. Di nuovo le scolare si sono occupate delle piú svariate tec-
niche di piegare i tovaglioli e dei motivi. Alla fine hanno deciso di piegare i tovaglioli con la forma del coniglio di Pasqua.
Anche il ricco tavolo del buffet e i tavoli degli invitati rispecchiavano il motivo

pasquale. Le scolare si sono divertite a lavorare nei diversi gruppi di pratica e ai diversi buffet, inoltre i tre diversi buffet hanno offerto un vero piacere per gli occhi e per il palato.




10 anni del Centro delle Api Fürstenburg
Il progetto Intereg IV “Tre paesi delle api Alto Adige-Austria-Svizzera” ha avuto inizio nell’anno scolastico 2012/13 presso la scuola professionale per l’agricoltura e le foreste Fürstenburg.


L’obiettivo di questo progetto era quello di creare un centro di competenze per la melittologia e l’apicoltura presso la scuola professionale Fürstenburg con il sostegno di 2 scuole partner, l’istituto agrario LLA Imst (A) e l’istituto agrario LBBZ Plantahof nel Cantone dei Grigioni (CH). Questo progetto nel Triangolo Retico ha costituito la base di un fenomeno di successo che dura ormai da 10 anni e che insieme ad altri fattori, ha permesso la creazione del Centro delle Api Fürstenburg. Fino ad oggi la struttura fondamentale di questo centro di competenze si basa su tre colonne portanti.
La prima colonna portante è rappresentata dalle lezioni di pratica per melittologia e apicoltura che, ormai da 10 anni, sono un elemento fisso del programma formativo della scuola professionale. Nei primi tre anni le lezioni di pratica pongono le basi di questa disciplina e stimolano l’interesse degli scolari. Nel quarto anno, nella materia facoltativa “Api”, vengono offerti in modo approfondito singoli settori tematici e addirittura alcuni maturanti elaborano, nel loro corso di preparazione alla maturità, dei progetti unici e sostenibili su questo tema.
Nell’anno scolastico 2021/22, due maturanti hanno creato con 2 progetti ben riusciti, ulteriori elementi costitutivi per il Centro delle Api Fürstenburg.
Nello specifico un percorso didattico sulle api, concepito e allestito dallo scolaro Alex Kerschbaumer di Proves, dotato di 12 pannelli informativi sul mondo delle api, arricchisce le lezioni di pratica della propria scuola, la materia facoltativa delle scuole elementari e medie ed offre ai gruppi di apicoltori la possibilità di usufruirne per corsi di aggiornamento.
Il secondo progetto aveva come tema la riorganizzazione e la valorizzazione dell’apiario didattico del circondario dell’Alta Venosta, che confina con l’areale scolastico. Il maturante Tobias Tarneller di Cengles ha eseguito diversi lavori di ristrutturazione e rinnovamento.
La seconda colonna è costituita dalla collaborazione e dallo scambio con l’Associazione Apicoltori Alto Adige e con gruppi di apicoltori dall’interno e dall’estero. Presso il Centro delle Api Fürstenburg vengono offerti da 10 anni tutti i corsi per apicoltori, corsi di prova, il modulo di base per apicoltori e il modulo professionale avanzato per apicoltori, il modulo per allevatori
di api regine e altri moduli per la produzione, la lavorazione e l’affinamento dei prodotti delle api. Nel frattempo la Fürstenburg si è affermata come sede permanente di convegni e conferenze. I più svariati gruppi di interesse nel campo dell’apicoltura si sono riuniti, confrontati, hanno festeggiato e hanno stretto delle amicizie, accomunati dalla passione per l’apicoltura. La terza colonna è rappresentata dalla formazione e dai corsi di aggiornamento degli insegnanti del Centro delle Api e dal collegamento con istituti delle api e centri di ricerca nazionali e internazionali. La formazione di personale specializzato e dei moltiplicatori era un elemento costitutivo del Progetto Intereg IV e ne costituisce fino ad oggi la base solida e competente. La direzione della scuola professionale Fürstenburg ha sempre promosso e sostenuto la creazione del Centro delle Api. Ci auguriamo che il Centro delle Api Fürstenburg continui ad avere successo come esempio di formazione sostenibile, scambio e collegamento.

2.7.3 Scuola professionale per l’economia domestica e agroalimentare Teodone
Che il pascolo torni ad essere un pascolo
Un pascolo, come un bosco o un prato, ha bisogno di cure regolari. Per sensibilizzare e aumentare la consapevolezza, la scuola professionale per l’agricoltura di Dietenheim/ Teodone invia regolarmente i suoi studenti a fare “lavori di pulizia”, questa volta con la quarta classe sui pascoli delle frazioni Dietenheim/ Teodone e Gais.


Dennis, uno studente della quarta, riassume la sua esperienza in questo modo: “Il progetto è stato molto istruttivo e interessante. Ci è piaciuto lavorare in modo indipendente e all’aperto. E abbiamo capito l’importanza della cura del pascolo. ” In autunno, Dennis e i suoi compagni di scuola hanno portato a termine questo progetto di gestione dei pascoli su un totale di circa 2 ettari nelle frazioni Dietenheim e Gais. Il progetto fa parte dei laboratori pratici previsti dalla scuola professionale. Stefan Steinwandter della stazione forestale Campo Tures e Stefan Schwingshackl della stazione forestale di Brunico hanno accompagnato i ragazzi sotto il profilo tecnico.
Il vantaggio di tale «pulizia domestica» consiste, da un lato, nella valorizzazione del pascolo e, di conseguenza, nell’aumento della resa di foraggio. Questo diminuisce nel tempo, quando un pascolo è invaso da un numero in-
sufficiente di animali rispetto alla sua superficie. Perché la natura recupera a piccoli passi ciò che l’uomo le ha sottratto. La successione ecologica sarebbe infatti, a lungo termine, la foresta. D’altra parte, la cura fa bene anche all’immagine esterna del paesaggio culturale. Uno spettacolo magnifico appunto.
In primo luogo, le azioni necessarie sono state coordinate e concordate e gli alunni sono stati divisi in due gruppi di lavoro. Dotati di attrezzi come falciatrici, motoseghe, coltelli atti a tagliare fogliame, rastrelli, cunei da taglio, corde e altri attrezzi e cartelli di avvertimento da parte delle amministrazioni e degli agricoltori interessati, i giovani si sono messi al lavoro: molti alberi sono stati abbattuti e sono stati eseguiti diversi lavori di falciatura e pacciamatura. Durante i lavori di pulizia e di rimozione del legname abbattuto, i contadini hanno aiutato con mezzi meccanici i due gruppi di studenti. In un’altra unità di laboratori pratici, gli alunni hanno infine costruito una staccionata a Gais.
“Durante la visita finale dei pascoli ci siamo resi conto di quello che avevamo fatto in poco tempo. Inoltre, il nostro insegnante Markus Rederlechner e i due forestali ci hanno elogiato per la qualità del nostro lavoro”, dice l’allievo Sebastian. Gertraud Aschbacher, direttrice della Scuola professionale per l´agricoltura, economia domestica e alimentazione di Dietenheim, si è rallegrata del fatto che la collaborazione tra la scuola, le stazioni forestali e i gruppi abbia funzionato meravigliosamente e che progetti di questo tipo abbiano creato un valore aggiunto per tutti.
2.7.4 Scuola professionale per l’agricoltura ed economia domestica Salern
Il termine “sostenibilità” deriva da un settore strettamente legato all’agricoltura, la silvicoltura, dove significa che non si deve abbattere più legno di quanto ne possa ricrescere. Oggi questo termine viene applicato a molti settori della vita e significa in generale che i sistemi non devono essere utilizzati e consumati più di quanto possano rigenerarsi. L’idea guida è quella di lasciare alle generazioni future tutte le condizioni necessarie per una buona vita. Anche l’agricoltura non può funzionare a lungo termine senza sostenibilità. Solo chi protegge il suolo, l’acqua, il bestiame, ecc. può essere sicuro che la sua azienda agricola rimarrà sana ed efficiente nel lungo periodo. Per la scuola professionale agraria Salern, è molto ovvio scrivere sostenibilità a lettere maiuscole. Così, l’argomento non viene affrontato solo in classe nell’ambito di vari workshop con partner esterni (OEW, centro tutela per i consumatori) o durante la giornata pedagogica degli insegnanti, ma anche nei processi quotidiani della scuola e dell’azienda agricola. Negli ultimi anni sono già state realizzate diverse iniziative:
Si fa attenzione a usare le risorse con parsimonia, a evitare gli sprechi e a separarli. Inoltre, è stato acquistato un distributore automatico di acqua per consentire agli studenti, alla comunità scolastica e ai partecipanti ai corsi di riempire le loro bottiglie d’acqua. La macchina del caffè funziona con le tazze. La fotocopiatrice è impostata per la copia fronte/retro e le copie “sbagliate” vengono raccolte in una scatola separata e possono essere riutilizzate.

Anche nella mensa scolastica si utilizzano, per quanto possibile, prodotti dell´azienda. La scelta spazia da latte e latticini a carne, patate, verdure e uova. Inoltre, la scuola acquista prodotti da aziende agricole biologiche altoatesine (mele, verdure...) e in genere presta attenzione a un elevato contenuto biologico negli ingredienti.
Benvenuti nell’Acri del mondo di Salern!
Dal 2021 è partito il progetto “Acri nel mondo”. Un altro passo verso la sostenibilità. Ma di cosa si tratta?
Per ogni persona nel mondo sono disponibili circa 2.000 metri quadrati di terra coltivabile. Questa superficie dovrebbe nutrire bene e in modo sano una persona e fornire anche tè, caffè, cacao, cotone e simili. Ma tutto ciò è redditizio?
Queste e molte altre domande sono state affrontate dalla scuola proges-
Il nostro percorso verso una maggiore sostenibilità
sionale per l’agricoltura e l’economia domestica di Salern dallo scorso anno scolastico. Nel corso di questo processo, è stato creato un mini-Acri del mondo su 200 m², ovvero su 1/10 del fabbisogno della scuola di terra coltivabile mondiale. Quest’area ospita, ad esempio, le colture più importanti del mondo, necessarie per la produzione di cibo, mangimi, energia e combustibili, nella stessa proporzione in cui crescono sugli 1,5 miliardi di ettari di terreno coltivabile sulla terra. L’obiettivo è quello di fornire non solo agli alunni, ma anche a tutti i visitatori una visione della produzione di alimenti. La scuola cerca di utilizzare questa visualizzazione per rendere più

comprensibile un tema globale. Sotto forma di visite guidate e di piccoli workshop tenuti da relatori, vengono fornite informazioni sulle condizioni ecologiche, sociali, economiche e politiche dell’agricoltura. Anche i temi speciali vengono ripresi e affrontati in modo adeguato all’età. Per esempio, con i bambini più piccoli si guarda a quali animali vivono nei campi, a cosa si coltiva e a come si tratta il cibo, mentre in collaborazione con gli adulti l’argomento principale è l’importanza della silvicoltura e dell’agricoltura, nonché l’apprezzamento del cibo, che è la base della nostra vita e della nostra cultura. Questa forma di sensibilizzazione ha lo scopo di far ca-

pire ai presenti come viene distribuita la terra e come può essere protetta e utilizzata in modo ottimale. L’Acri mondiale di Salern invita a riflettere sulle proprie abitudini alimentari e di consumo. Perché esse determinano la superficie coltivabile del mondo e hanno un’influenza costante sulla giustizia distributiva.
2.7.5 Scuola professionale per l’economia domestica e agroalimentare Tesimo
Rimanere al passo con i tempi
La scuola professionale per l’economia domestica e agroalimentare di Tesimo ha sempre perseguito lo stesso obiettivo, semplice e complesso allo stesso tempo: preparare bene i giovani al lavoro e alla vita. Per avere successo, è necessario un equilibrio particolarmente buono tra continuità e sicurezza e il coraggio all’ innovazione, soprattutto nel nostro tempo di cambiamenti.
I numeri parlano chiaro: 90 studenti iscritti nell’anno scolastico in corso sono la prova che l’offerta della scuola professionale di Tesimo, con convitto annesso, è molto apprezzata nella regione.
Pratica e teoria – insieme imbattibili
Questa combinazione si è dimostrata più che efficace nella vita scolastica. Le spiegazioni possono essere diverse: una di queste potrebbe essere rappresentata dai periodi di formazione notevolmente più lunghi, che spesso non soddisfanno le esigenze dei giovani sempre più dinamici. La scuola
professionale di Tesimo ne tiene conto e offre a tutti i livelli scolastici un’ampia gamma di attività in cui gli studenti possono dimostrare le proprie competenze sotto la propria responsabilità. Gli esempi sono molti, ma due eventi sono presentati qui a titolo esemplificativo:
• Nell’ambito dell’anno di orientamento, la classe prima ha organizzato una festa Prenatalizia per i genitori. L’ evento è stato un successo sotto tutti i punti di vista, scolastico e sociale. Gli studenti hanno mostrato tutto il loro potenziale e hanno ricevuto molti complimenti.
• La cooperativa studentesca “hondgmocht&hausgmocht” delle classi terze e quarte è riuscita a portare a termine con successo il compito di fornire un catering sostenibile a circa 120 ospiti dell’Associazione delle Donne Coltivatrici Sudtirolesi.

Guardare oltre l’orizzonte –un successo
Una realtà piccola come la scuola professionale di Tesimo ha bisogno di un correttivo esterno, sia per gli insegnanti che per gli studenti. In questo contesto, diverse iniziative si sono dimostrate valide, tutte hanno fornito un’esperienza preziosa senza però gravare economicamente sulle famiglie. Due progetti saranno riportati in dettaglio:
• La classe seconda si è aggiudicata il primo premio, un viaggio in gita a Berlino, nell’ambito del Concorso degli alunni per l’educazione politica 2022 dell’Agenzia federale per l’educazione civica di Bonn. Per il loro progetto, i 23 alunni hanno sviluppato azioni pratiche fino al

2030 per diffondere la solidarietà, la parità dei sessi e le pratiche di vita sostenibile nella vita scolastica quotidiana e non solo. Le prime azioni sono già in corso e, in linea con la tradizione della scuola, la pratica e la teoria sono state combinate con successo.
• Il Progetto Erasmus +” Heimat und regionale Identität in Europa” è programmato per un periodo di due anni e coinvolge diverse classi. Nell’anno scolastico in corso, c’è già stato uno scambio con la Germania e il Belgio. Nell’autunno 2023, la nuova classe quarta accoglierà i suoi
2.7.5

partner a Tesimo e in primavera, infine, visiterà i suoi partner tedeschi e belgi in Germania con un viaggio anche a Bruxelles.

Dare forma oggi al domani È un’ovvietà che la rotta per il futuro viene impostata nel presente, ma allo stesso tempo è così vera e importante che dovrebbe essere ricordata sempre. Dopo tutto, sono i giovani di oggi che guideranno il destino di tutti noi domani.
La mostra dei progetti della scuola professionale di Tesimo alla Giornata della Scuola Aperta ha suscitato molto interesse. Gli studenti hanno mostrato le loro competenze scolastiche con impegno e gioia, così che tutti – comunità scolastica e visitatori sono tornati a casa con impressioni positive e molto soddisfatti.


2.7.6 Scuola professionale per l’economia domestica e agroalimentare Egna
Anno di orientamento alla Scuola professionale per l’economia domestica e agroalimentare di Egna
Per la prima volta nell’anno scolastico 2022/23, la Scuola professionale di Egna propone, come offerta alternativa dopo la scuola media, un anno di orientamento durante il quale gli alun-
ni e le alunne potranno scoprire le loro potenzialità.
“Inizia! Riconosci il tuo talento e trova la tua strada.” È all’insegna di questo motto che è stato ideato e presentato l’anno di orientamento.
Al termine della scuola media, si impone la decisione su quale percorso di istruzione superiore intraprendere. Mentre una parte dei giovani e delle giovani ha già un’idea chiara sulla scuola superiore che frequenterà, una parte dei quattordicenni e delle quattordicenni ha difficoltà a prendere una decisione definitiva sul tipo di scuola a cui iscriversi. La pressione di dover prendere una decisione spesso porta alla scelta di una scuola che non corri-
sponde alle proprie inclinazioni e alle proprie aspettative. L’anno di orientamento rappresenta una soluzione per aiutare l’alunno o l’alunna ad affrontare con serenità e consapevolezza questo delicato processo decisionale.
Nel corso degli anni, la scuola professionale di Egna si è trovata spesso ad accogliere giovani provenienti da altre scuole secondarie di secondo grado, che avevano deciso di cambiare ad anno in corso o dopo aver frequentato il primo o il secondo anno di istruzione superiore. Grazie alla molteplicità dell’offerta, all’apprendimento basato sulla pratica e sulla collaborazione, alla promozione dell’apprendimento responsabile e alla condivisione di esperienze di successo, questi studenti e queste studentesse hanno ritrovato l’entusiasmo e la motivazione per l’apprendimento consolidando le proprie competenze. Dopo aver completato i tre anni di formazione, molti di questi giovani e di queste giovani hanno proseguito gli studi in un’altra scuola secondaria o hanno conseguito la maturità.
Come è organizzato l’Anno di orientamento
Le sei settimane tematiche (Themenwochen) sono uno dei pilastri fondamentali dell’Anno di orienta-
mento. Durante queste settimane di lezione, gli studenti e le studentesse hanno l’opportunità di fare esperienze ed acquisire competenze in diversi ambiti: creatività e artigianato (Kreatives und Handwerk), cibo e bevande (Essen & Trinken), io e gli altri (Ich & die anderen).
Kreatives und Handwerk

Le settimane tematiche dedicate alla creatività e all’artigianato si concentrano sulle abilità artigianali degli studenti e delle studentesse. Durante l’anno scolastico 2022/23 gli alunni e le
alunne hanno potuto ampliare le loro competenze e abilità artigianali nel settore tessile e in quello del legno.

Essen & Trinken
Nelle corso delle due settimane tematiche dedicate all’alimentazione e alle bevande, gli studenti e le studentesse si sono confrontati con il tema dell’alimentazione sana e sostenibile. Ad esempio, hanno condotto delle ricerche sulle possibilità concrete per alimentarsi in modo sostenibile e hanno poi presentato i risultati di questo lavoro alla festa di fine anno.
2.7.7 Scuola professionale di economia domestica e agroalimentare Aslago
Acqua: essenziale, preziosa e divertente
Nuovo progetto per le classi della scuola primaria presso la Scuola Professionale per l’economia domestica e agroalimentare Aslago

Da quest’anno presso la Scuola Professionale per economia domestica esiste un nuovo progetto per i bambini delle scuole primarie chiamato “Acqua: indispensabile, preziosa, divertente”.

Vivere l’acqua si in modo giocoso, ma trattandola con rispetto e apprezzamento, queste sono le affermazioni centrali del progetto. Lo scopo del progetto è quello di far comprendere
ai bambini l’importanza dell’acqua e di incoraggiarli ad un uso più consapevole di questo elemento vitale.
Il tema dell’acqua è trattato da diverse angolazioni. In primo luogo, viene illustrato per cosa l’acqua è effettivamente necessaria e quanto sia importante per la vita su questo pianeta e per il nostro benessere e la nostra salute. I bambini imparano come risparmiare acqua nella vita di tutti i giorni e quale impatto ha il nostro consumo di acqua sull’ambiente.
Con semplici esercizi e illustrazioni i bambini prendono coscienza di quanta acqua usiamo singolarmente effettivamente ogni singolo giorno e perché è importante utilizzare con parsimonia questa preziosa risorsa. Un altro obiettivo del progetto è quello di diffondere la conoscenza della quantità e della distribuzione dell’acqua sulla terra. I bambini imparano quanta acqua c’è sul nostro


“pianeta blu” e quale è il rapporto tra la quantità di acqua salata e acqua dolce. Questo viene illustrato ai bambini in modo molto pratico: nell’aula c’è un secchio con 10 litri d’acqua, che rappresenta l’acqua salata sulla terra. Dal secchio si prelevano 4 cucchiaini, questi rappresentano la falda freatica, un singolo cucchiaino indica la nostra disponibilità di acqua potabile. I tre contenitori con l’acqua uno accanto all’altro stupiscono gli studenti. Il ciclo dell’acqua viene spiegato con una poesia illustrata con immagini. La rappresentazione aiuta i bambini a capire come l’acqua evapora dalla superficie terrestre, si condensa in nuvole e poi ricade sulla terra sotto forma di pioggia.

Attraverso vari semplici esperimenti, i bambini apprendono in modo giocoso le caratteristiche dell’acqua. Termini come tensione superficiale e capillari-
tà vengono spiegati in modo semplice e comprensibile per i bambini. Il progetto promuove quindi anche la comprensione delle relazioni ecologiche. Naturalmente, c’è anche spazio per il gioco e la creatività. I bambini confezionano delle palline effervescenti per il bagno utilizzando ingredienti naturali e sperimentano con le bolle di sapone.



Quest’anno diverse classi scolastiche di tutto l’Alto Adige si sono iscritte al progetto “Acqua: indispensabile, preziosa, divertente”. Il progetto è stato accolto molto bene, sia dai bambini che dai loro insegnanti accompagnatori.

Aumentando la consapevolezza per un uso responsabile, parsimonioso e rispettoso della preziosa risorsa acqua, diamo un importante contributo alla sostenibilità e all’attuazione dei 17 obiettivi globali delle Nazioni Unite.

Partecipazione ad eventi fieristici e visite di istruzione
Anche in questa edizione di Agrialp, la scuola ha partecipato con un proprio stand, interamente progettato e realizzato, come di consueto, dagli alunni. Il gioco a tema “melapesco” è stato accompagnato dalla produzione in loco di mele essiccate. Formative e interessanti le visite ad aziende specializzate di settore come la “VOG products” per conoscere le lavorazioni secondarie delle mele, all’orto botanico di Bologna e al grande “Vivai Lucio Rossi” specializzato in specie arboree nel mantovano.



Stage
Per quest’anno formativo le tre settimane di Stage si sono svolte interamente presso le aziende locali operanti nel comparto agricolo. Pur non avendo potuto, come di prassi per la terza classe, svolgersi in area germanica, lo stage è stato una preziosa occasione per calarsi appieno nella realtà lavorativa aziendale del territorio, mettere in pratica le conoscenze acquisite e sviluppare ulteriormente le competenze tecnico applicative. I futuri tecnici del verde, allievi ed allieve della quarta classe, sono stati impegnati per ben otto settimane di stage: 320 ore di pratica in aziende
specializzate situate sia nella Provincia di Bolzano sia in quelle limitrofe.
Interventi sul verde
Molteplici gli interventi sul verde svolti dagli alunni e alunne, di tutte le classi. Potatura di siepi, rose e alberature, arieggiatura del prato, gestione e manutenzione delle aiuole, pulizia dalle infestanti, sono alcune delle operazioni che hanno interessato il Verde urbano del Comune di Vadena, l’area verde del Comando delle truppe alpine di Bolzano, il verde del parcheggio della Caserma dei Carabinieri 7° reggimento Guella Laives, il circolo ufficiale alpini Merano, e un giardino privato a pineta di Laives. Anche nel castagneto di Frangarto si è fatta la manutenzione e le piante trattate contro il cancro. Quest’anno gli alunni hanno ripristinato il vivaio della scuola a Laives con circa 650 piante ornamentali, creato un piccolo “orto dei semplici” con essenze aromatiche ed officinali e un impianto di piccoli frutti nell’area posteriore della scuola.
Collaborazioni con il Demanio Provinciale
In seguito all’accordo stipulato fra la scuola e l’Agenzia del Demanio Provinciale, gli alunni e le alunne della nostra scuola, quest’anno hanno in-
2.7.8 Manifestazione e attività della scuola professionale provinciale per la fruttiviticoltura e il giardinaggio di Laimburg in lingua italianaEsperimento – Acqua errante Acqua e capillarità Produzione di “Palle da bagno”
crementato le attività svolte potendo esercitarsi, oltre che presso le consolidate aziende private, anche nelle vigne e nei meleti del Demanio così come nella grande e attrezzata serra di Laimburg. In campo si sono cimentati in potature di meli e viti, esercitati nell’apposito campo di simulazione nella realizzazione di nuovo impianto di mele, nel tiraggio di funi e fili, messa a dimora piante e nel riconoscimento della qualità del materiale vivaistico. In serra hanno riprodotto piante per talee e semina, trasferite ed utilizzate poi nel vivaio della scuola. Formativa e utile anche la visita alla sezione Difesa del Centro di Sperimentazione di Laimburg per parlare di Cimice Asiatica.

Attenzione alla salute e prevenzione
Importanti momenti di informazione e riflessione utili a stimolare consapevolezza e crescita personale, gli incontri e i workshop a tema sono parte integrante del percorso scolastico. Gli alunni ed alunne hanno usufruito dello “Sportello all’ascolto” seguito da un counsellor familiare per favorire la comunicazione nel contesto scuola famiglia, degli interventi supportati da esperti del servizio di Medicina di Base sulla “Educazione all’affettivi-

tà”, delle informazioni sulla “Filiera dell’illegalità e effetti delle sostanze psicotrope illecite e cyberbullismo” fornite da esperti delle forze dell’ordine. Oltre ai già sperimentati workshop quest’anno gli alunni hanno partecipato all’esperienza “Aria viziata nell’aula scolastica” monitorando attivamente per un periodo la qualità dell’aria in aula.
Attenzione all’ambiente
Nell’ambito sempre più rilevante delle tematiche ambientali, le attività “La bussola del consumo” e “RedUse” per i nostri alunni e alunne, sono state occasioni per iniziare a riflettere e di imparare ad orientarsi come consumatori consapevoli in un’ottica di sostenibilità. Accanto a questi workshop quest’anno è iniziata la partecipazione attiva al progetto di ripulitura delle campagne del demanio di Laimburg con la raccolta dei rifiuti non degradabili abbandonati. Un modo diretto e utile di rivolgere attenzione all’ambiente
Formazione Continua
L’offerta formativa per adulti, agricoltori e interessati al settore della manutenzione del verde ha visto un incremento delle partecipazioni. Tra i numerosi corsi tenuti, sempre molto
richiesti quelli per il rilascio/rinnovo di vari patentini fra cui il propedeutico all’esame di “Abilitazione per utilizzatori professionali di prodotti fitosanitari” e relativi moduli di aggiornamento le, abilitazioni all’uso del muletto, della piattaforma, e l’uso della motosega, il corso di “Coltivazione, riconoscimento e utilizzo piante aromatiche e officinali” e il corso di “Imprenditore agricolo”.

Cifre, dati e fatti 3.

In questa terza parte sono fornite approfondite informazioni sui report delle ripartizioni e degli uffici elencati nelle seconda parte, supportati da cifre, dati e fatti. Un quadro delle informazioni contenute si ottiene dall’indice delle tabelle e delle figure.
Indice tabelle e figure
Zootecnia Agricoltura 3.1
3.1.1
I dati fra il censimento agricolo 2010 e quelli censiti nel 2022 differiscono per il motivo che tante aziende agricole con attività secondarie non sono state rilevate nell’ambito del censimento agricolo.
Il seguente grafico rappresenta i prezzi medi realizzati alle aste zootecniche dall’anno 2019 al 2022 per le razze Bruna, Pezzata Rossa, Holstein e Grigio Alpina.

Tab. 2: Animali da macello e vitelli da ingrasso – prezzi medi 2021 e 2022
Tab. 3: Interventi di fecondazione artificiale 2020 – 2022
Tab.
Tab. 6: Aste ovini e caprini 2022
Tab. 5: Razze ovine e caprine in Alto Adige 2022
Per le razze ovine “Pecora Tirolese bruno-nera”, “Pecora tipo Lamon”, “Pecora della Val Senales” e “Pecora della roccia” viene concesso il premio per razze minacciate d’estinzione ai sensi del Regolamento UE n. 1305/2013.

Malattie infettive e diffusive degli animali
Prevenzione a malattie infettive dei bovini, degli ovini e dei caprini I campioni sul latte di massa delle aziende bovine conferenti il latte rappresentano un metodo di analisi molto economico.
nelle quali vengono prelevati campioni sul latte di massa
Diarrea Virale Bovina/Mucosal Disease
I vitelli neonati vengono controllati relativamente alla Diarrea Virale Bovina (BVD) mediante il prelievo di un campione di cartilagine auricolare delle dimensioni di 3 mm. I marcatori prelevano i campioni dai vitelli al momento dell’apposizione della marca auricolare, entro le prime tre settimane di vita degli animali. I bovini positivi per il virus BVD vengono di regola immediatamente condotti alla macellazione.

Malattia della lingua blu (Blue Tongue)
Il Regolamento di Esecuzione (UE) 2021/620 della Commissione del 15 aprile 2021 recante modalità di applicazione del regolamento (UE) 2016/429 del Parlamento europeo e del Consiglio per quanto riguarda l’approvazione dello status di indenne da malattia e dello status di zona di non vaccinazione di alcuni Stati membri o di loro zone o compartimenti in relazione ad alcune malattie elencate e all’approvazione dei programmi di eradicazione per tali malattie elencate considera l’Alto Adige una zona indenne dalla malattia della lingua blu (Blue Tongue).
Tab.
* dal 2021 i dati si riferiscono all’anno solare
Artrite-encefalite dei caprini
Durante la campagna di profilassi, eseguita dall’anno 2021 da gennaio a novembre, tutte le aziende caprine vengono sottoposte a controllo relativamente alla Artrite-encefalite dei caprini (CAEV), causato da diversi tipi di lentivirus.
dal 2021
Numero di caprini esaminati per lentivirus nel corso delle campagne di profilassi
* dal 2021 i dati si riferiscono all’anno solare
delle aziende con positività al lentivirus durante le campagne di profilassi
* dal 2021 i dati si riferiscono all’anno solare
dei caprini con positività al lentivirus nelle campagne di profilassi
* dal 2021 i dati si riferiscono all’anno solare
Nel piano di eradicazione della CAEV rientrano solo i caprini che reagiscono positivamente al Tipo B1 del lentivirus.
Prodotti alimentari di origine animale
Tab. 8: Piano Nazionale Residui
In base al Piano Nazionale Residui (PNR) sono stati prelevati dal Servizio Veterinario dell’Azienda Sanitaria dell’Alto Adige presso macelli ed allevamenti zootecnici, da animali vivi e da prodotti carnei, prodotti lattiero-caseari, prodotti ittici e miele, i seguenti campioni:
3.1.2 Frutticoltura

Tab. 9: Ripartizione del raccolto mele 2021 e 2022 in Alto Adige (in tonnellate)

Tab. 10: Prezzi medi al produttore per il raccolto di varietà da tavola 2020 e 2021
Tab. 11: Export di mele verso Paesi terzi 2018-2022 (in tonnellate)
3.1.3 Viticoltura

Tab. 13: Situazione dello schedario viticolo 2022 in ettari e %

3.1.4 Orticoltura

3.1.5 Meccanizzazione agricola

Tab. 17: Trattrici nuove 2022
Fig. 10: Potenza media delle trattrici nuove (CV)
Osservando la media dei CV si nota un crescendo di potenza verso i 54 CV dal 1951 fino agli anni ottanta, con un leggero ribasso verso il 1985.
La media dei CV è salita continuamente a raggiungere il massimo nel 2022 di 98,07 CV.

Foreste, malghe ed economia montana



3.2 3.2.1

3.2.1 Caccia e pesca
Tab.

Agenzia Demanio provinciale 3.3
Tab. 20: Panoramica del piano di gestione forestale
Tab. 21: Vendita prodotti secondari 2022

Fig. 13: Produzione di legname 2021/2022
Tab. 22: Listino prezzi 2022 Segheria Latemar

Fig. 14: Segheria Latemar: Prezzi del I e IV assortimento abete rosso Latemar
Fig. 15: Utilizzazioni forestali in mc dal 2005 al 2022
Settore venatorio (tedesco)
Settore venatorio (italiano)
Settore rip. foreste
Settore ed. ambientale
Settore utilizzo del legno
Corsi lavori boschivi
Altre manifestazioni
Settore venatorio (tedesco)
Settore venatorio (italiano)
Settore rip. foreste
Settore ed. ambientale
Settore utilizzo del legno
Corsi lavori boschivi
Altre manifestazioni

Tab. 24: Stazione meteorologica Centro di Sperimentazione Laimburg – Tabella mensile 2022
3.5
Scuole professionali agricole, forestali e per l’economia domestica e agroalimentare

Editore
Herausgeber
Autonome Provinz Bozen – Südtirol
Ressort Landwirtschaft, Forstwirtschaft, Tourismus und Bevölkerungsschutz
Provincia Autonoma di Bolzano – Alto Adige Dipartimento Agricoltura, Foreste, Turismo e Protezione civile Palazzo 6, Via Brennero 6, 39100 Bolzano, Tel. +39 0471 415 000
Landhaus 6, Brennerstraße 6, 39100 Bozen, Tel. 0471 415 000
Ripartizione Agricoltura www.provincia.bz.it/agricoltura
Abteilung Landwirtschaft
www.provinz.bz.it/landwirtschaft
Ripartizione Foreste www.provincia.bz.it/foreste
Abteilung Forstwirtschaft
www.provinz.bz.it/forstwirtschaft
Centro di Sperimentazione Laimburg www.laimburg.it
Versuchszentrum Laimburg
www.laimburg.it
Deutsche Bildungsdirektion
Landesdirektion deutschsprachige Berufsbildung
www.provinz.bz.it/berufsbildung
Agentur Landesdomäne
Direzione provinciale Formazione professionale in lingua tedesca http://www.provinz.bz.it/formazione-professionale Agenzia Demanio provinciale https://demanio.provincia.bz.it
http://landesdomaene.provinz.bz.it

Libera Università di Bolzano www.unibz.it
Redaktionsteam
Angelika Aichner Kössler, Franziska Maria Hack, Angelika Blasbichler, Ulrike Raffl, Peter Möltner
Redazione
Angelika Aichner Kössler, Johanna Höller, Angelika Blasbichler, Nadia Eisenkeil, Heike Platter, Matthias Gauly, Peter Möltner
Fotonachweis
Foto
Sofern nicht dezidiert gekennzeichnet, stammen die verwendeten Bilder von den einzelnen Abteilungen, von den Bildagenturen www.shutterstock.com, www.pixabay.com sowie einzelne Fotos von folgenden Organisationen, Firmen oder Einzelpersonen: Fürstenburg GmbH, Südtiroler Beratungsring für Obst- und Weinbau, Südtiroler Bäuerinnenorganisation, Südtiroler Gärtnervereinigung, Südtiroler Weinkonsortium, VOG - Verband der Südtiroler Obstgenossenschaften, Amt für Jagd und Fischerei, Amt für ländliches Bauwesen, Francesco Grazioli, Marion Lafogler, Agentur für Presse und Kommunikation/Maja Clara, Josef Telfser, Philipp Santifaller und www.flickr.com/photos/tambako/, Focusnatura, Andreas Platzer, Roter Hahn/Frieder Blickle, Südtiroler Sennereiverband, Manuel Kottersteger, Universität Bozen, Sonja Herpich, Maschinenring Südtirol, Othmar Seehauser, Beratungsring für die Berglandwirtschaft, Südtiroler Landwirt, IDM Südtirol/ Frieder Blickle, Florian Andergassen, Südtiroler Apfelkonsortium, Freie Universität Bozen, Die Gärten von Schloss Trauttmansdorff Alexander Schechinger, Versuchszentrum Laimburg/Ivo Corrà, Südtiroler Energieverband VIP/Julia, Lesina Debiasi, IDM Südtirol-Alto Adige/HelmutRier/Frieder Blickle/Manuel Ferrigato, Südtirol Wein/ IDM/Tiberio Sorvillo, Eurac Research/Martina Jaider, Versuchszentrum Laimburg/ ivocorrà
Se non indicato esplicitamente, le immagini utilizzate sono state messe a disposizione dalle singole ripartizioni, agenzie provinciali e istituzioni di ricerca, dall’Agenzia immagine www.shutterstock.com, www.pixabay.com - singole foto dalla Consulenza per l’agricoltura montana, Fürstenburg srl, Centro di Consulenza per la fruttiviticoltura dell’Alto Adige, Associazione delle Donne Coltivatrici Sudtirolesi, Associazione Giardinieri Alto Adige, Consorzio Vini Alto Adige, VOG - Consorzio delle Cooperative Ortofrutticole dell’Alto Adige, Francesco Grazioli, Marion Lafogler, Agenzia di stampa e comunicazione/Maja Clara, Josef Telfser, Philipp Santifaller e www.flickr.com/photos/tambako/, Focusnatura, Andreas Platzer, Gallo Rosso/Frieder Blickle, Federazione Latterie Alto Adige, Manuel Kottersteger, Maschinenring Südtirol, Othmar Seehauser, Oskar Da Ritz, Südtiroler Landwirt, IDM Alto Adige/Frieder Blickle, Florian Andergassen, Alexander Schechinger, Federazione Energia Alto Adige, VIP/Julia, Lesina Debiasi, IDM Südtirol-Alto Adige/HelmutRier/Frieder Blickle/Manuel Ferrigato, Eurac Research/Martina Jaider, Raiffeisenverband Südtirol, Südtiroler Bauernbund, Verein der Absolventen Landwirtschaftlicher Schulen, Bioland Südtirol, VOG Products, Laimburg Research Centre/ivo corrà/andreas tauber, LPA/Tiberio Sorvillo, LPA/Trenkwalder, Agentur für Bevölkerungsschutz, Bioland Südtirol, Uli Mayer-Johanssen GmbH, IDM/Andreas Miersa, LPA/G.News, Condifesa Bolzano/Fabian Dalpiaz, Oliver Oppitz, Ortsgruppe Feldthurns, VI.P Gen.landw. Gesellschaft, Joachim Schmuhl, SBR - Eugen Tumler, Joos Armin, Wellenzohn Paul, berghof-martelltal.com.
Layout
Layout
Artigraf by Kraler GmbH
Fliridruck
Gänsbacherstraße 36 - 39049 Sterzing
Via Prati Nuovi 23, 39020 Marlengo
T +39 0472 765605, www.artigraf.bz
T +39 0473 442501, www.fliridruck.com
Stampa
Druck
Fliridruck, Marlengo
Kraler Druck GmbH - Handwerkerzone 54 - I-39040 Vahrn (BZ)